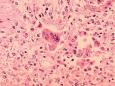
Viruserkrankung breitet sich aus: "Die Masern sind zurück" - auch in Deutschland

Die private US-Sonde »Athena« hat es zwar zum Mond geschafft, ist dort aber wahrscheinlich umgekippt. Das verantwortliche Unternehmen Intuitive Machines prüft nun, ob die geplanten Experimente noch möglich sind.
Die private US-Sonde »Athena« hat es zwar zum Mond geschafft, ist dort aber wahrscheinlich umgekippt. Das verantwortliche Unternehmen Intuitive Machines prüft nun, ob die geplanten Experimente noch möglich sind.
 Das private Raumfahrtunternehmen Intuitive Machines muss wahrscheinlich einen weiteren Fehlschlag hinnehmen: Nach der Mondlandung von "Athena" geht die US-Firma nicht davon aus, dass die Sonde aufrecht steht. Die gesamte Mission ist in Gefahr.
Das private Raumfahrtunternehmen Intuitive Machines muss wahrscheinlich einen weiteren Fehlschlag hinnehmen: Nach der Mondlandung von "Athena" geht die US-Firma nicht davon aus, dass die Sonde aufrecht steht. Die gesamte Mission ist in Gefahr.
 Die indische Mondsonde "Chandrayaan-3" untersucht die Oberfläche des Mondes und schickt die Daten an die Erde. Die Ergebnisse lassen vor allem die Pole des Mondes als attraktiven Standort für bemannte Mondstationen erscheinen.
Die indische Mondsonde "Chandrayaan-3" untersucht die Oberfläche des Mondes und schickt die Daten an die Erde. Die Ergebnisse lassen vor allem die Pole des Mondes als attraktiven Standort für bemannte Mondstationen erscheinen.
 Übergewicht ist ein globales Problem - auch bei Haustieren. Forschende nehmen deshalb eine bestimmte Hunderasse genauer unter die Lupe und entdecken dabei eine Genvariation, die maßgeblich für einen unstillbaren Appetit ist.
Übergewicht ist ein globales Problem - auch bei Haustieren. Forschende nehmen deshalb eine bestimmte Hunderasse genauer unter die Lupe und entdecken dabei eine Genvariation, die maßgeblich für einen unstillbaren Appetit ist.
 Dicht unter der Oberfläche des Mondes sammelt sich womöglich Wasser und gefriert, sagen indische Forschende. Das wären gute Aussichten für bemannte Mondstationen.
Dicht unter der Oberfläche des Mondes sammelt sich womöglich Wasser und gefriert, sagen indische Forschende. Das wären gute Aussichten für bemannte Mondstationen.
 Wer die AfD wählt, sehnt sich nach Zugehörigkeit, sagt der Psychologe Gerd Gigerenzer. Er erklärt, warum Elon Musk die Demokratie gefährdet. Und wieso er sich im Wahlkampf für Deutschland geschämt hat.
Wer die AfD wählt, sehnt sich nach Zugehörigkeit, sagt der Psychologe Gerd Gigerenzer. Er erklärt, warum Elon Musk die Demokratie gefährdet. Und wieso er sich im Wahlkampf für Deutschland geschämt hat.
 In Tunneln hält sich Abwärme, die Züge beim Bremsen und Beschleunigen erzeugen. Forschende haben untersucht, wie sie sich für Gebäude nutzen ließe – Paris macht es mit seiner Metro vor.
In Tunneln hält sich Abwärme, die Züge beim Bremsen und Beschleunigen erzeugen. Forschende haben untersucht, wie sie sich für Gebäude nutzen ließe – Paris macht es mit seiner Metro vor.
 Das Nothing Phone (3a) und das (3a) Pro feiern beim MWC in Barcelona Premiere. Die Geräte sind in fast jeder Hinsicht noch besser als die bereits starken Vorgänger, bleiben aber mit Preisen ab 330 und 460 Euro günstig. Das macht sie zu echten Mittelklasse-Stars - speziell für Schnellentschlossene.
Das Nothing Phone (3a) und das (3a) Pro feiern beim MWC in Barcelona Premiere. Die Geräte sind in fast jeder Hinsicht noch besser als die bereits starken Vorgänger, bleiben aber mit Preisen ab 330 und 460 Euro günstig. Das macht sie zu echten Mittelklasse-Stars - speziell für Schnellentschlossene.
 Aufgewertet mit künstlicher Intelligenz sollte eine neue Version von Siri zum Zugpferd für aktuelle iPhones werden. Doch die soll frühestens in einigen Monaten fertig sein. Für Apple ein peinlicher Vorgang.
Aufgewertet mit künstlicher Intelligenz sollte eine neue Version von Siri zum Zugpferd für aktuelle iPhones werden. Doch die soll frühestens in einigen Monaten fertig sein. Für Apple ein peinlicher Vorgang.
 Manche Stadtvögel nutzen ihre Nester inzwischen über Generationen – sie bestehen aus Plastikmüll. Ein niederländischer Ökologe hat die Brutstätten analysiert.
Manche Stadtvögel nutzen ihre Nester inzwischen über Generationen – sie bestehen aus Plastikmüll. Ein niederländischer Ökologe hat die Brutstätten analysiert.
 Krümel, Haare, Colaspritzer: Wenn die Tastatur allzu viel Schmodder angesammelt hat, graust es auch Menschen ohne Hygienefimmel. Im Fall der Fälle empfiehlt sich eine Radikalkur.
Krümel, Haare, Colaspritzer: Wenn die Tastatur allzu viel Schmodder angesammelt hat, graust es auch Menschen ohne Hygienefimmel. Im Fall der Fälle empfiehlt sich eine Radikalkur.
 Das iPhone 16E ist deutlich günstiger als die anderen aktuellen Apple-Smartphones. Aber ist es auch die bessere Alternative zu preiswerteren, älteren iPhones? Denn außer einem bärenstarken KI-Chip ist der Neuling in fast allen Bereichen nicht besser oder sogar schwächer ausgestattet als etwa das iPhone 15.
Das iPhone 16E ist deutlich günstiger als die anderen aktuellen Apple-Smartphones. Aber ist es auch die bessere Alternative zu preiswerteren, älteren iPhones? Denn außer einem bärenstarken KI-Chip ist der Neuling in fast allen Bereichen nicht besser oder sogar schwächer ausgestattet als etwa das iPhone 15.
 Seit dem Morgen ist der Kurznachrichtendienst x immer wieder von Störungen betroffen. Am Abend ist das Netzwerk wieder erreichbar. Der Grund für die Ausfälle ist unklar.
Seit dem Morgen ist der Kurznachrichtendienst x immer wieder von Störungen betroffen. Am Abend ist das Netzwerk wieder erreichbar. Der Grund für die Ausfälle ist unklar.
 Seit dem Morgen ist der Kurznachrichtendienst x immer wieder von Störungen betroffen. Laut Chef Elon Musk handelt es sich um einen Cyberangriff.
Seit dem Morgen ist der Kurznachrichtendienst x immer wieder von Störungen betroffen. Laut Chef Elon Musk handelt es sich um einen Cyberangriff.
 Ethereum im rekordverdächtigen Wert von rund 1,5 Milliarden Dollar konnten sie der Kryptobörse Bybit stehlen. Nun folgt für die mutmaßlich nordkoreanischen Täter die nächste Aufgabe – an die Beute herankommen und dann sichern.
Ethereum im rekordverdächtigen Wert von rund 1,5 Milliarden Dollar konnten sie der Kryptobörse Bybit stehlen. Nun folgt für die mutmaßlich nordkoreanischen Täter die nächste Aufgabe – an die Beute herankommen und dann sichern.
 Dass man bei Wasser aus Plastikflaschen Kunststoffteilchen mittrinkt, ist nicht überraschend. Aber auch bei Glasflaschen? Und Teebeuteln? Mikroplastik ist überall und wurde bereits im Gehirn und anderen Organen festgestellt. Forscher wissen Rat, wie man die eigene Plastikaufnahme reduzieren kann.
Dass man bei Wasser aus Plastikflaschen Kunststoffteilchen mittrinkt, ist nicht überraschend. Aber auch bei Glasflaschen? Und Teebeuteln? Mikroplastik ist überall und wurde bereits im Gehirn und anderen Organen festgestellt. Forscher wissen Rat, wie man die eigene Plastikaufnahme reduzieren kann.
 Der weiterhin steigende CO₂-Ausstoß wirkt sich einer Studie zufolge auch auf die Raumfahrt aus. Weil weniger Weltraumschrott verglüht, drohen mehr Kollisionen mit Satelliten.
Der weiterhin steigende CO₂-Ausstoß wirkt sich einer Studie zufolge auch auf die Raumfahrt aus. Weil weniger Weltraumschrott verglüht, drohen mehr Kollisionen mit Satelliten.
 Es gibt keine Anzeichen für eine Opioid-Krise in Deutschland. Jedoch sehen Fachleute erste Tendenzen, die auf einen steigenden Missbrauch von starken opioidhaltigen Schmerzmitteln bei jungen Menschen hinweisen könnten.
Es gibt keine Anzeichen für eine Opioid-Krise in Deutschland. Jedoch sehen Fachleute erste Tendenzen, die auf einen steigenden Missbrauch von starken opioidhaltigen Schmerzmitteln bei jungen Menschen hinweisen könnten.
 Mit "It Takes Two" landet Entwickler Hazelight einen absoluten Überraschungshit. Nun folgt "Split Fiction", bei dem man sich vor dem Bildschirm wieder zu zweit ins Abenteuer stürzen kann. Kann das Spiel die riesigen Fußstapfen füllen?
Mit "It Takes Two" landet Entwickler Hazelight einen absoluten Überraschungshit. Nun folgt "Split Fiction", bei dem man sich vor dem Bildschirm wieder zu zweit ins Abenteuer stürzen kann. Kann das Spiel die riesigen Fußstapfen füllen?
 Nicht täuschen lassen, es ist die Venus, nicht der Mond: Derzeit erscheint sie als schmale Sichel am Abendhimmel. Die Venus ist der Erde derzeit so nah, dass ein Opern- oder Fernglas ausreicht, um sie zu betrachten.
Nicht täuschen lassen, es ist die Venus, nicht der Mond: Derzeit erscheint sie als schmale Sichel am Abendhimmel. Die Venus ist der Erde derzeit so nah, dass ein Opern- oder Fernglas ausreicht, um sie zu betrachten.
 Bei dem Zusammenstoß zweier Schiffe vor der britischen Nordseeküste ist ein Öltanker in Brand geraten, Kerosin läuft aus. Laut Umweltexperten könnten Schadstoffe in die Richtung von Meeresschutzgebieten treiben.
Bei dem Zusammenstoß zweier Schiffe vor der britischen Nordseeküste ist ein Öltanker in Brand geraten, Kerosin läuft aus. Laut Umweltexperten könnten Schadstoffe in die Richtung von Meeresschutzgebieten treiben.
 Menschen waren schon seit mehr als 50 Jahren nicht auf dem Mond, dafür herrscht dort jetzt Roboter-Rushhour. SPIEGEL-Redakteur Christoph Seidler erklärt, was China und die USA wollen – und wie private Unternehmen mitmischen.
Menschen waren schon seit mehr als 50 Jahren nicht auf dem Mond, dafür herrscht dort jetzt Roboter-Rushhour. SPIEGEL-Redakteur Christoph Seidler erklärt, was China und die USA wollen – und wie private Unternehmen mitmischen.
 Die USA haben Anklage gegen zwölf chinesische Staatsangehörige erhoben. Sie sollen es auf Dissidenten, Medien und Behörden abgesehen haben. Einige mutmaßliche Täter seien von der chinesischen Regierung beauftragt.
Die USA haben Anklage gegen zwölf chinesische Staatsangehörige erhoben. Sie sollen es auf Dissidenten, Medien und Behörden abgesehen haben. Einige mutmaßliche Täter seien von der chinesischen Regierung beauftragt.
 Sonnenschein und Frühlingsgefühle: Das Wetter in Deutschland lädt zum Sonnenbaden ein. Allerdings sollte dabei die Sonnencreme nicht fehlen - UV-Strahlung ist schließlich die häufigste Ursache für Hautkrebs. Und davon gibt es immer mehr Fälle, zeigt nun eine neue Untersuchung.
Sonnenschein und Frühlingsgefühle: Das Wetter in Deutschland lädt zum Sonnenbaden ein. Allerdings sollte dabei die Sonnencreme nicht fehlen - UV-Strahlung ist schließlich die häufigste Ursache für Hautkrebs. Und davon gibt es immer mehr Fälle, zeigt nun eine neue Untersuchung.
 Der US-Präsident möchte die große Arktisinsel seinem Land einverleiben. Aber wozu? Der Grönland-Experte Paul Bierman erklärt, warum es meist keinen Sinn ergibt, die Rohstoffvorkommen dort auszubeuten.
Der US-Präsident möchte die große Arktisinsel seinem Land einverleiben. Aber wozu? Der Grönland-Experte Paul Bierman erklärt, warum es meist keinen Sinn ergibt, die Rohstoffvorkommen dort auszubeuten.
 Die Weltraumteleskope "Webb" und "Hubble" der Nasa zeigen Galaxien bereits jetzt schon sehr detailliert. Nun ist das neue Teleskop "Spherex" gestartet - es soll das All so farbenprächtig kartieren wie nie zuvor. Zugleich soll es die Ursprünge des Universums erforschen.
Die Weltraumteleskope "Webb" und "Hubble" der Nasa zeigen Galaxien bereits jetzt schon sehr detailliert. Nun ist das neue Teleskop "Spherex" gestartet - es soll das All so farbenprächtig kartieren wie nie zuvor. Zugleich soll es die Ursprünge des Universums erforschen.
 Deutschland kauft 35 Exemplare des Tarnkappenjets F-35 aus den USA. Doch es gibt Zweifel, ob die Maschinen im Krieg in jedem Fall funktionieren würden – und Spekulationen über einen geheimen Not-Aus-Schalter.
Deutschland kauft 35 Exemplare des Tarnkappenjets F-35 aus den USA. Doch es gibt Zweifel, ob die Maschinen im Krieg in jedem Fall funktionieren würden – und Spekulationen über einen geheimen Not-Aus-Schalter.
 Beim Reden benutzen wir nicht nur die Hände, um das Gesagte zu unterstreichen: Wer in einem Gespräch die Augenbrauen zusammenzieht, erhält eine ausführlichere Erklärung, so ein Forschungsteam. Diese Erkenntnis hat Auswirkungen auch auf die Entwicklung von KI.
Beim Reden benutzen wir nicht nur die Hände, um das Gesagte zu unterstreichen: Wer in einem Gespräch die Augenbrauen zusammenzieht, erhält eine ausführlichere Erklärung, so ein Forschungsteam. Diese Erkenntnis hat Auswirkungen auch auf die Entwicklung von KI.
 In die Begrenzung des Klimawandels zu investieren, ist teuer. Doch es nicht zu tun, wäre noch viel teurer. Denn die Folgen des Anstiegs der globalen Temperatur schaden auch der Wirtschaft enorm. Wie sehr, hat eine Untersuchung errechnet. Ein Ergebnis: Handeln würde sich wirtschaftlich lohnen.
In die Begrenzung des Klimawandels zu investieren, ist teuer. Doch es nicht zu tun, wäre noch viel teurer. Denn die Folgen des Anstiegs der globalen Temperatur schaden auch der Wirtschaft enorm. Wie sehr, hat eine Untersuchung errechnet. Ein Ergebnis: Handeln würde sich wirtschaftlich lohnen.
 Der Bundesnachrichtendienst hat unter dem Codenamen »Saaremaa« schon früh Informationen zum möglichen Ursprung des Coronavirus beschafft. Zwei Medienberichten zufolge verhinderte das Bundeskanzleramt die Veröffentlichung.
Der Bundesnachrichtendienst hat unter dem Codenamen »Saaremaa« schon früh Informationen zum möglichen Ursprung des Coronavirus beschafft. Zwei Medienberichten zufolge verhinderte das Bundeskanzleramt die Veröffentlichung.
 Stiften Inhalte auf TikTok zu Gewalt an? Die Regierung in Tirana scheint davon überzeugt zu sein. In Albanien wird sich die Video-App daher bis auf Weiteres nur noch mit technischen Tricks nutzen lassen.
Stiften Inhalte auf TikTok zu Gewalt an? Die Regierung in Tirana scheint davon überzeugt zu sein. In Albanien wird sich die Video-App daher bis auf Weiteres nur noch mit technischen Tricks nutzen lassen.
 Handygames wie »Ingress« und »Pokémon Go« haben Niantic berühmt und milliardenschwer gemacht. Jetzt verkauft die US-Firma Teile ihres Geschäfts und spricht von einem »mutigen neuen Kurs«.
Handygames wie »Ingress« und »Pokémon Go« haben Niantic berühmt und milliardenschwer gemacht. Jetzt verkauft die US-Firma Teile ihres Geschäfts und spricht von einem »mutigen neuen Kurs«.
 Die OP dauerte sechs Stunden, dann funktionierte das Herz aus Metall: Ein Patient in Australien hat damit länger als drei Monate gelebt. Nun wurde es gegen ein Spenderorgan ausgetauscht.
Die OP dauerte sechs Stunden, dann funktionierte das Herz aus Metall: Ein Patient in Australien hat damit länger als drei Monate gelebt. Nun wurde es gegen ein Spenderorgan ausgetauscht.
 Bei der Weltklimakonferenz beraten Staaten, wie sich die Erderwärmung eindämmen ließe. Die nächste findet im Amazonasgebiet statt. Nun gibt es Streit über eine Zufahrtsstraße.
Bei der Weltklimakonferenz beraten Staaten, wie sich die Erderwärmung eindämmen ließe. Die nächste findet im Amazonasgebiet statt. Nun gibt es Streit über eine Zufahrtsstraße.
 Der Mond schiebt sich in den Schatten der Erde: Über Deutschland ist am Freitagmorgen am Morgenhimmel eine partielle Mondfinsternis zu beobachten - wenn nicht zu viele Wolken im Weg sind. Und das Spektakel ist auch recht schnell wieder vorbei.
Der Mond schiebt sich in den Schatten der Erde: Über Deutschland ist am Freitagmorgen am Morgenhimmel eine partielle Mondfinsternis zu beobachten - wenn nicht zu viele Wolken im Weg sind. Und das Spektakel ist auch recht schnell wieder vorbei.
 Antibiotika bei unkomplizierten Atemwegserkrankungen oder Röntgen bei Rückenschmerzen: Ärzte und Ärztinnen verschreiben zu oft Leistungen, deren Nutzen zweifelhaft sind. So könnten Kosten in Millionenhöhe entstehen, wie eine Untersuchung zeigt. Die Ursachen dafür sind zahlreich.
Antibiotika bei unkomplizierten Atemwegserkrankungen oder Röntgen bei Rückenschmerzen: Ärzte und Ärztinnen verschreiben zu oft Leistungen, deren Nutzen zweifelhaft sind. So könnten Kosten in Millionenhöhe entstehen, wie eine Untersuchung zeigt. Die Ursachen dafür sind zahlreich.
 Eine »Outdoor-Influencerin« hat auf ihrer Reise durch Australien für ein Social-Media-Posting ein junges Wombat von seiner Mutter getrennt. Die Empörung ist groß – bis hin in die Spitzenpolitik.
Eine »Outdoor-Influencerin« hat auf ihrer Reise durch Australien für ein Social-Media-Posting ein junges Wombat von seiner Mutter getrennt. Die Empörung ist groß – bis hin in die Spitzenpolitik.
 Lange war unklar, warum Kinder in Folge einer Coronainfektion lebensgefährlich am Entzündungssyndrom PIMS erkranken können. Nun wollen Forschende die Ursache gefunden haben: Ein weiteres Virus soll beteiligt sein.
Lange war unklar, warum Kinder in Folge einer Coronainfektion lebensgefährlich am Entzündungssyndrom PIMS erkranken können. Nun wollen Forschende die Ursache gefunden haben: Ein weiteres Virus soll beteiligt sein.
 Wie entstand das SARS-CoV-2-Virus? Der Bundesnachrichtendienst will plausible Hinweise für die Laborthese haben. Doch der Virologe Christian Drosten sagt: Forschern fehlen die Quelldaten, um die Behauptung einzuschätzen.
Wie entstand das SARS-CoV-2-Virus? Der Bundesnachrichtendienst will plausible Hinweise für die Laborthese haben. Doch der Virologe Christian Drosten sagt: Forschern fehlen die Quelldaten, um die Behauptung einzuschätzen.
 Kein Fleck auf der Linse, sondern ein besonderer Himmelskörper: Die ESA-Raumsonde »Hera« ist nah am Planeten Mars vorbeigeflogen und hat dabei dessen Mond Deimos aus einer neuen Perspektive fotografiert.
Kein Fleck auf der Linse, sondern ein besonderer Himmelskörper: Die ESA-Raumsonde »Hera« ist nah am Planeten Mars vorbeigeflogen und hat dabei dessen Mond Deimos aus einer neuen Perspektive fotografiert.
 Apple hält sich bei den Verbesserungen des MacBook Air vornehm zurück. Doch der neue M4-Chip, eine folgsame Kamera und ein kleiner Preisnachlass reichen aus, um die vergleichbare Windows-Konkurrenz auf Abstand zu halten.
Apple hält sich bei den Verbesserungen des MacBook Air vornehm zurück. Doch der neue M4-Chip, eine folgsame Kamera und ein kleiner Preisnachlass reichen aus, um die vergleichbare Windows-Konkurrenz auf Abstand zu halten.
 Angeblich hat der BND Erkenntnisse zum Ursprung des Coronavirus. Die müssen endlich öffentlich gemacht werden, sonst nimmt das Vertrauen in Regierung und Wissenschaft weiteren Schaden.
Angeblich hat der BND Erkenntnisse zum Ursprung des Coronavirus. Die müssen endlich öffentlich gemacht werden, sonst nimmt das Vertrauen in Regierung und Wissenschaft weiteren Schaden.
 In Deutschland sind Insekten in Lebensmittel noch selten. Doch die Produktion steigt laut Branchenangaben EU-weit stark an. Trotz der Vorteile bleibt der Markt für Insektenprodukte hierzulande eine Nische. Warum die Alternative zum Fleisch so wenig Anklang findet und wo schon Insekten drinstecken, zeigt der Überblick.
In Deutschland sind Insekten in Lebensmittel noch selten. Doch die Produktion steigt laut Branchenangaben EU-weit stark an. Trotz der Vorteile bleibt der Markt für Insektenprodukte hierzulande eine Nische. Warum die Alternative zum Fleisch so wenig Anklang findet und wo schon Insekten drinstecken, zeigt der Überblick.
 Der Ausstoß von Klimagasen ist im vergangenen Jahr weiter zurückgegangen – dank mehr Ökostrom und weniger Kohlekraft. Ohne einen Anstieg bei Elektroautos und Wärmepumpen aber sind die Klimaziele für 2030 in Gefahr.
Der Ausstoß von Klimagasen ist im vergangenen Jahr weiter zurückgegangen – dank mehr Ökostrom und weniger Kohlekraft. Ohne einen Anstieg bei Elektroautos und Wärmepumpen aber sind die Klimaziele für 2030 in Gefahr.
 Durch die Explosion am Kachowka-Damm in der Ukraine gelangten laut einer neuen Studie Tausende Tonnen Schadstoffe an die Oberfläche. Die Folgen seien mit den Auswirkungen radioaktiver Strahlung vergleichbar.
Durch die Explosion am Kachowka-Damm in der Ukraine gelangten laut einer neuen Studie Tausende Tonnen Schadstoffe an die Oberfläche. Die Folgen seien mit den Auswirkungen radioaktiver Strahlung vergleichbar.
 Die radikalen Budgetkürzungen der US-Regierung treffen auch eine der renommiertesten Einrichtungen der Medizinforschung hart: Die Johns-Hopkins-Universität ist gezwungen, weltweit fast 2000 Mitarbeiter zu entlassen. Essenzielle Projekte, etwa zur Trinkwasserversorgung, fallen dem Kahlschlag zum Opfer.
Die radikalen Budgetkürzungen der US-Regierung treffen auch eine der renommiertesten Einrichtungen der Medizinforschung hart: Die Johns-Hopkins-Universität ist gezwungen, weltweit fast 2000 Mitarbeiter zu entlassen. Essenzielle Projekte, etwa zur Trinkwasserversorgung, fallen dem Kahlschlag zum Opfer.
 Während sich in den 1980er Jahren viele Menschen beim Skilaufen das Bein brechen, sehen aktuell Verletzungen oftmals anders aus. Das liegt an verschiedenen Faktoren, die sich seitdem verändert haben, erklärt ein Klinikarzt.
Während sich in den 1980er Jahren viele Menschen beim Skilaufen das Bein brechen, sehen aktuell Verletzungen oftmals anders aus. Das liegt an verschiedenen Faktoren, die sich seitdem verändert haben, erklärt ein Klinikarzt.
 Der Mond hat sich in den Schatten der Erde geschoben. In manchen Ländern verdunkelte sich der Erdtrabant komplett –sogar ein Blutmond war zu sehen.
Der Mond hat sich in den Schatten der Erde geschoben. In manchen Ländern verdunkelte sich der Erdtrabant komplett –sogar ein Blutmond war zu sehen.
 2023 wurde der Kachowka-Staudamm zerstört, gewaltige Wassermassen überfluteten weite Gebiete und verwandelten sie laut Forschern in eine »giftige Zeitbombe«. Ein junger Wald aber macht Hoffnung auf einen ökologischen Neustart.
2023 wurde der Kachowka-Staudamm zerstört, gewaltige Wassermassen überfluteten weite Gebiete und verwandelten sie laut Forschern in eine »giftige Zeitbombe«. Ein junger Wald aber macht Hoffnung auf einen ökologischen Neustart.
 Die Fellfärbung von frühen Säugetieren war durchgängig dunkelbraun, statt bunt, gestreift oder gefleckt, berichtet ein Forschungsteam. Sie gehen davon aus, dass die Tiere damals hauptsächlich nachtaktiv waren und sich so vor Feinden schützten.
Die Fellfärbung von frühen Säugetieren war durchgängig dunkelbraun, statt bunt, gestreift oder gefleckt, berichtet ein Forschungsteam. Sie gehen davon aus, dass die Tiere damals hauptsächlich nachtaktiv waren und sich so vor Feinden schützten.
 Die deutschen Geheimdienste wollen Hinweise darauf gefunden haben, dass Sars-CoV-2 aus einem chinesischen Labor stammt. Nun hat sich der frühere Chef des Robert Koch-Instituts dazu geäußert.
Die deutschen Geheimdienste wollen Hinweise darauf gefunden haben, dass Sars-CoV-2 aus einem chinesischen Labor stammt. Nun hat sich der frühere Chef des Robert Koch-Instituts dazu geäußert.
 Lobbyisten des chinesischen Konzerns sollen jahrelang EU-Abgeordnete und deren Assistenten mit Geld oder Geschenken bestochen haben. Die Ermittlungen laufen, das Parlament reagierte mit einer »Vorsichtsmaßnahme«.
Lobbyisten des chinesischen Konzerns sollen jahrelang EU-Abgeordnete und deren Assistenten mit Geld oder Geschenken bestochen haben. Die Ermittlungen laufen, das Parlament reagierte mit einer »Vorsichtsmaßnahme«.
 Apple stattet das iPad Air mit dem M3-Chip aus, was dem Tablet-PC einen kräftigen Leistungsschub versetzt. Es ist jetzt fast so kräftig wie ein aktuelles Pro, aber nicht teurer als der Vorgänger. Ansonsten bleibt alles beim Alten.
Apple stattet das iPad Air mit dem M3-Chip aus, was dem Tablet-PC einen kräftigen Leistungsschub versetzt. Es ist jetzt fast so kräftig wie ein aktuelles Pro, aber nicht teurer als der Vorgänger. Ansonsten bleibt alles beim Alten.
 Was macht es mit Raumfahrern, wenn ihre Mission plötzlich Monate statt Tage dauert? ISS-Experte Volker Schmid erklärt, wie sich Astronauten auf der Internationalen Raumstation die Zeit vertreiben.
Was macht es mit Raumfahrern, wenn ihre Mission plötzlich Monate statt Tage dauert? ISS-Experte Volker Schmid erklärt, wie sich Astronauten auf der Internationalen Raumstation die Zeit vertreiben.
 Seit fast zehn Monaten warten zwei Astronauten auf ihre Heimkehr von der Internationalen Raumstation. Nun gibt es gute Nachrichten für sie. Eine Raumkapsel, die sie zurück zur Erde bringen soll, ist auf dem Weg.
Seit fast zehn Monaten warten zwei Astronauten auf ihre Heimkehr von der Internationalen Raumstation. Nun gibt es gute Nachrichten für sie. Eine Raumkapsel, die sie zurück zur Erde bringen soll, ist auf dem Weg.
 Ihr Ausflug ins All sollte acht Tage dauern, es wurden neun Monate daraus. Doch für die beiden ISS-Astronauten Suni Williams und Barry Wilmore naht die Rettung. Ihre Rückflug-Kapsel ist auf dem Weg, mitsamt dem Ablöseteam "Crew 10".
Ihr Ausflug ins All sollte acht Tage dauern, es wurden neun Monate daraus. Doch für die beiden ISS-Astronauten Suni Williams und Barry Wilmore naht die Rettung. Ihre Rückflug-Kapsel ist auf dem Weg, mitsamt dem Ablöseteam "Crew 10".
 Eine Woche sollen Suni William und Barry Wilmore auf der Internationalen Raumstation verbringen. Wegen technischer Probleme flog ihr Raumschiff jedoch leer zu Erde zurück. Die beiden US-Astronauten blieben bis jetzt - zehn Monate - im All. Nun sind sie ihrer Rückkehr einen Schritt näher.
Eine Woche sollen Suni William und Barry Wilmore auf der Internationalen Raumstation verbringen. Wegen technischer Probleme flog ihr Raumschiff jedoch leer zu Erde zurück. Die beiden US-Astronauten blieben bis jetzt - zehn Monate - im All. Nun sind sie ihrer Rückkehr einen Schritt näher.
 In Nordspanien entdecken Forschende gut erhaltene Schädelknochen, die zwischen 1,1 und 1,4 Millionen Jahre alt sind. Sie liefern Hinweise auf das gleichzeitige Vorkommen von zwei Menschenarten. Die genaue zeitliche Koexistenz bleibt jedoch unklar.
In Nordspanien entdecken Forschende gut erhaltene Schädelknochen, die zwischen 1,1 und 1,4 Millionen Jahre alt sind. Sie liefern Hinweise auf das gleichzeitige Vorkommen von zwei Menschenarten. Die genaue zeitliche Koexistenz bleibt jedoch unklar.
 Hat ein Laborunfall die Coronapandemie ausgelöst? Seit fünf Jahren hält die Bundesregierung Indizien zum Ursprung des Virus zurück. Die Geheimniskrämerei vergiftet die wissenschaftliche Moral.
Hat ein Laborunfall die Coronapandemie ausgelöst? Seit fünf Jahren hält die Bundesregierung Indizien zum Ursprung des Virus zurück. Die Geheimniskrämerei vergiftet die wissenschaftliche Moral.
 Kühe schaden dem Klima. Durch ein neues Mittel soll sich das ändern. Der Futtermittelzusatz Bovaer verhindert, dass Kühe Methan in die Atmosphäre rülpsen. Schadet er den Menschen, wie viele behaupten?
Kühe schaden dem Klima. Durch ein neues Mittel soll sich das ändern. Der Futtermittelzusatz Bovaer verhindert, dass Kühe Methan in die Atmosphäre rülpsen. Schadet er den Menschen, wie viele behaupten?
 Nicht täuschen lassen, es ist die Venus, nicht der Mond: Derzeit erscheint sie als schmale Sichel am Abendhimmel. Die Venus ist der Erde derzeit so nah, dass ein Opern- oder Fernglas ausreicht, um sie zu betrachten.
Nicht täuschen lassen, es ist die Venus, nicht der Mond: Derzeit erscheint sie als schmale Sichel am Abendhimmel. Die Venus ist der Erde derzeit so nah, dass ein Opern- oder Fernglas ausreicht, um sie zu betrachten.
 Es gibt keine Anzeichen für eine Opioid-Krise in Deutschland. Jedoch sehen Fachleute erste Tendenzen, die auf einen steigenden Missbrauch von starken opioidhaltigen Schmerzmitteln bei jungen Menschen hinweisen könnten.
Es gibt keine Anzeichen für eine Opioid-Krise in Deutschland. Jedoch sehen Fachleute erste Tendenzen, die auf einen steigenden Missbrauch von starken opioidhaltigen Schmerzmitteln bei jungen Menschen hinweisen könnten.
 Seit fast zehn Monaten warten zwei Astronauten auf ihre Heimkehr von der Internationalen Raumstation. Nun gibt es gute Nachrichten für sie: Sie können bald zurück zur Erde.
Seit fast zehn Monaten warten zwei Astronauten auf ihre Heimkehr von der Internationalen Raumstation. Nun gibt es gute Nachrichten für sie: Sie können bald zurück zur Erde.
 Ein schriller, lauter Ton, danach Panik: Bei einer Demonstration gegen die Regierung in Serbien soll am Wochenende eine Schallwaffe eingesetzt worden sein. Was über den Vorfall und die Geräte bekannt ist.
Ein schriller, lauter Ton, danach Panik: Bei einer Demonstration gegen die Regierung in Serbien soll am Wochenende eine Schallwaffe eingesetzt worden sein. Was über den Vorfall und die Geräte bekannt ist.
 Prävention und Prophylaxe helfen - das zeigt aktuelle Deutsche Mundgesundheitsstudie. Demnach geht der Anteil von Patienten zurück, die mit Karies zu kämpfen haben. Bei Kindern sinkt die Zahl um 90 Prozent. Eine andere Zahnerkrankung bereitet dagegen 14 Millionen Deutschen Probleme.
Prävention und Prophylaxe helfen - das zeigt aktuelle Deutsche Mundgesundheitsstudie. Demnach geht der Anteil von Patienten zurück, die mit Karies zu kämpfen haben. Bei Kindern sinkt die Zahl um 90 Prozent. Eine andere Zahnerkrankung bereitet dagegen 14 Millionen Deutschen Probleme.
 Landungen auf dem Mond sind technisch schwierig. "Blue Ghost" gelingt es jedoch und führt in der Folge zehn Experimente auf dem Erdtrabanten durch. Doch jetzt erreicht das Gerät sein Lebensende.
Landungen auf dem Mond sind technisch schwierig. "Blue Ghost" gelingt es jedoch und führt in der Folge zehn Experimente auf dem Erdtrabanten durch. Doch jetzt erreicht das Gerät sein Lebensende.
 Das Shokz OpenMeet UC ist ein sehr kleines und leichtes Headset mit hybriden Schallwandlern, das man kaum spürt. Trotzdem ist der Klang ausgezeichnet, und das Mikrofon erfüllt ebenfalls hohe Ansprüche. Das hochwertige Vergnügen ist aber nicht günstig und nicht für jeden Kopf geeignet.
Das Shokz OpenMeet UC ist ein sehr kleines und leichtes Headset mit hybriden Schallwandlern, das man kaum spürt. Trotzdem ist der Klang ausgezeichnet, und das Mikrofon erfüllt ebenfalls hohe Ansprüche. Das hochwertige Vergnügen ist aber nicht günstig und nicht für jeden Kopf geeignet.
 Würde Spider-Man seine Stimme Donald Trump geben und Lord Voldemort für die Demokraten votieren? Kommt drauf an, wen man nach der vermeintlichen Vorliebe der fiktiven Charaktere fragt, sagen zwei Forscher.
Würde Spider-Man seine Stimme Donald Trump geben und Lord Voldemort für die Demokraten votieren? Kommt drauf an, wen man nach der vermeintlichen Vorliebe der fiktiven Charaktere fragt, sagen zwei Forscher.
 Für acht Tage wollten die zwei Astronauten Suni Williams und Barry Wilmore ins All fliegen. Jetzt sind fast neun Monate daraus geworden. Eine Rakete des Musk-Unternehmens SpaceX soll sie heimholen. Doch der Start misslingt.
Für acht Tage wollten die zwei Astronauten Suni Williams und Barry Wilmore ins All fliegen. Jetzt sind fast neun Monate daraus geworden. Eine Rakete des Musk-Unternehmens SpaceX soll sie heimholen. Doch der Start misslingt.
 Nach vielem Hin und Her sowie geänderter Flugbesatzungen sind nun die beiden US-Astronauten Suni Williams und Barry Wilmore auf dem Weg zurück zur Erde. Damit endet ihr interplanetarer Aufenthalt nach neun Monaten, statt nach acht Tagen.
Nach vielem Hin und Her sowie geänderter Flugbesatzungen sind nun die beiden US-Astronauten Suni Williams und Barry Wilmore auf dem Weg zurück zur Erde. Damit endet ihr interplanetarer Aufenthalt nach neun Monaten, statt nach acht Tagen.
 Sie sollten ursprünglich nur gut eine Woche bleiben, doch daraus wurden mehr als neun Monate: Zwei US-Astronauten steckten unfreiwillig auf der Internationalen Raumstation ISS fest. Nun hat ihre Rückreise zur Erde begonnen.
Sie sollten ursprünglich nur gut eine Woche bleiben, doch daraus wurden mehr als neun Monate: Zwei US-Astronauten steckten unfreiwillig auf der Internationalen Raumstation ISS fest. Nun hat ihre Rückreise zur Erde begonnen.
 Deutschland ist von Energieimporten wie Öl und Erdgas abhängig. In der derzeitigen Weltlage ist das riskant. Ist die neue Regierung klug, nutzt sie das Schuldenpaket, um mit der Energiewende Sicherheitspolitik zu machen.
Deutschland ist von Energieimporten wie Öl und Erdgas abhängig. In der derzeitigen Weltlage ist das riskant. Ist die neue Regierung klug, nutzt sie das Schuldenpaket, um mit der Energiewende Sicherheitspolitik zu machen.
 Der Sitz des US-Präsidenten hat jetzt Internet aus dem All. Musk hat es gespendet, ein Anwalt als ethisch sauber abgenickt. Die technische Umsetzung ist zumindest skurril.
Der Sitz des US-Präsidenten hat jetzt Internet aus dem All. Musk hat es gespendet, ein Anwalt als ethisch sauber abgenickt. Die technische Umsetzung ist zumindest skurril.
 Ungewöhnlicher gelber Schaum breitet sich an der Küste im Süden Australiens aus. Weil die Wellen auch tote Tiere an den Strand spülen und Surfer über gesundheitliche Probleme klagen, sind die Behörden alarmiert.
Ungewöhnlicher gelber Schaum breitet sich an der Küste im Süden Australiens aus. Weil die Wellen auch tote Tiere an den Strand spülen und Surfer über gesundheitliche Probleme klagen, sind die Behörden alarmiert.
 Jeder kennt das Geräusch, das beim Öffnen einer gefüllten Bügelflasche entsteht. Ein Forschungsteam untersucht den Vorgang mit Mikrofonen, Hochgeschwindigkeitskameras und selbstgebrautem Ingwerbier genauer und entdeckt einige verblüffende Details.
Jeder kennt das Geräusch, das beim Öffnen einer gefüllten Bügelflasche entsteht. Ein Forschungsteam untersucht den Vorgang mit Mikrofonen, Hochgeschwindigkeitskameras und selbstgebrautem Ingwerbier genauer und entdeckt einige verblüffende Details.
 Ein Geschenk oder NS-Raubgut? Diese Frage stellt sich ein Forschungsteam des Deutschen Museums in München, nachdem es ein Jagdflugzeug aus der Flugwerft Schleißheim genauer unter die Lupe nimmt. Obwohl es aktuell noch kein abschließendes Ergebnis gibt, wird der Flieger in Zukunft in den Niederlanden zu sehen sein.
Ein Geschenk oder NS-Raubgut? Diese Frage stellt sich ein Forschungsteam des Deutschen Museums in München, nachdem es ein Jagdflugzeug aus der Flugwerft Schleißheim genauer unter die Lupe nimmt. Obwohl es aktuell noch kein abschließendes Ergebnis gibt, wird der Flieger in Zukunft in den Niederlanden zu sehen sein.
 Viele Fans der "Assassin's Creed"-Reihe sind chronisch sauer. Die Gründe für den Ärger sind so vielfältig wie die Erwartungen an den neuen Ableger "Shadows". Das Japan-Abenteuer macht manches neu, vieles gut und wird doch einige Probleme, an denen die Reihe krankt, nicht los.
Viele Fans der "Assassin's Creed"-Reihe sind chronisch sauer. Die Gründe für den Ärger sind so vielfältig wie die Erwartungen an den neuen Ableger "Shadows". Das Japan-Abenteuer macht manches neu, vieles gut und wird doch einige Probleme, an denen die Reihe krankt, nicht los.
 Nach einigen Verschiebungen erscheint am Donnerstag ein neues »Assassin’s Creed«. Haben es die Macher noch drauf? Wir haben den Blockbuster vorab gespielt und beantworten zehn wichtige Fragen.
Nach einigen Verschiebungen erscheint am Donnerstag ein neues »Assassin’s Creed«. Haben es die Macher noch drauf? Wir haben den Blockbuster vorab gespielt und beantworten zehn wichtige Fragen.
 Ein Start-up plant für 2028 die Geburt eines Mammuts. Zuletzt hat die Firma immerhin flauschige Mäuse erschaffen. Wer steckt hinter der Idee und was kann daraus werden? SPIEGEL-Redakteur Johann Grolle ordnet den Plan ein.
Ein Start-up plant für 2028 die Geburt eines Mammuts. Zuletzt hat die Firma immerhin flauschige Mäuse erschaffen. Wer steckt hinter der Idee und was kann daraus werden? SPIEGEL-Redakteur Johann Grolle ordnet den Plan ein.
 Ein Start-up plant für 2028 die Geburt eines Mammuts. Zuletzt hat die Firma immerhin flauschige Mäuse erschaffen. Wer steckt hinter der Idee – und was kann daraus werden? SPIEGEL-Redakteur Johann Grolle ordnet den Plan ein.
Ein Start-up plant für 2028 die Geburt eines Mammuts. Zuletzt hat die Firma immerhin flauschige Mäuse erschaffen. Wer steckt hinter der Idee – und was kann daraus werden? SPIEGEL-Redakteur Johann Grolle ordnet den Plan ein.
 Stiftung Warentest wirft einen schnellen Blick auf das iPhone 16E. Die Prüfer finden es in vielen Punkten dem normalen 16er ebenbürtig, in einigen sogar besser. Nur eine Eigenschaft der Vorgänger vermissen sie bei Apples neuem "Billig-Smartphone".
Stiftung Warentest wirft einen schnellen Blick auf das iPhone 16E. Die Prüfer finden es in vielen Punkten dem normalen 16er ebenbürtig, in einigen sogar besser. Nur eine Eigenschaft der Vorgänger vermissen sie bei Apples neuem "Billig-Smartphone".
 Sie sollten nur eine Woche im All bleiben, am Ende waren es neun Monate. Nun sind die Nasa-Astronauten Butch Wilmore und Suni Williams endlich wieder zurück auf der Erde. An die Schwerkraft müssen sie sich aber noch gewöhnen.
Sie sollten nur eine Woche im All bleiben, am Ende waren es neun Monate. Nun sind die Nasa-Astronauten Butch Wilmore und Suni Williams endlich wieder zurück auf der Erde. An die Schwerkraft müssen sie sich aber noch gewöhnen.
 Aus einer Woche im All wurden neun Monate – doch nun sind Butch Wilmore und Suni Williams wieder auf der Erde. Vor Floridas Küste wartete ein besonderes Empfangskomitee auf eine Raumkapsel »voller Grinsen«.
Aus einer Woche im All wurden neun Monate – doch nun sind Butch Wilmore und Suni Williams wieder auf der Erde. Vor Floridas Küste wartete ein besonderes Empfangskomitee auf eine Raumkapsel »voller Grinsen«.
 Der Einsatz künstlicher Intelligenz fordert immer mehr Rechenleistung. Dem will US-Branchenprimus Nvidia mit einem neuen Chip begegnen. Damit soll es auch gelingen, die Kosten von KI-Software zu senken.
Der Einsatz künstlicher Intelligenz fordert immer mehr Rechenleistung. Dem will US-Branchenprimus Nvidia mit einem neuen Chip begegnen. Damit soll es auch gelingen, die Kosten von KI-Software zu senken.
 Die Astronauten Suni Williams und Butch Wilmore sind nach 286 Tagen von der ISS zurück. Für den Körper ist so ein Aufenthalt eine immense Herausforderung, was dabei genau geschieht ist auch Ärzten noch ein Rätsel.
Die Astronauten Suni Williams und Butch Wilmore sind nach 286 Tagen von der ISS zurück. Für den Körper ist so ein Aufenthalt eine immense Herausforderung, was dabei genau geschieht ist auch Ärzten noch ein Rätsel.
 2024 steigen die Temperaturen weltweit erstmals über die neuralgische Marke von 1,5 Grad im Vergleich zum vorindustriellen Zeitalter. Das hat laut UN-Wetterorganisation Folgen: Die Ozeane übersäuern zunehmend. Zudem steigt der Meeresspiegel schneller als in den 90er Jahren.
2024 steigen die Temperaturen weltweit erstmals über die neuralgische Marke von 1,5 Grad im Vergleich zum vorindustriellen Zeitalter. Das hat laut UN-Wetterorganisation Folgen: Die Ozeane übersäuern zunehmend. Zudem steigt der Meeresspiegel schneller als in den 90er Jahren.
 Aale sind eine bedrohte Art, ihr Bestand ist in Europa massiv gesunken. In Berliner Gewässern werden daher Millionen von ihnen ausgesetzt. Die Berliner Flüsse münden in die Elbe, über die erwachsene Aale zu ihrem Laichgebiet in der Sargassosee schwimmen können.
Aale sind eine bedrohte Art, ihr Bestand ist in Europa massiv gesunken. In Berliner Gewässern werden daher Millionen von ihnen ausgesetzt. Die Berliner Flüsse münden in die Elbe, über die erwachsene Aale zu ihrem Laichgebiet in der Sargassosee schwimmen können.
 Neun Monate haben sie auf der ISS festgesessen, jetzt sind Butch Wilmore und Suni Williams auf die Erde zurückgekehrt. In einer Dragon-Kapsel von SpaceX landeten sie vor der Küste des US-Bundesstaates Florida auf dem Wasser.
Neun Monate haben sie auf der ISS festgesessen, jetzt sind Butch Wilmore und Suni Williams auf die Erde zurückgekehrt. In einer Dragon-Kapsel von SpaceX landeten sie vor der Küste des US-Bundesstaates Florida auf dem Wasser.
 Es sind die ersten hochauflösenden Bilder dieser Art. Die US-Landefähre Blue Ghost sammelte wissenschaftliche Daten, dann ging ihr die Energie aus. Die Forscher hoffen auf einen Neustart nach der langen Mondnacht.
Es sind die ersten hochauflösenden Bilder dieser Art. Die US-Landefähre Blue Ghost sammelte wissenschaftliche Daten, dann ging ihr die Energie aus. Die Forscher hoffen auf einen Neustart nach der langen Mondnacht.
 Die ersten Datenmengen besitzen die Größe von 200 Tagen HD-Videostreams: Die Raumfahrtbehörde Esa stellt Beobachtungen der Raumsonde »Euclid« vor. Dabei geht es um die Ausdehnung des Universums. Und um dunkle Energie.
Die ersten Datenmengen besitzen die Größe von 200 Tagen HD-Videostreams: Die Raumfahrtbehörde Esa stellt Beobachtungen der Raumsonde »Euclid« vor. Dabei geht es um die Ausdehnung des Universums. Und um dunkle Energie.
 Die europäische Raumfahrtbehörde veröffentlicht erstmals Beobachtungsdaten der Sonde "Euclid". Diese soll eine 3D-Karte des Universums erstellen und Erkenntnisse über dunkle Materie und Energie liefern. Die enorme Menge an neuen Informationen begeistert die Forscher.
Die europäische Raumfahrtbehörde veröffentlicht erstmals Beobachtungsdaten der Sonde "Euclid". Diese soll eine 3D-Karte des Universums erstellen und Erkenntnisse über dunkle Materie und Energie liefern. Die enorme Menge an neuen Informationen begeistert die Forscher.
 Der Wirkstoff Imvanex wurde zum Schutz vor der Pockenkrankheit entwickelt. Doch auch gegen Mpox zeigt er Wirkung. Der mögliche Effekt einer zweiten Dosis wirft noch Fragen auf.
Der Wirkstoff Imvanex wurde zum Schutz vor der Pockenkrankheit entwickelt. Doch auch gegen Mpox zeigt er Wirkung. Der mögliche Effekt einer zweiten Dosis wirft noch Fragen auf.
 2024 war das erste Jahr, das laut Weltwetterorganisation im Schnitt mehr als 1,5 Grad wärmer war, als im vorindustriellen Mittel. Der Klimawandel führt nicht nur zu einem Anstieg der globalen Durchschnittstemperaturen, sondern hat auch immer deutlichere Auswirkungen auf Meere und Eis.
2024 war das erste Jahr, das laut Weltwetterorganisation im Schnitt mehr als 1,5 Grad wärmer war, als im vorindustriellen Mittel. Der Klimawandel führt nicht nur zu einem Anstieg der globalen Durchschnittstemperaturen, sondern hat auch immer deutlichere Auswirkungen auf Meere und Eis.
 Der Darwin-Nasenfrosch lebt eigentlich auf der chilenischen Insel Chiloé. Doch dort tobt eine verheerende Krankheit. Also startete der Londoner Zoo eine spektakuläre Rettungsaktion, um die Art zu erhalten.
Der Darwin-Nasenfrosch lebt eigentlich auf der chilenischen Insel Chiloé. Doch dort tobt eine verheerende Krankheit. Also startete der Londoner Zoo eine spektakuläre Rettungsaktion, um die Art zu erhalten.
 Vor 25.000 Jahren nutzten Mammuts offenbar ein Tal nahe dem heutigen St. Pölten als Tal als Durchzugs- und Weidegebiet. Das blieb den damals lebenden Menschen nicht verborgen. Forscher stoßen nun auf die Überreste eiszeitlicher Tier-Schlachtungen.
Vor 25.000 Jahren nutzten Mammuts offenbar ein Tal nahe dem heutigen St. Pölten als Tal als Durchzugs- und Weidegebiet. Das blieb den damals lebenden Menschen nicht verborgen. Forscher stoßen nun auf die Überreste eiszeitlicher Tier-Schlachtungen.
Masern könnten längst der Vergangenheit angehören, dank wirksamer Impfungen. Doch ein Aussterben der gefährlichen Kinderkrankheit ist derzeit nicht in Sicht - im Gegenteil: Europa verzeichnet die höchsten Fallzahlen seit 25 Jahren. Auch in Deutschland gibt es immer mehr Infektionen. Woran liegt das?
Masern könnten längst der Vergangenheit angehören, dank wirksamer Impfungen. Doch ein Aussterben der gefährlichen Kinderkrankheit ist derzeit nicht in Sicht - im Gegenteil: Europa verzeichnet die höchsten Fallzahlen seit 25 Jahren. Auch in Deutschland gibt es immer mehr Infektionen. Woran liegt das?
 Vor etwa 25.000 Jahren nutzten Mammuts offenbar ein Tal nahe dem heutigen St. Pölten als Durchzugs- und Weidegebiet. Das blieb den damals lebenden Menschen nicht verborgen. Forscher stoßen nun auf die Überreste eiszeitlicher Tier-Schlachtungen.
Vor etwa 25.000 Jahren nutzten Mammuts offenbar ein Tal nahe dem heutigen St. Pölten als Durchzugs- und Weidegebiet. Das blieb den damals lebenden Menschen nicht verborgen. Forscher stoßen nun auf die Überreste eiszeitlicher Tier-Schlachtungen.
 Auf der Erde leben 8,2 Milliarden Menschen - oder etwa doch nicht? Eine neue Studie zeigt, dass die Weltbevölkerung erheblich unterschätzt wird. Besonders ländliche Regionen sind betroffen, was weitreichende Konsequenzen für die Ressourcenzuteilung haben könnte.
Auf der Erde leben 8,2 Milliarden Menschen - oder etwa doch nicht? Eine neue Studie zeigt, dass die Weltbevölkerung erheblich unterschätzt wird. Besonders ländliche Regionen sind betroffen, was weitreichende Konsequenzen für die Ressourcenzuteilung haben könnte.
 Ein Geschenk oder NS-Raubgut? Diese Frage stellt sich ein Forschungsteam des Deutschen Museums in München, nachdem es ein Jagdflugzeug aus der Flugwerft Schleißheim genauer unter die Lupe genommen hat. Obwohl es aktuell noch kein abschließendes Ergebnis gibt, wird das Flugzeug in Zukunft in den Niederlanden zu sehen sein.
Ein Geschenk oder NS-Raubgut? Diese Frage stellt sich ein Forschungsteam des Deutschen Museums in München, nachdem es ein Jagdflugzeug aus der Flugwerft Schleißheim genauer unter die Lupe genommen hat. Obwohl es aktuell noch kein abschließendes Ergebnis gibt, wird das Flugzeug in Zukunft in den Niederlanden zu sehen sein.
 Forscher haben die 98 meistgesehenen TikTok-Videos zu ADHS untersucht. Kein einziges sei empfehlenswert, gut die Hälfte irreführend. Problematisch sei das speziell für Jugendliche, die sich selbst diagnostizieren.
Forscher haben die 98 meistgesehenen TikTok-Videos zu ADHS untersucht. Kein einziges sei empfehlenswert, gut die Hälfte irreführend. Problematisch sei das speziell für Jugendliche, die sich selbst diagnostizieren.
 Laut Kalender beginnt der Frühling erst jetzt. Dabei ist er längst da, wie blühende Haselsträucher und Forsythien verraten. Und sie zeigen Wissenschaftlern auch: Der Klimawandel verschiebt die Jahreszeiten und verkürzt den Winter.
Laut Kalender beginnt der Frühling erst jetzt. Dabei ist er längst da, wie blühende Haselsträucher und Forsythien verraten. Und sie zeigen Wissenschaftlern auch: Der Klimawandel verschiebt die Jahreszeiten und verkürzt den Winter.
 Der KI-gestützte Chatbot von Meta wird nun auch in der EU Teil von Instagram, WhatsApp, Facebook und Messenger. Bisher hatte Meta das mit Verweis auf die angeblich komplizierte Gesetzeslage nicht gewagt.
Der KI-gestützte Chatbot von Meta wird nun auch in der EU Teil von Instagram, WhatsApp, Facebook und Messenger. Bisher hatte Meta das mit Verweis auf die angeblich komplizierte Gesetzeslage nicht gewagt.
 Pinguin-Kot, der auch als Guano bezeichnet wird, riecht wie verfaulte Schalentiere. Schwärme von Krebstieren meiden bereits kleinste Mengen dieser Ausscheidungen im Wasser, finden Forschende heraus. Doch der strenge Geruch ist nicht der Grund für die fluchtartigen Bewegungen der winzigen Tiere.
Pinguin-Kot, der auch als Guano bezeichnet wird, riecht wie verfaulte Schalentiere. Schwärme von Krebstieren meiden bereits kleinste Mengen dieser Ausscheidungen im Wasser, finden Forschende heraus. Doch der strenge Geruch ist nicht der Grund für die fluchtartigen Bewegungen der winzigen Tiere.
 Nachdem sich Meta ausgiebig mit dem "komplexen Regulierungssystem der EU "auseinandergesetzt" hat, führt der US-Konzern jetzt auch in insgesamt 41 europäischen Ländern seine KI-Funktionen ein. Zunächst soll Meta AI in Whatsapp, Facebook, Instagram und Messenger als Chatbot zur Verfügung stehen.
Nachdem sich Meta ausgiebig mit dem "komplexen Regulierungssystem der EU "auseinandergesetzt" hat, führt der US-Konzern jetzt auch in insgesamt 41 europäischen Ländern seine KI-Funktionen ein. Zunächst soll Meta AI in Whatsapp, Facebook, Instagram und Messenger als Chatbot zur Verfügung stehen.
 Durch die Erforschung von Wellensittichen könnten künftige Behandlungen von Sprachstörungen vorangebracht werden. Deren Gehirne funktionieren an entscheidender Stelle offenbar ähnlich wie die der Menschen.
Durch die Erforschung von Wellensittichen könnten künftige Behandlungen von Sprachstörungen vorangebracht werden. Deren Gehirne funktionieren an entscheidender Stelle offenbar ähnlich wie die der Menschen.
 In einem Jahr geht laut Experten so viel Gletschereis verloren, dass es dem Wasserverbrauch der Weltbevölkerung innerhalb von 30 Jahren entspricht. Der Erhalt von Gletscherschmelzwasser sei essenziell für Klima, Natur und Mensch.
In einem Jahr geht laut Experten so viel Gletschereis verloren, dass es dem Wasserverbrauch der Weltbevölkerung innerhalb von 30 Jahren entspricht. Der Erhalt von Gletscherschmelzwasser sei essenziell für Klima, Natur und Mensch.
 Weltweit schrumpfen Gletscher mit alarmierender Geschwindigkeit. Eine neue Studie zeigt, wie rasant die Schmelze in den letzten Jahren geschieht - mit teils verheerenden Auswirkungen. Die Vereinten Nationen werfen nun ein Schlaglicht auf die Misere und rufen erstmals den Welttag der Gletscher aus.
Weltweit schrumpfen Gletscher mit alarmierender Geschwindigkeit. Eine neue Studie zeigt, wie rasant die Schmelze in den letzten Jahren geschieht - mit teils verheerenden Auswirkungen. Die Vereinten Nationen werfen nun ein Schlaglicht auf die Misere und rufen erstmals den Welttag der Gletscher aus.
 Ein Gericht in North Dakota verurteilt Greenpeace zu Hunderten Millionen Dollar Schadensersatz, weil die Organisation den Bau einer Pipeline behindert hat. Was heißt das für Proteste von Aktivisten in den USA und weltweit?
Ein Gericht in North Dakota verurteilt Greenpeace zu Hunderten Millionen Dollar Schadensersatz, weil die Organisation den Bau einer Pipeline behindert hat. Was heißt das für Proteste von Aktivisten in den USA und weltweit?
 Schon der Februar fällt in diesem Jahr ungewöhnlich trocken aus. Der März legt mit viel Sonne nach. Betreiber von Solaranlagen freuen sich. Doch die Natur leidet unter dem Regenmangel. Auswertungen von Wetterdaten zeigen, wo die Frühjahrsdürre am schlimmsten ist.
Schon der Februar fällt in diesem Jahr ungewöhnlich trocken aus. Der März legt mit viel Sonne nach. Betreiber von Solaranlagen freuen sich. Doch die Natur leidet unter dem Regenmangel. Auswertungen von Wetterdaten zeigen, wo die Frühjahrsdürre am schlimmsten ist.
 Es ist 20 Zentimeter groß und mit dem Känguru verwandt. Wissenschaftler in Australien haben sich mit Moschusrattenkängurus beschäftigt. Die Ergebnisse der Untersuchung könnten laut den Forschern erklären, warum sich das Känguru hüpfend fortbewegt.
Es ist 20 Zentimeter groß und mit dem Känguru verwandt. Wissenschaftler in Australien haben sich mit Moschusrattenkängurus beschäftigt. Die Ergebnisse der Untersuchung könnten laut den Forschern erklären, warum sich das Känguru hüpfend fortbewegt.
 Das Go ist das günstigste Smart Lock von Nuki, im Praxistest erweist es sich aber als nahezu ebenso gut wie die deutlich teureren Alternativen. Mit Matter gelingt auch problemlos die Integration ins Smarthome, falls man das möchte.
Das Go ist das günstigste Smart Lock von Nuki, im Praxistest erweist es sich aber als nahezu ebenso gut wie die deutlich teureren Alternativen. Mit Matter gelingt auch problemlos die Integration ins Smarthome, falls man das möchte.
 Yoga, Meditation, Kirchenbesuch: In spirituellen Momenten langweilen sich Menschen erstaunlich häufig, hat der Bildungspsychologe Thomas Götz herausgefunden. Und er warnt: Langeweile ist nicht nur unangenehm, sie ist schädlich.
Yoga, Meditation, Kirchenbesuch: In spirituellen Momenten langweilen sich Menschen erstaunlich häufig, hat der Bildungspsychologe Thomas Götz herausgefunden. Und er warnt: Langeweile ist nicht nur unangenehm, sie ist schädlich.
 Mit einer umstrittenen Verhaftung und der Drohung, Hunderte Millionen Dollar Fördergeld zu streichen, setzt die US-Regierung die Universitäten unter Druck. Experten zufolge will Donald Trump die Hochschulen mundtot machen. Es funktioniert offenbar.
Mit einer umstrittenen Verhaftung und der Drohung, Hunderte Millionen Dollar Fördergeld zu streichen, setzt die US-Regierung die Universitäten unter Druck. Experten zufolge will Donald Trump die Hochschulen mundtot machen. Es funktioniert offenbar.
 Die Unesco warnt vor den Folgen der weltweiten Gletscherschmelze. Für zwei Milliarden Menschen ist demnach die Versorgung mit Wasser und Lebensmitteln gefährdet.
Die Unesco warnt vor den Folgen der weltweiten Gletscherschmelze. Für zwei Milliarden Menschen ist demnach die Versorgung mit Wasser und Lebensmitteln gefährdet.
 Das Sexvideoportal Pornhub aus Kanada ist eine der meistbesuchten Websites der Welt. Wenn es nach einem kanadischen Comedian geht, sollen Amerikaner künftig draußen bleiben – um Donald Trump im Handelsstreit zum Einlenken zu bewegen.
Das Sexvideoportal Pornhub aus Kanada ist eine der meistbesuchten Websites der Welt. Wenn es nach einem kanadischen Comedian geht, sollen Amerikaner künftig draußen bleiben – um Donald Trump im Handelsstreit zum Einlenken zu bewegen.
 Gletschereis ist ein gigantisches Süßwasserreservoir. Seit drei Jahren schrumpfen die Eisriesen so schnell wie noch nie. Experten sehen dadurch gleich mehrere Katastrophen auf die Menschheit zukommen.
Gletschereis ist ein gigantisches Süßwasserreservoir. Seit drei Jahren schrumpfen die Eisriesen so schnell wie noch nie. Experten sehen dadurch gleich mehrere Katastrophen auf die Menschheit zukommen.
 Wald ist nicht nur schön anzusehen, er kann auch Rückzugsort sein und Kraft geben. Man kann regelrecht darin baden. Doch wie funktioniert das? Und wie kann man die Natur in den Alltag holen, wenn sie eigentlich gerade weit weg ist? Zwei Expertinnen wissen Rat.
Wald ist nicht nur schön anzusehen, er kann auch Rückzugsort sein und Kraft geben. Man kann regelrecht darin baden. Doch wie funktioniert das? Und wie kann man die Natur in den Alltag holen, wenn sie eigentlich gerade weit weg ist? Zwei Expertinnen wissen Rat.
 Große Hammerhaie sind vom Aussterben bedroht. Wissenschaftler haben sie in den Gewässern der Bahamas untersucht und dabei herausgefunden: Einige der Langstreckenwanderer sind dort zu Stubenhockern geworden.
Große Hammerhaie sind vom Aussterben bedroht. Wissenschaftler haben sie in den Gewässern der Bahamas untersucht und dabei herausgefunden: Einige der Langstreckenwanderer sind dort zu Stubenhockern geworden.
 Sensible Daten von Dutzenden US-Bürgern stehen offen im Netz, weil die Trump-Regierung die nun freigegebenen Akten zum Mord an John F. Kennedy unzureichend geschwärzt hat. Die Opfer wollen sich wehren.
Sensible Daten von Dutzenden US-Bürgern stehen offen im Netz, weil die Trump-Regierung die nun freigegebenen Akten zum Mord an John F. Kennedy unzureichend geschwärzt hat. Die Opfer wollen sich wehren.
 Am Montag könnte die erste komplette Rakete des bayrischen Start-ups Isar Aerospace abheben. Der Erfolg wird in gesammelten Daten gemessen, eine Explosion wird von den Entwicklern sogar erwartet.
Am Montag könnte die erste komplette Rakete des bayrischen Start-ups Isar Aerospace abheben. Der Erfolg wird in gesammelten Daten gemessen, eine Explosion wird von den Entwicklern sogar erwartet.
 Die Bahamas sind nicht nur bei Menschen bliebt. Auch große Hammerhaie sieht man immer öfter in der Region. Eigentlich wandern die Tiere weite Strecken. Aber ihre Population wird bedroht. Das Verständnis über die Bewegungsmuster der Tiere ist wichtig, um Schutzmaßnahmen zu verbessern.
Die Bahamas sind nicht nur bei Menschen bliebt. Auch große Hammerhaie sieht man immer öfter in der Region. Eigentlich wandern die Tiere weite Strecken. Aber ihre Population wird bedroht. Das Verständnis über die Bewegungsmuster der Tiere ist wichtig, um Schutzmaßnahmen zu verbessern.
 Wald ist nicht nur schön anzusehen, er ist auch Rückzugsort und gibt Kraft. Man kann regelrecht darin baden. Doch wie funktioniert das? Und wie kann man die Natur in den Alltag holen, wenn sie eigentlich gerade weit weg ist? Zwei Expertinnen wissen Rat.
Wald ist nicht nur schön anzusehen, er ist auch Rückzugsort und gibt Kraft. Man kann regelrecht darin baden. Doch wie funktioniert das? Und wie kann man die Natur in den Alltag holen, wenn sie eigentlich gerade weit weg ist? Zwei Expertinnen wissen Rat.
 Nichts geht mehr: Ein Stromausfall hat den Flugverkehr am Londoner Airport Heathrow gestoppt. Auslöser war ein Brand. Experten haben eine Vermutung, wie es dazu kam und warum die Folgen so immens sind.
Nichts geht mehr: Ein Stromausfall hat den Flugverkehr am Londoner Airport Heathrow gestoppt. Auslöser war ein Brand. Experten haben eine Vermutung, wie es dazu kam und warum die Folgen so immens sind.
 Britische Forscher präsentieren Ellmer, ein fortschrittliches KI-Robotersystem. Ellmer kann auf menschliche Anweisungen hin komplexe Aufgaben wie Kaffeekochen oder das Dekorieren von Tellern ausführen. Die Technologie ist ein Blick in die Zukunft.
Britische Forscher präsentieren Ellmer, ein fortschrittliches KI-Robotersystem. Ellmer kann auf menschliche Anweisungen hin komplexe Aufgaben wie Kaffeekochen oder das Dekorieren von Tellern ausführen. Die Technologie ist ein Blick in die Zukunft.
 Forscher von vier Hochschulen können möglicherweise denjenigen Trost spenden, denen der Einlass in angesagte Klubs in Berlin verwehrt bleibt: Das Kriterium für die Auswahl der Gäste ist laut einer Studie nämlich ein Paradoxon.
Forscher von vier Hochschulen können möglicherweise denjenigen Trost spenden, denen der Einlass in angesagte Klubs in Berlin verwehrt bleibt: Das Kriterium für die Auswahl der Gäste ist laut einer Studie nämlich ein Paradoxon.
 Das Xiaomi 15 Ultra ist aktuell eines der besten Smartphones, vor allem die Zoom-Fähigkeiten seiner mächtigen Vierfachkamera sind beeindruckend. Die weitere technische Ausstattung ist ebenfalls top, und das Gerät kann es auch mit dem Galaxy S25 Ultra aufnehmen. In einem Punkt ist Xiaomi aber zu zurückhaltend.
Das Xiaomi 15 Ultra ist aktuell eines der besten Smartphones, vor allem die Zoom-Fähigkeiten seiner mächtigen Vierfachkamera sind beeindruckend. Die weitere technische Ausstattung ist ebenfalls top, und das Gerät kann es auch mit dem Galaxy S25 Ultra aufnehmen. In einem Punkt ist Xiaomi aber zu zurückhaltend.
 Maria Branyas Morera ist 117 Jahre und 168 Tage alt, als sie stirbt. Sie wird damit als Supercentenarian bezeichnet und ist für die Wissenschaft hoch interessant. Forschende untersuchen zahlreiche Proben der Frau und finden nun die Kriterien, die Maria zu ihrem außergewöhnlich langen Leben verhalfen.
Maria Branyas Morera ist 117 Jahre und 168 Tage alt, als sie stirbt. Sie wird damit als Supercentenarian bezeichnet und ist für die Wissenschaft hoch interessant. Forschende untersuchen zahlreiche Proben der Frau und finden nun die Kriterien, die Maria zu ihrem außergewöhnlich langen Leben verhalfen.
 Vor genau fünf Jahren trat der erste Lockdown der Coronapandemie in Kraft. Hier erzählen acht Prominente, Wissenschaftler und Politiker, wie sie die Zeit erlebt haben und was sie bis heute persönlich beschäftigt.
Vor genau fünf Jahren trat der erste Lockdown der Coronapandemie in Kraft. Hier erzählen acht Prominente, Wissenschaftler und Politiker, wie sie die Zeit erlebt haben und was sie bis heute persönlich beschäftigt.
 Haustiere tragen deutlich zur Belastung der Umwelt bei, vor allem durch ihr Futter, aber auch durch Kot und Urin. "Das Ausmaß hat uns überrascht", sagt ein Forscher. Aber kann man Hunde auch rein pflanzlich ernähren, ist es gesund für die Tiere?
Haustiere tragen deutlich zur Belastung der Umwelt bei, vor allem durch ihr Futter, aber auch durch Kot und Urin. "Das Ausmaß hat uns überrascht", sagt ein Forscher. Aber kann man Hunde auch rein pflanzlich ernähren, ist es gesund für die Tiere?
 Vor der neuseeländischen Nordküste suchen Wissenschaftler im Dezember 2023 nach Fressgelagen im Meer. Plötzlich fällt ihnen ein bunter Farbklecks auf dem Kopf eines Hais auf. Eine Boje? Nein. Beim genaueren Hinschauen stellt sich der orangefarbene Fleck als Oktopus heraus.
Vor der neuseeländischen Nordküste suchen Wissenschaftler im Dezember 2023 nach Fressgelagen im Meer. Plötzlich fällt ihnen ein bunter Farbklecks auf dem Kopf eines Hais auf. Eine Boje? Nein. Beim genaueren Hinschauen stellt sich der orangefarbene Fleck als Oktopus heraus.
 Nach angedrohten Millionenkürzungen durch die US-Regierung knickt die Columbia University ein und verspricht, Richtlinien zu überarbeiten. Der Schritt könnte weitreichende Folgen haben – Dutzende Universitäten stehen unter Druck.
Nach angedrohten Millionenkürzungen durch die US-Regierung knickt die Columbia University ein und verspricht, Richtlinien zu überarbeiten. Der Schritt könnte weitreichende Folgen haben – Dutzende Universitäten stehen unter Druck.
 Der Kölner Intensivmediziner veröffentlichte in der Pandemie, wie viele Intensivbetten in Deutschland noch frei waren. Die Zahl wurde zu einem Gradmesser dafür, wie viele Menschen schwer erkrankt waren.
Der Kölner Intensivmediziner veröffentlichte in der Pandemie, wie viele Intensivbetten in Deutschland noch frei waren. Die Zahl wurde zu einem Gradmesser dafür, wie viele Menschen schwer erkrankt waren.
 Die Virologin Sandra Ciesek wurde in der Pandemie durch den Podcast »Coronavirus-Update« bekannt. Mit Sorge beobachtet sie, wie einige Menschen die Seuche bis heute zu einer harmlosen Krankheit umdeuten.
Die Virologin Sandra Ciesek wurde in der Pandemie durch den Podcast »Coronavirus-Update« bekannt. Mit Sorge beobachtet sie, wie einige Menschen die Seuche bis heute zu einer harmlosen Krankheit umdeuten.
 Der Bonner Virologe polarisierte in der Pandemie mit Vorschlägen, die das öffentliche Leben weniger eingeschränkt hätten als die Maßnahmen der Regierung. Heute ist er selbst Politiker.
Der Bonner Virologe polarisierte in der Pandemie mit Vorschlägen, die das öffentliche Leben weniger eingeschränkt hätten als die Maßnahmen der Regierung. Heute ist er selbst Politiker.
 Sie ist 38, hat einen Gehstock und liegt den größten Teil des Tages im Bett. Seit ihrer Coronainfektion leidet die SPIEGEL-Kolumnistin Margarete Stokowski an Long Covid.
Sie ist 38, hat einen Gehstock und liegt den größten Teil des Tages im Bett. Seit ihrer Coronainfektion leidet die SPIEGEL-Kolumnistin Margarete Stokowski an Long Covid.
 Die Braunschweiger Professorin Melanie Brinkmann machte in der Coronakrise konkrete Vorschläge, um die Pandemie unter Kontrolle zu bringen. Dafür wurde sie heftig angefeindet. Heute plädiert sie dafür, die Zeit aufzuarbeiten.
Die Braunschweiger Professorin Melanie Brinkmann machte in der Coronakrise konkrete Vorschläge, um die Pandemie unter Kontrolle zu bringen. Dafür wurde sie heftig angefeindet. Heute plädiert sie dafür, die Zeit aufzuarbeiten.
 Der Lungenfacharzt Leif Erik Sander forscht an der Berliner Charité zu Covid-19. Er erinnert sich an Tage ohne Feierabend und einen riskanten Tweet zum Impfstoff von AstraZeneca.
Der Lungenfacharzt Leif Erik Sander forscht an der Berliner Charité zu Covid-19. Er erinnert sich an Tage ohne Feierabend und einen riskanten Tweet zum Impfstoff von AstraZeneca.
 Der Virologe aus Neu-Ulm war zu Pandemiezeiten der Chef der Ständigen Impfkommission. Das Gremium hat damals auch die Empfehlungen dafür erarbeitet, wer wann gegen Corona geimpft werden durfte.
Der Virologe aus Neu-Ulm war zu Pandemiezeiten der Chef der Ständigen Impfkommission. Das Gremium hat damals auch die Empfehlungen dafür erarbeitet, wer wann gegen Corona geimpft werden durfte.
 Der CDU-Politiker Jens Spahn wurde als Gesundheitsminister während der Pandemie zum beliebtesten und gleichzeitig zum umstrittensten Kabinettsmitglied der Bundesregierung.
Der CDU-Politiker Jens Spahn wurde als Gesundheitsminister während der Pandemie zum beliebtesten und gleichzeitig zum umstrittensten Kabinettsmitglied der Bundesregierung.
 Für die Trinkwasserversorgung in Deutschland sind Talsperren ein wichtiger Baustein. Doch steigende Temperaturen wirken sich zunehmend auf die Wasserqualität aus. Forscher warnen nun vor Sauerstoffmangel und schädlichen Substanzen. Lässt sich gegensteuern?
Für die Trinkwasserversorgung in Deutschland sind Talsperren ein wichtiger Baustein. Doch steigende Temperaturen wirken sich zunehmend auf die Wasserqualität aus. Forscher warnen nun vor Sauerstoffmangel und schädlichen Substanzen. Lässt sich gegensteuern?
 Am 29. März schiebt sich der Mond vor die Sonne – zumindest ein bisschen. Ein solches Himmelsschauspiel ist recht selten. Was gibt es beim Zuschauen zu beachten?
Am 29. März schiebt sich der Mond vor die Sonne – zumindest ein bisschen. Ein solches Himmelsschauspiel ist recht selten. Was gibt es beim Zuschauen zu beachten?
 Am 27. März schickt die Europäische Weltraumorganisation die Raumsonde »Gaia« auf eine Friedhofsbahn. Obwohl das Gerät kaum jemand kennt, hat es die Astronomie revolutioniert.
Am 27. März schickt die Europäische Weltraumorganisation die Raumsonde »Gaia« auf eine Friedhofsbahn. Obwohl das Gerät kaum jemand kennt, hat es die Astronomie revolutioniert.
 Vor einem Jahr werden erstmals Vogelgrippeviren in Kühen in den USA nachgewiesen. Seitdem grassiert das Virus und befällt neben Vögeln auch eine Reihe von Säugetierarten - und Menschen. Experten und Expertinnen sind besorgt. Die wichtigsten Antworten zu H5N1 sind hier zusammengefasst.
Vor einem Jahr werden erstmals Vogelgrippeviren in Kühen in den USA nachgewiesen. Seitdem grassiert das Virus und befällt neben Vögeln auch eine Reihe von Säugetierarten - und Menschen. Experten und Expertinnen sind besorgt. Die wichtigsten Antworten zu H5N1 sind hier zusammengefasst.
 Donald Trump verwandelt sein Land in einen autokratischen Staat, warnt Harvard-Professor Steven Levitsky, Autor des Bestsellers »Wie Demokratien sterben«. Er sagt: Die Gründerväter der USA haben eine wichtige Entwicklung nicht vorhergesehen.
Donald Trump verwandelt sein Land in einen autokratischen Staat, warnt Harvard-Professor Steven Levitsky, Autor des Bestsellers »Wie Demokratien sterben«. Er sagt: Die Gründerväter der USA haben eine wichtige Entwicklung nicht vorhergesehen.
 In der Türkei gehen Tausende Menschen auf die Straße, um gegen die Festnahme des Istanbuler Bürgermeisters zu protestieren. Auf X können sie sich dabei laut Berichten nicht verlassen.
In der Türkei gehen Tausende Menschen auf die Straße, um gegen die Festnahme des Istanbuler Bürgermeisters zu protestieren. Auf X können sie sich dabei laut Berichten nicht verlassen.
 Viele Fans der "Assassin's Creed"-Reihe sind chronisch sauer. Die Gründe für den Ärger sind so vielfältig wie die Erwartungen an den neuen Ableger "Shadows". Das Japan-Abenteuer macht manches neu, vieles gut und wird doch einige Probleme, an denen die Reihe krankt, nicht los.
Viele Fans der "Assassin's Creed"-Reihe sind chronisch sauer. Die Gründe für den Ärger sind so vielfältig wie die Erwartungen an den neuen Ableger "Shadows". Das Japan-Abenteuer macht manches neu, vieles gut und wird doch einige Probleme, an denen die Reihe krankt, nicht los.
 Millionen Tuberkulose-Patienten wurden in den vergangenen Jahren durch eine frühe Behandlung gerettet. Doch diese Erfolge stehen auf dem Spiel, warnt die WHO. Denn nicht nur die USA geben weniger für Entwicklungshilfe aus.
Millionen Tuberkulose-Patienten wurden in den vergangenen Jahren durch eine frühe Behandlung gerettet. Doch diese Erfolge stehen auf dem Spiel, warnt die WHO. Denn nicht nur die USA geben weniger für Entwicklungshilfe aus.
 Sie sind gerade einmal einen halben Millimeter breit und etwa drei Zentimeter lang. Doch wenn sie sich aneinander reihen, bilden sie Bänder mit bis zu zehn Metern Länge. Diese seltsamen Formationen entdecken Forscher in mehreren Wüstengebieten. Sie sehen sie als ein Hinweis auf eine unbekannte Lebensform.
Sie sind gerade einmal einen halben Millimeter breit und etwa drei Zentimeter lang. Doch wenn sie sich aneinander reihen, bilden sie Bänder mit bis zu zehn Metern Länge. Diese seltsamen Formationen entdecken Forscher in mehreren Wüstengebieten. Sie sehen sie als ein Hinweis auf eine unbekannte Lebensform.
 Das nördliche Great Barrier Reef ist nach der Massenbleiche im vergangenen Jahr schon wieder betroffen, schlimmer trifft es dieses Jahr das Ningaloo Reef an der Westküste. »Herzzerreißend« findet das eine Forscherin.
Das nördliche Great Barrier Reef ist nach der Massenbleiche im vergangenen Jahr schon wieder betroffen, schlimmer trifft es dieses Jahr das Ningaloo Reef an der Westküste. »Herzzerreißend« findet das eine Forscherin.
 Unter anderem die USA kürzen ihre Entwicklungshilfe. Auch für den Kampf gegen die Infektionskrankheit Tuberkulose fehlt jetzt Geld. Das könnte dramatische Folgen haben, warnt die WHO. Millionen Menschenleben seien gefährdet - nicht nur in armen Ländern.
Unter anderem die USA kürzen ihre Entwicklungshilfe. Auch für den Kampf gegen die Infektionskrankheit Tuberkulose fehlt jetzt Geld. Das könnte dramatische Folgen haben, warnt die WHO. Millionen Menschenleben seien gefährdet - nicht nur in armen Ländern.
 Britische Behörden haben den ersten Fall von Vogelgrippe bei einem Schaf entdeckt. Was ist der Stand, und wie gefährlich ist das Virus für Menschen?
Britische Behörden haben den ersten Fall von Vogelgrippe bei einem Schaf entdeckt. Was ist der Stand, und wie gefährlich ist das Virus für Menschen?
 Millionen Tuberkulosepatienten wurden in den vergangenen Jahren durch eine frühe Behandlung gerettet. Doch diese Erfolge stehen auf dem Spiel, warnt die WHO. Denn nicht nur die USA geben weniger für Entwicklungshilfe aus.
Millionen Tuberkulosepatienten wurden in den vergangenen Jahren durch eine frühe Behandlung gerettet. Doch diese Erfolge stehen auf dem Spiel, warnt die WHO. Denn nicht nur die USA geben weniger für Entwicklungshilfe aus.
 Der Mobilfunkausbau in der Fläche soll vorangetrieben werden. Die Bundesnetzagentur verlängert kostenlos die Lizenzen von drei Providern. Die müssen dafür investieren.
Der Mobilfunkausbau in der Fläche soll vorangetrieben werden. Die Bundesnetzagentur verlängert kostenlos die Lizenzen von drei Providern. Die müssen dafür investieren.
 Daten und Fotos vom Smartphone löschen, Accounts sperren, Laptop-Festplatten verschlüsseln: Welche Vorsichtsmaßnahmen sind sinnvoll, falls US-Grenzbeamte die Geräte durchsuchen wollen?
Daten und Fotos vom Smartphone löschen, Accounts sperren, Laptop-Festplatten verschlüsseln: Welche Vorsichtsmaßnahmen sind sinnvoll, falls US-Grenzbeamte die Geräte durchsuchen wollen?
 Das deutsche Start-up Isar Aerospace will künftig regelmäßig Satelliten mit seinen Trägerraketen ins All schicken. Doch zunächst stehen Testflüge an. Der erste soll heute in Norwegen über die Bühne gehen, scheitert aber am Wetter. Lange warten will das Unternehmen aber nicht.
Das deutsche Start-up Isar Aerospace will künftig regelmäßig Satelliten mit seinen Trägerraketen ins All schicken. Doch zunächst stehen Testflüge an. Der erste soll heute in Norwegen über die Bühne gehen, scheitert aber am Wetter. Lange warten will das Unternehmen aber nicht.
 Alt werden wollen viele - vor allem: gesund alt werden. Welche Ernährung die Wahrscheinlichkeit, mit 70 oder 75 Jahren noch gesund zu sein, deutlich steigert, zeigt eine internationale Studie. Sie basiert auf Daten, die seit 1976 von mehr als 100.000 Menschen gesammelt wurden.
Alt werden wollen viele - vor allem: gesund alt werden. Welche Ernährung die Wahrscheinlichkeit, mit 70 oder 75 Jahren noch gesund zu sein, deutlich steigert, zeigt eine internationale Studie. Sie basiert auf Daten, die seit 1976 von mehr als 100.000 Menschen gesammelt wurden.
 Wer einen Highspeed-Router für den Anschluss an ein bestehendes Modem sucht, wird mit der neuen Fritzbox 4690 bestens bedient. Er überträgt Daten rasend schnell über Wi-Fi 7 oder LAN-Kabel. Für manche Nutzer ist das Gerät allerdings zu schwach ausgestattet.
Wer einen Highspeed-Router für den Anschluss an ein bestehendes Modem sucht, wird mit der neuen Fritzbox 4690 bestens bedient. Er überträgt Daten rasend schnell über Wi-Fi 7 oder LAN-Kabel. Für manche Nutzer ist das Gerät allerdings zu schwach ausgestattet.
 In Großbritannien wird erstmals die Vogelgrippe bei einem Schaf nachgewiesen. Das Virus wird bei einem Tier in der Grafschaft Yorkshire entdeckt. Britische Behörden zerstreuen Sorgen um eine weitere Ausbreitung.
In Großbritannien wird erstmals die Vogelgrippe bei einem Schaf nachgewiesen. Das Virus wird bei einem Tier in der Grafschaft Yorkshire entdeckt. Britische Behörden zerstreuen Sorgen um eine weitere Ausbreitung.
 Rund neun Monate saßen zwei US-Astronauten auf der ISS fest. Der Nasa zufolge haben die beiden ein Gehalt für eine 40-Stunden-Woche erhalten. Donald Trump hat sich zur Frage ihrer Überstunden geäußert.
Rund neun Monate saßen zwei US-Astronauten auf der ISS fest. Der Nasa zufolge haben die beiden ein Gehalt für eine 40-Stunden-Woche erhalten. Donald Trump hat sich zur Frage ihrer Überstunden geäußert.
 Die Dienstreise der beiden US-Astronauten Williams und Wilmore zur ISS dauert länger als geplant: fast neun Monate statt nur wenige Tage. Die Nasa vergütet die längere Einsatzzeit nicht als Überstunden. US-Präsident Trump verspricht einzuspringen - auch wenn er die Schuld bei seinem Vorgänger Biden sieht.
Die Dienstreise der beiden US-Astronauten Williams und Wilmore zur ISS dauert länger als geplant: fast neun Monate statt nur wenige Tage. Die Nasa vergütet die längere Einsatzzeit nicht als Überstunden. US-Präsident Trump verspricht einzuspringen - auch wenn er die Schuld bei seinem Vorgänger Biden sieht.
 Seit der Teillegalisierung von Cannabis registriert die Charite einen Anstieg des Konsums bei Menschen, die bereits psychisch vorbelastet sind. Auch Studien aus Kanada zeigen, dass die Folgen gravierend sein könnten. Der Experte kann der Liberalisierung aus psychiatrischer Perspektive kaum Positives abgewinnen
Seit der Teillegalisierung von Cannabis registriert die Charite einen Anstieg des Konsums bei Menschen, die bereits psychisch vorbelastet sind. Auch Studien aus Kanada zeigen, dass die Folgen gravierend sein könnten. Der Experte kann der Liberalisierung aus psychiatrischer Perspektive kaum Positives abgewinnen
 Vor einem Jahr geht die Nachricht um die Welt: In den USA wird erstmals eine Vogelgrippe-Infektion bei einer Milchkuh nachgewiesen. Seitdem breitet sich dort H5N1 unter den Tieren rasant aus. Warum das Land den Ausbruch nicht in den Griff bekommt und ob die nächste Pandemie droht, erklärt Virologe Schwemmle im Interview mit ntv.de.
Vor einem Jahr geht die Nachricht um die Welt: In den USA wird erstmals eine Vogelgrippe-Infektion bei einer Milchkuh nachgewiesen. Seitdem breitet sich dort H5N1 unter den Tieren rasant aus. Warum das Land den Ausbruch nicht in den Griff bekommt und ob die nächste Pandemie droht, erklärt Virologe Schwemmle im Interview mit ntv.de.
 Demütigung der Eliten, Abschiebungen, Anti-Wokeness: Mit dem Angriff auf die Universitäten kann Trump mehrere Schlachten gleichzeitig führen. Die Entwicklung erinnert an die Gleichschaltung der Universitäten 1933 in Deutschland.
Demütigung der Eliten, Abschiebungen, Anti-Wokeness: Mit dem Angriff auf die Universitäten kann Trump mehrere Schlachten gleichzeitig führen. Die Entwicklung erinnert an die Gleichschaltung der Universitäten 1933 in Deutschland.
 Ein junger Pottwal wird Mitte Februar tot vor der Küste Sylts geborgen. Seitdem untersuchen Wissenschaftler den tonnenschweren Kadaver. Jetzt finden sie die Ursache für den Tod des gigantischen Tieres. Die Analysen sind damit aber noch nicht abgeschlossen.
Ein junger Pottwal wird Mitte Februar tot vor der Küste Sylts geborgen. Seitdem untersuchen Wissenschaftler den tonnenschweren Kadaver. Jetzt finden sie die Ursache für den Tod des gigantischen Tieres. Die Analysen sind damit aber noch nicht abgeschlossen.
 Die Messenger-App Signal ist für ihre Sicherheit bekannt und wurde einst von einem staatskritischen Aktivisten entwickelt. Warum es trotzdem ein Problem ist, wenn die US-Regierung sie zur Planung von Militärschlägen nutzt.
Die Messenger-App Signal ist für ihre Sicherheit bekannt und wurde einst von einem staatskritischen Aktivisten entwickelt. Warum es trotzdem ein Problem ist, wenn die US-Regierung sie zur Planung von Militärschlägen nutzt.
 Ein Metallsucher ist in England auf einen 300.000-Euro-Schatz gestoßen. Der Fund von Pferdegeschirr, Zeremonienspeere und Eisenreifen zeigt laut Fachleuten, dass der Norden der Nation vor 2000 Jahren »definitiv kein Hinterland« war.
Ein Metallsucher ist in England auf einen 300.000-Euro-Schatz gestoßen. Der Fund von Pferdegeschirr, Zeremonienspeere und Eisenreifen zeigt laut Fachleuten, dass der Norden der Nation vor 2000 Jahren »definitiv kein Hinterland« war.
 Britische Archäologen melden die Entdeckung eines riesigen Schatzes aus der Eisenzeit in Nordengland. Ein Hobby-Archäologe hatte diesen mit Hilfe eines Metalldetektors aufgespürt. Der Fund stammt aus der Zeit um Jesu Geburt.
Britische Archäologen melden die Entdeckung eines riesigen Schatzes aus der Eisenzeit in Nordengland. Ein Hobby-Archäologe hatte diesen mit Hilfe eines Metalldetektors aufgespürt. Der Fund stammt aus der Zeit um Jesu Geburt.
 Ein Schlagabtausch zwischen Elon Musk und Polens Außenminister hat Warschau veranlasst, Zahlen zu nennen: Damit die Ukraine Starlink nutzen kann, hat Polen 77 Millionen Euro gezahlt. Weitere Millionen sollen folgen.
Ein Schlagabtausch zwischen Elon Musk und Polens Außenminister hat Warschau veranlasst, Zahlen zu nennen: Damit die Ukraine Starlink nutzen kann, hat Polen 77 Millionen Euro gezahlt. Weitere Millionen sollen folgen.
 Offenbar wollte ein 38-Jähriger heimliche Aufnahmen in der Umkleidekabine eines Bekleidungsgeschäfts machen. Doch die von ihm installierte Kamera wurde schnell entdeckt – und verriet ihn letztlich.
Offenbar wollte ein 38-Jähriger heimliche Aufnahmen in der Umkleidekabine eines Bekleidungsgeschäfts machen. Doch die von ihm installierte Kamera wurde schnell entdeckt – und verriet ihn letztlich.
 Seit Ende 2013 hat die Esa-Sonde "Gaia" Himmelskörper in der Milchstraße beobachtet - mit drei Billionen Observationen und teils "spektakulären Resultaten". Dank ihr wissen wir, dass unsere Galaxie ganz anders aussieht als gedacht. Nun geht ihr zwar nicht der Sprit, aber das Gas aus.
Seit Ende 2013 hat die Esa-Sonde "Gaia" Himmelskörper in der Milchstraße beobachtet - mit drei Billionen Observationen und teils "spektakulären Resultaten". Dank ihr wissen wir, dass unsere Galaxie ganz anders aussieht als gedacht. Nun geht ihr zwar nicht der Sprit, aber das Gas aus.
 Wer einen Laptop mit schlechtem Mikrofon hat und in Videoanrufen blechern klingt, wird als weniger intelligent wahrgenommen. Das fanden Psychologen heraus, die sich von eigenen Erlebnissen inspirieren ließen.
Wer einen Laptop mit schlechtem Mikrofon hat und in Videoanrufen blechern klingt, wird als weniger intelligent wahrgenommen. Das fanden Psychologen heraus, die sich von eigenen Erlebnissen inspirieren ließen.
 Sich mühsam durch Google-Ergebnisseiten zu kämpfen, könnte bald eine in Vergessenheit geratene Kulturtechnik sein: Seit heute liefert die Suchmaschine auch deutschen Nutzern eine KI-gestützte Zusammenfassung der Antworten.
Sich mühsam durch Google-Ergebnisseiten zu kämpfen, könnte bald eine in Vergessenheit geratene Kulturtechnik sein: Seit heute liefert die Suchmaschine auch deutschen Nutzern eine KI-gestützte Zusammenfassung der Antworten.
 Mit »Callie« hatte die Nasa in zwei Comics eine Frau und Person of Color zur Raumfahrtheldin gemacht. Offenbar wegen Trump nahm die Behörde die Geschichten aus dem Netz. Die tauchen nun in Island wieder auf.
Mit »Callie« hatte die Nasa in zwei Comics eine Frau und Person of Color zur Raumfahrtheldin gemacht. Offenbar wegen Trump nahm die Behörde die Geschichten aus dem Netz. Die tauchen nun in Island wieder auf.
 Geht das Datenvolumen zuneige, kann man kostenlos nachbuchen: Mit neuen Tarifen ab zehn Euro mischt Aldi Talk den Prepaidmarkt auf. Unser Angebotscheck verrät die Plus- und Minuspunkte.
Geht das Datenvolumen zuneige, kann man kostenlos nachbuchen: Mit neuen Tarifen ab zehn Euro mischt Aldi Talk den Prepaidmarkt auf. Unser Angebotscheck verrät die Plus- und Minuspunkte.
 Die sogenannten Ewigkeitschemikalien, wissenschaftlich PFAS, heißen so, weil sie extrem stabil und langlebig sind. Aber leider auch gesundheitsschädlich. Nun gibt es ein neues Verfahren zum Abbau der Schadstoffe - das auch noch einen zweiten großen Vorteil bietet.
Die sogenannten Ewigkeitschemikalien, wissenschaftlich PFAS, heißen so, weil sie extrem stabil und langlebig sind. Aber leider auch gesundheitsschädlich. Nun gibt es ein neues Verfahren zum Abbau der Schadstoffe - das auch noch einen zweiten großen Vorteil bietet.
 In der Netflix-Serie »Adolescence« begeht ein 13-Jähriger einen kaum fassbaren Mord. Wurde er von der sogenannten »Incel«-Community angestachelt? Der Kommunikationsforscher Jacob Johanssen dechiffriert die Codes und Werte der Subkultur.
In der Netflix-Serie »Adolescence« begeht ein 13-Jähriger einen kaum fassbaren Mord. Wurde er von der sogenannten »Incel«-Community angestachelt? Der Kommunikationsforscher Jacob Johanssen dechiffriert die Codes und Werte der Subkultur.
 In Signal werden Nachrichten per Ende-zu-Ende-Verschlüsselung gesichert: Nur Absender und Empfänger der Nachricht können sie lesen. Die US-Geheimchat-Affäre zeigt, dass der Chatdienst doch nicht so sicher ist, wie gedacht.
In Signal werden Nachrichten per Ende-zu-Ende-Verschlüsselung gesichert: Nur Absender und Empfänger der Nachricht können sie lesen. Die US-Geheimchat-Affäre zeigt, dass der Chatdienst doch nicht so sicher ist, wie gedacht.
 Sensible Daten von Dutzenden US-Bürgern stehen offen im Netz, weil die Trump-Regierung die nun freigegebenen Akten zum Mord an John F. Kennedy unzureichend geschwärzt hat. Die Opfer wollen sich wehren.
Sensible Daten von Dutzenden US-Bürgern stehen offen im Netz, weil die Trump-Regierung die nun freigegebenen Akten zum Mord an John F. Kennedy unzureichend geschwärzt hat. Die Opfer wollen sich wehren.
 Seit Jahrzehnten testet eine Studie Kinder und Jugendliche in Deutschland auf Leistung, Bewegung und Gesundheit. Die aktuelle Studie wird noch ausgewertet, aber ein fällt bereits auf: Jungen wie Mädchen erleben einen Leistungseinbruch beim Fahrrad-Test. Eine Folge der Pandemie?
Seit Jahrzehnten testet eine Studie Kinder und Jugendliche in Deutschland auf Leistung, Bewegung und Gesundheit. Die aktuelle Studie wird noch ausgewertet, aber ein fällt bereits auf: Jungen wie Mädchen erleben einen Leistungseinbruch beim Fahrrad-Test. Eine Folge der Pandemie?
 Angesichts des Mangels an Organspenden sollen Schweine künftig einmal als Spender dienen - nun ist chinesischen Forschern ein wichtiger Schritt auf diesem Weg gelungen. Die weltweit erste Transplantation einer Schweineleber in einen Menschen liefert wichtige Erkenntnisse.
Angesichts des Mangels an Organspenden sollen Schweine künftig einmal als Spender dienen - nun ist chinesischen Forschern ein wichtiger Schritt auf diesem Weg gelungen. Die weltweit erste Transplantation einer Schweineleber in einen Menschen liefert wichtige Erkenntnisse.
 Nach Herz und Niere nun auch die Leber: Chinesische Ärzte haben das Organ eines Schweins für zehn Tage erfolgreich einem hirntoten Menschen eingesetzt. Forscher sprechen von einem großen Schritt für die Medizin.
Nach Herz und Niere nun auch die Leber: Chinesische Ärzte haben das Organ eines Schweins für zehn Tage erfolgreich einem hirntoten Menschen eingesetzt. Forscher sprechen von einem großen Schritt für die Medizin.
 Eigentlich wollten sich zwei Freunde nur einen Abend in Berlin vertreiben, mit einem Trinkspiel an einer Radarfalle. Jetzt werden ihre Videos millionenfach abgerufen, sie haben sogar Fans in den USA. Was ist passiert?
Eigentlich wollten sich zwei Freunde nur einen Abend in Berlin vertreiben, mit einem Trinkspiel an einer Radarfalle. Jetzt werden ihre Videos millionenfach abgerufen, sie haben sogar Fans in den USA. Was ist passiert?
 Wer Medikamente bestellt, legt damit Details über die eigene Gesundheit offen. Das müssen Apotheken berücksichtigen, wenn sie auf Plattformen wie Amazon Marketplace verkaufen, sagt jetzt der Bundesgerichtshof.
Wer Medikamente bestellt, legt damit Details über die eigene Gesundheit offen. Das müssen Apotheken berücksichtigen, wenn sie auf Plattformen wie Amazon Marketplace verkaufen, sagt jetzt der Bundesgerichtshof.
 In der Netflix-Serie »Adolescence« begeht ein 13-Jähriger einen kaum fassbaren Mord. Wurde er von der sogenannten Incel-Community angestachelt? Der Kommunikationsforscher Jacob Johanssen dechiffriert die Codes und Werte der Subkultur.
In der Netflix-Serie »Adolescence« begeht ein 13-Jähriger einen kaum fassbaren Mord. Wurde er von der sogenannten Incel-Community angestachelt? Der Kommunikationsforscher Jacob Johanssen dechiffriert die Codes und Werte der Subkultur.
 Die Gletscher in den Dolomiten verlieren in den vergangenen Jahren immer mehr Eis. Die Schäden sind laut einer neuen Studie wegen des Klimawandels nicht mehr umkehrbar. Den Wissenschaftlern zufolge werden die Gletscher "innerhalb weniger Jahrzehnte verschwinden".
Die Gletscher in den Dolomiten verlieren in den vergangenen Jahren immer mehr Eis. Die Schäden sind laut einer neuen Studie wegen des Klimawandels nicht mehr umkehrbar. Den Wissenschaftlern zufolge werden die Gletscher "innerhalb weniger Jahrzehnte verschwinden".
 Mönche brachten einst das Wissen der Menschheit zu Papier, so das gängige Bild. Doch laut einer neuen Untersuchung könnten Frauen eine relevante Rolle in der Buchkunst gespielt haben.
Mönche brachten einst das Wissen der Menschheit zu Papier, so das gängige Bild. Doch laut einer neuen Untersuchung könnten Frauen eine relevante Rolle in der Buchkunst gespielt haben.
 Eine neue Studie zeigt, wie stark der Klimawandel in den Wasserkreislauf der Erde eingreift. Die Massen verschieben sich so stark, dass der Planet taumelt.
Eine neue Studie zeigt, wie stark der Klimawandel in den Wasserkreislauf der Erde eingreift. Die Massen verschieben sich so stark, dass der Planet taumelt.
 Vor der neuseeländischen Nordküste suchen Wissenschaftler im Dezember 2023 nach Fressgelagen im Meer. Plötzlich fällt ihnen ein bunter Farbklecks auf dem Kopf eines Hais auf. Eine Boje? Nein. Beim genaueren Hinschauen stellt sich der orangefarbene Fleck als Oktopus heraus.
Vor der neuseeländischen Nordküste suchen Wissenschaftler im Dezember 2023 nach Fressgelagen im Meer. Plötzlich fällt ihnen ein bunter Farbklecks auf dem Kopf eines Hais auf. Eine Boje? Nein. Beim genaueren Hinschauen stellt sich der orangefarbene Fleck als Oktopus heraus.
 Die Tür an Berliner Klubs kann hart sein, aber nach welchem Prinzip werden die Leute eingelassen? Das haben sich Forschende nun genauer angesehen – und gewisse Muster beobachtet.
Die Tür an Berliner Klubs kann hart sein, aber nach welchem Prinzip werden die Leute eingelassen? Das haben sich Forschende nun genauer angesehen – und gewisse Muster beobachtet.
 Wenn man an seine Kindheit zurückdenkt, bleiben die ersten Lebensjahre meist im Dunkeln. Die Forschung spricht von infantiler Amnesie. Nun findet jedoch eine neue Studie Hinweise, dass schon Einjährige Erlebtes abspeichern. Das wirft Fragen auf - und hätte weitreichende Folgen.
Wenn man an seine Kindheit zurückdenkt, bleiben die ersten Lebensjahre meist im Dunkeln. Die Forschung spricht von infantiler Amnesie. Nun findet jedoch eine neue Studie Hinweise, dass schon Einjährige Erlebtes abspeichern. Das wirft Fragen auf - und hätte weitreichende Folgen.
 Der Mond schiebt sich zwischen Sonne und Erde. Je nach Standort und Wetter könnte der Stern als Sichel erscheinen. In Deutschland bietet die Nordseeküste beste Chancen, das Himmelsspektakel zu sehen.
Der Mond schiebt sich zwischen Sonne und Erde. Je nach Standort und Wetter könnte der Stern als Sichel erscheinen. In Deutschland bietet die Nordseeküste beste Chancen, das Himmelsspektakel zu sehen.
 Sie war nicht tot, sie hat nur ein paar Jahrtausende im Schlamm geschlummert. Eine Alge aus der Ostsee dient als Paradebeispiel für die »Auferstehungsökologie«, die ein Rostocker Forschungsteam praktiziert.
Sie war nicht tot, sie hat nur ein paar Jahrtausende im Schlamm geschlummert. Eine Alge aus der Ostsee dient als Paradebeispiel für die »Auferstehungsökologie«, die ein Rostocker Forschungsteam praktiziert.
 Facebook will zurück zum »OG Facebook«, also der Ursprungsversion der Plattform, und hat mehrere Updates angekündigt. Nun sollen wieder Beiträge von Freunden und Menschen, die man kennt, im Fokus stehen.
Facebook will zurück zum »OG Facebook«, also der Ursprungsversion der Plattform, und hat mehrere Updates angekündigt. Nun sollen wieder Beiträge von Freunden und Menschen, die man kennt, im Fokus stehen.
 Erste Papiere von Union und SPD deuten auf eine schlaffe Klimapolitik der nächsten Jahre hin. Die Klimaziele werden so nicht erreicht – dafür soll in teure Symbolpolitik investiert werden.
Erste Papiere von Union und SPD deuten auf eine schlaffe Klimapolitik der nächsten Jahre hin. Die Klimaziele werden so nicht erreicht – dafür soll in teure Symbolpolitik investiert werden.
 Nachdem Kieselalgen der Art Skeletonema marinoi Tausende Jahre lang auf dem Boden der Ostsee geschlafen hatten, holen Forscher sie nun ins Leben zurück. Und sind verblüfft: Die Algen haben nicht nur gerade so überlebt, sondern "sie wachsen, teilen sich und betreiben Photosynthese".
Nachdem Kieselalgen der Art Skeletonema marinoi Tausende Jahre lang auf dem Boden der Ostsee geschlafen hatten, holen Forscher sie nun ins Leben zurück. Und sind verblüfft: Die Algen haben nicht nur gerade so überlebt, sondern "sie wachsen, teilen sich und betreiben Photosynthese".
 In Südostasien hat die Erde stark gebebt, mehrere Menschen kamen ums Leben. Der Seismologe Frederik Tilmann befürchtet steigende Opferzahlen und erklärt, warum weitere Erschütterungen wahrscheinlich sind.
In Südostasien hat die Erde stark gebebt, mehrere Menschen kamen ums Leben. Der Seismologe Frederik Tilmann befürchtet steigende Opferzahlen und erklärt, warum weitere Erschütterungen wahrscheinlich sind.
 Von einem Fossil sind die Innereien bestens erhalten, aber der äußere Panzer fehlt. Das Tier erzählt vom Überleben zwischen Eis und Säure im Erdaltertum – und der 25 Jahre dauernden Arbeit einer hartnäckigen Paläontologin.
Von einem Fossil sind die Innereien bestens erhalten, aber der äußere Panzer fehlt. Das Tier erzählt vom Überleben zwischen Eis und Säure im Erdaltertum – und der 25 Jahre dauernden Arbeit einer hartnäckigen Paläontologin.
 An diesem Wochenende schiebt sich der Neumond teilweise vor die Sonne. Den größten Effekt hat die Sonnenfinsternis in Grönland oder Nordamerika. Doch auch in Deutschland können Menschen mit etwas Glück beobachten, wie die Sonne mitten am Tag zum Teil verdunkelt wird.
An diesem Wochenende schiebt sich der Neumond teilweise vor die Sonne. Den größten Effekt hat die Sonnenfinsternis in Grönland oder Nordamerika. Doch auch in Deutschland können Menschen mit etwas Glück beobachten, wie die Sonne mitten am Tag zum Teil verdunkelt wird.
 Die Ecoflow Rapid ist eine schicke, kompakte und leistungsstarke Powerbank. iPhones steht sie besonders gut, wenn sie magnetisch an ihnen haftet, sie kann aber auch Notebooks mit Strom versorgen.
Die Ecoflow Rapid ist eine schicke, kompakte und leistungsstarke Powerbank. iPhones steht sie besonders gut, wenn sie magnetisch an ihnen haftet, sie kann aber auch Notebooks mit Strom versorgen.
 Nach nur siebeneinhalb Monaten im Amt hört Katrina Armstrong als geschäftsführende Präsidentin an der New Yorker Columbia University auf. Zuletzt war die Hochschule wegen drohender Millionenkürzungen vor Donald Trump eingeknickt.
Nach nur siebeneinhalb Monaten im Amt hört Katrina Armstrong als geschäftsführende Präsidentin an der New Yorker Columbia University auf. Zuletzt war die Hochschule wegen drohender Millionenkürzungen vor Donald Trump eingeknickt.
 Die Tür in Berliner Techno-Clubs ist hart, so viel ist bekannt. Doch wie entscheiden die Türsteher, wer reinkommt und wer nicht? Ein internationales Forscherteam entschlüsselt Entscheidungsmuster. Nicht alle Kriterien liegen in der Macht des Feiernden - und am Ende zählt das gewisse Extra.
Die Tür in Berliner Techno-Clubs ist hart, so viel ist bekannt. Doch wie entscheiden die Türsteher, wer reinkommt und wer nicht? Ein internationales Forscherteam entschlüsselt Entscheidungsmuster. Nicht alle Kriterien liegen in der Macht des Feiernden - und am Ende zählt das gewisse Extra.
 Die Augen jucken, die Nase läuft - für Allergiker ein sicheres Zeichen: Der Frühling ist da. Wird es draußen wärmer, dann wirbelt wieder reichlich Blütenstaub durch die Luft und macht ihnen das Leben schwer. In manchen Regionen ganz besonders.
Die Augen jucken, die Nase läuft - für Allergiker ein sicheres Zeichen: Der Frühling ist da. Wird es draußen wärmer, dann wirbelt wieder reichlich Blütenstaub durch die Luft und macht ihnen das Leben schwer. In manchen Regionen ganz besonders.
 Es ist wieder so weit: In der Nacht zum Sonntag werden die Uhren eine Stunde nach vorn gedreht. Doch ist die Zeitumstellung sinnvoll? Auch Experten sind da uneins. Alles so lassen, meinen nun zwei spanische Forscher mit Blick auf Historie und Studienlage. Es brauche jedoch eine kleine Verschiebung.
Es ist wieder so weit: In der Nacht zum Sonntag werden die Uhren eine Stunde nach vorn gedreht. Doch ist die Zeitumstellung sinnvoll? Auch Experten sind da uneins. Alles so lassen, meinen nun zwei spanische Forscher mit Blick auf Historie und Studienlage. Es brauche jedoch eine kleine Verschiebung.
 China und die USA kämpfen um die Vorherrschaft bei künstlicher Intelligenz, sie investieren dreistellige Milliardenbeträge. Aber auch Europa mischt mit. Und hat tatsächlich eine Chance. Der SPIEGEL-Report.
China und die USA kämpfen um die Vorherrschaft bei künstlicher Intelligenz, sie investieren dreistellige Milliardenbeträge. Aber auch Europa mischt mit. Und hat tatsächlich eine Chance. Der SPIEGEL-Report.
 2028 will die europäische Raumfahrtorganisation Esa zum Mars aufbrechen und dort mit dem Rover »Rosalind Franklin« nach Spuren von Leben suchen. Für die Landeplattform des Vehikels hat sich nun ein Konstrukteur gefunden.
2028 will die europäische Raumfahrtorganisation Esa zum Mars aufbrechen und dort mit dem Rover »Rosalind Franklin« nach Spuren von Leben suchen. Für die Landeplattform des Vehikels hat sich nun ein Konstrukteur gefunden.
 Ein deutscher Forscher arbeitet in den USA an einem neuartigen Beton, der die Energiewende vorantreiben soll. Denn mit ihm könnten Fußböden, Brücken und sogar Straßen Strom speichern.
Ein deutscher Forscher arbeitet in den USA an einem neuartigen Beton, der die Energiewende vorantreiben soll. Denn mit ihm könnten Fußböden, Brücken und sogar Straßen Strom speichern.
 Bislang waren alle deutschen Astronauten Männer – das soll sich mit der Berlinerin Rabea Rogge jetzt ändern: Sie will ab Dienstag mit einem SpaceX-Team tagelang um die Pole fliegen.
Bislang waren alle deutschen Astronauten Männer – das soll sich mit der Berlinerin Rabea Rogge jetzt ändern: Sie will ab Dienstag mit einem SpaceX-Team tagelang um die Pole fliegen.
 Während viele große Raubtiere weltweit schwinden, erleben andere Arten dieser Gruppe einen raschen Aufschwung: Der Wolf hat sich in Europa schnell verbreitet. Das nützt auch vielen Menschen.
Während viele große Raubtiere weltweit schwinden, erleben andere Arten dieser Gruppe einen raschen Aufschwung: Der Wolf hat sich in Europa schnell verbreitet. Das nützt auch vielen Menschen.
 Immer wieder muss der Start der Trägerrakete des bayerischen Start-ups Isar Aerospace in den vergangenen Tagen verschoben werden. Jetzt hebt "Spectrum" endlich ab. Doch der Flug dauert nur kurz.
Immer wieder muss der Start der Trägerrakete des bayerischen Start-ups Isar Aerospace in den vergangenen Tagen verschoben werden. Jetzt hebt "Spectrum" endlich ab. Doch der Flug dauert nur kurz.
 In Deutschland ist die Tiefseeforscherin Antje Boetius ein Star. Jetzt wechselt sie in die USA – eine gewagte Entscheidung zu einem Zeitpunkt, an dem die Wissenschaft dort massiv durch die Regierung angegriffen wird.
In Deutschland ist die Tiefseeforscherin Antje Boetius ein Star. Jetzt wechselt sie in die USA – eine gewagte Entscheidung zu einem Zeitpunkt, an dem die Wissenschaft dort massiv durch die Regierung angegriffen wird.
 Immer wieder muss der Start der Trägerrakete des bayerischen Start-ups Isar Aerospace in den vergangenen Tagen verschoben werden. Jetzt hebt Spectrum endlich ab. Doch der Flug dauert nur kurz.
Immer wieder muss der Start der Trägerrakete des bayerischen Start-ups Isar Aerospace in den vergangenen Tagen verschoben werden. Jetzt hebt Spectrum endlich ab. Doch der Flug dauert nur kurz.
 Isar Aerospace hat erstmals eine Rakete gestartet. Nach rund einer halben Minute war der Premierenflug schon vorbei. Ein Problem ist das nicht – und doch stehen Europas Raumfahrtfirmen vor vielen Herausforderungen.
Isar Aerospace hat erstmals eine Rakete gestartet. Nach rund einer halben Minute war der Premierenflug schon vorbei. Ein Problem ist das nicht – und doch stehen Europas Raumfahrtfirmen vor vielen Herausforderungen.
 Er erinnert tatsächlich ein wenig an das Meerestier, gehört zur Ordnung der Gespensterschrecken: Im Prager Zoo sind jetzt einige Exemplare der extrem seltenen Baumhummer zu sehen. Eigentlich galten die Tiere als ausgestorben.
Er erinnert tatsächlich ein wenig an das Meerestier, gehört zur Ordnung der Gespensterschrecken: Im Prager Zoo sind jetzt einige Exemplare der extrem seltenen Baumhummer zu sehen. Eigentlich galten die Tiere als ausgestorben.
 Die Messenger-App Signal ist für ihre Sicherheit bekannt und wurde einst von einem staatskritischen Aktivisten entwickelt. Warum es trotzdem ein Problem ist, wenn die US-Regierung sie zur Planung von Militärschlägen nutzt.
Die Messenger-App Signal ist für ihre Sicherheit bekannt und wurde einst von einem staatskritischen Aktivisten entwickelt. Warum es trotzdem ein Problem ist, wenn die US-Regierung sie zur Planung von Militärschlägen nutzt.
 Die US-Regierung sucht einen nicht-chinesischen Käufer für das amerikanische Geschäft der Kurzvideo-App TikTok. Präsident Trump ist zuversichtlich, dass ein Deal vor der Frist am Samstag zustandekommt.
Die US-Regierung sucht einen nicht-chinesischen Käufer für das amerikanische Geschäft der Kurzvideo-App TikTok. Präsident Trump ist zuversichtlich, dass ein Deal vor der Frist am Samstag zustandekommt.
 Seit Jahrzehnten nehmen die Dürreperioden auf der Erde zu, die Menge des an Land gespeicherten Wassers sinkt deutlich. Und die Verlagerung des Wassers zu den Ozeanen lässt den Meeresspiegel steigen. Diese Entwicklung war in drei Jahren nacheinander besonders extrem.
Seit Jahrzehnten nehmen die Dürreperioden auf der Erde zu, die Menge des an Land gespeicherten Wassers sinkt deutlich. Und die Verlagerung des Wassers zu den Ozeanen lässt den Meeresspiegel steigen. Diese Entwicklung war in drei Jahren nacheinander besonders extrem.
 Zwölf deutsche Männer waren bereits im Weltall - bislang aber noch keine deutsche Frau. Das soll sich mit Rabea Rogge jetzt ändern. Die Berlinerin wird mit einem SpaceX-Team tagelang um die Pole fliegen. Mit an Bord: ein Milliardär, eine Filmemacherin und ein Polar-Führer.
Zwölf deutsche Männer waren bereits im Weltall - bislang aber noch keine deutsche Frau. Das soll sich mit Rabea Rogge jetzt ändern. Die Berlinerin wird mit einem SpaceX-Team tagelang um die Pole fliegen. Mit an Bord: ein Milliardär, eine Filmemacherin und ein Polar-Führer.
 Bei der Verbesserung der psychischen Gesundheit und dem Kurieren von Einsamkeit stößt die traditionelle Medizin an ihre Grenzen. Immer mehr Ärztinnen und Ärzte greifen deswegen zu einer ungewöhnlichen Maßnahme: Kunst auf Rezept.
Bei der Verbesserung der psychischen Gesundheit und dem Kurieren von Einsamkeit stößt die traditionelle Medizin an ihre Grenzen. Immer mehr Ärztinnen und Ärzte greifen deswegen zu einer ungewöhnlichen Maßnahme: Kunst auf Rezept.
 Die US-Regierung sucht einen nicht chinesischen Käufer für das amerikanische Geschäft der Kurzvideo-App TikTok. Präsident Trump ist zuversichtlich, dass ein Deal vor der Frist am Samstag zustande kommt.
Die US-Regierung sucht einen nicht chinesischen Käufer für das amerikanische Geschäft der Kurzvideo-App TikTok. Präsident Trump ist zuversichtlich, dass ein Deal vor der Frist am Samstag zustande kommt.
 Apple soll in Frankreich eine Geldstrafe in Höhe von 150 Millionen Euro zahlen. Die Kartellwächter stören sich an der Umsetzung einer Datenschutzfunktion. Ändern muss der Konzern aber offenbar nichts.
Apple soll in Frankreich eine Geldstrafe in Höhe von 150 Millionen Euro zahlen. Die Kartellwächter stören sich an der Umsetzung einer Datenschutzfunktion. Ändern muss der Konzern aber offenbar nichts.
 Unzählige winzige Kügelchen aus Stein zusammengeklumpt: Auf dem Mars stößt der Nasa-Rover "Perseverance" auf einen ungewöhnlichen Felsbrocken. Die Wissenschaftler beschreiben die Entdeckung als "schockierend" und rätseln über dessen Entstehung.
Unzählige winzige Kügelchen aus Stein zusammengeklumpt: Auf dem Mars stößt der Nasa-Rover "Perseverance" auf einen ungewöhnlichen Felsbrocken. Die Wissenschaftler beschreiben die Entdeckung als "schockierend" und rätseln über dessen Entstehung.
 Ein mittelalterlicher Bestseller, versteckt in einem 400 Jahre alten Buch: Ein Forscherteam der Universität Cambridge hat diesen ungewöhnlichen Fund gemacht. Moderne Technik half dabei, die verborgenen Zeilen zu enthüllen.
Ein mittelalterlicher Bestseller, versteckt in einem 400 Jahre alten Buch: Ein Forscherteam der Universität Cambridge hat diesen ungewöhnlichen Fund gemacht. Moderne Technik half dabei, die verborgenen Zeilen zu enthüllen.
 Hat Russland eine Forschungsanlage der Europäischen Union in Italien ausspioniert? Eine Aufklärungsdrohne soll das Gebiet mehrfach durchquert haben. Nun ermittelt die Staatsanwaltschaft.
Hat Russland eine Forschungsanlage der Europäischen Union in Italien ausspioniert? Eine Aufklärungsdrohne soll das Gebiet mehrfach durchquert haben. Nun ermittelt die Staatsanwaltschaft.
 Zu warm, zu trocken: Wie schon der Februar glänzt auch der März mit ungewöhnlich sonnigem Wetter - zum Nachteil der Natur. Denn im Frühjahr soll die Vegetation erwachen. Doch der Boden ist seit Wochen viel zu trocken. Für Pflanzen und Tiere wird das das ganze Jahr lang Folgen haben.
Zu warm, zu trocken: Wie schon der Februar glänzt auch der März mit ungewöhnlich sonnigem Wetter - zum Nachteil der Natur. Denn im Frühjahr soll die Vegetation erwachen. Doch der Boden ist seit Wochen viel zu trocken. Für Pflanzen und Tiere wird das das ganze Jahr lang Folgen haben.
 Blau gegen Pickel, gelb gegen Rötungen, rot gegen Falten: Hersteller und Influencer preisen die Vorzüge von LED-Masken an. Wirken die wirklich? SPIEGEL-Redakteurin Alina Schadwinkel nennt die wissenschaftlichen Fakten.
Blau gegen Pickel, gelb gegen Rötungen, rot gegen Falten: Hersteller und Influencer preisen die Vorzüge von LED-Masken an. Wirken die wirklich? SPIEGEL-Redakteurin Alina Schadwinkel nennt die wissenschaftlichen Fakten.
 Ein Mann aus Michigan erhält eine lebenswichtige Organspende. Doch nur kurze Zeit später stirbt er. Die Ursache findet sich schnell im Spenderorgan. Es ist mit Tollwut infiziert. Einen ähnlichen Fall gab es auch vor Jahren in Deutschland.
Ein Mann aus Michigan erhält eine lebenswichtige Organspende. Doch nur kurze Zeit später stirbt er. Die Ursache findet sich schnell im Spenderorgan. Es ist mit Tollwut infiziert. Einen ähnlichen Fall gab es auch vor Jahren in Deutschland.
 Geekom bietet mit dem A8 Max einen Mini-PC an, der in einem größeren Gehäuse die Muskeln spielen lässt. In Kombination mit zahlreichen Anschlüssen kann er auch professionellen Ansprüchen gerecht werden. Besser als sein kleinerer Vorgänger ist er aber besonders bei einer Aufgabe.
Geekom bietet mit dem A8 Max einen Mini-PC an, der in einem größeren Gehäuse die Muskeln spielen lässt. In Kombination mit zahlreichen Anschlüssen kann er auch professionellen Ansprüchen gerecht werden. Besser als sein kleinerer Vorgänger ist er aber besonders bei einer Aufgabe.
 Am Montagabend stellt Apple iOS 18.4, iPadOS18.4 und macOS 15.4 bereit. Mit der neuen Software werden Apples KI-Funktionen auch in der EU verfügbar. Zumindest jene, die schon fertig sind.
Am Montagabend stellt Apple iOS 18.4, iPadOS18.4 und macOS 15.4 bereit. Mit der neuen Software werden Apples KI-Funktionen auch in der EU verfügbar. Zumindest jene, die schon fertig sind.
 Der Raketenstart ist geglückt, die Berlinerin Rabea Rogge ist an Bord einer »Dragon«-Kapsel unterwegs: Mit einem SpaceX-Team soll sie rund vier Tage lang über die Polarregionen der Erde fliegen.
Der Raketenstart ist geglückt, die Berlinerin Rabea Rogge ist an Bord einer »Dragon«-Kapsel unterwegs: Mit einem SpaceX-Team soll sie rund vier Tage lang über die Polarregionen der Erde fliegen.
 Am Montagabend stellt Apple iOS 18.4, iPadOS 18.4 und macOS 15.4 bereit. Mit der neuen Software werden Apples KI-Funktionen auch in der EU verfügbar. Zumindest jene, die schon fertig sind.
Am Montagabend stellt Apple iOS 18.4, iPadOS 18.4 und macOS 15.4 bereit. Mit der neuen Software werden Apples KI-Funktionen auch in der EU verfügbar. Zumindest jene, die schon fertig sind.
 Unter Donald Trump streicht die Regierung Forschungseinrichtungen die Fördergelder. Führende Wissenschaftler warnen nun in einem offenen Brief vor den Gefahren und berichten von einem »Klima der Angst«.
Unter Donald Trump streicht die Regierung Forschungseinrichtungen die Fördergelder. Führende Wissenschaftler warnen nun in einem offenen Brief vor den Gefahren und berichten von einem »Klima der Angst«.
 Im Kampf um die Vorherrschaft um künstliche Intelligenz hat der ChatGPT-Entwickler ein Rekordinvestment bekannt gegeben. Das erhöht den Wert der Firma beträchtlich. Der neue Bildgenerator sorgt für Furore und Kritik.
Im Kampf um die Vorherrschaft um künstliche Intelligenz hat der ChatGPT-Entwickler ein Rekordinvestment bekannt gegeben. Das erhöht den Wert der Firma beträchtlich. Der neue Bildgenerator sorgt für Furore und Kritik.
 Hitzewellen, sehr nasse oder trockene Jahre: Was früher extrem war, ist heute normal, schreibt der DWD in seinem Klimabericht für 2024. Er warnt vor den Folgen für die deutsche Energieversorgung und das Leben in den Städten.
Hitzewellen, sehr nasse oder trockene Jahre: Was früher extrem war, ist heute normal, schreibt der DWD in seinem Klimabericht für 2024. Er warnt vor den Folgen für die deutsche Energieversorgung und das Leben in den Städten.
 Der Handel mit Galapagos-Leguanen ist streng verboten. Eine Studie zeigt nun, dass das illegale Geschäft mit den seltenen Reptilien floriert. Im Fokus der Machenschaften steht ein Mann, der aus Uganda heraus agiert.
Der Handel mit Galapagos-Leguanen ist streng verboten. Eine Studie zeigt nun, dass das illegale Geschäft mit den seltenen Reptilien floriert. Im Fokus der Machenschaften steht ein Mann, der aus Uganda heraus agiert.
 Rabea Rogge ist die erste Astronautin aus Deutschland. Sie ist auf der Privatmission eines Kryptoinvestors unterwegs. Das liegt auch daran, dass sich die Politik kaum für Frauen im All interessiert hat.
Rabea Rogge ist die erste Astronautin aus Deutschland. Sie ist auf der Privatmission eines Kryptoinvestors unterwegs. Das liegt auch daran, dass sich die Politik kaum für Frauen im All interessiert hat.
 Hitzewellen, sehr nasse oder trockene Jahre: Was früher extrem war, ist heute normal, schreibt der DWD in seinem Klimabericht für 2024. Er warnt vor den Folgen für die deutsche Energieversorgung.
Hitzewellen, sehr nasse oder trockene Jahre: Was früher extrem war, ist heute normal, schreibt der DWD in seinem Klimabericht für 2024. Er warnt vor den Folgen für die deutsche Energieversorgung.
 Auf Einladung eines Milliardärs ist sie mit an Bord: Die Berliner Polarforscherin Rabea Rogge will unter anderem die Schwerelosigkeit erforschen. Kein Mitglied der Crew ist ausgebildeter Raumfahrer.
Auf Einladung eines Milliardärs ist sie mit an Bord: Die Berliner Polarforscherin Rabea Rogge will unter anderem die Schwerelosigkeit erforschen. Kein Mitglied der Crew ist ausgebildeter Raumfahrer.
 Bei deutschen Usern taucht plötzlich ein bunter Kreis in WhatsApp auf. Dahinter steckt Meta AI. Zu übersehen ist die neue KI-Funktion kaum, dabei wirkt sie hierzulande noch ziemlich halbgar.
Bei deutschen Usern taucht plötzlich ein bunter Kreis in WhatsApp auf. Dahinter steckt Meta AI. Zu übersehen ist die neue KI-Funktion kaum, dabei wirkt sie hierzulande noch ziemlich halbgar.
 Jahrzehnte lagerte das Fossil eines Meeressauriers im Magazin des Urweltmuseums Hauff. Nun haben Forschende es genauer untersucht. Das Exemplar zeigt, wie verschieden sich die Urzeitreptilien in der Jurazeit entwickelten.
Jahrzehnte lagerte das Fossil eines Meeressauriers im Magazin des Urweltmuseums Hauff. Nun haben Forschende es genauer untersucht. Das Exemplar zeigt, wie verschieden sich die Urzeitreptilien in der Jurazeit entwickelten.
 Ein Marathonlauf ist eine extreme Belastung für den Körper. Das Gehirn versucht, den schweren Energieverlust durch die langanhaltenden Strapazen auszugleichen. Wie das abläuft, findet ein Forschungsteam mit einer Pilotstudie heraus.
Ein Marathonlauf ist eine extreme Belastung für den Körper. Das Gehirn versucht, den schweren Energieverlust durch die langanhaltenden Strapazen auszugleichen. Wie das abläuft, findet ein Forschungsteam mit einer Pilotstudie heraus.
 Eine Oral-B-iO-Zahnbürste kann mehr als 300 Euro kosten, es gibt sie aber auch als Serie 2 ohne jeden Schnickschnack für knapp 60 Euro. Im Praxistest stellt sie sich als unkomplizierte Einsteiger-Alternative heraus, die genauso gründlich putzt wie die Testsiegerin bei Stiftung Warentest. Der Hersteller verdient trotzdem gut.
Eine Oral-B-iO-Zahnbürste kann mehr als 300 Euro kosten, es gibt sie aber auch als Serie 2 ohne jeden Schnickschnack für knapp 60 Euro. Im Praxistest stellt sie sich als unkomplizierte Einsteiger-Alternative heraus, die genauso gründlich putzt wie die Testsiegerin bei Stiftung Warentest. Der Hersteller verdient trotzdem gut.
 Ein milder Winter und viel Sonnenschein - das Jahr 2024 war in Deutschland das wärmste seit Beginn der Messungen. Der Klimawandel zeigt sich immer deutlicher, sagt der Deutsche Wetterdienst. Immerhin: Der Grundwasserspeicher wurde durch viel Regen aufgefüllt.
Ein milder Winter und viel Sonnenschein - das Jahr 2024 war in Deutschland das wärmste seit Beginn der Messungen. Der Klimawandel zeigt sich immer deutlicher, sagt der Deutsche Wetterdienst. Immerhin: Der Grundwasserspeicher wurde durch viel Regen aufgefüllt.
 In Südafrikas Buchten gibt es kaum noch Weiße Haie. Das hat tiefgreifende Auswirkungen auf die Nahrungskette und biologische Vielfalt im Atlantik, wie ein Forschungsteam herausfindet. Doch warum sind die Spitzenprädatoren verschwunden? Die Ursache könnte ein anderes Raubtier sein.
In Südafrikas Buchten gibt es kaum noch Weiße Haie. Das hat tiefgreifende Auswirkungen auf die Nahrungskette und biologische Vielfalt im Atlantik, wie ein Forschungsteam herausfindet. Doch warum sind die Spitzenprädatoren verschwunden? Die Ursache könnte ein anderes Raubtier sein.
 Schmalere Texte, neue Menüs und ein Dark Mode. Das Online-Nachschlagewerk passt sein Layout im deutschsprachigen Raum an die international verbreitetere Version an. Lesen, Verstehen und Mitmachen sollen so einfacher werden.
Schmalere Texte, neue Menüs und ein Dark Mode. Das Online-Nachschlagewerk passt sein Layout im deutschsprachigen Raum an die international verbreitetere Version an. Lesen, Verstehen und Mitmachen sollen so einfacher werden.
 Wer Medikamente bestellt, legt damit Details über die eigene Gesundheit offen. Das müssen Apotheken berücksichtigen, wenn sie auf Plattformen wie Amazon Marketplace verkaufen, sagt jetzt der Bundesgerichtshof.
Wer Medikamente bestellt, legt damit Details über die eigene Gesundheit offen. Das müssen Apotheken berücksichtigen, wenn sie auf Plattformen wie Amazon Marketplace verkaufen, sagt jetzt der Bundesgerichtshof.
 Jahrzehnte lagerte das Fossil eines Meeressauriers im Magazin des Urwelt-Museums Hauff. Nun haben Forschende es genauer untersucht. Das Exemplar zeigt, wie verschieden sich die Urzeitreptilien in der Jurazeit entwickelten.
Jahrzehnte lagerte das Fossil eines Meeressauriers im Magazin des Urwelt-Museums Hauff. Nun haben Forschende es genauer untersucht. Das Exemplar zeigt, wie verschieden sich die Urzeitreptilien in der Jurazeit entwickelten.
 Disorazol Z1 ist ein Naturstoff, der normalerweise von Bakterien produziert wird. Er kann das Wachstum von Zellen verhindern und diese auch zerstören. Daher wird er bereits seit Längerem als mögliches Antikrebsmittel untersucht. Jetzt konnten Magdeburger Chemiker erstmals den Wirkstoff im Labor nachbauen.
Disorazol Z1 ist ein Naturstoff, der normalerweise von Bakterien produziert wird. Er kann das Wachstum von Zellen verhindern und diese auch zerstören. Daher wird er bereits seit Längerem als mögliches Antikrebsmittel untersucht. Jetzt konnten Magdeburger Chemiker erstmals den Wirkstoff im Labor nachbauen.
 Fünf Tage nach dem Erdbeben in Myanmar haben Rettungskräfte einen Mann aus den Schuttbergen befreit. Es ist ein Hoffnungsschimmer, doch mit jeder Minute sinken die Chancen, noch Überlebende zu finden.
Fünf Tage nach dem Erdbeben in Myanmar haben Rettungskräfte einen Mann aus den Schuttbergen befreit. Es ist ein Hoffnungsschimmer, doch mit jeder Minute sinken die Chancen, noch Überlebende zu finden.
 Nach acht Jahren bekommt die Switch einen Nachfolger: Wie Nintendo jetzt bekannt gab, kommt die Switch 2 Anfang Juni auf den Markt. Auch zu den Funktionen und ersten Spielen gibt es Neuigkeiten.
Nach acht Jahren bekommt die Switch einen Nachfolger: Wie Nintendo jetzt bekannt gab, kommt die Switch 2 Anfang Juni auf den Markt. Auch zu den Funktionen und ersten Spielen gibt es Neuigkeiten.
 Dass sich eine Impfung gegen Gürtelrose positiv auf das Demenzrisiko auswirkt, wird bereits seit Längerem vermutet. Jetzt liefert eine neue Studie weitere gute Belege: Offenbar hat der kleine Pieks tatsächlich einen äußerst nützlichen Nebeneffekt. Allerdings profitiert nur eins der Geschlechter.
Dass sich eine Impfung gegen Gürtelrose positiv auf das Demenzrisiko auswirkt, wird bereits seit Längerem vermutet. Jetzt liefert eine neue Studie weitere gute Belege: Offenbar hat der kleine Pieks tatsächlich einen äußerst nützlichen Nebeneffekt. Allerdings profitiert nur eins der Geschlechter.
 "Mario Kart" kennt vermutlich jeder Fan von Videospielen. Wegen solcher Spieleklassiker, aber auch wegen neuer Games wurde die Switch von Nintendo zum großen Erfolg. Nun kommt eine neue Konsole auf den Markt - die aber das Rad nicht neu erfindet.
"Mario Kart" kennt vermutlich jeder Fan von Videospielen. Wegen solcher Spieleklassiker, aber auch wegen neuer Games wurde die Switch von Nintendo zum großen Erfolg. Nun kommt eine neue Konsole auf den Markt - die aber das Rad nicht neu erfindet.
 In Hamburg wurde ein Sarg aus Gusseisen gefunden, der nun im Magazin eines Museums verwahrt wird. Wahrscheinlich hat er eine lange Reise hinter sich und barg eine böse Überraschung für alle, die hineinschauten.
In Hamburg wurde ein Sarg aus Gusseisen gefunden, der nun im Magazin eines Museums verwahrt wird. Wahrscheinlich hat er eine lange Reise hinter sich und barg eine böse Überraschung für alle, die hineinschauten.
 In Afrika sorgt die Ausbreitung des früher als Affenpocken bezeichneten Mpox-Virus für eine internationale Notlage. Die EU-Gesundheitsbehörde ECDC schätzt das Risiko einer Ausbreitung der Ib-Variante in Europa als gering ein. Dennoch zeigt sich nun in Berlin ein hoher Anstieg an Neuinfektionen.
In Afrika sorgt die Ausbreitung des früher als Affenpocken bezeichneten Mpox-Virus für eine internationale Notlage. Die EU-Gesundheitsbehörde ECDC schätzt das Risiko einer Ausbreitung der Ib-Variante in Europa als gering ein. Dennoch zeigt sich nun in Berlin ein hoher Anstieg an Neuinfektionen.
 Nachdem Kieselalgen der Art Skeletonema marinoi Tausende Jahre lang auf dem Boden der Ostsee geschlafen hatten, holen Forscher sie nun ins Leben zurück. Und sind verblüfft: Die Algen haben nicht nur gerade so überlebt, sondern "sie wachsen, teilen sich und betreiben Photosynthese".
Nachdem Kieselalgen der Art Skeletonema marinoi Tausende Jahre lang auf dem Boden der Ostsee geschlafen hatten, holen Forscher sie nun ins Leben zurück. Und sind verblüfft: Die Algen haben nicht nur gerade so überlebt, sondern "sie wachsen, teilen sich und betreiben Photosynthese".
 Viele Hobbygärtner erinnern sich noch voller Grausen an das vergangene Jahr: Das Frühjahr war extrem feucht und eine "Superschnecke" wurde zur Plage. Diesmal ist es extrem trocken. Das macht der Spanischen Wegschnecke zu schaffen.
Viele Hobbygärtner erinnern sich noch voller Grausen an das vergangene Jahr: Das Frühjahr war extrem feucht und eine "Superschnecke" wurde zur Plage. Diesmal ist es extrem trocken. Das macht der Spanischen Wegschnecke zu schaffen.
 Miso ist eine fermentierte Würzpaste aus Japan, die aus Sojabohnen, Reis oder Gerste mittels Fermentation hergestellt werden kann. In einem Experiment auf der Internationalen Raumstation wurde die aromatische Paste im All produziert. Auf der Erde wird das Ergebnis untersucht und die Ergebnisse veröffentlicht.
Miso ist eine fermentierte Würzpaste aus Japan, die aus Sojabohnen, Reis oder Gerste mittels Fermentation hergestellt werden kann. In einem Experiment auf der Internationalen Raumstation wurde die aromatische Paste im All produziert. Auf der Erde wird das Ergebnis untersucht und die Ergebnisse veröffentlicht.
 Der Weltraum, unendliche Weiten – und lecker Miso. Forscher sind zu dem Ergebnis gekommen, dass im All produzierte Paste das »Wohlbefinden und die Leistungsfähigkeit von Astronauten verbessern« könnte.
Der Weltraum, unendliche Weiten – und lecker Miso. Forscher sind zu dem Ergebnis gekommen, dass im All produzierte Paste das »Wohlbefinden und die Leistungsfähigkeit von Astronauten verbessern« könnte.
 In Bolivien studieren Forscher die Rufe von Neuweltaffen und entdecken Erstaunliches: Die Tiere können bis zu dreieinhalb Oktaven jodeln, während Menschen nur eine Oktave schaffen. Das Geheimnis liegt wohl in einer besonderen Anatomie, die Menschen fehlt.
In Bolivien studieren Forscher die Rufe von Neuweltaffen und entdecken Erstaunliches: Die Tiere können bis zu dreieinhalb Oktaven jodeln, während Menschen nur eine Oktave schaffen. Das Geheimnis liegt wohl in einer besonderen Anatomie, die Menschen fehlt.
 Es ist ein Friedhof der nicht so kuscheligen Tiere: 19 riesige Amphibien starben vor rund 230 Millionen Jahren in einem alten Überschwemmungsgebiet. Warum? Paläontologen haben sich auf Spurensuche begeben.
Es ist ein Friedhof der nicht so kuscheligen Tiere: 19 riesige Amphibien starben vor rund 230 Millionen Jahren in einem alten Überschwemmungsgebiet. Warum? Paläontologen haben sich auf Spurensuche begeben.
 Seit Jahrzehnten dominieren US-Konzerne die Techindustrie und das Internet. Nun, nach Donald Trumps zweiter Amtsübernahme, formieren sich in Europa Gegenbewegungen und rufen zum Boykott auf. Wie viel Erfolg können sie haben?
Seit Jahrzehnten dominieren US-Konzerne die Techindustrie und das Internet. Nun, nach Donald Trumps zweiter Amtsübernahme, formieren sich in Europa Gegenbewegungen und rufen zum Boykott auf. Wie viel Erfolg können sie haben?
 Im Juni erscheint die Switch 2, unser Autor hatte sie schon in der Hand. Hier verrät er, was die spannendsten neuen Games und Funktionen sind und mit welcher Entscheidung Nintendo Gamer erzürnt.
Im Juni erscheint die Switch 2, unser Autor hatte sie schon in der Hand. Hier verrät er, was die spannendsten neuen Games und Funktionen sind und mit welcher Entscheidung Nintendo Gamer erzürnt.
 Hollywood-Stars wie Val Kilmer und David Lynch waren starke Raucher – und warnten selbst vor den Gefahren. Jetzt sind sie tot. Warum redet kaum jemand über die unsichtbare Epidemie?
Hollywood-Stars wie Val Kilmer und David Lynch waren starke Raucher – und warnten selbst vor den Gefahren. Jetzt sind sie tot. Warum redet kaum jemand über die unsichtbare Epidemie?
 Seit über elf Jahren liegt das Wrack einer Boeing 777, die mit 239 Menschen besetzt war, irgendwo im Indischen Ozean. Jetzt pausiert die vielleicht letzte Suche. Scheitert die Mission, bleibt die Unglücksursache wohl ein Geheimnis.
Seit über elf Jahren liegt das Wrack einer Boeing 777, die mit 239 Menschen besetzt war, irgendwo im Indischen Ozean. Jetzt pausiert die vielleicht letzte Suche. Scheitert die Mission, bleibt die Unglücksursache wohl ein Geheimnis.
 Wissenschaftler finden eine Methode, um aus Mondstaub Solarzellen herzustellen. Das könnte die Transportkosten um 99 Prozent reduzieren und dadurch den Bau von Mondkolonien erleichtern. Zwar sind die Zellen nicht besonders effizient - doch sie haben einen anderen Vorteil.
Wissenschaftler finden eine Methode, um aus Mondstaub Solarzellen herzustellen. Das könnte die Transportkosten um 99 Prozent reduzieren und dadurch den Bau von Mondkolonien erleichtern. Zwar sind die Zellen nicht besonders effizient - doch sie haben einen anderen Vorteil.
 Mit dem Galaxy A56 möchte Samsung wieder einen Verkaufsschlager in der Smartphone-Mittelklasse landen. Die Chancen dafür stehen gut, denn die Südkoreaner haben die richtigen Verbesserungen gemacht, ohne an der Preisschraube zu drehen.
Mit dem Galaxy A56 möchte Samsung wieder einen Verkaufsschlager in der Smartphone-Mittelklasse landen. Die Chancen dafür stehen gut, denn die Südkoreaner haben die richtigen Verbesserungen gemacht, ohne an der Preisschraube zu drehen.
 Klimaforscher melden für die vergangenen zwölf Monate die stärkste Erwärmung in Australien seit Beginn der Wetterstatistik. Besonders verheerend sind allerdings die Begleiterscheinungen: Stürme beschädigen Strände und Städte. Eine Fläche so groß wie Schweden steht unter Wasser.
Klimaforscher melden für die vergangenen zwölf Monate die stärkste Erwärmung in Australien seit Beginn der Wetterstatistik. Besonders verheerend sind allerdings die Begleiterscheinungen: Stürme beschädigen Strände und Städte. Eine Fläche so groß wie Schweden steht unter Wasser.
 Die Tür in Berliner Techno-Clubs ist hart, so viel ist bekannt. Doch wie entscheiden die Türsteher, wer reinkommt und wer nicht? Ein internationales Forscherteam entschlüsselt Entscheidungsmuster. Nicht alle Kriterien liegen in der Macht des Feiernden - und am Ende zählt das gewisse Extra.
Die Tür in Berliner Techno-Clubs ist hart, so viel ist bekannt. Doch wie entscheiden die Türsteher, wer reinkommt und wer nicht? Ein internationales Forscherteam entschlüsselt Entscheidungsmuster. Nicht alle Kriterien liegen in der Macht des Feiernden - und am Ende zählt das gewisse Extra.
 Zecken sind Parasiten, die sich in die Haut stechen, Blut saugen und dabei gefährliche Krankheiten übertragen können. Doch das Immunsystem eines Forschers hat sich so entwickelt, dass es die Spinnentiere tötet, bevor sie ihn infizieren können.
Zecken sind Parasiten, die sich in die Haut stechen, Blut saugen und dabei gefährliche Krankheiten übertragen können. Doch das Immunsystem eines Forschers hat sich so entwickelt, dass es die Spinnentiere tötet, bevor sie ihn infizieren können.
 Hollywoodstars wie Val Kilmer und David Lynch waren starke Raucher – und warnten selbst vor den Gefahren. Jetzt sind sie tot. Warum redet kaum jemand über die unsichtbare Epidemie?
Hollywoodstars wie Val Kilmer und David Lynch waren starke Raucher – und warnten selbst vor den Gefahren. Jetzt sind sie tot. Warum redet kaum jemand über die unsichtbare Epidemie?
 Die Nasa will auf dem Mond eine Basis für Marsmissione schaffen. Aber wie versorgt man die am besten mit Energie? Wissenschaftler aus Potsdam haben eine Idee.
Die Nasa will auf dem Mond eine Basis für Marsmissione schaffen. Aber wie versorgt man die am besten mit Energie? Wissenschaftler aus Potsdam haben eine Idee.
 Die Menschen im Süden und im Mittleren Westen der USA haben mit schweren Stürmen und Tornados zu kämpfen. Meteorologen erklären die Ursache und warnen vor dem Wochenende.
Die Menschen im Süden und im Mittleren Westen der USA haben mit schweren Stürmen und Tornados zu kämpfen. Meteorologen erklären die Ursache und warnen vor dem Wochenende.
 Die Nasa will auf dem Mond eine Basis für Marsmissionen schaffen. Aber wie versorgt man die am besten mit Energie? Wissenschaftler aus Potsdam haben eine Idee.
Die Nasa will auf dem Mond eine Basis für Marsmissionen schaffen. Aber wie versorgt man die am besten mit Energie? Wissenschaftler aus Potsdam haben eine Idee.
 Mit einer groß angelegten Aktion ist die Polizei gegen eine Bande vorgegangen, die im Internet Drogen und Medikamente verkauft haben soll. Besonders brisant: Einer der Beschuldigten ist vom Fach.
Mit einer groß angelegten Aktion ist die Polizei gegen eine Bande vorgegangen, die im Internet Drogen und Medikamente verkauft haben soll. Besonders brisant: Einer der Beschuldigten ist vom Fach.
 Diäten gibt es viele - aber welche ist die erfolgversprechendste? Eine neue Studie vergleicht nun zwei Methoden miteinander: Bei der einen wird jeden Tag auf Kalorien verzichtet, bei der anderen nur jeden zweiten. Das Ergebnis überrascht selbst eine Forscherin.
Diäten gibt es viele - aber welche ist die erfolgversprechendste? Eine neue Studie vergleicht nun zwei Methoden miteinander: Bei der einen wird jeden Tag auf Kalorien verzichtet, bei der anderen nur jeden zweiten. Das Ergebnis überrascht selbst eine Forscherin.
 Laut Berechnungen der Nasa könnte Asteroid 2024 YR4 in knapp acht Jahren auf dem Mond einschlagen. Das Risiko wird aktuell mit fast vier Prozent angegeben. Die dabei freigesetzte Energie wäre gewaltig - und eine Kollision könnte auch Folgen für die Erde haben.
Laut Berechnungen der Nasa könnte Asteroid 2024 YR4 in knapp acht Jahren auf dem Mond einschlagen. Das Risiko wird aktuell mit fast vier Prozent angegeben. Die dabei freigesetzte Energie wäre gewaltig - und eine Kollision könnte auch Folgen für die Erde haben.
 Ein Dutzend deutsche Männer waren schon im All, aber noch keine Frau. Bis jetzt: Rund vier Tage lang flog Rabea Rogge mit einem SpaceX-Team um die Erdpole. Auch ihre Landung war nun besonders.
Ein Dutzend deutsche Männer waren schon im All, aber noch keine Frau. Bis jetzt: Rund vier Tage lang flog Rabea Rogge mit einem SpaceX-Team um die Erdpole. Auch ihre Landung war nun besonders.
 Dubiose Onlineanbieter verlangen Wucherpreise für das digitale Visum ETA, das Deutsche seit dieser Woche für Großbritannien brauchen. Wie man der Falle entgeht.
Dubiose Onlineanbieter verlangen Wucherpreise für das digitale Visum ETA, das Deutsche seit dieser Woche für Großbritannien brauchen. Wie man der Falle entgeht.
 Fast 47 Jahre nach Sigmund Jähn reist auch die erste deutsche Frau ins All. Nach vier Tagen kehrt Rabea Rogge zurück auf die Erde. In dieser Zeit umkreiste sie in der "Dragon"-Kapsel 55 Mal die Erde.. An Bord war sie für die Koordination der Forschung verantwortlich.
Fast 47 Jahre nach Sigmund Jähn reist auch die erste deutsche Frau ins All. Nach vier Tagen kehrt Rabea Rogge zurück auf die Erde. In dieser Zeit umkreiste sie in der "Dragon"-Kapsel 55 Mal die Erde.. An Bord war sie für die Koordination der Forschung verantwortlich.
 Während seiner ersten Amtszeit als US-Präsident hatte Donald Trump ein Verbot der Social-Media-Plattform TikTok selbst initiiert. Nun sollte es in Kraft treten. Doch Trump will das verhindern.
Während seiner ersten Amtszeit als US-Präsident hatte Donald Trump ein Verbot der Social-Media-Plattform TikTok selbst initiiert. Nun sollte es in Kraft treten. Doch Trump will das verhindern.
 Der Drang, perfekt zu essen, kann zu einer Reihe psychischer und physischer Probleme führen. Menschen, die unter Orthorexie leiden, ordnen meist ihr ganzes Leben der vermeintlich richtigen Ernährung unter. Was dahintersteckt, wer betroffen ist und was helfen kann.
Der Drang, perfekt zu essen, kann zu einer Reihe psychischer und physischer Probleme führen. Menschen, die unter Orthorexie leiden, ordnen meist ihr ganzes Leben der vermeintlich richtigen Ernährung unter. Was dahintersteckt, wer betroffen ist und was helfen kann.
 Mpox – ist doch weit weg, oder? Nein, aktuelle Varianten des Virus kursieren auch in Deutschland. Wenn die Seuche nicht als globale Bedrohung bekämpft wird, warnen Experten, könnte sich das schwer rächen.
Mpox – ist doch weit weg, oder? Nein, aktuelle Varianten des Virus kursieren auch in Deutschland. Wenn die Seuche nicht als globale Bedrohung bekämpft wird, warnen Experten, könnte sich das schwer rächen.
 Die Ausbreitung des früher als Affenpocken bezeichneten Mpox-Virus sorgt vor allem in Afrika für eine internationale Notlage. Bisher schätzt die EU-Gesundheitsbehörde ECDC das Risiko einer Ausbreitung in Europa als gering ein - trotz der Häufung in Berlin. Jetzt schlagen britische Forscher Alarm.
Die Ausbreitung des früher als Affenpocken bezeichneten Mpox-Virus sorgt vor allem in Afrika für eine internationale Notlage. Bisher schätzt die EU-Gesundheitsbehörde ECDC das Risiko einer Ausbreitung in Europa als gering ein - trotz der Häufung in Berlin. Jetzt schlagen britische Forscher Alarm.
 Wird es auf der Erde eines Tages so heiß wie auf der Venus? Forscher warnen: Am Himmel gibt es immer weniger Wolken. Die Folgen für das Klima könnten dramatisch sein.
Wird es auf der Erde eines Tages so heiß wie auf der Venus? Forscher warnen: Am Himmel gibt es immer weniger Wolken. Die Folgen für das Klima könnten dramatisch sein.
 Ein Dutzend deutsche Männer war schon im All, aber noch keine Frau. Bis jetzt: Rund vier Tage lang flog Rabea Rogge mit einem SpaceX-Team um die Erdpole. Auch ihre Landung war besonders.
Ein Dutzend deutsche Männer war schon im All, aber noch keine Frau. Bis jetzt: Rund vier Tage lang flog Rabea Rogge mit einem SpaceX-Team um die Erdpole. Auch ihre Landung war besonders.
 Es geht ihnen um Trump, Musk oder Bezos, um Datensicherheit oder die Stärkung der heimischen Wirtschaft: Viele Europäer würden sich gern von Techdiensten aus den USA lösen. Zehn niedrigschwellige Ideen für jede und jeden.
Es geht ihnen um Trump, Musk oder Bezos, um Datensicherheit oder die Stärkung der heimischen Wirtschaft: Viele Europäer würden sich gern von Techdiensten aus den USA lösen. Zehn niedrigschwellige Ideen für jede und jeden.
 Es wird langsam gefährlich eng im Weltraum: Mehr als eine Million Schrottteile ziehen ihre Kreise um die Erde - und es werden ständig mehr. Doch was hat das für Folgen? Experten warnen vor zunehmenden Kollisionen und Lichtverschmutzung.
Es wird langsam gefährlich eng im Weltraum: Mehr als eine Million Schrottteile ziehen ihre Kreise um die Erde - und es werden ständig mehr. Doch was hat das für Folgen? Experten warnen vor zunehmenden Kollisionen und Lichtverschmutzung.
 Es war ein Kampf mit »katastrophalem Ende«: Skelette von bis zu 150 römischen Soldaten weisen auf ein Gemetzel vor knapp 2000 Jahren hin. Entdeckt wurden die Überreste bei der Sanierung eines Fußballplatzes.
Es war ein Kampf mit »katastrophalem Ende«: Skelette von bis zu 150 römischen Soldaten weisen auf ein Gemetzel vor knapp 2000 Jahren hin. Entdeckt wurden die Überreste bei der Sanierung eines Fußballplatzes.
 Weil Trump in seiner Zollwut die Wirtschaft zu lähmen droht, nennen ihn manche schon »Degrowth Donald«. Doch es gibt tauglichere Mittel, mit der Klimakrise klarzukommen.
Weil Trump in seiner Zollwut die Wirtschaft zu lähmen droht, nennen ihn manche schon »Degrowth Donald«. Doch es gibt tauglichere Mittel, mit der Klimakrise klarzukommen.
 Als Vergeltung gegen Trumps neue Zölle beschließt China Exportbeschränkungen auf sieben Seltene Erden: Rohstoffe, die unentbehrlich für zivile und militärische US-Hightech-Produkte sind. Und Xi Jinping hat noch einiges in der Hinterhand.
Als Vergeltung gegen Trumps neue Zölle beschließt China Exportbeschränkungen auf sieben Seltene Erden: Rohstoffe, die unentbehrlich für zivile und militärische US-Hightech-Produkte sind. Und Xi Jinping hat noch einiges in der Hinterhand.
 Apple soll in Frankreich eine Geldstrafe in Höhe von 150 Millionen Euro zahlen. Die Kartellwächter stören sich an der Umsetzung einer Datenschutzfunktion. Ändern muss der Konzern aber offenbar nichts.
Apple soll in Frankreich eine Geldstrafe in Höhe von 150 Millionen Euro zahlen. Die Kartellwächter stören sich an der Umsetzung einer Datenschutzfunktion. Ändern muss der Konzern aber offenbar nichts.
 Seit Jahrzehnten nehmen die Dürreperioden auf der Erde zu, die Menge des an Land gespeicherten Wassers sinkt deutlich. Und die Verlagerung des Wassers zu den Ozeanen lässt den Meeresspiegel steigen. Diese Entwicklung war in drei Jahren nacheinander besonders extrem.
Seit Jahrzehnten nehmen die Dürreperioden auf der Erde zu, die Menge des an Land gespeicherten Wassers sinkt deutlich. Und die Verlagerung des Wassers zu den Ozeanen lässt den Meeresspiegel steigen. Diese Entwicklung war in drei Jahren nacheinander besonders extrem.
 Dinge kaufen ist eine tolle Sache, wird uns von Kindesbeinen an suggeriert. Doch wann wird das Shoppen zur Sucht? In Zeiten von Social Media verfallen Menschen noch leichter in einen Kaufrausch - und shoppen sich um Geld, Lebensglück und ihre psychische Gesundheit.
Dinge kaufen ist eine tolle Sache, wird uns von Kindesbeinen an suggeriert. Doch wann wird das Shoppen zur Sucht? In Zeiten von Social Media verfallen Menschen noch leichter in einen Kaufrausch - und shoppen sich um Geld, Lebensglück und ihre psychische Gesundheit.
 Als Vergeltung gegen Trumps neue Zölle beschließt China Exportbeschränkungen auf sieben seltene Erden: Rohstoffe, die unentbehrlich für zivile und militärische US-Hightechprodukte sind. Und Xi Jinping hat noch einiges in der Hinterhand.
Als Vergeltung gegen Trumps neue Zölle beschließt China Exportbeschränkungen auf sieben seltene Erden: Rohstoffe, die unentbehrlich für zivile und militärische US-Hightechprodukte sind. Und Xi Jinping hat noch einiges in der Hinterhand.
 Computerspielende Millionäre oder verarmte Kaufsüchtige: Wild wird darüber spekuliert, wer in In-Game-Shops riesige Summen springen lässt. Hier kommen echte Vielkäufer und ein Brancheninsider zu Wort.
Computerspielende Millionäre oder verarmte Kaufsüchtige: Wild wird darüber spekuliert, wer in In-Game-Shops riesige Summen springen lässt. Hier kommen echte Vielkäufer und ein Brancheninsider zu Wort.
 Millionen-Preisgelder, gestiftet von Silicon-Valley-Größen: Die Gewinner des diesjährigen Breakthrough Prize stehen fest. Der Glamour der Verleihung steht im krassen Gegensatz zur neuen Wirklichkeit von Forschenden in den USA.
Millionen-Preisgelder, gestiftet von Silicon-Valley-Größen: Die Gewinner des diesjährigen Breakthrough Prize stehen fest. Der Glamour der Verleihung steht im krassen Gegensatz zur neuen Wirklichkeit von Forschenden in den USA.
 Bei deutschen Usern taucht plötzlich ein bunter Kreis in WhatsApp auf. Dahinter steckt Meta AI. Zu übersehen ist die neue KI-Funktion kaum, dabei wirkt sie hierzulande noch ziemlich halbgar.
Bei deutschen Usern taucht plötzlich ein bunter Kreis in WhatsApp auf. Dahinter steckt Meta AI. Zu übersehen ist die neue KI-Funktion kaum, dabei wirkt sie hierzulande noch ziemlich halbgar.
 Im Kampf um die Vorherrschaft um künstliche Intelligenz hat der ChatGPT-Entwickler ein Rekordinvestment bekannt gegeben. Das erhöht den Wert der Firma beträchtlich. Der neue Bildgenerator sorgt für Furore und Kritik.
Im Kampf um die Vorherrschaft um künstliche Intelligenz hat der ChatGPT-Entwickler ein Rekordinvestment bekannt gegeben. Das erhöht den Wert der Firma beträchtlich. Der neue Bildgenerator sorgt für Furore und Kritik.
 Ein milder Winter und viel Sonnenschein - das Jahr 2024 war in Deutschland das wärmste seit Beginn der Messungen. Der Klimawandel zeigt sich immer deutlicher, sagt der Deutsche Wetterdienst. Immerhin: Der Grundwasserspeicher wurde durch viel Regen aufgefüllt.
Ein milder Winter und viel Sonnenschein - das Jahr 2024 war in Deutschland das wärmste seit Beginn der Messungen. Der Klimawandel zeigt sich immer deutlicher, sagt der Deutsche Wetterdienst. Immerhin: Der Grundwasserspeicher wurde durch viel Regen aufgefüllt.
 Ein Dutzend deutsche Männer waren schon im Weltraum, aber noch keine Frau - bis jetzt: Die Berlinerin Rabea Rogge startet an Bord einer Rakete des US-Raumfahrtunternehmens SpaceX zu einem Überflug der Polarregionen ins All.
Ein Dutzend deutsche Männer waren schon im Weltraum, aber noch keine Frau - bis jetzt: Die Berlinerin Rabea Rogge startet an Bord einer Rakete des US-Raumfahrtunternehmens SpaceX zu einem Überflug der Polarregionen ins All.
 Hat man einmal schlechten Fisch oder Fleischsalat gegessen, verdirbt einem das den Appetit auf diese Speisen für sehr lange Zeit - der Körper wehrt sich dann dagegen. Auch wenn das Essen das nächste Mal vollkommen in Ordnung ist. Warum das so ist, hat ein Forschungsteam herausgefunden.
Hat man einmal schlechten Fisch oder Fleischsalat gegessen, verdirbt einem das den Appetit auf diese Speisen für sehr lange Zeit - der Körper wehrt sich dann dagegen. Auch wenn das Essen das nächste Mal vollkommen in Ordnung ist. Warum das so ist, hat ein Forschungsteam herausgefunden.
 Die Last der Verhütung liegt meist bei Frauen. Nun wird erstmals eine hormonfreie Antibabypille für Männer klinisch getestet. Sie könnte eine gerechtere Verteilung der Verantwortung für Familienplanung ermöglichen und Männern mehr Autonomie bieten.
Die Last der Verhütung liegt meist bei Frauen. Nun wird erstmals eine hormonfreie Antibabypille für Männer klinisch getestet. Sie könnte eine gerechtere Verteilung der Verantwortung für Familienplanung ermöglichen und Männern mehr Autonomie bieten.
 Rund 800 Jahre lang ruhten die Vulkane im Südwesten Islands, nun strömt wieder Lava. Die kommende Zeit wird unruhig auf der Reykjanes-Halbinsel, da sind sich die Wissenschaftler sicher. Für die Anwohner wird es schwierig.
Rund 800 Jahre lang ruhten die Vulkane im Südwesten Islands, nun strömt wieder Lava. Die kommende Zeit wird unruhig auf der Reykjanes-Halbinsel, da sind sich die Wissenschaftler sicher. Für die Anwohner wird es schwierig.
 Der Schattenwolf ist vor Tausenden von Jahren ausgestorben. Eine Firma in den USA will die Art nun mithilfe moderner Technologie zurückgebracht haben. Schon vor einigen Wochen sorgt das Unternehmen mit der Züchtung von "Wollhaarmäusen" für Aufsehen.
Der Schattenwolf ist vor Tausenden von Jahren ausgestorben. Eine Firma in den USA will die Art nun mithilfe moderner Technologie zurückgebracht haben. Schon vor einigen Wochen sorgt das Unternehmen mit der Züchtung von "Wollhaarmäusen" für Aufsehen.
 Bei Bauarbeiten an einem Wiener Sportplatz stoßen Arbeiter auf menschliche Überreste. Dann wird klar: Vor fast 2000 Jahren wurden hier rund 150 Männer "auf grausamste Weise abgeschlachtet". Für Archäologen ein spektakulärer Fund, der Erkenntnisse über die Entstehung der Stadt liefern könnte.
Bei Bauarbeiten an einem Wiener Sportplatz stoßen Arbeiter auf menschliche Überreste. Dann wird klar: Vor fast 2000 Jahren wurden hier rund 150 Männer "auf grausamste Weise abgeschlachtet". Für Archäologen ein spektakulärer Fund, der Erkenntnisse über die Entstehung der Stadt liefern könnte.
 Die Auswirkungen des Klimawandels lassen sich vor allem anhand langjähriger Messungen feststellen. Die Temperaturen steigen laut der regelmäßig veröffentlichten Daten immer weiter. Das bewirkt auch eine zunehmende Trockenheit. Nun bricht der März erneut Rekorde.
Die Auswirkungen des Klimawandels lassen sich vor allem anhand langjähriger Messungen feststellen. Die Temperaturen steigen laut der regelmäßig veröffentlichten Daten immer weiter. Das bewirkt auch eine zunehmende Trockenheit. Nun bricht der März erneut Rekorde.
 Trotz Regierungsmaßnahmen bleibt der illegale Goldabbau im Amazonas-Regenwald ein gravierendes Problem. Die Auswirkungen sind ökologisch verheerend. Bewaffnete Schürfer dringen in geschützte Gebiete vor und holzen großflächig Bäume ab.
Trotz Regierungsmaßnahmen bleibt der illegale Goldabbau im Amazonas-Regenwald ein gravierendes Problem. Die Auswirkungen sind ökologisch verheerend. Bewaffnete Schürfer dringen in geschützte Gebiete vor und holzen großflächig Bäume ab.
 Pflanzen und Tiere leiden unter Trockenheit. Bleibe die Lage so, drohten Waldbrände und Ernteeinbußen, warnt Bundesumweltministerin Steffi Lemke. Der niedrige Wasserstand des Rheins beeinträchtige zudem die Wirtschaft.
Pflanzen und Tiere leiden unter Trockenheit. Bleibe die Lage so, drohten Waldbrände und Ernteeinbußen, warnt Bundesumweltministerin Steffi Lemke. Der niedrige Wasserstand des Rheins beeinträchtige zudem die Wirtschaft.
 Die Art wurde durch »Game of Thrones« bekannt, starb aber vor 13.000 Jahren aus. Eine US-Firma hat nun Jungtiere gezüchtet, die wie der »Dire Wolf« aus der Serie ein dichtes weißes Fell besitzen.
Die Art wurde durch »Game of Thrones« bekannt, starb aber vor 13.000 Jahren aus. Eine US-Firma hat nun Jungtiere gezüchtet, die wie der »Dire Wolf« aus der Serie ein dichtes weißes Fell besitzen.
 US-Kunden decken sich einem Bericht zufolge mit Apple-Geräten ein. Gleichzeitig soll der Konzern noch eilig Nachschub einfliegen und an einer langfristigen Strategie gegen die Zölle arbeiten.
US-Kunden decken sich einem Bericht zufolge mit Apple-Geräten ein. Gleichzeitig soll der Konzern noch eilig Nachschub einfliegen und an einer langfristigen Strategie gegen die Zölle arbeiten.
 Drei Jahre lang haben Forscher untersucht, wo und wie klimaschädliches CO₂ in der Nordsee gespeichert werden könnte. Nun nennen sie konkrete Stellen rund hundert Kilometer vor der Küste, weisen aber auch auf Risiken hin.
Drei Jahre lang haben Forscher untersucht, wo und wie klimaschädliches CO₂ in der Nordsee gespeichert werden könnte. Nun nennen sie konkrete Stellen rund hundert Kilometer vor der Küste, weisen aber auch auf Risiken hin.
 US-Präsident Donald Trump kürzt Gelder für das National Institute of Health drastisch. Wissenschaftliche Mitarbeiter werden entlassen, klinische Studien ausgebremst. Auch eine experimentelle Krebstherapie ist betroffen. Für die Patientinnen und Patienten eine Hiobsbotschaft.
US-Präsident Donald Trump kürzt Gelder für das National Institute of Health drastisch. Wissenschaftliche Mitarbeiter werden entlassen, klinische Studien ausgebremst. Auch eine experimentelle Krebstherapie ist betroffen. Für die Patientinnen und Patienten eine Hiobsbotschaft.
 Schon länger streiten Wissenschaftler über das Aussterben der Dinosaurier: War ein Asteroideneinschlag schuld, oder ging es schon vorher bergab mit den berühmten Reptilien? Fehlende Fossilien zum Ende der Dino-Ära lassen Letzteres vermuten. Eine Studie bietet jedoch einen neuen Ansatz.
Schon länger streiten Wissenschaftler über das Aussterben der Dinosaurier: War ein Asteroideneinschlag schuld, oder ging es schon vorher bergab mit den berühmten Reptilien? Fehlende Fossilien zum Ende der Dino-Ära lassen Letzteres vermuten. Eine Studie bietet jedoch einen neuen Ansatz.
 Wie genau wurde die »Titanic« auf ihrer Jungfernfahrt von dem Eisberg beschädigt, mit dem sie kollidierte? Das soll eine neue Computersimulation erklären. Ingenieure an Bord kämpften offenbar bis zum Schluss darum, das Licht an Bord intakt zu halten.
Wie genau wurde die »Titanic« auf ihrer Jungfernfahrt von dem Eisberg beschädigt, mit dem sie kollidierte? Das soll eine neue Computersimulation erklären. Ingenieure an Bord kämpften offenbar bis zum Schluss darum, das Licht an Bord intakt zu halten.
 Einst zählte der Aralsee zu den größten Binnengewässern der Erde. Weil sein Wasser für Projekte in der Landwirtschaft abgezapft wurde, ist er weitgehend verschwunden. Das hat Folgen bis in den Erdmantel.
Einst zählte der Aralsee zu den größten Binnengewässern der Erde. Weil sein Wasser für Projekte in der Landwirtschaft abgezapft wurde, ist er weitgehend verschwunden. Das hat Folgen bis in den Erdmantel.
 Ist es tatsächlich gelungen, Schattenwölfe wie die aus der Serie »Game of Thrones« zum Leben zu erwecken? Tiere, die vor 13.000 Jahren ausgestorben sind? Forscher sehen das Gen-Experiment kritisch.
Ist es tatsächlich gelungen, Schattenwölfe wie die aus der Serie »Game of Thrones« zum Leben zu erwecken? Tiere, die vor 13.000 Jahren ausgestorben sind? Forscher sehen das Gen-Experiment kritisch.
 Die Raumfahrt ist eines der wenigen Gebiete, auf denen Russland und die USA auch nach dem russischen Angriff auf die Ukraine kooperieren. Nun hat wieder eine Crew aus beiden Ländern die Raumstation ISS erreicht. Sie soll zusammen erst am Ende des Jahres zur Erde zurückkehren.
Die Raumfahrt ist eines der wenigen Gebiete, auf denen Russland und die USA auch nach dem russischen Angriff auf die Ukraine kooperieren. Nun hat wieder eine Crew aus beiden Ländern die Raumstation ISS erreicht. Sie soll zusammen erst am Ende des Jahres zur Erde zurückkehren.
 Im Juni erscheint die Switch 2, unser Autor hatte sie schon in der Hand. Hier verrät er, was die spannendsten neuen Games und Funktionen sind und mit welcher Entscheidung Nintendo Gamer erzürnt.
Im Juni erscheint die Switch 2, unser Autor hatte sie schon in der Hand. Hier verrät er, was die spannendsten neuen Games und Funktionen sind und mit welcher Entscheidung Nintendo Gamer erzürnt.
 Der Wasserstand am Bodensee ist außergewöhnlich niedrig, Dürre macht auch anderen Orten zu schaffen. Wissenschaftlerin Dörthe Tetzlaff erklärt, wie groß das Problem ist und was nun helfen würde.
Der Wasserstand am Bodensee ist außergewöhnlich niedrig, Dürre macht auch anderen Orten zu schaffen. Wissenschaftlerin Dörthe Tetzlaff erklärt, wie groß das Problem ist und was nun helfen würde.
 Die Abhängigkeit von amerikanischen Techkonzernen ist Europa schon lange ein Dorn im Auge. Doch eigene Projekte zeigen häufig, wie weit man hinter der IT-Supermacht zurückliegt. Nur eines ist wirklich erfolgreich und besser.
Die Abhängigkeit von amerikanischen Techkonzernen ist Europa schon lange ein Dorn im Auge. Doch eigene Projekte zeigen häufig, wie weit man hinter der IT-Supermacht zurückliegt. Nur eines ist wirklich erfolgreich und besser.
 Jährlich gelangen tonnenweise schädliche Kunststoffe in die Umwelt. Besonders Mikroplastik verschmutzt die Natur. Die EU will jetzt mit stärkeren Gesetzen dagegen vorgehen. Betroffen sind nicht nur Unternehmen jeder Größe, sondern auch Schiffe. Die Bedingungen verschärfen sich.
Jährlich gelangen tonnenweise schädliche Kunststoffe in die Umwelt. Besonders Mikroplastik verschmutzt die Natur. Die EU will jetzt mit stärkeren Gesetzen dagegen vorgehen. Betroffen sind nicht nur Unternehmen jeder Größe, sondern auch Schiffe. Die Bedingungen verschärfen sich.
 Deutschland erlebt derzeit eine anhaltende Trockenperiode - Regen kommt allenfalls als kurzer Schauer. Das macht nicht nur der Landwirtschaft und Schifffahrt zu schaffen. Auch die Natur leidet. Droht ein Dürre-Sommer?
Deutschland erlebt derzeit eine anhaltende Trockenperiode - Regen kommt allenfalls als kurzer Schauer. Das macht nicht nur der Landwirtschaft und Schifffahrt zu schaffen. Auch die Natur leidet. Droht ein Dürre-Sommer?
 Ein Forscherteam aus Japan findet heraus: Wurde ein Mensch in der kalten Jahreszeit gezeugt, ist er später im Leben seltener übergewichtig. Die Studie zeigt, dass diese Menschen mehr sogenanntes braunes Fett im Körper besitzen, das Kalorien verbrennt.
Ein Forscherteam aus Japan findet heraus: Wurde ein Mensch in der kalten Jahreszeit gezeugt, ist er später im Leben seltener übergewichtig. Die Studie zeigt, dass diese Menschen mehr sogenanntes braunes Fett im Körper besitzen, das Kalorien verbrennt.
 Die ersten Siedler von Malta sind wohl auf Einbäumen, Flößen oder anderen Gefährten auf die Insel im Mittelmeer gelangt und das deutlich früher als vermutet. Wie sie dort überlebten, haben Wissenschaftler aus Jena nun erforscht.
Die ersten Siedler von Malta sind wohl auf Einbäumen, Flößen oder anderen Gefährten auf die Insel im Mittelmeer gelangt und das deutlich früher als vermutet. Wie sie dort überlebten, haben Wissenschaftler aus Jena nun erforscht.
 Kauen statt impfen? Wenn es nach einem internationalen Forschungsteam geht, könnte das bald schon Realität werden. Die Wissenschaftler haben einen Kaugummi entwickelt, der bestimmte Viren neutralisieren kann. Die wichtigste Zutat: eine Bohne.
Kauen statt impfen? Wenn es nach einem internationalen Forschungsteam geht, könnte das bald schon Realität werden. Die Wissenschaftler haben einen Kaugummi entwickelt, der bestimmte Viren neutralisieren kann. Die wichtigste Zutat: eine Bohne.
 Mit dem Fortschritt künstlicher Intelligenz steigt der weltweite Energiebedarf. Forscher der Firma Lightmatter stellen nun einen photonischen Prozessor vor, der KI-Modelle energieeffizienter betreiben soll. Die Studie offenbart das Potenzial der Technologie - doch es bleiben Herausforderungen.
Mit dem Fortschritt künstlicher Intelligenz steigt der weltweite Energiebedarf. Forscher der Firma Lightmatter stellen nun einen photonischen Prozessor vor, der KI-Modelle energieeffizienter betreiben soll. Die Studie offenbart das Potenzial der Technologie - doch es bleiben Herausforderungen.
 Während seiner ersten Amtszeit als US-Präsident hatte Donald Trump ein Verbot der Social-Media-Plattform TikTok selbst initiiert. Nun sollte es in Kraft treten. Doch Trump will das verhindern.
Während seiner ersten Amtszeit als US-Präsident hatte Donald Trump ein Verbot der Social-Media-Plattform TikTok selbst initiiert. Nun sollte es in Kraft treten. Doch Trump will das verhindern.
 Werbeunterbrechungen auf YouTube nerven. Will man sie per Premium-Abo ganz loswerden, wird es schnell teuer. Das Paket Premium Lite soll nun als Einstiegsangebot fungieren, hat aber einen großen Haken.
Werbeunterbrechungen auf YouTube nerven. Will man sie per Premium-Abo ganz loswerden, wird es schnell teuer. Das Paket Premium Lite soll nun als Einstiegsangebot fungieren, hat aber einen großen Haken.
 Rund vier Prozent der Menschen in Deutschland zwischen 16 und 74 Jahren waren noch nie online. Das teilt das Statistische Bundesamt mit. Im EU-Vergleich zeigen sich deutliche Unterschiede.
Rund vier Prozent der Menschen in Deutschland zwischen 16 und 74 Jahren waren noch nie online. Das teilt das Statistische Bundesamt mit. Im EU-Vergleich zeigen sich deutliche Unterschiede.
 OpenAI-Mitgründer Elon Musk schießt seit Monaten gegen das KI-Unternehmen. Nun klagt der ChatGPT-Entwickler zurück, um Musks Angriffe und sein »falsches Übernahmeangebot« zu stoppen.
OpenAI-Mitgründer Elon Musk schießt seit Monaten gegen das KI-Unternehmen. Nun klagt der ChatGPT-Entwickler zurück, um Musks Angriffe und sein »falsches Übernahmeangebot« zu stoppen.
 Ein internationales Team veröffentlicht erstmals die vollständigen Genome von sechs Menschenaffenarten. Dies erlaubt tiefere Einblicke in ihre Evolution und genetische Verwandtschaft zum Menschen. Die Forscher hoffen auch auf neue Erkenntnisse zur Übertragung von Krankheiten.
Ein internationales Team veröffentlicht erstmals die vollständigen Genome von sechs Menschenaffenarten. Dies erlaubt tiefere Einblicke in ihre Evolution und genetische Verwandtschaft zum Menschen. Die Forscher hoffen auch auf neue Erkenntnisse zur Übertragung von Krankheiten.
 Sie gelten als nachhaltiger Fisch, doch in der Bewertung der Organisation MSC wurden Makrelen nun herabgestuft. Es gibt aber Alternativen.
Sie gelten als nachhaltiger Fisch, doch in der Bewertung der Organisation MSC wurden Makrelen nun herabgestuft. Es gibt aber Alternativen.
 Deutschland soll sich bei Kernfusion weltweit an die Spitze setzen - so der Plan von Union und SPD. Der Bau des weltweit ersten Kraftwerks dieser Art wird im Koalitionsvertrag als Ziel ausgegeben. Doch kann Deutschland das leisten? Experten zeigen sich zuversichtlich.
Deutschland soll sich bei Kernfusion weltweit an die Spitze setzen - so der Plan von Union und SPD. Der Bau des weltweit ersten Kraftwerks dieser Art wird im Koalitionsvertrag als Ziel ausgegeben. Doch kann Deutschland das leisten? Experten zeigen sich zuversichtlich.
 Wer ein günstiges und kompaktes, aber leistungsstarkes und langlebiges Smartphone sucht, sollte einen Blick auf das neue Google Pixel 9a werfen. Denn im Praxistest zeigt es mit einer flachen Rückseite, starker Hardware und überlegener Software zum Mittelklasse-Preis Oberklasse-Niveau.
Wer ein günstiges und kompaktes, aber leistungsstarkes und langlebiges Smartphone sucht, sollte einen Blick auf das neue Google Pixel 9a werfen. Denn im Praxistest zeigt es mit einer flachen Rückseite, starker Hardware und überlegener Software zum Mittelklasse-Preis Oberklasse-Niveau.
 Weil Trump in seiner Zollwut die Wirtschaft zu lähmen droht, nennen ihn manche schon »Degrowth Donald«. Doch es gibt tauglichere Mittel, mit der Klimakrise klarzukommen.
Weil Trump in seiner Zollwut die Wirtschaft zu lähmen droht, nennen ihn manche schon »Degrowth Donald«. Doch es gibt tauglichere Mittel, mit der Klimakrise klarzukommen.
 Parkinson ist eine tückische Erkrankung, die schon beginnt, bevor sich Symptome zeigen. Und die Zahl der Betroffenen steigt weltweit stark an. Aber es gibt Möglichkeiten, vorzubeugen - denn nur zehn Prozent der Parkinson-Erkrankungen sind genetisch bedingt.
Parkinson ist eine tückische Erkrankung, die schon beginnt, bevor sich Symptome zeigen. Und die Zahl der Betroffenen steigt weltweit stark an. Aber es gibt Möglichkeiten, vorzubeugen - denn nur zehn Prozent der Parkinson-Erkrankungen sind genetisch bedingt.
 Die Dürre ist zurück, Deutschland hat ein Wasserproblem. Davor warnen Forscher seit Jahren. Vorsorge wird aber kleingeschrieben, auch im neuen Koalitionsvertrag. Das Thema kommt darin nur an zwei Stellen vor.
Die Dürre ist zurück, Deutschland hat ein Wasserproblem. Davor warnen Forscher seit Jahren. Vorsorge wird aber kleingeschrieben, auch im neuen Koalitionsvertrag. Das Thema kommt darin nur an zwei Stellen vor.
 In der Maya-Stadt Tikal haben Forschende einen besonderen Fund gemacht: Sie haben einen Altar ausgegraben, der wohl nicht aus Maya-Hand stammt. Stattdessen liefert er Hinweise auf einen alten Konflikt.
In der Maya-Stadt Tikal haben Forschende einen besonderen Fund gemacht: Sie haben einen Altar ausgegraben, der wohl nicht aus Maya-Hand stammt. Stattdessen liefert er Hinweise auf einen alten Konflikt.
 Manche Stoffe können die Hormone beeinflussen oder Allergien auslösen. Nun will die EU Kinderspielzeug sicherer machen. Auch bei der Transparenz soll es neue Regeln geben.
Manche Stoffe können die Hormone beeinflussen oder Allergien auslösen. Nun will die EU Kinderspielzeug sicherer machen. Auch bei der Transparenz soll es neue Regeln geben.
 Die Jackery Explorer 2000 v2 ist eine besonders kompakte und leichte Powerstation mit hoher Kapazität und Leistung. Das macht sie zu einem idealen Camping-Begleiter, aber sie steht auch zu Hause nicht nur nutzlos im Keller.
Die Jackery Explorer 2000 v2 ist eine besonders kompakte und leichte Powerstation mit hoher Kapazität und Leistung. Das macht sie zu einem idealen Camping-Begleiter, aber sie steht auch zu Hause nicht nur nutzlos im Keller.
 Krähen zeigen erstaunliche Fähigkeiten in der Erkennung geometrischer Formen. Forscher der Universität Tübingen berichten, dass die Vögel abweichende geometrische Formen spontan erkennen. Diese Fähigkeit könnte in der biologischen Evolution verwurzelt sein.
Krähen zeigen erstaunliche Fähigkeiten in der Erkennung geometrischer Formen. Forscher der Universität Tübingen berichten, dass die Vögel abweichende geometrische Formen spontan erkennen. Diese Fähigkeit könnte in der biologischen Evolution verwurzelt sein.
 Die Herausforderungen beim Klimaschutz sind gewaltig. Dem Koalitionsvertrag merkt man an: Weder bei Union noch SPD hat das Thema Priorität. Was Hoffnung macht, was nicht.
Die Herausforderungen beim Klimaschutz sind gewaltig. Dem Koalitionsvertrag merkt man an: Weder bei Union noch SPD hat das Thema Priorität. Was Hoffnung macht, was nicht.
 Nachnamen sind mehr als nur Zuordnungen: Sie sind Zeitzeugen der deutschen Geschichte. ntv.de hat mit einem Experten für Namenforschung gesprochen, der erklärt, wie unsere Nachnamen vor über 1000 Jahren entstanden sind und was sie bedeuten.
Nachnamen sind mehr als nur Zuordnungen: Sie sind Zeitzeugen der deutschen Geschichte. ntv.de hat mit einem Experten für Namenforschung gesprochen, der erklärt, wie unsere Nachnamen vor über 1000 Jahren entstanden sind und was sie bedeuten.
 Obwohl sie nur einen geringen Teil der Bevölkerung ausmachen, merken sie am deutlichsten die Folgen der Erderwärmung: die indigenen Völker der Welt. Einige müssen ihre Heimat bereits verlassen, vielen steht dies noch bevor.
Obwohl sie nur einen geringen Teil der Bevölkerung ausmachen, merken sie am deutlichsten die Folgen der Erderwärmung: die indigenen Völker der Welt. Einige müssen ihre Heimat bereits verlassen, vielen steht dies noch bevor.
 Hat man einmal schlechten Fisch oder Fleischsalat gegessen, verdirbt einem das den Appetit auf diese Speisen für sehr lange Zeit - der Körper wehrt sich dann dagegen. Auch wenn das Essen das nächste Mal vollkommen in Ordnung ist. Warum das so ist, hat ein Forschungsteam herausgefunden.
Hat man einmal schlechten Fisch oder Fleischsalat gegessen, verdirbt einem das den Appetit auf diese Speisen für sehr lange Zeit - der Körper wehrt sich dann dagegen. Auch wenn das Essen das nächste Mal vollkommen in Ordnung ist. Warum das so ist, hat ein Forschungsteam herausgefunden.
 Viele Obst- und Gemüsesorten bekommt man mittlerweile das ganze Jahr über, aber Spargel nicht. Wer ihn mag, freut sich, dass die Erntezeit begonnen hat. Aber warum endet die Saison immer genau am 24. Juni? Und warum stinkt Urin nach dem Spargelessen?
Viele Obst- und Gemüsesorten bekommt man mittlerweile das ganze Jahr über, aber Spargel nicht. Wer ihn mag, freut sich, dass die Erntezeit begonnen hat. Aber warum endet die Saison immer genau am 24. Juni? Und warum stinkt Urin nach dem Spargelessen?
 Die Menge der Plastikabfälle wächst jedes Jahr. Viele davon werden gesammelt und sortiert. Dennoch findet man mittlerweile überall Mikroplastikreste. Erklärungen dafür liefert eine Studie. Denn die Unterschiede in der Verwertung zwischen den Ländern sind enorm.
Die Menge der Plastikabfälle wächst jedes Jahr. Viele davon werden gesammelt und sortiert. Dennoch findet man mittlerweile überall Mikroplastikreste. Erklärungen dafür liefert eine Studie. Denn die Unterschiede in der Verwertung zwischen den Ländern sind enorm.
 Viele Obst- und Gemüsesorten bekommt man mittlerweile das ganze Jahr über, aber Spargel nicht. Wer ihn mag, freut sich, dass die Erntezeit begonnen hat. Aber warum endet die Saison immer genau am 24. Juni? Warum ist Spargel so teuer? Und warum stinkt Urin nach dem Spargelessen?
Viele Obst- und Gemüsesorten bekommt man mittlerweile das ganze Jahr über, aber Spargel nicht. Wer ihn mag, freut sich, dass die Erntezeit begonnen hat. Aber warum endet die Saison immer genau am 24. Juni? Warum ist Spargel so teuer? Und warum stinkt Urin nach dem Spargelessen?
 Ein amerikanisches Start-up will den aus »Game of Thrones« bekannten und vor etwa 13.000 Jahren ausgestorbenen Schattenwolf neu erschaffen haben. Was uns daran fasziniert und welche Gefahr der Wirbel um die Tiere birgt.
Ein amerikanisches Start-up will den aus »Game of Thrones« bekannten und vor etwa 13.000 Jahren ausgestorbenen Schattenwolf neu erschaffen haben. Was uns daran fasziniert und welche Gefahr der Wirbel um die Tiere birgt.
 Es ist ihre Jahreszeit: Zu Ostern werden wieder zahlreiche junge Feldhasen geboren. Auch wenn ihr Bestand zuletzt konstant blieb: Die Tiere sind gefährdet. Das hat die verschiedensten Gründe.
Es ist ihre Jahreszeit: Zu Ostern werden wieder zahlreiche junge Feldhasen geboren. Auch wenn ihr Bestand zuletzt konstant blieb: Die Tiere sind gefährdet. Das hat die verschiedensten Gründe.
 Mark Zuckerberg steht unter Druck. Am Montag beginnt der Prozess der US-Regierung gegen seinen Social-Media-Konzern. Der Vorwurf: Milliardenschwere Übernahmen von Konkurrenten seien illegal gewesen.
Mark Zuckerberg steht unter Druck. Am Montag beginnt der Prozess der US-Regierung gegen seinen Social-Media-Konzern. Der Vorwurf: Milliardenschwere Übernahmen von Konkurrenten seien illegal gewesen.
 Ein deutsches Forschungsteam entdeckt im Bitteren Saftporling den wohl bittersten Geschmack, der der Menschheit bekannt ist. Ein besonderer Bitterstoff aktiviert die Geschmacksrezeptoren selbst in geringsten Konzentrationen. Gleichzeitig ist der Pilz vollkommen ungiftig, wenn auch ungenießbar.
Ein deutsches Forschungsteam entdeckt im Bitteren Saftporling den wohl bittersten Geschmack, der der Menschheit bekannt ist. Ein besonderer Bitterstoff aktiviert die Geschmacksrezeptoren selbst in geringsten Konzentrationen. Gleichzeitig ist der Pilz vollkommen ungiftig, wenn auch ungenießbar.
 Popstar Katy Perry und andere prominente Frauen fliegen mit Blue Origin ins All. Doch die Art des Weltraumflugs unterscheidet sich deutlich von Missionen wie der ersten Deutschen im All, Rabea Rogge. Kann man überhaupt von einem Flug ins All sprechen?
Popstar Katy Perry und andere prominente Frauen fliegen mit Blue Origin ins All. Doch die Art des Weltraumflugs unterscheidet sich deutlich von Missionen wie der ersten Deutschen im All, Rabea Rogge. Kann man überhaupt von einem Flug ins All sprechen?
 Wie Nebelschwaden ziehen sich leuchtend grüne Gebilde durch das Wasser: Dieses als Milky Seas bekannte Phänomen ist spektakulär - aber bis heute kaum erforscht. Nun soll eine Datenbank klären helfen, was riesige Meeresareale wochenlang leuchten lässt.
Wie Nebelschwaden ziehen sich leuchtend grüne Gebilde durch das Wasser: Dieses als Milky Seas bekannte Phänomen ist spektakulär - aber bis heute kaum erforscht. Nun soll eine Datenbank klären helfen, was riesige Meeresareale wochenlang leuchten lässt.
 Wie schafft man es, jeden Tag etliche Tiere zu töten? Der Soziologe Marcel Sebastian ist der Frage nachgegangen und erklärt, was Schlachter und Menschen, die Fleisch essen, verbindet.
Wie schafft man es, jeden Tag etliche Tiere zu töten? Der Soziologe Marcel Sebastian ist der Frage nachgegangen und erklärt, was Schlachter und Menschen, die Fleisch essen, verbindet.
 Der Chipolo Pop ist ein ganz besonderer Bluetooth-Tracker, Made in EU. Denn er kann sowohl mit Apples "Wo ist?" als auch Googles "Mein Gerät finden" aufgespürt werden. Außerdem hat der poppige Tracker spezielle Talente und ist robuster und weitreichender als seine Vorgänger.
Der Chipolo Pop ist ein ganz besonderer Bluetooth-Tracker, Made in EU. Denn er kann sowohl mit Apples "Wo ist?" als auch Googles "Mein Gerät finden" aufgespürt werden. Außerdem hat der poppige Tracker spezielle Talente und ist robuster und weitreichender als seine Vorgänger.
 Europa ist der Kontinent, der sich am schnellsten erwärmt. Jetzt hat der Klimawandeldienst Copernicus neue Daten vorgelegt.
Europa ist der Kontinent, der sich am schnellsten erwärmt. Jetzt hat der Klimawandeldienst Copernicus neue Daten vorgelegt.
 Seit einigen Wochen ist die KI der Facebook-Mutter Meta auch in der EU verfügbar. Wer jetzt Beiträge bei Facebook und Co veröffentlicht, muss damit rechnen, dass sie zum Software-Training genutzt werden.
Seit einigen Wochen ist die KI der Facebook-Mutter Meta auch in der EU verfügbar. Wer jetzt Beiträge bei Facebook und Co veröffentlicht, muss damit rechnen, dass sie zum Software-Training genutzt werden.
 Kopf-, Muskel- und Gelenkschmerzen, Übelkeit und Durchfall – das Oropouche-Virus hat Symptome wie das Denguefieber. In Lateinamerika ist die Zahl der Erkrankungen sprunghaft angestiegen. Forschende raten Reisenden zur Vorsicht.
Kopf-, Muskel- und Gelenkschmerzen, Übelkeit und Durchfall – das Oropouche-Virus hat Symptome wie das Denguefieber. In Lateinamerika ist die Zahl der Erkrankungen sprunghaft angestiegen. Forschende raten Reisenden zur Vorsicht.
 Ein Virus ist in Südamerika viel weiter verbreitet als vorher bekannt. Ein Forscherteam entdeckt die Antikörper gegen das Oropouche- Fieber in jeder 16. Blutprobe. Die Symptome reichen von Gliederschmerzen bis Hautausschlägen. Rückkehrer aus den Gebieten bringen die Krankheit auch nach Deutschland.
Ein Virus ist in Südamerika viel weiter verbreitet als vorher bekannt. Ein Forscherteam entdeckt die Antikörper gegen das Oropouche- Fieber in jeder 16. Blutprobe. Die Symptome reichen von Gliederschmerzen bis Hautausschlägen. Rückkehrer aus den Gebieten bringen die Krankheit auch nach Deutschland.
 Es wird immer wärmer in Europa. Das bringt viele Auswirkungen - Hitzestress für Mensch, Tier und Umwelt, aber auch mehr Regen. Der fällt so zahlreich, dass knapp ein Drittel der Flüsse Hochwasser führen. Extreme Wetterereignisse bringen Zerstörung und kosten 335 Menschen das Leben.
Es wird immer wärmer in Europa. Das bringt viele Auswirkungen - Hitzestress für Mensch, Tier und Umwelt, aber auch mehr Regen. Der fällt so zahlreich, dass knapp ein Drittel der Flüsse Hochwasser führen. Extreme Wetterereignisse bringen Zerstörung und kosten 335 Menschen das Leben.
 Klimaschutz? Ein zu vermeidendes Wort! Genderforschung? Unerwünscht! Trumps Regierung betreibt Forschungszensur - mit weitreichenden Folgen. Nicht nur in den USA werden die Menschen die Konsequenzen zu spüren bekommen, sondern auf der ganzen Welt, warnen Fachleute.
Klimaschutz? Ein zu vermeidendes Wort! Genderforschung? Unerwünscht! Trumps Regierung betreibt Forschungszensur - mit weitreichenden Folgen. Nicht nur in den USA werden die Menschen die Konsequenzen zu spüren bekommen, sondern auf der ganzen Welt, warnen Fachleute.
 Allein in Deutschland hat YouTube rund 56 Millionen User. Andreas Briese hat diesen Aufstieg früh mitgeprägt. Hier spricht der Deutschland-Chef der Plattform über Videotrends, Hunde auf Skateboards und ausgebrannte Creator.
Allein in Deutschland hat YouTube rund 56 Millionen User. Andreas Briese hat diesen Aufstieg früh mitgeprägt. Hier spricht der Deutschland-Chef der Plattform über Videotrends, Hunde auf Skateboards und ausgebrannte Creator.
 In Deutschland ist die Benutzung von Toilettenpapier nach dem Toilettengang Standard, doch die Anwendung ist nicht optimal. Dermatologen empfehlen aus zwei bestimmten Gründen die Reinigung mit Wasser, die in anderen Ländern verbreitet ist.
In Deutschland ist die Benutzung von Toilettenpapier nach dem Toilettengang Standard, doch die Anwendung ist nicht optimal. Dermatologen empfehlen aus zwei bestimmten Gründen die Reinigung mit Wasser, die in anderen Ländern verbreitet ist.
 Tripper ist in Europa auf dem Vormarsch, zugleich wird die Behandlung immer schwieriger, Resistenzen nehmen zu. Ein neuer antibiotischer Wirkstoff macht Medizinern nun Hoffnung.
Tripper ist in Europa auf dem Vormarsch, zugleich wird die Behandlung immer schwieriger, Resistenzen nehmen zu. Ein neuer antibiotischer Wirkstoff macht Medizinern nun Hoffnung.
 Sie reduzieren den Appetit und verlangsamen die Verdauung. Mit Abnehmspritzen nehmen Anwender und Anwenderinnen ab. Doch der Wirkstoff lässt Menschen vermehrt auch zu anderen Lebensmitteln greifen. Der Effekt könnte Einfluss auf Lebensmittelhersteller haben.
Sie reduzieren den Appetit und verlangsamen die Verdauung. Mit Abnehmspritzen nehmen Anwender und Anwenderinnen ab. Doch der Wirkstoff lässt Menschen vermehrt auch zu anderen Lebensmitteln greifen. Der Effekt könnte Einfluss auf Lebensmittelhersteller haben.
 Eine Heilung gibt es auch mit diesem Medikament nicht. Doch der Antikörper Lecanemab kann das Fortschreiten von Alzheimer verlangsamen. Erstmals wird eine solche Therapie nun in der EU zugelassen. Aber nicht alle Patienten können davon profitieren.
Eine Heilung gibt es auch mit diesem Medikament nicht. Doch der Antikörper Lecanemab kann das Fortschreiten von Alzheimer verlangsamen. Erstmals wird eine solche Therapie nun in der EU zugelassen. Aber nicht alle Patienten können davon profitieren.
 Markus Söder muss seine Indien-Reise wegen eines akuten Magen-Darm-Infekts abbrechen. Er ist nicht der erste Europäer, den das Essen in dem südasiatischen Land in die Knie zwingt. Doch woran liegt das?
Markus Söder muss seine Indien-Reise wegen eines akuten Magen-Darm-Infekts abbrechen. Er ist nicht der erste Europäer, den das Essen in dem südasiatischen Land in die Knie zwingt. Doch woran liegt das?
 US-Präsident Trump drangsaliert Spitzenunis, aus Harvard und Princeton gibt es Widerstand. Was hinter dem Streit steckt, wo die Einschüchterung wirkt und wohin Wissenschaftler fliehen könnten. Die wichtigsten Antworten.
US-Präsident Trump drangsaliert Spitzenunis, aus Harvard und Princeton gibt es Widerstand. Was hinter dem Streit steckt, wo die Einschüchterung wirkt und wohin Wissenschaftler fliehen könnten. Die wichtigsten Antworten.
 In sozialen Medien macht ein Video die Runde, demzufolge eine Frau in Köln einen Syrer erstochen haben soll. Es handelt sich um eine Falschmeldung. Der Polizei ist kein solcher Fall bekannt.
In sozialen Medien macht ein Video die Runde, demzufolge eine Frau in Köln einen Syrer erstochen haben soll. Es handelt sich um eine Falschmeldung. Der Polizei ist kein solcher Fall bekannt.
 Es ist eine bislang ungeklärte Frage: Woher kommt das Wasser auf unserem Planeten? Manche glauben, es stammt von Asteroiden und Kometen aus dem äußeren Sonnensystem. Andere, dass die junge Erde bereits ausreichend Wasser im Gestein gespeichert hat. Eine neue Studie legt nun neue Belege vor.
Es ist eine bislang ungeklärte Frage: Woher kommt das Wasser auf unserem Planeten? Manche glauben, es stammt von Asteroiden und Kometen aus dem äußeren Sonnensystem. Andere, dass die junge Erde bereits ausreichend Wasser im Gestein gespeichert hat. Eine neue Studie legt nun neue Belege vor.
 Lange haben die Behörden gezögert, doch jetzt ist es so weit: In der EU wird erstmals eine Alzheimer-Therapie zugelassen. Helfen kann Lecanemab allerdings nur einem kleinen Teil der Patienten. Außerdem ist die Behandlung aufwendig und riskant.
Lange haben die Behörden gezögert, doch jetzt ist es so weit: In der EU wird erstmals eine Alzheimer-Therapie zugelassen. Helfen kann Lecanemab allerdings nur einem kleinen Teil der Patienten. Außerdem ist die Behandlung aufwendig und riskant.
 Schwere Regenfälle ließen einen Fluss über die Ufer treten. Die Gemeinde Bogota im US-Bundesstaat Tennessee versank im Wasser. Zahlreiche Menschen wurden gerettet. Doch eine Farm trotzte den Fluten – dank Papas Ratschlag.
Schwere Regenfälle ließen einen Fluss über die Ufer treten. Die Gemeinde Bogota im US-Bundesstaat Tennessee versank im Wasser. Zahlreiche Menschen wurden gerettet. Doch eine Farm trotzte den Fluten – dank Papas Ratschlag.
 Vor hundert Jahren entdeckten Menschen erstmals tote Koloss-Kalmare. Nun ist Forschern ein lebendes Exemplar der rätselhaften Wesen vor die Linse geschwommen.
Vor hundert Jahren entdeckten Menschen erstmals tote Koloss-Kalmare. Nun ist Forschern ein lebendes Exemplar der rätselhaften Wesen vor die Linse geschwommen.
 Wenn ein Balkonkraftwerk installiert werden soll, stellt sich die Frage, ob es mit einem Batteriespeicher kombiniert werden soll. Die Rechnung geht durch verbesserte und intelligentere Technik, sinkende Preise und dynamische Stromtarife immer häufiger auf, solange man nicht übers Ziel hinausschießt.
Wenn ein Balkonkraftwerk installiert werden soll, stellt sich die Frage, ob es mit einem Batteriespeicher kombiniert werden soll. Die Rechnung geht durch verbesserte und intelligentere Technik, sinkende Preise und dynamische Stromtarife immer häufiger auf, solange man nicht übers Ziel hinausschießt.
 Forscher suchen im Weltall vor allem nach "Biosignaturen", wenn es um die Frage geht, ob wir nicht allein sind. Der Blick richtet sich nun auf K2-18b - ein Exoplanet, der in der sogenannten bewohnbaren Zone liegt.
Forscher suchen im Weltall vor allem nach "Biosignaturen", wenn es um die Frage geht, ob wir nicht allein sind. Der Blick richtet sich nun auf K2-18b - ein Exoplanet, der in der sogenannten bewohnbaren Zone liegt.
 Vegane Ernährung besteht ausschließlich aus Pflanzen. Doch bekommt man so auch alle Stoffe, die der Körper braucht? Ein Forschungsteam muss feststellen, dass fast die Hälfte der vegan Lebenden zu wenig Lysin und Leucin aufnimmt. Ein Mangel kann zu Muskelabbau und Schwäche führen.
Vegane Ernährung besteht ausschließlich aus Pflanzen. Doch bekommt man so auch alle Stoffe, die der Körper braucht? Ein Forschungsteam muss feststellen, dass fast die Hälfte der vegan Lebenden zu wenig Lysin und Leucin aufnimmt. Ein Mangel kann zu Muskelabbau und Schwäche führen.
 Planetenforscher jubeln: Auf dem 124 Lichtjahre entfernten Exoplaneten K2-18b haben sie Gase gefunden, die eigentlich nur von Lebewesen produziert werden. Die Wissenschaftler sprechen von einem Wendepunkt.
Planetenforscher jubeln: Auf dem 124 Lichtjahre entfernten Exoplaneten K2-18b haben sie Gase gefunden, die eigentlich nur von Lebewesen produziert werden. Die Wissenschaftler sprechen von einem Wendepunkt.
 Harvard wehrt sich gegen die US-Regierung, die streicht Milliarden Fördermittel. Der Konflikt zeigt, wie abhängig selbst die reichste US-Uni von öffentlichen Geldern ist. Und wie sehr Trump die Forschung in den USA bedroht.
Harvard wehrt sich gegen die US-Regierung, die streicht Milliarden Fördermittel. Der Konflikt zeigt, wie abhängig selbst die reichste US-Uni von öffentlichen Geldern ist. Und wie sehr Trump die Forschung in den USA bedroht.
 Rund 1000 Dollar haben Fans des YouTubers MrBeast für eine »MrBeast Experience« in Las Vegas ausgegeben. Deren Inhalt hat er, gelinde gesagt, offenbar etwas überverkauft. Das legen Kommentare in den sozialen Medien nahe.
Rund 1000 Dollar haben Fans des YouTubers MrBeast für eine »MrBeast Experience« in Las Vegas ausgegeben. Deren Inhalt hat er, gelinde gesagt, offenbar etwas überverkauft. Das legen Kommentare in den sozialen Medien nahe.
 Angelehnt an die Community Notes auf X will TikTok testweise bestimmte Nutzerinnen und Nutzer Anmerkungen unter den Clips posten lassen. Anders als bei Meta sollen die »Footnotes« keine Faktenchecks ersetzen.
Angelehnt an die Community Notes auf X will TikTok testweise bestimmte Nutzerinnen und Nutzer Anmerkungen unter den Clips posten lassen. Anders als bei Meta sollen die »Footnotes« keine Faktenchecks ersetzen.
 Wer ein iPhone nutzt, sollte nicht zögern, das zur Verfügung stehende Update auf iOS 18.4.1 zu installieren. Die Aktualisierung schließt unter anderem zwei kritische Sicherheitslücken, die offenbar bereits für Angriffe ausgenutzt wurden. Auch iPads sind betroffen.
Wer ein iPhone nutzt, sollte nicht zögern, das zur Verfügung stehende Update auf iOS 18.4.1 zu installieren. Die Aktualisierung schließt unter anderem zwei kritische Sicherheitslücken, die offenbar bereits für Angriffe ausgenutzt wurden. Auch iPads sind betroffen.
 Wer mit der offiziellen App der Deutschen Bahn richtig umgeht, kommt vielleicht nicht pünktlich an, kann die Reise aber angenehmer gestalten. Eine Übersicht über nützliche Funktionen.
Wer mit der offiziellen App der Deutschen Bahn richtig umgeht, kommt vielleicht nicht pünktlich an, kann die Reise aber angenehmer gestalten. Eine Übersicht über nützliche Funktionen.
 In Bayern steigt die Zahl der Infektionen mit dem Hantavirus im Vergleich zu den Vorjahren deutlich. Die Meldungen kommen vor allem aus dem Bayerischen Wald. Aber auch andere Regionen sind betroffen.
In Bayern steigt die Zahl der Infektionen mit dem Hantavirus im Vergleich zu den Vorjahren deutlich. Die Meldungen kommen vor allem aus dem Bayerischen Wald. Aber auch andere Regionen sind betroffen.
 Forschende entwickeln ein Minikraftwerk, das Regen zu Strom macht. Mit der neuen Methode erreichen sie einen höheren Wirkungsgrad als mit bekannten Verfahren. Die Technik könnte schon bald auf Hausdächern zum Einsatz kommen.
Forschende entwickeln ein Minikraftwerk, das Regen zu Strom macht. Mit der neuen Methode erreichen sie einen höheren Wirkungsgrad als mit bekannten Verfahren. Die Technik könnte schon bald auf Hausdächern zum Einsatz kommen.
 Harvard wehrt sich gegen die US-Regierung, die streicht Milliarden an Fördermitteln. Der Konflikt zeigt, wie abhängig selbst die reichste US-Uni von öffentlichen Geldern ist. Und wie sehr Trump die Forschung in den USA bedroht.
Harvard wehrt sich gegen die US-Regierung, die streicht Milliarden an Fördermitteln. Der Konflikt zeigt, wie abhängig selbst die reichste US-Uni von öffentlichen Geldern ist. Und wie sehr Trump die Forschung in den USA bedroht.
 Auch wenn der Erfolg der Vision Pro nicht allzu groß ist, soll Apple an dem Konzept festhalten und weitere Mixed-Reality-Headsets planen. Eines davon könnte die breite Masse begeistern, denn es soll deutlich leichter, dünner und auch günstiger als das aktuelle Gerät sein.
Auch wenn der Erfolg der Vision Pro nicht allzu groß ist, soll Apple an dem Konzept festhalten und weitere Mixed-Reality-Headsets planen. Eines davon könnte die breite Masse begeistern, denn es soll deutlich leichter, dünner und auch günstiger als das aktuelle Gerät sein.
 Rückschlag für Google im US-Kartellverfahren: Der Alphabet-Konzern soll zwei Märkte für Onlinewerbung illegal beherrscht haben, entschied eine Richterin. Es ist nicht das erste negative Urteil für den Tech-Giganten.
Rückschlag für Google im US-Kartellverfahren: Der Alphabet-Konzern soll zwei Märkte für Onlinewerbung illegal beherrscht haben, entschied eine Richterin. Es ist nicht das erste negative Urteil für den Tech-Giganten.
 Die neue Regierung will Datennutzung vor den Datenschutz stellen. Hier erklärt Deutschlands oberste Datenschützerin Louisa Specht-Riemenschneider, was sie davon hält.
Die neue Regierung will Datennutzung vor den Datenschutz stellen. Hier erklärt Deutschlands oberste Datenschützerin Louisa Specht-Riemenschneider, was sie davon hält.
 Aufgrund einer Genmutation liegt Sarah Kobs Brustkrebsrisiko bei 90 Prozent, ihre Großmutter starb an der Krankheit. Deshalb entschied sie sich für eine OP. Wie blickt sie heute auf die Entscheidung?
Aufgrund einer Genmutation liegt Sarah Kobs Brustkrebsrisiko bei 90 Prozent, ihre Großmutter starb an der Krankheit. Deshalb entschied sie sich für eine OP. Wie blickt sie heute auf die Entscheidung?
 Über den Einsatz von künstlicher Intelligenz wird in der Filmbranche heftig gestritten. Der Co-Chef von Netflix, Ted Sarandos, schlägt sich dabei im Gespräch mit Analysten auf die Seite der KI-Fans.
Über den Einsatz von künstlicher Intelligenz wird in der Filmbranche heftig gestritten. Der Co-Chef von Netflix, Ted Sarandos, schlägt sich dabei im Gespräch mit Analysten auf die Seite der KI-Fans.
 Die allmorgendliche und allabendliche Routine im Bad sieht bei den meisten Menschen so aus: Zahncreme auf die Bürste, putzen, Schaum ausspucken - und dann gründlich mit Wasser ausspülen. Doch Letzteres sollte man besser nicht tun, raten Zahnärzte - warum nicht?
Die allmorgendliche und allabendliche Routine im Bad sieht bei den meisten Menschen so aus: Zahncreme auf die Bürste, putzen, Schaum ausspucken - und dann gründlich mit Wasser ausspülen. Doch Letzteres sollte man besser nicht tun, raten Zahnärzte - warum nicht?
 Die Muskeln brennen, man schwitzt und keucht: So ein Halbmarathon ist anstrengend. Und dann läuft neben einem plötzlich auch noch ein Roboter. So geschehen in Peking. Eine Chance auf den Sieg haben die Humanoiden jedoch nicht.
Die Muskeln brennen, man schwitzt und keucht: So ein Halbmarathon ist anstrengend. Und dann läuft neben einem plötzlich auch noch ein Roboter. So geschehen in Peking. Eine Chance auf den Sieg haben die Humanoiden jedoch nicht.
 Wie viele Tiere können Sie in 90 Sekunden aufzählen? Zwischen der Anzahl der verschiedenen Arten und der restlichen Lebenszeit gibt es offenbar einen Zusammenhang, finden Forschende heraus. Sie schauten sich Daten von Senioren und Seniorinnen aus drei Jahrzehnten an.
Wie viele Tiere können Sie in 90 Sekunden aufzählen? Zwischen der Anzahl der verschiedenen Arten und der restlichen Lebenszeit gibt es offenbar einen Zusammenhang, finden Forschende heraus. Sie schauten sich Daten von Senioren und Seniorinnen aus drei Jahrzehnten an.
 Norwegisches Erdgas rettete Deutschland in der Energiekrise, als russische Lieferungen wegfielen. Nun hängt die deutsche Wirtschaft an drei Pipelines, die auf dem Boden der Nordsee liegen. Wie können sie geschützt werden?
Norwegisches Erdgas rettete Deutschland in der Energiekrise, als russische Lieferungen wegfielen. Nun hängt die deutsche Wirtschaft an drei Pipelines, die auf dem Boden der Nordsee liegen. Wie können sie geschützt werden?
 Mark Zuckerberg steht unter Druck. Am Montag beginnt der Prozess der US-Regierung gegen seinen Social-Media-Konzern. Der Vorwurf: Milliardenschwere Übernahmen von Konkurrenten seien illegal gewesen.
Mark Zuckerberg steht unter Druck. Am Montag beginnt der Prozess der US-Regierung gegen seinen Social-Media-Konzern. Der Vorwurf: Milliardenschwere Übernahmen von Konkurrenten seien illegal gewesen.
 Kiloweise frittiertes Essen, übergroße Portionen: TikTok-Videos von extremen Völlereien ziehen Millionen an. Ein gefährlicher Trend, der tausendfach nachgeahmt wird. Ein 24-jähriger Streamer starb sogar.
Kiloweise frittiertes Essen, übergroße Portionen: TikTok-Videos von extremen Völlereien ziehen Millionen an. Ein gefährlicher Trend, der tausendfach nachgeahmt wird. Ein 24-jähriger Streamer starb sogar.
 Es ist ihre Jahreszeit: Zu Ostern werden wieder zahlreiche junge Feldhasen geboren. Auch wenn ihr Bestand zuletzt konstant blieb: Die Tiere sind gefährdet. Das hat die verschiedensten Gründe.
Es ist ihre Jahreszeit: Zu Ostern werden wieder zahlreiche junge Feldhasen geboren. Auch wenn ihr Bestand zuletzt konstant blieb: Die Tiere sind gefährdet. Das hat die verschiedensten Gründe.
 Drei Astronauten sind in den frühen Morgenstunden sicher in Kasachstan gelandet. Die beiden Russen und ein US-Amerikaner haben sieben Monate im All verbracht. Der Amerikaner Don Pettit hat noch einen Grund zu feiern.
Drei Astronauten sind in den frühen Morgenstunden sicher in Kasachstan gelandet. Die beiden Russen und ein US-Amerikaner haben sieben Monate im All verbracht. Der Amerikaner Don Pettit hat noch einen Grund zu feiern.
 Eine neue Entdeckung lässt bisherige Theorien zur Entstehung von Galaxien wackeln. Das James-Webb-Weltraumteleskop liefert Hinweise darauf, dass nach dem Urknall eine Spiralgalaxie existierte, die der Milchstraße sehr ähnelte. Vor allem der Zeitraum, in der diese entstand, ist für Fachleute eine Überraschung.
Eine neue Entdeckung lässt bisherige Theorien zur Entstehung von Galaxien wackeln. Das James-Webb-Weltraumteleskop liefert Hinweise darauf, dass nach dem Urknall eine Spiralgalaxie existierte, die der Milchstraße sehr ähnelte. Vor allem der Zeitraum, in der diese entstand, ist für Fachleute eine Überraschung.
 Zu Ostern werden traditionell Eier gefärbt, versteckt und verschenkt. Doch woher kommen diese und wie viele Hühner gibt es eigentlich auf der Welt? Hier kommen die wichtigsten Antworten zum Osterfest.
Zu Ostern werden traditionell Eier gefärbt, versteckt und verschenkt. Doch woher kommen diese und wie viele Hühner gibt es eigentlich auf der Welt? Hier kommen die wichtigsten Antworten zum Osterfest.
 Mit dem »James Webb«-Weltraumteleskop sind Wissenschaftler durch Zufall auf eine Galaxie gestoßen, die bereits eine Milliarde Jahre nach dem Urknall entstand.
Mit dem »James Webb«-Weltraumteleskop sind Wissenschaftler durch Zufall auf eine Galaxie gestoßen, die bereits eine Milliarde Jahre nach dem Urknall entstand.
 China will zur Wissenschaftsnation Nummer eins werden. Das Land investiert massiv in Grundlagenforschung, zieht Großexperimente in Rekordzeit hoch. Geht die Strategie auf?
China will zur Wissenschaftsnation Nummer eins werden. Das Land investiert massiv in Grundlagenforschung, zieht Großexperimente in Rekordzeit hoch. Geht die Strategie auf?
 Sex-Inhalte haben OnlyFans berühmt-berüchtigt gemacht und extrem profitabel. Doch wer auf der Plattform Erfolg haben will, muss ständig präsent sein. Über das Geschäft mit der Einsamkeit und seine Abgründe.
Sex-Inhalte haben OnlyFans berühmt-berüchtigt gemacht und extrem profitabel. Doch wer auf der Plattform Erfolg haben will, muss ständig präsent sein. Über das Geschäft mit der Einsamkeit und seine Abgründe.
 Anthropologen wollen herausfinden, warum Neandertaler ausstarben und Homo sapiens überlebten. Einer aktuellen Studie zufolge, gibt es eine neue Theorie dazu, die sich mit den schädlichen Auswirkungen der Sonne vor 41.000 Jahren und dem Schutz davor auseinandersetzt.
Anthropologen wollen herausfinden, warum Neandertaler ausstarben und Homo sapiens überlebten. Einer aktuellen Studie zufolge, gibt es eine neue Theorie dazu, die sich mit den schädlichen Auswirkungen der Sonne vor 41.000 Jahren und dem Schutz davor auseinandersetzt.
 KI-Chatbots versprechen Hilfe bei psychischen Problemen - doch kann eine Maschine zuhören, trösten und vor allem: heilen? Experten warnen vor Risiken und bemängeln, dass der KI eine entscheidende Eigenschaft fehlt.
KI-Chatbots versprechen Hilfe bei psychischen Problemen - doch kann eine Maschine zuhören, trösten und vor allem: heilen? Experten warnen vor Risiken und bemängeln, dass der KI eine entscheidende Eigenschaft fehlt.
 Meist wird die Abhängigkeit von Arzneimitteln erst spät erkannt. Schnell steigen Suchtdruck und Dosis. Wie ergeht es Betroffenen, und welche Wege gibt es, aus dem Teufelskreis auszusteigen? Eine »Arte Re:«-Reportage von SPIEGEL TV.
Meist wird die Abhängigkeit von Arzneimitteln erst spät erkannt. Schnell steigen Suchtdruck und Dosis. Wie ergeht es Betroffenen, und welche Wege gibt es, aus dem Teufelskreis auszusteigen? Eine »Arte Re:«-Reportage von SPIEGEL TV.
 Ein bizarrer Test, eine politische Abrechnung, ein »Bomben-Prank« und sehr viele Einbauschränke: Seit dem Start von YouTube im April 2005 ist in der deutschen Videowelt viel passiert. Hier sind 20 Meilensteine.
Ein bizarrer Test, eine politische Abrechnung, ein »Bomben-Prank« und sehr viele Einbauschränke: Seit dem Start von YouTube im April 2005 ist in der deutschen Videowelt viel passiert. Hier sind 20 Meilensteine.
 Eine Heilung gibt es auch mit diesem Medikament nicht. Doch der Antikörper Lecanemab kann das Fortschreiten von Alzheimer verlangsamen. Erstmals wird eine solche Therapie nun in der EU zugelassen. Aber nicht alle Patienten können davon profitieren.
Eine Heilung gibt es auch mit diesem Medikament nicht. Doch der Antikörper Lecanemab kann das Fortschreiten von Alzheimer verlangsamen. Erstmals wird eine solche Therapie nun in der EU zugelassen. Aber nicht alle Patienten können davon profitieren.
 In Washington geht es ab Montag um die Zukunft der Internetsuche: Google soll für illegale Monopolpraktiken abgestraft werden. Muss sich der Konzern von Chrome und Android trennen?
In Washington geht es ab Montag um die Zukunft der Internetsuche: Google soll für illegale Monopolpraktiken abgestraft werden. Muss sich der Konzern von Chrome und Android trennen?
 Der US-Präsident verspricht ärmeren Menschen mehr Geld, von seiner Politik profitieren aber vor allem Reiche. Forscherin Simone Schnall erklärt, warum seine Fans Donald Trump treu bleiben, auch wenn er ihnen schadet.
Der US-Präsident verspricht ärmeren Menschen mehr Geld, von seiner Politik profitieren aber vor allem Reiche. Forscherin Simone Schnall erklärt, warum seine Fans Donald Trump treu bleiben, auch wenn er ihnen schadet.
 Forscher melden einen starken Rückgang der Niederschläge im Himalaya. Die Schneedecke sinkt auf ein 23-Jahres-Tief. Es ist bereits das dritte Jahr in Folge mit niedrigen Werten. Die Wassersicherheit von fast zwei Milliarden Menschen steht damit auf dem Spiel.
Forscher melden einen starken Rückgang der Niederschläge im Himalaya. Die Schneedecke sinkt auf ein 23-Jahres-Tief. Es ist bereits das dritte Jahr in Folge mit niedrigen Werten. Die Wassersicherheit von fast zwei Milliarden Menschen steht damit auf dem Spiel.
 Vor hundert Jahren entdeckten Menschen erstmals tote Koloss-Kalmare. Nun ist Forschern ein lebendes Exemplar der rätselhaften Wesen vor die Linse geschwommen.
Vor hundert Jahren entdeckten Menschen erstmals tote Koloss-Kalmare. Nun ist Forschern ein lebendes Exemplar der rätselhaften Wesen vor die Linse geschwommen.
 Menschen trinken in Gesellschaft Alkohol. Nun haben Forschende im afrikanischen Guinea-Bissau Menschenaffen beobachtet, die zusammen vergorene Brotbaumfrüchte futtern. Liegt hier die Urform des Feierns?
Menschen trinken in Gesellschaft Alkohol. Nun haben Forschende im afrikanischen Guinea-Bissau Menschenaffen beobachtet, die zusammen vergorene Brotbaumfrüchte futtern. Liegt hier die Urform des Feierns?
 Forschenden ist es erstmals gelungen, wilde Schimpansen beim gemeinsamen Konsum alkoholhaltiger Früchte zu beobachten. Das Teilen dieser könnte auch soziale Bindungen stärken.
Forschenden ist es erstmals gelungen, wilde Schimpansen beim gemeinsamen Konsum alkoholhaltiger Früchte zu beobachten. Das Teilen dieser könnte auch soziale Bindungen stärken.
 An einem britischen College wurde bis vor wenigen Jahren aus einem Kolonialschädel getrunken. Er machte offenbar bei festlichen Abendessen die Runde. Ein Archäologe spricht von einer »schändlichen Geschichte«.
An einem britischen College wurde bis vor wenigen Jahren aus einem Kolonialschädel getrunken. Er machte offenbar bei festlichen Abendessen die Runde. Ein Archäologe spricht von einer »schändlichen Geschichte«.
 Am Himmel über Deutschland werden in der Nacht besonders viele Sternschnuppen erwartet. Grund ist der Meteorstrom der Lyriden. Wolken dürften die Beobachtung jedoch erschweren.
Am Himmel über Deutschland werden in der Nacht besonders viele Sternschnuppen erwartet. Grund ist der Meteorstrom der Lyriden. Wolken dürften die Beobachtung jedoch erschweren.
 Der Bundesnachrichtendienst ist nicht verpflichtet, seine Informationen zum Ursprung der weltweiten Coronapandemie zu veröffentlichen. Das könne die »auswärtigen Interessen der Bundesrepublik« beschädigen.
Der Bundesnachrichtendienst ist nicht verpflichtet, seine Informationen zum Ursprung der weltweiten Coronapandemie zu veröffentlichen. Das könne die »auswärtigen Interessen der Bundesrepublik« beschädigen.
 Musik kann die Laune verbessern und sogar Schmerzen lindern. Forschende haben untersucht, was dabei im Gehirn passiert. Nicht alle Versuchspersonen reagierten jedoch gleich stark auf ihre Lieblingssongs.
Musik kann die Laune verbessern und sogar Schmerzen lindern. Forschende haben untersucht, was dabei im Gehirn passiert. Nicht alle Versuchspersonen reagierten jedoch gleich stark auf ihre Lieblingssongs.
 Astronomen entdecken einen Exoplaneten, der rapide zerfällt. Der Planet BD+05 4868 Ab zieht einen gigantischen Schweif hinter sich her - und verliert bei jeder Umrundung seines Sterns Material in der Menge des Mount Everest. Sein Ende ist damit bereits absehbar.
Astronomen entdecken einen Exoplaneten, der rapide zerfällt. Der Planet BD+05 4868 Ab zieht einen gigantischen Schweif hinter sich her - und verliert bei jeder Umrundung seines Sterns Material in der Menge des Mount Everest. Sein Ende ist damit bereits absehbar.
 Fracht aus dem Weltall eigenständig zurück zur Erde bringen: Bisher ist Europa dabei auf die Firma SpaceX von Elon Musk angewiesen. Doch eine kleine deutsche Firma hat nun eine spektakuläre Technik getestet.
Fracht aus dem Weltall eigenständig zurück zur Erde bringen: Bisher ist Europa dabei auf die Firma SpaceX von Elon Musk angewiesen. Doch eine kleine deutsche Firma hat nun eine spektakuläre Technik getestet.
 Planetenforscher jubeln: Auf dem 124 Lichtjahre entfernten Exoplaneten K2-18b haben sie Gase gefunden, die eigentlich nur von Lebewesen produziert werden. Die Wissenschaftler sprechen von einem Wendepunkt.
Planetenforscher jubeln: Auf dem 124 Lichtjahre entfernten Exoplaneten K2-18b haben sie Gase gefunden, die eigentlich nur von Lebewesen produziert werden. Die Wissenschaftler sprechen von einem Wendepunkt.
 In den USA sterben jährlich 1000 Menschen durch Polizeischüsse. Die meisten Getöteten werden dabei mehrfach von Kugeln getroffen - im Schnitt sogar sechsmal, zeigt eine neue Studie. Damit verringert sich die Chance der Opfer, zu überleben.
In den USA sterben jährlich 1000 Menschen durch Polizeischüsse. Die meisten Getöteten werden dabei mehrfach von Kugeln getroffen - im Schnitt sogar sechsmal, zeigt eine neue Studie. Damit verringert sich die Chance der Opfer, zu überleben.
 Die EU-Kommission hat gegen Apple und Meta Strafen in Höhe von 500 Millionen und 200 Millionen Euro verhängt. Nach Ansicht der Behörde haben die Unternehmen gegen europäisches Digitalrecht verstoßen.
Die EU-Kommission hat gegen Apple und Meta Strafen in Höhe von 500 Millionen und 200 Millionen Euro verhängt. Nach Ansicht der Behörde haben die Unternehmen gegen europäisches Digitalrecht verstoßen.
 Nach seinem Tod wird Papst Franziskus in einem offenen Sarg aufgebahrt. Auffällige Verfärbungen auf der linken Gesichtshälfte und den Fingerkuppen sorgen für Spekulationen. Experten erklären die Ursachen. Sie sehen darin Hinweise auf die Umstände seines Todes.
Nach seinem Tod wird Papst Franziskus in einem offenen Sarg aufgebahrt. Auffällige Verfärbungen auf der linken Gesichtshälfte und den Fingerkuppen sorgen für Spekulationen. Experten erklären die Ursachen. Sie sehen darin Hinweise auf die Umstände seines Todes.
 Eine selbstfahrende Haubitze, 15 Meter lang, die Kanone hat ein Kaliber von 170 Millimetern: Die martialische Koksan aus Nordkorea ist offenbar in der Ukraine im Einsatz. Warum die Waffe für die Kremltruppen wichtig ist.
Eine selbstfahrende Haubitze, 15 Meter lang, die Kanone hat ein Kaliber von 170 Millimetern: Die martialische Koksan aus Nordkorea ist offenbar in der Ukraine im Einsatz. Warum die Waffe für die Kremltruppen wichtig ist.
 Eigentlich gelten die Masern in den USA als ausgerottet, doch bei einem Ausbruch haben sich nun so viele Menschen angesteckt wie seit Jahrzehnten nicht mehr. Die Zahl der registrierten Fälle kletterte landesweit auf 800.
Eigentlich gelten die Masern in den USA als ausgerottet, doch bei einem Ausbruch haben sich nun so viele Menschen angesteckt wie seit Jahrzehnten nicht mehr. Die Zahl der registrierten Fälle kletterte landesweit auf 800.
 Schon kleine Unterschiede bei der Schlafdauer wirken sich bei Heranwachsenden offenbar auf die Leistung des Gehirns aus. Das zeigen Daten einer großen Studie. Das Ergebnis überrascht selbst die Forschenden.
Schon kleine Unterschiede bei der Schlafdauer wirken sich bei Heranwachsenden offenbar auf die Leistung des Gehirns aus. Das zeigen Daten einer großen Studie. Das Ergebnis überrascht selbst die Forschenden.
 Hunde sind treue Begleiter und bieten ihren Haltern besondere emotionale Nähe. Warum die Beziehung zu den Tieren von vielen als erfüllend empfunden wird, möchte ein Forscherteam herausfinden. Es fördert die einzigartige Rolle von Hunden zutage.
Hunde sind treue Begleiter und bieten ihren Haltern besondere emotionale Nähe. Warum die Beziehung zu den Tieren von vielen als erfüllend empfunden wird, möchte ein Forscherteam herausfinden. Es fördert die einzigartige Rolle von Hunden zutage.
 Ein ungewöhnliches Lichtsignal brachte Astronomen auf die Spur: In einem fremden Sternensystem haben sie einen Planeten mit einem kometenartigen Schweif entdeckt. Für den Himmelskörper sehen sie eine düstere Zukunft.
Ein ungewöhnliches Lichtsignal brachte Astronomen auf die Spur: In einem fremden Sternensystem haben sie einen Planeten mit einem kometenartigen Schweif entdeckt. Für den Himmelskörper sehen sie eine düstere Zukunft.
 Google soll den meistgenutzten Browser der Welt abstoßen, fordert das US-Justizministerium. Damit soll die Marktmacht des Konzerns eingehegt werden. Was logisch klingt, ist in Wahrheit zu kurz gedacht.
Google soll den meistgenutzten Browser der Welt abstoßen, fordert das US-Justizministerium. Damit soll die Marktmacht des Konzerns eingehegt werden. Was logisch klingt, ist in Wahrheit zu kurz gedacht.
 Die Trump-Regierung gängelt die Wissenschaft, kürzt Universitäten massiv das Geld und schüchtert Forscherinnen und Studenten mit Ausweisungen ein. Vier Wissenschaftler berichten, warum sie das Land verlassen wollen.
Die Trump-Regierung gängelt die Wissenschaft, kürzt Universitäten massiv das Geld und schüchtert Forscherinnen und Studenten mit Ausweisungen ein. Vier Wissenschaftler berichten, warum sie das Land verlassen wollen.
 Die größte Stadt der Türkei hat einem schweren Erdbeben getrotzt. Doch es ist nur eine Frage der Zeit, bis noch weit schlimmere Erdstöße die Metropole erschüttern. Die Folgen dürften dramatisch sein.
Die größte Stadt der Türkei hat einem schweren Erdbeben getrotzt. Doch es ist nur eine Frage der Zeit, bis noch weit schlimmere Erdstöße die Metropole erschüttern. Die Folgen dürften dramatisch sein.
 Papst Franziskus wird noch bis Freitag in Rom aufgebahrt. Damit seine sterbliche Hülle nicht verwest, wurde sie aufwendig konserviert – eine Kunst, bei der viel schiefgehen kann. Wie aber funktioniert das genau?
Papst Franziskus wird noch bis Freitag in Rom aufgebahrt. Damit seine sterbliche Hülle nicht verwest, wurde sie aufwendig konserviert – eine Kunst, bei der viel schiefgehen kann. Wie aber funktioniert das genau?
 Fortschritte bei Akkus für Elektroautos meldet der chinesische Konzern CATL. Eine Batterie-Variante soll eine Reichweite von 1500 Kilometern bringen. Für besonderes Aufsehen sorgen jedoch die Pläne zu Natrium-Akkus - denn diese haben einige Vorteile gegenüber herkömmlichen Batterien.
Fortschritte bei Akkus für Elektroautos meldet der chinesische Konzern CATL. Eine Batterie-Variante soll eine Reichweite von 1500 Kilometern bringen. Für besonderes Aufsehen sorgen jedoch die Pläne zu Natrium-Akkus - denn diese haben einige Vorteile gegenüber herkömmlichen Batterien.
 Mit der Quantentechnik soll das Internet abhörsicher werden. Für Testanlagen waren bisher spezielle Kabel und eine extreme Kühlung nötig. Ein Versuch in Deutschland zeigt, dass es anders geht.
Mit der Quantentechnik soll das Internet abhörsicher werden. Für Testanlagen waren bisher spezielle Kabel und eine extreme Kühlung nötig. Ein Versuch in Deutschland zeigt, dass es anders geht.
 Mit einer neuen Einstellung kann man erschweren, dass private WhatsApp-Nachrichten nach außen dringen. Auch die hauseigene KI wird ausgesperrt. Man sollte sich aber nicht zu sehr auf die Funktion verlassen.
Mit einer neuen Einstellung kann man erschweren, dass private WhatsApp-Nachrichten nach außen dringen. Auch die hauseigene KI wird ausgesperrt. Man sollte sich aber nicht zu sehr auf die Funktion verlassen.
 Die Nutzung privater Handys ist im Pentagon weitgehend untersagt. US-Verteidigungsminister Pete Hegseth ließ sich daher die Chat-App Signal einem Bericht zufolge in der Desktop-Variante einrichten.
Die Nutzung privater Handys ist im Pentagon weitgehend untersagt. US-Verteidigungsminister Pete Hegseth ließ sich daher die Chat-App Signal einem Bericht zufolge in der Desktop-Variante einrichten.
 Am Skelett eines Mannes in England fanden Forscher verräterische Bissspuren. Sie stammen vermutlich von einer Großkatze. Für einen der beiden endete die Begegnung fatal.
Am Skelett eines Mannes in England fanden Forscher verräterische Bissspuren. Sie stammen vermutlich von einer Großkatze. Für einen der beiden endete die Begegnung fatal.
 US-Präsident Donald Trump streicht Gelder für die Wissenschaft drastisch zusammen. Die Daten eines Stellenportals zeigen: Forschende bewerben sich nun deutlich häufiger auf Jobs außerhalb der USA.
US-Präsident Donald Trump streicht Gelder für die Wissenschaft drastisch zusammen. Die Daten eines Stellenportals zeigen: Forschende bewerben sich nun deutlich häufiger auf Jobs außerhalb der USA.
 Das weltweit größte Sonnenteleskop hat erstmals Bilder mit dem deutschen Instrument VTF aufgenommen. Die Aufnahmen zeigen beispiellose Details der Sonnenoberfläche. Forscher erhoffen sich neue Erkenntnisse über die Dynamik der Sonne.
Das weltweit größte Sonnenteleskop hat erstmals Bilder mit dem deutschen Instrument VTF aufgenommen. Die Aufnahmen zeigen beispiellose Details der Sonnenoberfläche. Forscher erhoffen sich neue Erkenntnisse über die Dynamik der Sonne.
 Wer für uns angenehm riecht, mit dem möchten wir eher befreundet sein. Das hat ein Experiment in den USA ergeben. Dabei geht es nicht nur um den Körperduft.
Wer für uns angenehm riecht, mit dem möchten wir eher befreundet sein. Das hat ein Experiment in den USA ergeben. Dabei geht es nicht nur um den Körperduft.
 Ein deutsches Staatsunternehmen kauft trotz Ukrainekrieg russisches Gas, das Volumen hat zuletzt sogar zugenommen. SPIEGEL-Redakteurin Susanne Götze erklärt, wie die Deals ablaufen und wie sich das Wirtschaftsministerium verhält.
Ein deutsches Staatsunternehmen kauft trotz Ukrainekrieg russisches Gas, das Volumen hat zuletzt sogar zugenommen. SPIEGEL-Redakteurin Susanne Götze erklärt, wie die Deals ablaufen und wie sich das Wirtschaftsministerium verhält.
 Gut 34 Milliarden Dollar Gewinn und 90 Milliarden Dollar Umsatz: Dem Alphabet-Konzern geht es blendend. Die Cloud wächst überdurchschnittlich, doch das Werbegeschäft bleibt die wichtigste Einnahmequelle.
Gut 34 Milliarden Dollar Gewinn und 90 Milliarden Dollar Umsatz: Dem Alphabet-Konzern geht es blendend. Die Cloud wächst überdurchschnittlich, doch das Werbegeschäft bleibt die wichtigste Einnahmequelle.
 In uralten Gesteinsschichten sind Forscher auf die älteste Ameise der Welt gestoßen. Mit ihren sensenartigen Mundwerkzeugen haben die Tiere wohl ihre Beute umklammert und aufgespießt.
In uralten Gesteinsschichten sind Forscher auf die älteste Ameise der Welt gestoßen. Mit ihren sensenartigen Mundwerkzeugen haben die Tiere wohl ihre Beute umklammert und aufgespießt.
 Fehlermeldungen und technische Probleme stören Vorbestellungen für die Switch 2 in den USA. Nintendo, Hersteller der neuen Spielkonsole, gibt sich überrascht.
Fehlermeldungen und technische Probleme stören Vorbestellungen für die Switch 2 in den USA. Nintendo, Hersteller der neuen Spielkonsole, gibt sich überrascht.
 Insbesondere ältere Menschen werden oft Opfer von Betrugsversuchen. Die Behörden in Osaka wollen dagegen vorgehen: Menschen über 65 Jahre dürfen während der Nutzung von Geldautomaten nicht mehr telefonieren.
Insbesondere ältere Menschen werden oft Opfer von Betrugsversuchen. Die Behörden in Osaka wollen dagegen vorgehen: Menschen über 65 Jahre dürfen während der Nutzung von Geldautomaten nicht mehr telefonieren.
 Die Europäische Union ist immer noch stark von Öl- und Erdgasimporten abhängig. Mehr Wind- und Solarparks sichern politische Unabhängigkeit, doch dieser Wandel hat mächtige Gegner.
Die Europäische Union ist immer noch stark von Öl- und Erdgasimporten abhängig. Mehr Wind- und Solarparks sichern politische Unabhängigkeit, doch dieser Wandel hat mächtige Gegner.
 In Brasilien wird ein sensationeller Fund gemacht: In einem Felsabdruck wird die älteste Ameise der Welt aufgestöbert. Die Forschungsergebnisse zu dem uralten Tier können auch dabei helfen, Lücken in der Evolutionsgeschichte zu schließen.
In Brasilien wird ein sensationeller Fund gemacht: In einem Felsabdruck wird die älteste Ameise der Welt aufgestöbert. Die Forschungsergebnisse zu dem uralten Tier können auch dabei helfen, Lücken in der Evolutionsgeschichte zu schließen.
 Experten stufen es als Sensation ein: Ein Seeadler-Paar in Duisburg hat drei Jungtiere bekommen. Auf die Entwicklung der nächsten Wochen wird gespannt geschaut. Für den Bruterfolg gibt es einige wichtige Faktoren - auch von den Menschen in der Umgebung hängt es nun maßgeblich ab.
Experten stufen es als Sensation ein: Ein Seeadler-Paar in Duisburg hat drei Jungtiere bekommen. Auf die Entwicklung der nächsten Wochen wird gespannt geschaut. Für den Bruterfolg gibt es einige wichtige Faktoren - auch von den Menschen in der Umgebung hängt es nun maßgeblich ab.
 Aufgrund der geografischen Isolation ist Hawaii bekannt für eine ganze Reihe bizarrer Lebewesen. Die neueste Entdeckung ist eine fleischfressende Mottenraupe. Um an ihre Beute zu gelangen, halten sich die Larven in der Nähe von Spinnennetzen auf.
Aufgrund der geografischen Isolation ist Hawaii bekannt für eine ganze Reihe bizarrer Lebewesen. Die neueste Entdeckung ist eine fleischfressende Mottenraupe. Um an ihre Beute zu gelangen, halten sich die Larven in der Nähe von Spinnennetzen auf.
 In Washington geht es ab Montag um die Zukunft der Internetsuche: Google soll für illegale Monopolpraktiken abgestraft werden. Muss sich der Konzern von Chrome und Android trennen?
In Washington geht es ab Montag um die Zukunft der Internetsuche: Google soll für illegale Monopolpraktiken abgestraft werden. Muss sich der Konzern von Chrome und Android trennen?
 Impfmüdigkeit und Fehlinformationen lassen die Zahl der Immunisierungen in den USA schrumpfen. Die Folgen sind mitunter fatal, wie eine neue Studie nun berechnet: Das Risiko für Masern-Ausbrüche ist schon jetzt deutlich erhöht - und längst besiegt geglaubte Krankheiten könnten zurückkehren.
Impfmüdigkeit und Fehlinformationen lassen die Zahl der Immunisierungen in den USA schrumpfen. Die Folgen sind mitunter fatal, wie eine neue Studie nun berechnet: Das Risiko für Masern-Ausbrüche ist schon jetzt deutlich erhöht - und längst besiegt geglaubte Krankheiten könnten zurückkehren.
 Extremwetter und Borkenkäfer haben ihre Spuren hinterlassen: Allein 23 Prozent des thüringischen Waldes sind offenbar so kaputt, dass sie aufgeforstet gehören. Die Besitzer müssen umdenken.
Extremwetter und Borkenkäfer haben ihre Spuren hinterlassen: Allein 23 Prozent des thüringischen Waldes sind offenbar so kaputt, dass sie aufgeforstet gehören. Die Besitzer müssen umdenken.
 Der neue KI-Bot von Meta ist hierzulande erst seit wenigen Wochen auf WhatsApp, Facebook und Instagram verfügbar. Nach einem kritischen Medienbericht schränkt Meta das Programm nun ein.
Der neue KI-Bot von Meta ist hierzulande erst seit wenigen Wochen auf WhatsApp, Facebook und Instagram verfügbar. Nach einem kritischen Medienbericht schränkt Meta das Programm nun ein.
 Forscher entdecken ein übersehenes Reich auf und in unserem Körper: Jeder Mensch ist von Billionen Viren besiedelt. Die winzigen Partikel können krank machen – und halten uns zugleich offenbar gesund.
Forscher entdecken ein übersehenes Reich auf und in unserem Körper: Jeder Mensch ist von Billionen Viren besiedelt. Die winzigen Partikel können krank machen – und halten uns zugleich offenbar gesund.
 Wegovy und Ozempic: Die Spritzen versprechen einen schnellen Gewichtsverlust. Nun wirbt ein Unternehmen mit einer Tablette, die genauso gut funktionieren soll. Eine klinische Studie macht Hoffnung, aber viele Fragen sind offen.
Wegovy und Ozempic: Die Spritzen versprechen einen schnellen Gewichtsverlust. Nun wirbt ein Unternehmen mit einer Tablette, die genauso gut funktionieren soll. Eine klinische Studie macht Hoffnung, aber viele Fragen sind offen.
 Nach einem sogenannten Überlastungsangriff ist das Internetportal berlin.de gestört. Wer hinter der Attacke steht, ist nach Angaben der Senatskanzlei nicht bekannt. Es ist nicht die erste Attacke dieser Art.
Nach einem sogenannten Überlastungsangriff ist das Internetportal berlin.de gestört. Wer hinter der Attacke steht, ist nach Angaben der Senatskanzlei nicht bekannt. Es ist nicht die erste Attacke dieser Art.
 Bisher haben sie nur fünf Menschen auf der ganzen Welt gesehen: die Farbe Olo. Mithilfe eines speziellen Lasersystems haben Forscher den blaugrünen Farbton jetzt entdeckt. Er soll alle anderen Farben an Intensität und Leuchtkraft übertreffen. Doch ist Olo wirklich neu?
Bisher haben sie nur fünf Menschen auf der ganzen Welt gesehen: die Farbe Olo. Mithilfe eines speziellen Lasersystems haben Forscher den blaugrünen Farbton jetzt entdeckt. Er soll alle anderen Farben an Intensität und Leuchtkraft übertreffen. Doch ist Olo wirklich neu?
 In Teilen von Madrid, Lissabon oder Barcelona gehen nach dem Blackout am Montag wieder die Lichter an. Daten zeigen: Bei der Wiederherstellung der Stromversorgung haben erneuerbare Energien eine wichtige Rolle gespielt.
In Teilen von Madrid, Lissabon oder Barcelona gehen nach dem Blackout am Montag wieder die Lichter an. Daten zeigen: Bei der Wiederherstellung der Stromversorgung haben erneuerbare Energien eine wichtige Rolle gespielt.
 Im zweiten Anlauf klappte es: Amazon hat im Rahmen von Project Kuiper 27 voll funktionsfähige Internetsatelliten in die Umlaufbahn geschickt. Die Zahl soll in den kommenden Jahren massiv ansteigen.
Im zweiten Anlauf klappte es: Amazon hat im Rahmen von Project Kuiper 27 voll funktionsfähige Internetsatelliten in die Umlaufbahn geschickt. Die Zahl soll in den kommenden Jahren massiv ansteigen.
 In den USA sterben jährlich 1000 Menschen durch Polizeischüsse. Die meisten Getöteten werden dabei mehrfach von Kugeln getroffen - im Schnitt sogar sechsmal, zeigt eine neue Studie. Damit verringert sich die Chance der Opfer, zu überleben.
In den USA sterben jährlich 1000 Menschen durch Polizeischüsse. Die meisten Getöteten werden dabei mehrfach von Kugeln getroffen - im Schnitt sogar sechsmal, zeigt eine neue Studie. Damit verringert sich die Chance der Opfer, zu überleben.
 Der Chatbot von OpenAI gibt künftig konkrete Produktempfehlungen. Zu Beginn geht es OpenAI nicht darum, Geld zu verdienen. Dennoch dürfte die Ankündigung ein Schreckmoment für Google sein.
Der Chatbot von OpenAI gibt künftig konkrete Produktempfehlungen. Zu Beginn geht es OpenAI nicht darum, Geld zu verdienen. Dennoch dürfte die Ankündigung ein Schreckmoment für Google sein.
 Der massive Stromausfall in Spanien ist laut einem spanischen Experten auf zwei Hauptprobleme zurückzuführen: die schlechte internationale Anbindung und den hohen Anteil an erneuerbaren Energien. Mögliche Lösungen des Problems seien nicht schnell zur Hand.
Der massive Stromausfall in Spanien ist laut einem spanischen Experten auf zwei Hauptprobleme zurückzuführen: die schlechte internationale Anbindung und den hohen Anteil an erneuerbaren Energien. Mögliche Lösungen des Problems seien nicht schnell zur Hand.
 Trockenheit, Klimawandel und Schädlinge machen den heimischen Wäldern zu schaffen. Andernorts werden große Flächen gerodet. Die Esa will mit einer neuen Mission die grüne Lunge der Erde besser verstehen.
Trockenheit, Klimawandel und Schädlinge machen den heimischen Wäldern zu schaffen. Andernorts werden große Flächen gerodet. Die Esa will mit einer neuen Mission die grüne Lunge der Erde besser verstehen.
 US-Präsident Donald Trump streicht Gelder für die Wissenschaft drastisch zusammen. Die Daten eines Stellenportals zeigen: Forschende bewerben sich nun deutlich häufiger auf Jobs außerhalb der USA.
US-Präsident Donald Trump streicht Gelder für die Wissenschaft drastisch zusammen. Die Daten eines Stellenportals zeigen: Forschende bewerben sich nun deutlich häufiger auf Jobs außerhalb der USA.
 Am Skelett eines Mannes in England fanden Forscher verräterische Bissspuren. Sie stammen vermutlich von einer Großkatze. Für einen der beiden endete die Begegnung fatal.
Am Skelett eines Mannes in England fanden Forscher verräterische Bissspuren. Sie stammen vermutlich von einer Großkatze. Für einen der beiden endete die Begegnung fatal.
 Die Nutzung privater Handys ist im Pentagon weitgehend untersagt. US-Verteidigungsminister Pete Hegseth ließ sich daher die Chat-App Signal einem Bericht zufolge in der Desktop-Variante einrichten.
Die Nutzung privater Handys ist im Pentagon weitgehend untersagt. US-Verteidigungsminister Pete Hegseth ließ sich daher die Chat-App Signal einem Bericht zufolge in der Desktop-Variante einrichten.
 Chatbots sind stets höflich und freundlich zu ihren Nutzern - darauf sind sie getrimmt. Doch eine neue Version von ChatGPT übertreibt es mit dem Zuspruch. Selbst definitiv schlechte Ideen werden von der KI euphorisch unterstützt. Die Entwickler reagieren jetzt.
Chatbots sind stets höflich und freundlich zu ihren Nutzern - darauf sind sie getrimmt. Doch eine neue Version von ChatGPT übertreibt es mit dem Zuspruch. Selbst definitiv schlechte Ideen werden von der KI euphorisch unterstützt. Die Entwickler reagieren jetzt.
 Nach einem Brand in einem australischen Nationalpark sind 700 Koalas gezielt getötet worden. Die Regierung spricht von einem Akt der Barmherzigkeit, Tierrechtler verurteilen das Vorgehen als »nationale Schande«.
Nach einem Brand in einem australischen Nationalpark sind 700 Koalas gezielt getötet worden. Die Regierung spricht von einem Akt der Barmherzigkeit, Tierrechtler verurteilen das Vorgehen als »nationale Schande«.
 Lange galten Vorgänge im Erdmantel als wahrscheinlichste Ursache für die Anhebung der südafrikanischen Landfläche. Eine Studie zweifelt dies nun an. Verantwortlich ist wohl vielmehr der Mensch.
Lange galten Vorgänge im Erdmantel als wahrscheinlichste Ursache für die Anhebung der südafrikanischen Landfläche. Eine Studie zweifelt dies nun an. Verantwortlich ist wohl vielmehr der Mensch.
 Orang-Utans im Zoo sind kreativer als ihre wildlebenden Artgenossen. Das zeigt eine Studie. Die Menschenaffen erkunden ihre Umgebung intensiver und nutzen dabei Werkzeuge. Forscher haben eine Vermutung, was der Grund für den großen Forscherdrang der gefangenen Tiere sein könnte.
Orang-Utans im Zoo sind kreativer als ihre wildlebenden Artgenossen. Das zeigt eine Studie. Die Menschenaffen erkunden ihre Umgebung intensiver und nutzen dabei Werkzeuge. Forscher haben eine Vermutung, was der Grund für den großen Forscherdrang der gefangenen Tiere sein könnte.
 Der Facebook-Feed ist gefüllt mit Spam-Beiträgen, das sieht nun auch Meta ein und kündigt an, dagegen vorzugehen. Demnach hat das Unternehmen 2024 bereits mehr als 100 Millionen Fake-Seiten entfernt.
Der Facebook-Feed ist gefüllt mit Spam-Beiträgen, das sieht nun auch Meta ein und kündigt an, dagegen vorzugehen. Demnach hat das Unternehmen 2024 bereits mehr als 100 Millionen Fake-Seiten entfernt.
 Kosmos 482 ist 500 Kilogramm schwer und seit mehr als 50 Jahren in der Erdumlaufbahn unterwegs. Statt wie geplant auf der Venus zu landen, dürfte die sowjetische Raumsonde bald auf der Erde einschlagen.
Kosmos 482 ist 500 Kilogramm schwer und seit mehr als 50 Jahren in der Erdumlaufbahn unterwegs. Statt wie geplant auf der Venus zu landen, dürfte die sowjetische Raumsonde bald auf der Erde einschlagen.
 Nach einem sogenannten Überlastungsangriff ist das Internetportal berlin.de gestört. Wer hinter der Attacke steht, ist nach Angaben der Senatskanzlei nicht bekannt. Es ist nicht die erste Attacke dieser Art.
Nach einem sogenannten Überlastungsangriff ist das Internetportal berlin.de gestört. Wer hinter der Attacke steht, ist nach Angaben der Senatskanzlei nicht bekannt. Es ist nicht die erste Attacke dieser Art.
 Der massive Stromausfall in Spanien ist laut einem spanischen Experten auf zwei Hauptprobleme zurückzuführen: die schlechte internationale Anbindung und den hohen Anteil an erneuerbaren Energien. Mögliche Lösungen des Problems seien nicht schnell zur Hand.
Der massive Stromausfall in Spanien ist laut einem spanischen Experten auf zwei Hauptprobleme zurückzuführen: die schlechte internationale Anbindung und den hohen Anteil an erneuerbaren Energien. Mögliche Lösungen des Problems seien nicht schnell zur Hand.
 Der Skandal um den Umgang mit sensiblen Informationen in der Trump-Regierung ist trotz der Entlassung von Sicherheitsberater Mike Waltz nicht beendet. Im Mittelpunkt steht nun die App TeleMessage.
Der Skandal um den Umgang mit sensiblen Informationen in der Trump-Regierung ist trotz der Entlassung von Sicherheitsberater Mike Waltz nicht beendet. Im Mittelpunkt steht nun die App TeleMessage.
 EU-Kommissionspräsidentin Ursula von der Leyen sieht die Rolle der Wissenschaft in Gefahr und erinnert an Marie Curie. Als Lockmittel für US-Forscher bietet sie ordentlich Geld.
EU-Kommissionspräsidentin Ursula von der Leyen sieht die Rolle der Wissenschaft in Gefahr und erinnert an Marie Curie. Als Lockmittel für US-Forscher bietet sie ordentlich Geld.
 Angesichts der drohenden Mittelkürzungen bangen US-Forscher um ihre Datensätze und Arbeitsergebnisse. In Bremen finden zumindest Teile der Datensätze der Wetter- und Ozeanografiebehörde NOAA eine neue Heimat. Für die Uni-Rektorin geht es um nicht weniger als den Erhalt von Wissen..
Angesichts der drohenden Mittelkürzungen bangen US-Forscher um ihre Datensätze und Arbeitsergebnisse. In Bremen finden zumindest Teile der Datensätze der Wetter- und Ozeanografiebehörde NOAA eine neue Heimat. Für die Uni-Rektorin geht es um nicht weniger als den Erhalt von Wissen..
 Orang-Utans im Zoo sind kreativer als ihre wildlebenden Artgenossen. Das zeigt eine Studie. Die Menschenaffen erkunden ihre Umgebung intensiver und nutzen dabei Werkzeuge. Forscher haben eine Vermutung, was der Grund für den großen Forscherdrang der gefangenen Tiere sein könnte.
Orang-Utans im Zoo sind kreativer als ihre wildlebenden Artgenossen. Das zeigt eine Studie. Die Menschenaffen erkunden ihre Umgebung intensiver und nutzen dabei Werkzeuge. Forscher haben eine Vermutung, was der Grund für den großen Forscherdrang der gefangenen Tiere sein könnte.
 Die Gesundheit von Menschen wird wesentlich von ihrem Einkommen und ihrer Ausbildung bestimmt, stellt eine Studie der WHO fest. Menschen in ärmeren Regionen haben demnach eine deutlich geringere Lebenserwartung. Die WHO schlägt auch konkrete Gegenmaßnahmen vor.
Die Gesundheit von Menschen wird wesentlich von ihrem Einkommen und ihrer Ausbildung bestimmt, stellt eine Studie der WHO fest. Menschen in ärmeren Regionen haben demnach eine deutlich geringere Lebenserwartung. Die WHO schlägt auch konkrete Gegenmaßnahmen vor.
 Trumps mittlerweile entlassener Sicherheitsberater Mike Waltz, aber auch die US-Grenzschutzbehörde nutzten eine von TeleMessage angepasste Version der App Signal. Der Dienstleister räumte nun Sicherheitsprobleme ein.
Trumps mittlerweile entlassener Sicherheitsberater Mike Waltz, aber auch die US-Grenzschutzbehörde nutzten eine von TeleMessage angepasste Version der App Signal. Der Dienstleister räumte nun Sicherheitsprobleme ein.
 US-Präsident Donald Trump stoppt die Finanzierung bestimmter medizinischer Forschung, bei der Krankheitserreger verstärkt werden. Sein Gesundheitsminister Robert Kennedy stellt die Arbeit der Labore als gefährlich dar.
US-Präsident Donald Trump stoppt die Finanzierung bestimmter medizinischer Forschung, bei der Krankheitserreger verstärkt werden. Sein Gesundheitsminister Robert Kennedy stellt die Arbeit der Labore als gefährlich dar.
 Forscher der TU München und des Imperial College London entwickeln eine Methode zur schnelleren Identifikation von Krankheitserregern. Mit der neuen Technik kann die Wartezeit von mehreren Tagen auf wenige Minuten verkürzt werden. Dies könnte die Therapie revolutionieren.
Forscher der TU München und des Imperial College London entwickeln eine Methode zur schnelleren Identifikation von Krankheitserregern. Mit der neuen Technik kann die Wartezeit von mehreren Tagen auf wenige Minuten verkürzt werden. Dies könnte die Therapie revolutionieren.
 Viele sind sich sicher: GTA 6 wird die Videospiel-Industrie in ihren Grundfesten erschüttern. Wie groß die Erwartungen sind, zeigt schon die Resonanz auf den zweiten Trailer, in dem Entwickler Rockstar erstmals tiefer in die Handlung des Gangster-Epos eintaucht.
Viele sind sich sicher: GTA 6 wird die Videospiel-Industrie in ihren Grundfesten erschüttern. Wie groß die Erwartungen sind, zeigt schon die Resonanz auf den zweiten Trailer, in dem Entwickler Rockstar erstmals tiefer in die Handlung des Gangster-Epos eintaucht.
 Die Opfer hatten keine Chance: NSO konnte sein Überwachungsprogramm Pegasus auf beliebigen Smartphones installieren und unter anderem WhatsApp-Chats mitlesen. Nun soll die Firma finanziell büßen.
Die Opfer hatten keine Chance: NSO konnte sein Überwachungsprogramm Pegasus auf beliebigen Smartphones installieren und unter anderem WhatsApp-Chats mitlesen. Nun soll die Firma finanziell büßen.
 In den USA hat laut Medienberichten erstmals eine KI-Version eines Gestorbenen vor Gericht ausgesagt. Die Rede ist von einem »Frankenstein der Liebe«, der Richter gab sich gerührt.
In den USA hat laut Medienberichten erstmals eine KI-Version eines Gestorbenen vor Gericht ausgesagt. Die Rede ist von einem »Frankenstein der Liebe«, der Richter gab sich gerührt.
 Wer nicht zeitnah reagiert, spendiert Meta die eigenen Instagram-Fotos und Facebook-Posts als KI-Trainingsmaterial. Künstler und Verbraucherschützer stemmen sich dagegen, doch die Zeit wird knapp.
Wer nicht zeitnah reagiert, spendiert Meta die eigenen Instagram-Fotos und Facebook-Posts als KI-Trainingsmaterial. Künstler und Verbraucherschützer stemmen sich dagegen, doch die Zeit wird knapp.
 Sie tauchen 20 Meter tief ohne Atemgerät, auch schwanger oder im hohen Alter: Die Haenyeo von der südkoreanischen Insel Jeju leisten Legendäres. Eine Genanalyse zeigt, warum ihre Körper die Belastung aushalten.
Sie tauchen 20 Meter tief ohne Atemgerät, auch schwanger oder im hohen Alter: Die Haenyeo von der südkoreanischen Insel Jeju leisten Legendäres. Eine Genanalyse zeigt, warum ihre Körper die Belastung aushalten.
 Wissenschaftler können Krankheitserreger mit neuen Eigenschaften kreieren. Donald Trump hält das für gefährlich und will die Forschung per Dekret drastisch einschränken. Er verweist auch auf die Coronapandemie.
Wissenschaftler können Krankheitserreger mit neuen Eigenschaften kreieren. Donald Trump hält das für gefährlich und will die Forschung per Dekret drastisch einschränken. Er verweist auch auf die Coronapandemie.
 Für Spielefans gibt es gerade eine gute und eine schlechte Nachricht. Die gute: »Grand Theft Auto VI« hat jetzt endlich ein Releasedatum. Die schlechte: Das Spiel soll erst in gut einem Jahr erscheinen.
Für Spielefans gibt es gerade eine gute und eine schlechte Nachricht. Die gute: »Grand Theft Auto VI« hat jetzt endlich ein Releasedatum. Die schlechte: Das Spiel soll erst in gut einem Jahr erscheinen.
 Die Erde hat den zweitwärmsten April seit Beginn der Aufzeichnungen hinter sich. Im Vorjahr lag die Durchschnittstemperatur noch höher - dafür gab es aber einen speziellen Grund.
Die Erde hat den zweitwärmsten April seit Beginn der Aufzeichnungen hinter sich. Im Vorjahr lag die Durchschnittstemperatur noch höher - dafür gab es aber einen speziellen Grund.
 Trotz jahrzehntelanger Forschung bleibt die Tiefsee größtenteils unverstanden. Nur ein kleiner Bruchteil des Tiefseebodens ist laut einer neuen Studie durch direkte Beobachtungen erfasst. Und dieser Bereich erstreckt sich größtenteils auf die 200-Meilen-Zonen weniger Staaten.
Trotz jahrzehntelanger Forschung bleibt die Tiefsee größtenteils unverstanden. Nur ein kleiner Bruchteil des Tiefseebodens ist laut einer neuen Studie durch direkte Beobachtungen erfasst. Und dieser Bereich erstreckt sich größtenteils auf die 200-Meilen-Zonen weniger Staaten.
 Die Spielkonsole Switch war kommerziell ein Riesenerfolg, bald bringt Nintendo das Nachfolgegerät in den Handel. Für dieses hat das Unternehmen jetzt erstmals eine Absatzprognose öffentlich gemacht.
Die Spielkonsole Switch war kommerziell ein Riesenerfolg, bald bringt Nintendo das Nachfolgegerät in den Handel. Für dieses hat das Unternehmen jetzt erstmals eine Absatzprognose öffentlich gemacht.
 Feinste Partikel aus dem Rauch von Waldbränden können sich tief in der Lunge festsetzen. Experten haben die Gesundheitsauswirkungen von durch den Klimawandel verursachten Bränden in den USA berechnet.
Feinste Partikel aus dem Rauch von Waldbränden können sich tief in der Lunge festsetzen. Experten haben die Gesundheitsauswirkungen von durch den Klimawandel verursachten Bränden in den USA berechnet.
 Obwohl die Tiefsee mehr als 60 Prozent der Erdoberfläche ausmacht, ist sie weitgehend unerforscht. Experten warnen: Ganze Regionen könnten zerstört werden, bevor sie jemand gesehen hat.
Obwohl die Tiefsee mehr als 60 Prozent der Erdoberfläche ausmacht, ist sie weitgehend unerforscht. Experten warnen: Ganze Regionen könnten zerstört werden, bevor sie jemand gesehen hat.
 Der neue Roboterarm Vulcan kann Millionen verschiedener Gegenstände zielgenau platzieren. Amazon verspricht, dass die Automation nicht zulasten von Arbeitsplätzen geht.
Der neue Roboterarm Vulcan kann Millionen verschiedener Gegenstände zielgenau platzieren. Amazon verspricht, dass die Automation nicht zulasten von Arbeitsplätzen geht.
 Die Jugend in Ländern wie Albanien, Jamaika oder Kasachstan glaubt fester an ihre Zukunftschancen als Gleichaltrige in Frankreich oder Südkorea. Das geht aus einer Studie hervor. Wenn die Wirtschaft wächst, ist das laut den Forschern auch kein Problem. Doch der Optimismus birgt Risiken.
Die Jugend in Ländern wie Albanien, Jamaika oder Kasachstan glaubt fester an ihre Zukunftschancen als Gleichaltrige in Frankreich oder Südkorea. Das geht aus einer Studie hervor. Wenn die Wirtschaft wächst, ist das laut den Forschern auch kein Problem. Doch der Optimismus birgt Risiken.
 Vor Jahrhunderten träumten Alchemisten von der Umwandlung von billigem Metall in wertvolles Gold. Physiker am Forschungszentrum Cern zeigen nun, dass es möglich ist: Sie machen aus Blei Gold. Doch die Menge ist winzig - und das Ganze hat noch einen weiteren Haken.
Vor Jahrhunderten träumten Alchemisten von der Umwandlung von billigem Metall in wertvolles Gold. Physiker am Forschungszentrum Cern zeigen nun, dass es möglich ist: Sie machen aus Blei Gold. Doch die Menge ist winzig - und das Ganze hat noch einen weiteren Haken.
 Am Kernforschungszentrum Cern in Genf lassen Forscher Bleikerne bei Lichtgeschwindigkeit durch einen Tunnel fliegen. Dabei entsteht Gold, wie sie nun berichteten. Einen Haken gibt es allerdings.
Am Kernforschungszentrum Cern in Genf lassen Forscher Bleikerne bei Lichtgeschwindigkeit durch einen Tunnel fliegen. Dabei entsteht Gold, wie sie nun berichteten. Einen Haken gibt es allerdings.
 Auf X machte die Seite schon die Runde: Auf einer Fake-Homepage von Friedrich Merz streuen Unbekannte Falschbehauptungen über seine politischen Pläne. Die CDU kündigt Konsequenzen an.
Auf X machte die Seite schon die Runde: Auf einer Fake-Homepage von Friedrich Merz streuen Unbekannte Falschbehauptungen über seine politischen Pläne. Die CDU kündigt Konsequenzen an.
 Ein Museumsstück der Raumfahrtgeschichte soll an diesem Wochenende auf die Erde stürzen. Es handelt sich um eine Sonde der Sowjetunion, die 1972 eigentlich gestartet war, um die Venus zu erforschen. Nun jedoch schlägt sie irgendwo auf der Erde auf.
Ein Museumsstück der Raumfahrtgeschichte soll an diesem Wochenende auf die Erde stürzen. Es handelt sich um eine Sonde der Sowjetunion, die 1972 eigentlich gestartet war, um die Venus zu erforschen. Nun jedoch schlägt sie irgendwo auf der Erde auf.
 Es sind die ältesten vollständig erhaltenen Jagdwaffen der Menschheitsgeschichte: Doch eine neue Datierung der Schöninger Speere aus Niedersachsen kratzt am Image des Sensationsfundes. Ein Forschungsteam schätzt ihn rund 100.000 Jahre jünger ein als bisher angenommen.
Es sind die ältesten vollständig erhaltenen Jagdwaffen der Menschheitsgeschichte: Doch eine neue Datierung der Schöninger Speere aus Niedersachsen kratzt am Image des Sensationsfundes. Ein Forschungsteam schätzt ihn rund 100.000 Jahre jünger ein als bisher angenommen.
 Unter dem neuen Kanzler soll sich vor allem das Umweltministerium um Klimapolitik kümmern. Das weckt schlechte Erinnerungen an die Strukturen vor 2021. Es kommt jetzt auf den Gestaltungswillen des Ministers an.
Unter dem neuen Kanzler soll sich vor allem das Umweltministerium um Klimapolitik kümmern. Das weckt schlechte Erinnerungen an die Strukturen vor 2021. Es kommt jetzt auf den Gestaltungswillen des Ministers an.
 Ihr Fund gilt als Sensation: Außergewöhnlich gut erhaltene Holzwaffen aus einer Fundstätte in Niedersachsen wurden bisher auf ein Alter von 300.000 Jahren datiert. Forscher halten sie nun für deutlich jünger.
Ihr Fund gilt als Sensation: Außergewöhnlich gut erhaltene Holzwaffen aus einer Fundstätte in Niedersachsen wurden bisher auf ein Alter von 300.000 Jahren datiert. Forscher halten sie nun für deutlich jünger.
 Sie sind die höchste Bergkette Europas, Heimat des Edelweißes und ein beliebtes Reiseziel - die Alpen. Aber wie sind die Alpen eigentlich entstanden? Eine Geologin und ein Geologe erklären bei ntv.de, wo der Ursprung des Gebirges liegt.
Sie sind die höchste Bergkette Europas, Heimat des Edelweißes und ein beliebtes Reiseziel - die Alpen. Aber wie sind die Alpen eigentlich entstanden? Eine Geologin und ein Geologe erklären bei ntv.de, wo der Ursprung des Gebirges liegt.
 Das Ziel war die Venus, doch da kam eine sowjetische Sonde nie an. Stattdessen schwebte sie seit 1972 in der Erdumlaufbahn. Die Sonde überfliegt auch Deutschland, bevor sie schließlich Moskau zufolge ihr Ende in einem Ozean findet.
Das Ziel war die Venus, doch da kam eine sowjetische Sonde nie an. Stattdessen schwebte sie seit 1972 in der Erdumlaufbahn. Die Sonde überfliegt auch Deutschland, bevor sie schließlich Moskau zufolge ihr Ende in einem Ozean findet.
 Topmanagerin Jen Wong hat die 20 Jahre alte Diskussionsplattform Reddit aus der Nische geholt und auf Erfolg getrimmt. Wieso Trump ihr keine Sorgen macht – und welche Pläne sie für Deutschland hat.
Topmanagerin Jen Wong hat die 20 Jahre alte Diskussionsplattform Reddit aus der Nische geholt und auf Erfolg getrimmt. Wieso Trump ihr keine Sorgen macht – und welche Pläne sie für Deutschland hat.
 Ein Student verkauft ein iPad im Netz, bekommt das Geld überwiesen und übergibt das Tablet dem vermeintlichen Käufer. Erst Monate später wird klar: Der Mann ist ein Betrüger. Wie man die Masche rechtzeitig erkennt.
Ein Student verkauft ein iPad im Netz, bekommt das Geld überwiesen und übergibt das Tablet dem vermeintlichen Käufer. Erst Monate später wird klar: Der Mann ist ein Betrüger. Wie man die Masche rechtzeitig erkennt.
 Die ausgediente Raumsonde Kosmos 482 ist in den Pazifik abgestürzt, ohne Schäden anzurichten. Ihr Ziel war die Venus – ein Planet, über den wir bis heute verblüffend wenig wissen, obwohl er uns näher ist als der Mars.
Die ausgediente Raumsonde Kosmos 482 ist in den Pazifik abgestürzt, ohne Schäden anzurichten. Ihr Ziel war die Venus – ein Planet, über den wir bis heute verblüffend wenig wissen, obwohl er uns näher ist als der Mars.
 Skype-Nutzer sind ab Montag nicht mehr über die App erreichbar, haben aber noch Gelegenheit, ihr Gesprächsarchiv zu sichern. Microsoft möchte die Nutzer zu einem anderen Dienst umleiten.
Skype-Nutzer sind ab Montag nicht mehr über die App erreichbar, haben aber noch Gelegenheit, ihr Gesprächsarchiv zu sichern. Microsoft möchte die Nutzer zu einem anderen Dienst umleiten.
 Ein Trupp von Twens erschütterte vor 100 Jahren das wissenschaftliche Weltbild. Sie zeigten, dass im Reich der Atome der gesunde Menschenverstand nicht gilt und legten die Grundlage für den Bau der Atombombe.
Ein Trupp von Twens erschütterte vor 100 Jahren das wissenschaftliche Weltbild. Sie zeigten, dass im Reich der Atome der gesunde Menschenverstand nicht gilt und legten die Grundlage für den Bau der Atombombe.
 Die Quantenmechanik wird hundert Jahre alt – heute forschen Wissenschaftler auf ihrer Grundlage und entwickeln neue Technologien. Vier Experimente veranschaulichen die überraschenden Regeln der Quantenwelt.
Die Quantenmechanik wird hundert Jahre alt – heute forschen Wissenschaftler auf ihrer Grundlage und entwickeln neue Technologien. Vier Experimente veranschaulichen die überraschenden Regeln der Quantenwelt.
 Die Gesundheit von Menschen wird wesentlich von ihrem Einkommen und ihrer Ausbildung bestimmt, stellt eine Studie der WHO fest. Menschen in ärmeren Regionen haben demnach eine deutlich geringere Lebenserwartung. Die WHO schlägt auch konkrete Gegenmaßnahmen vor.
Die Gesundheit von Menschen wird wesentlich von ihrem Einkommen und ihrer Ausbildung bestimmt, stellt eine Studie der WHO fest. Menschen in ärmeren Regionen haben demnach eine deutlich geringere Lebenserwartung. Die WHO schlägt auch konkrete Gegenmaßnahmen vor.
 Der Ursprung des Coronavirus ist nebulös. Eine neue Studie verweist nun auf Ähnlichkeiten mit der Ausbreitung jenes Virus, das 2002/2003 eine Epidemie ausgelöst hatte. Dies spreche für einen natürlichen Ursprung von Sars-CoV-2 - und gegen einen Laborunfall.
Der Ursprung des Coronavirus ist nebulös. Eine neue Studie verweist nun auf Ähnlichkeiten mit der Ausbreitung jenes Virus, das 2002/2003 eine Epidemie ausgelöst hatte. Dies spreche für einen natürlichen Ursprung von Sars-CoV-2 - und gegen einen Laborunfall.
 Das World Wide Web ist fest in amerikanischer Hand, der Präsident hätte die Möglichkeit, diese Macht als Druckmittel einzusetzen. Aus Sorge arbeitet Europa daran, sich von US-Konzernen unabhängiger zu machen. Einfach ist das nicht.
Das World Wide Web ist fest in amerikanischer Hand, der Präsident hätte die Möglichkeit, diese Macht als Druckmittel einzusetzen. Aus Sorge arbeitet Europa daran, sich von US-Konzernen unabhängiger zu machen. Einfach ist das nicht.
 Wissenschaftler haben in Pompeji die Überreste von vier Menschen gefunden. Die Ausgrabungen zeigen, wie eine Familie vergeblich versuchte, sich vor Gestein, Lava und Asche zu schützen.
Wissenschaftler haben in Pompeji die Überreste von vier Menschen gefunden. Die Ausgrabungen zeigen, wie eine Familie vergeblich versuchte, sich vor Gestein, Lava und Asche zu schützen.
 Mit großem Aufwand haben Betrüger den Hamburger Klassikstar Sebastian Knauer hereingelegt und seinen Facebook-Account gekapert. Sie missbrauchen ihn für AfD-freundliche Propaganda. Hilfe von Meta lässt auf sich warten.
Mit großem Aufwand haben Betrüger den Hamburger Klassikstar Sebastian Knauer hereingelegt und seinen Facebook-Account gekapert. Sie missbrauchen ihn für AfD-freundliche Propaganda. Hilfe von Meta lässt auf sich warten.
 Sie ist groß, karnivor und vom Aussterben bedroht: Die Mount-Augustus-Schnecke gibt es nur in Neuseeland. Doch ihr einziger Lebensraum wurde vor Jahren zerstört. Ein Zuchtprogramm versucht, die seltene Art zu erhalten. Dabei gelingen dem Team einmalige Filmaufnahmen.
Sie ist groß, karnivor und vom Aussterben bedroht: Die Mount-Augustus-Schnecke gibt es nur in Neuseeland. Doch ihr einziger Lebensraum wurde vor Jahren zerstört. Ein Zuchtprogramm versucht, die seltene Art zu erhalten. Dabei gelingen dem Team einmalige Filmaufnahmen.
 Mehr als 83 Millionen Menschen mussten im vergangenen Jahr in ihrem eigenen Land Zuflucht suchen, so viel wie nie zuvor. Einen massiven Anstieg gibt es bei der durch Naturkatastrophen ausgelösten Flucht – besonders betroffen: die USA.
Mehr als 83 Millionen Menschen mussten im vergangenen Jahr in ihrem eigenen Land Zuflucht suchen, so viel wie nie zuvor. Einen massiven Anstieg gibt es bei der durch Naturkatastrophen ausgelösten Flucht – besonders betroffen: die USA.
 Sie tauchen 20 Meter tief ohne Atemgerät, auch schwanger oder im hohen Alter: Die Haenyeo von der südkoreanischen Insel Jeju leisten Legendäres. Eine Genanalyse zeigt, warum ihre Körper die Belastung aushalten.
Sie tauchen 20 Meter tief ohne Atemgerät, auch schwanger oder im hohen Alter: Die Haenyeo von der südkoreanischen Insel Jeju leisten Legendäres. Eine Genanalyse zeigt, warum ihre Körper die Belastung aushalten.
 Samsung bringt das Galaxy S25 Edge auf den Markt. Das Smartphone ist extrem dünn, aber so leistungsstark wie die Normalos. Auch bei der Laufzeit soll man angeblich keine allzu großen Einschränkungen hinnehmen. In knapp vier Monaten stellt Apple vermutlich ein iPhone mit ähnlichen Eigenschaften vor.
Samsung bringt das Galaxy S25 Edge auf den Markt. Das Smartphone ist extrem dünn, aber so leistungsstark wie die Normalos. Auch bei der Laufzeit soll man angeblich keine allzu großen Einschränkungen hinnehmen. In knapp vier Monaten stellt Apple vermutlich ein iPhone mit ähnlichen Eigenschaften vor.
 116.900 Menschen werden dem Statistischen Bundesamt zufolge 2023 wegen Hautkrebs stationär behandelt. Das ist wesentlich mehr als noch 20 Jahre zuvor. Besonders die Fälle von hellem Hautkrebs nehmen zu. Die Experten sehen dafür zwei Gründe.
116.900 Menschen werden dem Statistischen Bundesamt zufolge 2023 wegen Hautkrebs stationär behandelt. Das ist wesentlich mehr als noch 20 Jahre zuvor. Besonders die Fälle von hellem Hautkrebs nehmen zu. Die Experten sehen dafür zwei Gründe.
 Migräne ist weit mehr als "nur" Kopfschmerz und quält Betroffene sehr: Bereits Tage bis Stunden vor einer Attacke klagen viele über teils schwere Symptome. Ein in den USA zugelassenes Präparat kann diese Beschwerden lindern. Ein deutscher Experte spricht sogar von einem Paradigmenwechsel.
Migräne ist weit mehr als "nur" Kopfschmerz und quält Betroffene sehr: Bereits Tage bis Stunden vor einer Attacke klagen viele über teils schwere Symptome. Ein in den USA zugelassenes Präparat kann diese Beschwerden lindern. Ein deutscher Experte spricht sogar von einem Paradigmenwechsel.
 Viele Millionen Menschen tippen Tag für Tag auf das Icon der Google-App für Smartphones. Jetzt gibt es eine kleine Veränderung. Erkennen Sie die?
Viele Millionen Menschen tippen Tag für Tag auf das Icon der Google-App für Smartphones. Jetzt gibt es eine kleine Veränderung. Erkennen Sie die?
 Videoaufnahmen zeigen einen jungen Mann mit Rucksack, der eine Mauer beschmiert: Das UNESCO-Weltkulturerbe Chan Chan in Peru ist mit einem obszönen Graffiti verunstaltet worden. Dem Verunstalter droht nun eine empfindliche Strafe.
Videoaufnahmen zeigen einen jungen Mann mit Rucksack, der eine Mauer beschmiert: Das UNESCO-Weltkulturerbe Chan Chan in Peru ist mit einem obszönen Graffiti verunstaltet worden. Dem Verunstalter droht nun eine empfindliche Strafe.
 Immer häufiger werden Wale an den Küsten der Nord- und Ostsee gesichtet. In diesem Jahr wurden bereits mehrere Wal-Kadaver geborgen, darunter ein tonnenschwerer Pottwal auf Sylt. Experten untersuchen die Ursachen für diese ungewöhnlichen Strandungen.
Immer häufiger werden Wale an den Küsten der Nord- und Ostsee gesichtet. In diesem Jahr wurden bereits mehrere Wal-Kadaver geborgen, darunter ein tonnenschwerer Pottwal auf Sylt. Experten untersuchen die Ursachen für diese ungewöhnlichen Strandungen.
 Auf den neuen Kanzler warten bei der Energiewende große Aufgaben. Ein neues Format zeigt, wo Rückschritte drohen und Fortschritte gelingen.
Auf den neuen Kanzler warten bei der Energiewende große Aufgaben. Ein neues Format zeigt, wo Rückschritte drohen und Fortschritte gelingen.
 Forscher haben vier Jahre lang beobachtet, wie Schimpansenmütter mit ihrem Nachwuchs umgehen. Probleme wie bei Zootieren und Menschenkindern zeigten sich kaum. Die Wissenschaftler haben dafür eine simple Erklärung.
Forscher haben vier Jahre lang beobachtet, wie Schimpansenmütter mit ihrem Nachwuchs umgehen. Probleme wie bei Zootieren und Menschenkindern zeigten sich kaum. Die Wissenschaftler haben dafür eine simple Erklärung.
 Wie aus dem Nichts jemanden anrufen, eine drastische Story auftischen, Zeitdruck aufbauen: Schockanrufe sind unter Kriminellen populär. Ein Fall aus Regensburg zeigt, wie lukrativ die Masche sein kann.
Wie aus dem Nichts jemanden anrufen, eine drastische Story auftischen, Zeitdruck aufbauen: Schockanrufe sind unter Kriminellen populär. Ein Fall aus Regensburg zeigt, wie lukrativ die Masche sein kann.
 Reiche konsumieren mehr als andere, was Ressourcen verbraucht und dem Klima schadet. Erstmals haben Forscher diesen Einfluss nun berechnet.
Reiche konsumieren mehr als andere, was Ressourcen verbraucht und dem Klima schadet. Erstmals haben Forscher diesen Einfluss nun berechnet.
 Feinste Partikel aus dem Rauch von Waldbränden können sich tief in der Lunge festsetzen. Experten haben die Gesundheitsauswirkungen von durch den Klimawandel verursachten Bränden in den USA berechnet.
Feinste Partikel aus dem Rauch von Waldbränden können sich tief in der Lunge festsetzen. Experten haben die Gesundheitsauswirkungen von durch den Klimawandel verursachten Bränden in den USA berechnet.
 Forscher haben vier Jahre lang beobachtet, wie wild lebende Schimpansenmütter mit ihrem Nachwuchs umgehen. Probleme wie bei Zootieren oder Menschenkindern zeigten sich kaum. Die Wissenschaftler haben dafür eine simple Erklärung.
Forscher haben vier Jahre lang beobachtet, wie wild lebende Schimpansenmütter mit ihrem Nachwuchs umgehen. Probleme wie bei Zootieren oder Menschenkindern zeigten sich kaum. Die Wissenschaftler haben dafür eine simple Erklärung.
 Nadja Abd el Farrag stirbt mit nur 60 Jahren an Organversagen. Schon länger soll die Ex-Partnerin von Dieter Bohlen gesundheitliche Probleme gehabt haben. Unter anderem litt sie an Leberzirrhose. Ein Mediziner erklärt die dramatischen Folgen dieser Krankheit.
Nadja Abd el Farrag stirbt mit nur 60 Jahren an Organversagen. Schon länger soll die Ex-Partnerin von Dieter Bohlen gesundheitliche Probleme gehabt haben. Unter anderem litt sie an Leberzirrhose. Ein Mediziner erklärt die dramatischen Folgen dieser Krankheit.
 Sie jagen Wolken und trotzen der Eiseskälte der Antarktis: Für ihre Studien begeben sich Forschende häufig in Extremsituationen. Das Magazin »Nature« hat die sechs eindrucksvollsten Bilder gekürt.
Sie jagen Wolken und trotzen der Eiseskälte der Antarktis: Für ihre Studien begeben sich Forschende häufig in Extremsituationen. Das Magazin »Nature« hat die sechs eindrucksvollsten Bilder gekürt.
 Britische Wissenschaftler dokumentieren erstmals den Moment, in dem sich ein Herz bildet. Die einmaligen Zeitrafferaufnahmen zeigen, wie sich leuchtende Zellen in einem Mausembryo bewegen, teilen und formieren. Die Erkenntnisse könnten Herzfehler bei Babys früher erkennbar machen.
Britische Wissenschaftler dokumentieren erstmals den Moment, in dem sich ein Herz bildet. Die einmaligen Zeitrafferaufnahmen zeigen, wie sich leuchtende Zellen in einem Mausembryo bewegen, teilen und formieren. Die Erkenntnisse könnten Herzfehler bei Babys früher erkennbar machen.
 Den Flüssen fehlt Wasser, der Boden ist außergewöhnlich trocken, Waldstücke brennen – Fachleute zeigen sich beunruhigt über die anhaltende Dürre. Für die kommenden Monate deutet sich zudem eine bedrohliche Wetterlage an.
Den Flüssen fehlt Wasser, der Boden ist außergewöhnlich trocken, Waldstücke brennen – Fachleute zeigen sich beunruhigt über die anhaltende Dürre. Für die kommenden Monate deutet sich zudem eine bedrohliche Wetterlage an.
 Schaut man auf die größten Treiber von CO₂-Emissionen, Mobilität und Essen, finden sich deutliche Unterschiede zwischen den Geschlechtern. Die Gründe dafür könnten mit männlicher Identität zusammenhängen.
Schaut man auf die größten Treiber von CO₂-Emissionen, Mobilität und Essen, finden sich deutliche Unterschiede zwischen den Geschlechtern. Die Gründe dafür könnten mit männlicher Identität zusammenhängen.
 Kaum Regen, dafür viel Sonne und Hitze: Angesichts des Klimawandels haben es Bauern immer schwerer. Auch in diesem Frühling sind die Böden zu trocken - auf den erlösenden Niederschlag warten Landwirte vielerorts vergeblich. Eine mögliche Lösung: Künstliche Intelligenz auf dem Acker.
Kaum Regen, dafür viel Sonne und Hitze: Angesichts des Klimawandels haben es Bauern immer schwerer. Auch in diesem Frühling sind die Böden zu trocken - auf den erlösenden Niederschlag warten Landwirte vielerorts vergeblich. Eine mögliche Lösung: Künstliche Intelligenz auf dem Acker.
 Ein internationales Forscherteam dokumentiert ein überraschend menschliches Verhalten bei Schimpansen: Die Menschenaffen reinigen Hintern und Genitalien - und versorgen Wunden gezielt mit Heilpflanzen. Forscher sehen darin die evolutionären Wurzeln von Medizin und Gesundheitsfürsorge.
Ein internationales Forscherteam dokumentiert ein überraschend menschliches Verhalten bei Schimpansen: Die Menschenaffen reinigen Hintern und Genitalien - und versorgen Wunden gezielt mit Heilpflanzen. Forscher sehen darin die evolutionären Wurzeln von Medizin und Gesundheitsfürsorge.
 Die russische Regierung greift im Krieg gegen die Ukraine auch Ziele in Europa an. Nicht mit Raketen oder Bomben, sondern in Form von Hackerattacken. Jetzt haben Experten eine neue Kampagne aufgedeckt.
Die russische Regierung greift im Krieg gegen die Ukraine auch Ziele in Europa an. Nicht mit Raketen oder Bomben, sondern in Form von Hackerattacken. Jetzt haben Experten eine neue Kampagne aufgedeckt.
 Ein Dienstleister der Berliner Verkehrsbetriebe wurde gehackt. Zahlungsdaten haben die Täter nach bisherigen Erkenntnissen nicht erbeutet. Betroffene Kunden sollten aber auf Phishingversuche achtgeben.
Ein Dienstleister der Berliner Verkehrsbetriebe wurde gehackt. Zahlungsdaten haben die Täter nach bisherigen Erkenntnissen nicht erbeutet. Betroffene Kunden sollten aber auf Phishingversuche achtgeben.
 Der Expertenrat für Klimafragen legt seinen neuen Prüfbericht vor. Demnach wird ein Ziel erreicht, doch die Klimaneutralität 2045 ist in Gefahr. Die Experten üben Kritik an der neuen Merz-Regierung.
Der Expertenrat für Klimafragen legt seinen neuen Prüfbericht vor. Demnach wird ein Ziel erreicht, doch die Klimaneutralität 2045 ist in Gefahr. Die Experten üben Kritik an der neuen Merz-Regierung.
 Deutschland könnte seine Klimaziele für 2030 doch noch erreichen: Zu dem Ergebnis kommt ein Expertengremium der Bundesregierung. Hier sagt dessen Vorsitzender, was von Schwarz-Rot zu erwarten ist – und wie schlecht es um die Wälder steht.
Deutschland könnte seine Klimaziele für 2030 doch noch erreichen: Zu dem Ergebnis kommt ein Expertengremium der Bundesregierung. Hier sagt dessen Vorsitzender, was von Schwarz-Rot zu erwarten ist – und wie schlecht es um die Wälder steht.
 Große Trockenheit und hohe Temperaturen sind ein enormes Gesundheitsrisiko. Im Hochsommer fallen immer wieder viele Menschen der Hitze zum Opfer. Für das Vorjahr schätzt das RKI ihre Zahl auf 2800.
Große Trockenheit und hohe Temperaturen sind ein enormes Gesundheitsrisiko. Im Hochsommer fallen immer wieder viele Menschen der Hitze zum Opfer. Für das Vorjahr schätzt das RKI ihre Zahl auf 2800.
 Von der Erde aus sieht der Mond - abgesehen davon, dass er zu- und abnimmt - immer gleich aus. Doch die "Dark Side of the Moon" hat eine ganz andere Gestalt. Wie kommt das zustande? Die Ursache liegt im Inneren des Erdtrabanten, findet ein Forschungsteam heraus.
Von der Erde aus sieht der Mond - abgesehen davon, dass er zu- und abnimmt - immer gleich aus. Doch die "Dark Side of the Moon" hat eine ganz andere Gestalt. Wie kommt das zustande? Die Ursache liegt im Inneren des Erdtrabanten, findet ein Forschungsteam heraus.
 Seit Jahren drängen die USA auf eine Erhöhung der Verteidigungsausgaben der anderen Nato-Partner. Der Schlüssel zur Berechnung lässt viel Raum für Zahlen-Tricksereien.
Seit Jahren drängen die USA auf eine Erhöhung der Verteidigungsausgaben der anderen Nato-Partner. Der Schlüssel zur Berechnung lässt viel Raum für Zahlen-Tricksereien.
 Seinen Namen kennt kaum jemand, seine Entwicklungen schon: Richard Garwin hat die Wasserstoffbombe erschaffen. Später engagierte er sich für Rüstungskontrolle und erfand andere Dinge, wie eine Muschelwaschmaschine.
Seinen Namen kennt kaum jemand, seine Entwicklungen schon: Richard Garwin hat die Wasserstoffbombe erschaffen. Später engagierte er sich für Rüstungskontrolle und erfand andere Dinge, wie eine Muschelwaschmaschine.
 Ein richtiger Schritt zurück, mehrere kleine Schritte nach vorn: Der Sony WH-1000XM6 macht fast alles besser als der Vorgänger und ist damit ein heißer Anwärter auf den Titel des besten aktuellen Bluetooth-Kopfhörers. Für den Ohrenschmaus muss man allerdings tief in die Tasche greifen.
Ein richtiger Schritt zurück, mehrere kleine Schritte nach vorn: Der Sony WH-1000XM6 macht fast alles besser als der Vorgänger und ist damit ein heißer Anwärter auf den Titel des besten aktuellen Bluetooth-Kopfhörers. Für den Ohrenschmaus muss man allerdings tief in die Tasche greifen.
 Ein Baby aus den USA wird mit einer seltenen, lebensbedrohlichen Erbkrankheit geboren. Die Ärzte zögern nicht lange und entwickeln eine maßgeschneiderte Gentherapie - und die zeigt Wirkung: Der Zustand des Kindes verbessert sich. Die Technik hat enormes Potenzial, glauben Experten.
Ein Baby aus den USA wird mit einer seltenen, lebensbedrohlichen Erbkrankheit geboren. Die Ärzte zögern nicht lange und entwickeln eine maßgeschneiderte Gentherapie - und die zeigt Wirkung: Der Zustand des Kindes verbessert sich. Die Technik hat enormes Potenzial, glauben Experten.
 Asien ist der wichtigste Produktionsstandort für Apple. Die US-Regierung drängt den Konzern, iPhones in den USA zu bauen. Jetzt hat Präsident Trump über ein Gespräch mit dem Apple-Chef geplaudert.
Asien ist der wichtigste Produktionsstandort für Apple. Die US-Regierung drängt den Konzern, iPhones in den USA zu bauen. Jetzt hat Präsident Trump über ein Gespräch mit dem Apple-Chef geplaudert.
 Die Trockenheit infolge des Klimawandels hat ihr Gutes: Die Brut von Mücken hat es schwerer, zu überleben. Daher schwirrt es im Frühjahr bislang wenig. Im Sommer kann sich das aber ändern, sagen Experten. Besondere Sorge bereitet die expansive Asiatische Tigermücke.
Die Trockenheit infolge des Klimawandels hat ihr Gutes: Die Brut von Mücken hat es schwerer, zu überleben. Daher schwirrt es im Frühjahr bislang wenig. Im Sommer kann sich das aber ändern, sagen Experten. Besondere Sorge bereitet die expansive Asiatische Tigermücke.
 Die Kontaktliste im Handy ersetzt das Wählen. Folglich haben immer weniger Deutsche ihre eigene Mobilnummer spontan parat. Andere Nummern schneiden in einer aktuellen Umfrage besser ab.
Die Kontaktliste im Handy ersetzt das Wählen. Folglich haben immer weniger Deutsche ihre eigene Mobilnummer spontan parat. Andere Nummern schneiden in einer aktuellen Umfrage besser ab.
 Bei der führenden US-Kryptobörse Coinbase sind zahlreiche Kundendaten entwendet worden. Die Erpresser fordern 20 Millionen Dollar. Firmenchef Armstrong dreht den Spieß um und setzt die gleiche Summe für ihre Ergreifung aus.
Bei der führenden US-Kryptobörse Coinbase sind zahlreiche Kundendaten entwendet worden. Die Erpresser fordern 20 Millionen Dollar. Firmenchef Armstrong dreht den Spieß um und setzt die gleiche Summe für ihre Ergreifung aus.
 Ob und wie der vielleicht erste Vogel Archaeopteryx flog, war lange umstritten. Zuletzt verdichten sich die Indizien für seine Flugfähigkeit - ein Forschungsteam aus den USA liefert nun einen weiteren Beleg: Es handelt sich um spezielle Federn, ohne die es der Urvogel wohl schwer gehabt hätte, abzuheben.
Ob und wie der vielleicht erste Vogel Archaeopteryx flog, war lange umstritten. Zuletzt verdichten sich die Indizien für seine Flugfähigkeit - ein Forschungsteam aus den USA liefert nun einen weiteren Beleg: Es handelt sich um spezielle Federn, ohne die es der Urvogel wohl schwer gehabt hätte, abzuheben.
 Eine Fläche so groß wie Mallorca – innerhalb eines Jahres gerodet, kahl, verloren. Und das allein im Amazonasgebiet, dem grünen Herzen der Erde. Doch es gibt Hoffnung: Die Abholzung in Brasilien geht 2024 deutlich zurück. Naturschützer nennen die Ursachen.
Eine Fläche so groß wie Mallorca – innerhalb eines Jahres gerodet, kahl, verloren. Und das allein im Amazonasgebiet, dem grünen Herzen der Erde. Doch es gibt Hoffnung: Die Abholzung in Brasilien geht 2024 deutlich zurück. Naturschützer nennen die Ursachen.
 Seit Monaten hat es in Deutschland kaum geregnet. Die Böden trocknen zunehmend aus. Ohne einen deutlichen Wetterwechsel könnte die aktuelle Trockenphase sogar einen historischen Negativrekord von 1893 pulverisieren.
Seit Monaten hat es in Deutschland kaum geregnet. Die Böden trocknen zunehmend aus. Ohne einen deutlichen Wetterwechsel könnte die aktuelle Trockenphase sogar einen historischen Negativrekord von 1893 pulverisieren.
 Bei einem Toilettengang des Flugkapitäns wurde der Co-Pilot einer Lufthansa-Maschine bewusstlos. Minutenlang flog der Airbus A321 mit 199 Fluggästen an Bord führerlos über Spanien. Der Fall dürfte eine Diskussion wiederbeleben.
Bei einem Toilettengang des Flugkapitäns wurde der Co-Pilot einer Lufthansa-Maschine bewusstlos. Minutenlang flog der Airbus A321 mit 199 Fluggästen an Bord führerlos über Spanien. Der Fall dürfte eine Diskussion wiederbeleben.
 Stiftung Warentest prüft 16 aktuelle Akku-Bohrschrauber, 13 davon mit Schlagfunktion. Es stellt sich heraus, dass ein hoher Preis nicht unbedingt für hohe Qualität steht und umgekehrt. Der Preis-Leistungs-Sieger ist das zweitbeste Gerät, die Nummer 1 auch ein eher günstiges Werkzeug.
Stiftung Warentest prüft 16 aktuelle Akku-Bohrschrauber, 13 davon mit Schlagfunktion. Es stellt sich heraus, dass ein hoher Preis nicht unbedingt für hohe Qualität steht und umgekehrt. Der Preis-Leistungs-Sieger ist das zweitbeste Gerät, die Nummer 1 auch ein eher günstiges Werkzeug.
 Schon wenige Tausend Follower reichen, um Anfragen für Werbekooperationen in sozialen Medien zu bekommen. Für die Firmen lohnt sich das aber oft mehr als für die Content-Creator.
Schon wenige Tausend Follower reichen, um Anfragen für Werbekooperationen in sozialen Medien zu bekommen. Für die Firmen lohnt sich das aber oft mehr als für die Content-Creator.
 Die Zahl der Menschen, die den Umweltschutz als "sehr wichtig" ansehen, geht einer Umfrage zufolge immer weiter zurück. Auch der Optimismus der Deutschen im Kampf gegen den Klimawandel schwindet. Die Folgen sind bereits jetzt deutlich spürbar.
Die Zahl der Menschen, die den Umweltschutz als "sehr wichtig" ansehen, geht einer Umfrage zufolge immer weiter zurück. Auch der Optimismus der Deutschen im Kampf gegen den Klimawandel schwindet. Die Folgen sind bereits jetzt deutlich spürbar.
 Die Schweinswal-Population vor der deutschen Ostseeküste schrumpft drastisch. Stellnetze, Lärm, Klimawandel: Viele Gründe für den Rückgang haben Menschen zu verantworten.
Die Schweinswal-Population vor der deutschen Ostseeküste schrumpft drastisch. Stellnetze, Lärm, Klimawandel: Viele Gründe für den Rückgang haben Menschen zu verantworten.
 Das Ende der Kupferkabel-Anschlüsse ist zwar beschlossene Sache, wird sich faktisch aber noch über Jahre hinziehen. Trotzdem kann man schon jetzt Schnäppchen für die Zeit danach finden.
Das Ende der Kupferkabel-Anschlüsse ist zwar beschlossene Sache, wird sich faktisch aber noch über Jahre hinziehen. Trotzdem kann man schon jetzt Schnäppchen für die Zeit danach finden.
 Die Zahl der Schweinswale in der deutschen Ostsee geht stark zurück. Schuld sind verschiedene Faktoren wie die Fischerei, Lärm und der Klimawandel. Gegen die Ursachen ließe sich durchaus vorgehen.
Die Zahl der Schweinswale in der deutschen Ostsee geht stark zurück. Schuld sind verschiedene Faktoren wie die Fischerei, Lärm und der Klimawandel. Gegen die Ursachen ließe sich durchaus vorgehen.
 Robert F. Kennedy will Amerika gesünder machen. Aber er stoppt Forschungsvorhaben, entlässt Zehntausende Mitarbeiter und hinterfragt Impfungen. Experten fürchten, die Menschen könnten durch ihn am Ende kränker werden.
Robert F. Kennedy will Amerika gesünder machen. Aber er stoppt Forschungsvorhaben, entlässt Zehntausende Mitarbeiter und hinterfragt Impfungen. Experten fürchten, die Menschen könnten durch ihn am Ende kränker werden.
 Der Streit zwischen Apple und der Spielefirma Epic ist erneut eskaliert. Weil Epic sein beliebtes Spiel »Fortnite« in Apples US-Store nicht mehr anbieten darf, verschwindet es auch in der EU – zum wiederholten Mal.
Der Streit zwischen Apple und der Spielefirma Epic ist erneut eskaliert. Weil Epic sein beliebtes Spiel »Fortnite« in Apples US-Store nicht mehr anbieten darf, verschwindet es auch in der EU – zum wiederholten Mal.
 Migräne ist weit mehr als "nur" Kopfschmerz und quält Betroffene sehr: Bereits Tage bis Stunden vor einer Attacke klagen viele über teils schwere Symptome. Ein in den USA zugelassenes Präparat kann diese Beschwerden lindern. Ein deutscher Experte spricht sogar von einem Paradigmenwechsel.
Migräne ist weit mehr als "nur" Kopfschmerz und quält Betroffene sehr: Bereits Tage bis Stunden vor einer Attacke klagen viele über teils schwere Symptome. Ein in den USA zugelassenes Präparat kann diese Beschwerden lindern. Ein deutscher Experte spricht sogar von einem Paradigmenwechsel.
 Er sei vom Auslandsgeheimdienst gebeten worden, »konservative Stimmen« vor der Wahl in Rumänien zu unterdrücken, behauptet Telegram-CEO Pawel Durow. Die Franzosen weisen den Vorwurf kategorisch zurück.
Er sei vom Auslandsgeheimdienst gebeten worden, »konservative Stimmen« vor der Wahl in Rumänien zu unterdrücken, behauptet Telegram-CEO Pawel Durow. Die Franzosen weisen den Vorwurf kategorisch zurück.
 Dass Glühwürmchen leuchten können, war bekannt - aber auch die Zellen aller anderer Lebewesen senden geringe Mengen an Lichtteilchen aus, bestätigt eine Studie. Diese Aura erlischt erst mit dem Tod. Wie das Licht genau entsteht, ist jedoch noch ein Rätsel.
Dass Glühwürmchen leuchten können, war bekannt - aber auch die Zellen aller anderer Lebewesen senden geringe Mengen an Lichtteilchen aus, bestätigt eine Studie. Diese Aura erlischt erst mit dem Tod. Wie das Licht genau entsteht, ist jedoch noch ein Rätsel.
 Joe Biden hat Prostatakrebs - dazu noch eine "aggressive Form". Was bedeutet diese Diagnose für den ehemaligen US-Präsidenten? Welche Behandlungsmöglichkeiten gibt es? Und wie sind die Überlebenschancen? Die wichtigsten Fragen und Antworten.
Joe Biden hat Prostatakrebs - dazu noch eine "aggressive Form". Was bedeutet diese Diagnose für den ehemaligen US-Präsidenten? Welche Behandlungsmöglichkeiten gibt es? Und wie sind die Überlebenschancen? Die wichtigsten Fragen und Antworten.
 Dass Glühwürmchen leuchten können, war bekannt - aber auch die Zellen aller anderen Lebewesen senden geringe Mengen an Lichtteilchen aus, bestätigt eine Studie. Diese Aura erlischt erst mit dem Tod. Wie das Licht genau entsteht, ist jedoch noch ein Rätsel.
Dass Glühwürmchen leuchten können, war bekannt - aber auch die Zellen aller anderen Lebewesen senden geringe Mengen an Lichtteilchen aus, bestätigt eine Studie. Diese Aura erlischt erst mit dem Tod. Wie das Licht genau entsteht, ist jedoch noch ein Rätsel.
 Die Diagnose von Alzheimer ist bislang aufwendig und teuer. Die USA wollen das nun ändern - und stellen Patienten erstmals einen Bluttest zur Verfügung, der die neurodegenerative Erkrankung frühzeitig erkennt. Experten sprechen von einem "wichtigen Fortschritt".
Die Diagnose von Alzheimer ist bislang aufwendig und teuer. Die USA wollen das nun ändern - und stellen Patienten erstmals einen Bluttest zur Verfügung, der die neurodegenerative Erkrankung frühzeitig erkennt. Experten sprechen von einem "wichtigen Fortschritt".
 Transplantationen von Herz, Niere oder Leber sind in der Medizin gängig. Nun konnte ein US-Ärzteteam einem Patienten erstmals eine neue Blase einpflanzen. Zum Standardeingriff wird die OP jedoch wahrscheinlich nicht.
Transplantationen von Herz, Niere oder Leber sind in der Medizin gängig. Nun konnte ein US-Ärzteteam einem Patienten erstmals eine neue Blase einpflanzen. Zum Standardeingriff wird die OP jedoch wahrscheinlich nicht.
 Trotz des sehr ähnlichen Designs ist die Huawei Watch Fit 4 Pro keine echte Alternative zur Apple Watch Pro. Aber wer einen präzisen, äußerst ausdauernden, robusten und vielseitigen Fitnesstracker sucht, wird von der Uhr bestens bedient.
Trotz des sehr ähnlichen Designs ist die Huawei Watch Fit 4 Pro keine echte Alternative zur Apple Watch Pro. Aber wer einen präzisen, äußerst ausdauernden, robusten und vielseitigen Fitnesstracker sucht, wird von der Uhr bestens bedient.
 Trotz des sehr ähnlichen Designs ist die Huawei Watch Fit 4 Pro keine echte Alternative zur Apple Watch Ultra. Aber wer einen präzisen, äußerst ausdauernden, robusten und vielseitigen Fitnesstracker sucht, wird von der Uhr bestens bedient.
Trotz des sehr ähnlichen Designs ist die Huawei Watch Fit 4 Pro keine echte Alternative zur Apple Watch Ultra. Aber wer einen präzisen, äußerst ausdauernden, robusten und vielseitigen Fitnesstracker sucht, wird von der Uhr bestens bedient.
 Nach den erfolgreichen Rover-Fahrten auf dem Mars und Mond plant China den Start der Sonde Tianwen-2 zur Rückholung von Proben eines Asteroiden. Die Mission soll Erkenntnisse über die Ursprünge des Sonnensystems liefern.
Nach den erfolgreichen Rover-Fahrten auf dem Mars und Mond plant China den Start der Sonde Tianwen-2 zur Rückholung von Proben eines Asteroiden. Die Mission soll Erkenntnisse über die Ursprünge des Sonnensystems liefern.
 Millionen Tote, Lockdowns, Lieferengpässe: Das Chaos der Coronapandemie soll sich möglichst nicht wiederholen. Die Weltgesundheitsorganisation hat deshalb einen Pandemievertrag beschlossen. Das steht drin.
Millionen Tote, Lockdowns, Lieferengpässe: Das Chaos der Coronapandemie soll sich möglichst nicht wiederholen. Die Weltgesundheitsorganisation hat deshalb einen Pandemievertrag beschlossen. Das steht drin.
 Transplantationen von Herz, Niere oder Leber sind seit vielen Jahren gängige Praxis. Blasen waren bisher nicht dabei. Ein US-Ärzteteam betritt nun Neuland und verpflanzt das erste Mal eine Blase bei einem lebenden Patienten. Allerdings gibt es erhebliche Zweifel, ob sich das in Zukunft durchsetzen wird.
Transplantationen von Herz, Niere oder Leber sind seit vielen Jahren gängige Praxis. Blasen waren bisher nicht dabei. Ein US-Ärzteteam betritt nun Neuland und verpflanzt das erste Mal eine Blase bei einem lebenden Patienten. Allerdings gibt es erhebliche Zweifel, ob sich das in Zukunft durchsetzen wird.
 Wieso fuhr das mexikanische Segelschulschiff Cuauhtémoc scheinbar unkontrolliert gegen die Brooklyn Bridge? Gerald Immens ist Lotse und Kapitän, seiner Einschätzung nach könnten die Verantwortlichen zwei folgenreiche Fehler begangen haben.
Wieso fuhr das mexikanische Segelschulschiff Cuauhtémoc scheinbar unkontrolliert gegen die Brooklyn Bridge? Gerald Immens ist Lotse und Kapitän, seiner Einschätzung nach könnten die Verantwortlichen zwei folgenreiche Fehler begangen haben.
 Wenn die jüngsten Gerüchte zutreffend sind, wird das kommende "iPhone 17 Air" noch dünner als das kürzlich vorgestellte Samsung Galaxy S25 Edge sein. Apple erkauft sich die superschlanke Taille angeblich mit einem fast schon winzigen Akku, aber das Gerät soll trotzdem alltagstauglich sein
Wenn die jüngsten Gerüchte zutreffend sind, wird das kommende "iPhone 17 Air" noch dünner als das kürzlich vorgestellte Samsung Galaxy S25 Edge sein. Apple erkauft sich die superschlanke Taille angeblich mit einem fast schon winzigen Akku, aber das Gerät soll trotzdem alltagstauglich sein
 Von der Erde aus sieht der Mond - abgesehen davon, dass er zu- und abnimmt - immer gleich aus. Doch die "Dark Side of the Moon" hat eine ganz andere Gestalt. Wie kommt das zustande? Die Ursache liegt im Inneren des Erdtrabanten, findet ein Forschungsteam heraus.
Von der Erde aus sieht der Mond - abgesehen davon, dass er zu- und abnimmt - immer gleich aus. Doch die "Dark Side of the Moon" hat eine ganz andere Gestalt. Wie kommt das zustande? Die Ursache liegt im Inneren des Erdtrabanten, findet ein Forschungsteam heraus.
 Im Garten, auf dem Balkon oder dem Fenstersims: Tauben treiben viele Eigentümer und Mieter in den Wahnsinn. Dabei gibt es einfache Mittel und Wege, die Tiere zu vertreiben.
Im Garten, auf dem Balkon oder dem Fenstersims: Tauben treiben viele Eigentümer und Mieter in den Wahnsinn. Dabei gibt es einfache Mittel und Wege, die Tiere zu vertreiben.
 Forschende haben ein 500 Meter tiefes Loch ins Eis der Westantarktis gebohrt. Unter einem Gletscher stießen sie auf einen gewaltigen Fluss und auf Lebewesen, die in ewiger Dunkelheit zu Hause sind.
Forschende haben ein 500 Meter tiefes Loch ins Eis der Westantarktis gebohrt. Unter einem Gletscher stießen sie auf einen gewaltigen Fluss und auf Lebewesen, die in ewiger Dunkelheit zu Hause sind.
 Das Schmelzen der Polkappen lässt den Meeresspiegel steigen – eine Erhöhung von mehreren Metern ist mit der jetzigen Erwärmung wohl nicht mehr zu verhindern. Forscher reagieren mit einer deutlichen Warnung.
Das Schmelzen der Polkappen lässt den Meeresspiegel steigen – eine Erhöhung von mehreren Metern ist mit der jetzigen Erwärmung wohl nicht mehr zu verhindern. Forscher reagieren mit einer deutlichen Warnung.
 Westliche Geheimdienste warnen gemeinsam vor Angriffen mutmaßlich russischer Staatshacker auf westliche Logistik- und Technologiefirmen. Wer die Ukraine unterstützt, solle davon ausgehen, »im Zielspektrum zu sein«.
Westliche Geheimdienste warnen gemeinsam vor Angriffen mutmaßlich russischer Staatshacker auf westliche Logistik- und Technologiefirmen. Wer die Ukraine unterstützt, solle davon ausgehen, »im Zielspektrum zu sein«.
 Rund zwei Jahrzehnte lang beherrscht Google die Internet-Suche fast wie ein Monopolist, doch immer mehr Menschen nutzen inzwischen die Künstliche Intelligenz von Perplexity oder ChatGPT, die nicht nur schlichte Trefferlisten bieten. Jetzt hält der US-Gigant mit einem eigenen KI-Modus dagegen.
Rund zwei Jahrzehnte lang beherrscht Google die Internet-Suche fast wie ein Monopolist, doch immer mehr Menschen nutzen inzwischen die Künstliche Intelligenz von Perplexity oder ChatGPT, die nicht nur schlichte Trefferlisten bieten. Jetzt hält der US-Gigant mit einem eigenen KI-Modus dagegen.
 Experten warnen vor der massiven Vernichtung des Tropenurwalds. Das Ausmaß der Zerstörung ist einem Bericht zufolge so groß wie lange nicht. Oft hat das mit Bränden zu tun. Und mit der Produktion bestimmter Lebensmittel.
Experten warnen vor der massiven Vernichtung des Tropenurwalds. Das Ausmaß der Zerstörung ist einem Bericht zufolge so groß wie lange nicht. Oft hat das mit Bränden zu tun. Und mit der Produktion bestimmter Lebensmittel.
 Gibt es einen Schutz vor Atomraketen? Die USA wollen es versuchen: Golden Dome heißt das von US-Präsident Trump gestartete Projekt, in dem der Weltraum eine wichtige Rolle spielen soll. Bisher sind nur wenige Details bekannt. Doch Planspiele dazu gibt es schon länger.
Gibt es einen Schutz vor Atomraketen? Die USA wollen es versuchen: Golden Dome heißt das von US-Präsident Trump gestartete Projekt, in dem der Weltraum eine wichtige Rolle spielen soll. Bisher sind nur wenige Details bekannt. Doch Planspiele dazu gibt es schon länger.
 Das vielleicht teuerste US-Projekt seit den Mondflügen und der Entwicklung der Atombombe: Donald Trump treibt Pläne für den Golden Dome voran. Wie effektiv das System sein kann, ist völlig offen. Ein Kritiker spricht von einem »Witz«.
Das vielleicht teuerste US-Projekt seit den Mondflügen und der Entwicklung der Atombombe: Donald Trump treibt Pläne für den Golden Dome voran. Wie effektiv das System sein kann, ist völlig offen. Ein Kritiker spricht von einem »Witz«.
 Jony Ive hat einst das iPhone designt, jetzt will er für den ChatGPT-Entwickler OpenAI neue KI-Geräte entwerfen: Über Details ist noch nichts bekannt. Aber der Chef ist schon voll des Lobes.
Jony Ive hat einst das iPhone designt, jetzt will er für den ChatGPT-Entwickler OpenAI neue KI-Geräte entwerfen: Über Details ist noch nichts bekannt. Aber der Chef ist schon voll des Lobes.
 Die Kontaktliste im Handy ersetzt das Wählen. Folglich haben immer weniger Deutsche ihre eigene Mobilnummer spontan parat. Andere Nummern schneiden in einer aktuellen Umfrage besser ab.
Die Kontaktliste im Handy ersetzt das Wählen. Folglich haben immer weniger Deutsche ihre eigene Mobilnummer spontan parat. Andere Nummern schneiden in einer aktuellen Umfrage besser ab.
 Der merkwürdig aussehende Trend geistert seit einiger Zeit durch die sozialen Medien: Menschen kleben sich beim Schlafen den Mund zu. Das soll unter anderem gegen Schnarchen, Mundgeruch und Konzentrationsprobleme helfen. Ein Forschungsteam hat das überprüft - und warnt vor "ernsthaften Gesundheitsgefahren".
Der merkwürdig aussehende Trend geistert seit einiger Zeit durch die sozialen Medien: Menschen kleben sich beim Schlafen den Mund zu. Das soll unter anderem gegen Schnarchen, Mundgeruch und Konzentrationsprobleme helfen. Ein Forschungsteam hat das überprüft - und warnt vor "ernsthaften Gesundheitsgefahren".
 Rund 20 Prozent schwerer ist das Gehirn asiatischer Elefanten im Vergleich zu ihren Verwandten. Das fanden Forscher heraus, indem sie die Gehirne toter Elefanten entnahmen. Das Plus an Hirnmasse hat Folgen.
Rund 20 Prozent schwerer ist das Gehirn asiatischer Elefanten im Vergleich zu ihren Verwandten. Das fanden Forscher heraus, indem sie die Gehirne toter Elefanten entnahmen. Das Plus an Hirnmasse hat Folgen.
 Der merkwürdig aussehende Trend geistert seit einiger Zeit durch die sozialen Medien: Menschen kleben sich beim Schlafen den Mund zu. Das "Mouth Taping" soll unter anderem gegen Schnarchen, Mundgeruch und Konzentrationsprobleme helfen. Ein Forschungsteam hat das überprüft - und warnt vor "ernsthaften Gesundheitsgefahren".
Der merkwürdig aussehende Trend geistert seit einiger Zeit durch die sozialen Medien: Menschen kleben sich beim Schlafen den Mund zu. Das "Mouth Taping" soll unter anderem gegen Schnarchen, Mundgeruch und Konzentrationsprobleme helfen. Ein Forschungsteam hat das überprüft - und warnt vor "ernsthaften Gesundheitsgefahren".
 Häufigere Hitzewellen werden für Meereslebewesen zunehmend zur Gefahr. Clownfische schützen sich offenbar, indem sie kürzer werden. Das hat Einfluss auf ihre Partner und die anderen Fische ihrer Gruppe.
Häufigere Hitzewellen werden für Meereslebewesen zunehmend zur Gefahr. Clownfische schützen sich offenbar, indem sie kürzer werden. Das hat Einfluss auf ihre Partner und die anderen Fische ihrer Gruppe.
 Forscher entdecken bei Clownfischen vor Papua-Neuguinea eine erstaunliche Entwicklung: Wenn das Wasser während Hitzewellen zu warm wird, schrumpfen die Tiere. Aber nicht nur die Umweltbedingungen spielen dabei offenbar eine Rolle, sondern auch die soziale Ordnung unter den Fischen.
Forscher entdecken bei Clownfischen vor Papua-Neuguinea eine erstaunliche Entwicklung: Wenn das Wasser während Hitzewellen zu warm wird, schrumpfen die Tiere. Aber nicht nur die Umweltbedingungen spielen dabei offenbar eine Rolle, sondern auch die soziale Ordnung unter den Fischen.
 Die Erde erwärmt sich, und das Meereis im Südpolarmeer schrumpft. Pinguinen setzt das arg zu, dabei wirken ihre Ausscheidungen der Schmelze wohl entgegen, zumindest ein bisschen.
Die Erde erwärmt sich, und das Meereis im Südpolarmeer schrumpft. Pinguinen setzt das arg zu, dabei wirken ihre Ausscheidungen der Schmelze wohl entgegen, zumindest ein bisschen.
 Menschen können nur einen bestimmten Wellenbereich des Lichts sehen. Mit Nanotechnologie haben Forscher nun eine Kontaktlinse entwickelt, die bisher unsichtbares Infrarotlicht sichtbar macht - sogar mit geschlossenen Augen. Auch für die praktische Anwendung gibt es bereits Ideen.
Menschen können nur einen bestimmten Wellenbereich des Lichts sehen. Mit Nanotechnologie haben Forscher nun eine Kontaktlinse entwickelt, die bisher unsichtbares Infrarotlicht sichtbar macht - sogar mit geschlossenen Augen. Auch für die praktische Anwendung gibt es bereits Ideen.
 Es klingt nach Science Fiction für den Alltag: Eine Kontaktlinse aus einem chinesischen Labor macht unsichtbares Licht sichtbar. Die Technik könnte künftig auch farbenblinden Menschen helfen.
Es klingt nach Science Fiction für den Alltag: Eine Kontaktlinse aus einem chinesischen Labor macht unsichtbares Licht sichtbar. Die Technik könnte künftig auch farbenblinden Menschen helfen.
 Axolotl sind Meister der Regeneration: Beißen Feinde ihnen ein Bein ab, wächst es einfach wieder nach. Die Voraussetzung dafür, sagt Biochemikerin Elly Tanaka, könnte auch im Erbgut von uns Menschen schlummern.
Axolotl sind Meister der Regeneration: Beißen Feinde ihnen ein Bein ab, wächst es einfach wieder nach. Die Voraussetzung dafür, sagt Biochemikerin Elly Tanaka, könnte auch im Erbgut von uns Menschen schlummern.
 Gerade noch Elite-Student, bald abgeschoben? Trump hat der Harvard-Universität verboten, internationale Studierende aufzunehmen. Als die Nachricht durchsickert, sind die Betroffenen geschockt – wollen aber kämpfen.
Gerade noch Elite-Student, bald abgeschoben? Trump hat der Harvard-Universität verboten, internationale Studierende aufzunehmen. Als die Nachricht durchsickert, sind die Betroffenen geschockt – wollen aber kämpfen.
 Kanye West singt »Heil Hitler«. Dennoch ist das Musikvideo mit Millionen Klicks weiterhin auf Instagram zu finden. Ist es dem Social-Media-Unternehmen egal oder liegt es an der Kunstfreiheit?
Kanye West singt »Heil Hitler«. Dennoch ist das Musikvideo mit Millionen Klicks weiterhin auf Instagram zu finden. Ist es dem Social-Media-Unternehmen egal oder liegt es an der Kunstfreiheit?
 Sieben Milliarden Euro geben die Deutschen für Tiernahrung und Zubehör aus. Während die Geburtenrate sinkt, leben Hunde in mehr als 20 Prozent der Haushalte. Forscher legen dar, dass es für die Halter da durchaus einen Zusammenhang gibt.
Sieben Milliarden Euro geben die Deutschen für Tiernahrung und Zubehör aus. Während die Geburtenrate sinkt, leben Hunde in mehr als 20 Prozent der Haushalte. Forscher legen dar, dass es für die Halter da durchaus einen Zusammenhang gibt.
 Ermittler aus sieben Ländern haben diese Woche die Infrastruktur der einflussreichsten Schadsoftware-Varianten abgeschaltet. Bei der »Operation Endgame 2.0« führen viele Spuren nach Russland.
Ermittler aus sieben Ländern haben diese Woche die Infrastruktur der einflussreichsten Schadsoftware-Varianten abgeschaltet. Bei der »Operation Endgame 2.0« führen viele Spuren nach Russland.
 Wiener Wissenschaftler entdecken den genetischen Code hinter dem Heilungswunder des Schwanzlurchs Axolotl. Dieselben Gene kommen auch beim Menschen vor: Wird die Medizin eines Tages in der Lage sein, verletzte Gliedmaßen nachwachsen zu lassen?
Wiener Wissenschaftler entdecken den genetischen Code hinter dem Heilungswunder des Schwanzlurchs Axolotl. Dieselben Gene kommen auch beim Menschen vor: Wird die Medizin eines Tages in der Lage sein, verletzte Gliedmaßen nachwachsen zu lassen?
 Die angebliche Wiederauferstehung des Schattenwolfs hat für große Aufregung gesorgt. Nun sagt die Forscherin hinter dem Projekt, die Tiere seien »geklonte Grauwölfe mit 20 Änderungen.« Und will nie etwas anderes gesagt haben.
Die angebliche Wiederauferstehung des Schattenwolfs hat für große Aufregung gesorgt. Nun sagt die Forscherin hinter dem Projekt, die Tiere seien »geklonte Grauwölfe mit 20 Änderungen.« Und will nie etwas anderes gesagt haben.
 Das Oberlandesgericht Köln hat entschieden, dass Meta Beiträge von Nutzerinnen und Nutzern für das Training seiner KI verwenden darf. Die Verbraucherzentrale NRW hatte gegen die Pläne des Facebook-Mutterkonzerns geklagt.
Das Oberlandesgericht Köln hat entschieden, dass Meta Beiträge von Nutzerinnen und Nutzern für das Training seiner KI verwenden darf. Die Verbraucherzentrale NRW hatte gegen die Pläne des Facebook-Mutterkonzerns geklagt.
 Die Harvard-Universität geht juristisch gegen das Verbot vor, ausländische Studenten aufzunehmen. Die Ivy-League-Uni bezeichnete die Maßnahme des US-Präsidenten als verfassungswidrige Vergeltungsmaßnahme.
Die Harvard-Universität geht juristisch gegen das Verbot vor, ausländische Studenten aufzunehmen. Die Ivy-League-Uni bezeichnete die Maßnahme des US-Präsidenten als verfassungswidrige Vergeltungsmaßnahme.
 Bessere Aufklärung aus dem Weltall - das will die Bundeswehr mit dem Projekt SARah erreichen. Ende 2023 sind alle drei Satelliten im All. Doch bei zwei von dreien müssen Antennen ausgefahren werden - und das klappt nicht. Das Projekt steht auf der Kippe - bis jetzt.
Bessere Aufklärung aus dem Weltall - das will die Bundeswehr mit dem Projekt SARah erreichen. Ende 2023 sind alle drei Satelliten im All. Doch bei zwei von dreien müssen Antennen ausgefahren werden - und das klappt nicht. Das Projekt steht auf der Kippe - bis jetzt.
 Wozu eine KI im Extremfall fähig wäre, testen Entwickler routinemäßig vor der Veröffentlichung. Sogenannte Red Teams lassen sich dafür wilde Szenarien einfallen – so wie jetzt bei Anthropic. Was man dazu wissen muss.
Wozu eine KI im Extremfall fähig wäre, testen Entwickler routinemäßig vor der Veröffentlichung. Sogenannte Red Teams lassen sich dafür wilde Szenarien einfallen – so wie jetzt bei Anthropic. Was man dazu wissen muss.
 Die US-Regierung setzt Harvard massiv unter Druck. SPIEGEL-Korrespondent Claus Hecking berichtet über Forschende, die das Land verlassen wollen. Können die Eliteunis den Braindrain verhindern?
Die US-Regierung setzt Harvard massiv unter Druck. SPIEGEL-Korrespondent Claus Hecking berichtet über Forschende, die das Land verlassen wollen. Können die Eliteunis den Braindrain verhindern?
 Die US-Regierung setzt Harvard und Co. massiv unter Druck. SPIEGEL-Korrespondent Claus Hecking berichtet über Forschende, die das Land verlassen wollen. Können die Eliteunis den Braindrain verhindern?
Die US-Regierung setzt Harvard und Co. massiv unter Druck. SPIEGEL-Korrespondent Claus Hecking berichtet über Forschende, die das Land verlassen wollen. Können die Eliteunis den Braindrain verhindern?
 Microsoft beendet im Oktober die Unterstützung von Windows 10. Computer, deren Hardware nicht für ein Upgrade auf Windows 11 geeignet sind, werden dann zu einem Sicherheitsproblem. Eine einfache, effektive und kostenlose Lösung ist der Wechsel zu Linux, wobei man erst mal zweigleisig fahren kann.
Microsoft beendet im Oktober die Unterstützung von Windows 10. Computer, deren Hardware nicht für ein Upgrade auf Windows 11 geeignet sind, werden dann zu einem Sicherheitsproblem. Eine einfache, effektive und kostenlose Lösung ist der Wechsel zu Linux, wobei man erst mal zweigleisig fahren kann.
 Historischer Fund in den peruanischen Anden: Forscher haben mithilfe von Lasertechnik eine Vielzahl archäologischer Strukturen identifiziert. Der Fund könnte ein Meilenstein im Verständnis der indigenen Kultur sein.
Historischer Fund in den peruanischen Anden: Forscher haben mithilfe von Lasertechnik eine Vielzahl archäologischer Strukturen identifiziert. Der Fund könnte ein Meilenstein im Verständnis der indigenen Kultur sein.
 Der Streit zwischen Apple und der Spielefirma Epic ist erneut eskaliert. Weil Epic sein beliebtes Spiel »Fortnite« in Apples US-Store nicht mehr anbieten darf, verschwindet es auch in der EU – zum wiederholten Mal.
Der Streit zwischen Apple und der Spielefirma Epic ist erneut eskaliert. Weil Epic sein beliebtes Spiel »Fortnite« in Apples US-Store nicht mehr anbieten darf, verschwindet es auch in der EU – zum wiederholten Mal.
 Die Zahl der Schweinswale in der deutschen Ostsee geht stark zurück. Schuld sind verschiedene Faktoren wie die Fischerei, Lärm und der Klimawandel. Gegen die Ursachen ließe sich durchaus vorgehen.
Die Zahl der Schweinswale in der deutschen Ostsee geht stark zurück. Schuld sind verschiedene Faktoren wie die Fischerei, Lärm und der Klimawandel. Gegen die Ursachen ließe sich durchaus vorgehen.
 Erfolg für Harvard vor Gericht: Eine Bundesrichterin hat der Eliteuniversität recht gegeben und das Vorhaben der US-Regierung, ausländische Studierende auszuschließen, vorerst gestoppt.
Erfolg für Harvard vor Gericht: Eine Bundesrichterin hat der Eliteuniversität recht gegeben und das Vorhaben der US-Regierung, ausländische Studierende auszuschließen, vorerst gestoppt.
 Die US-Regierung will der Harvard-Universität verbieten, ausländische Studierende aufzunehmen. Hier schildern vier deutsche Kommilitonen, was das für ihr Leben bedeutet und warum sie trotzdem Hoffnung haben.
Die US-Regierung will der Harvard-Universität verbieten, ausländische Studierende aufzunehmen. Hier schildern vier deutsche Kommilitonen, was das für ihr Leben bedeutet und warum sie trotzdem Hoffnung haben.
 Seit Beginn des 20. Jahrhunderts wurde ein stetiger Zuwachs bei der Intelligenz der Menschen gemessen - bis Forschende in den 2010er Jahren eine Umkehr des Trends beschrieben. Wird die Menschheit wieder dümmer? Ein Psychologe erklärt ntv.de, ob etwas dran ist.
Seit Beginn des 20. Jahrhunderts wurde ein stetiger Zuwachs bei der Intelligenz der Menschen gemessen - bis Forschende in den 2010er Jahren eine Umkehr des Trends beschrieben. Wird die Menschheit wieder dümmer? Ein Psychologe erklärt ntv.de, ob etwas dran ist.
 In Island stehen die größten Anlagen, die CO₂ wieder aus der Luft holen. Doch laut einem Bericht stößt der Betrieb netto noch immer Treibhausgase aus. Die Skepsis gegenüber der Technik wächst.
In Island stehen die größten Anlagen, die CO₂ wieder aus der Luft holen. Doch laut einem Bericht stößt der Betrieb netto noch immer Treibhausgase aus. Die Skepsis gegenüber der Technik wächst.
 Die Plattform X von Milliardär Elon Musk hat einmal mehr mit technischen Problemen zu kämpfen, und das offenbar weltweit. Noch sind die Hintergründe unklar. Unlängst hatte es in einem Datencenter in den USA einen Brand gegeben.
Die Plattform X von Milliardär Elon Musk hat einmal mehr mit technischen Problemen zu kämpfen, und das offenbar weltweit. Noch sind die Hintergründe unklar. Unlängst hatte es in einem Datencenter in den USA einen Brand gegeben.
 Nutzer auf der ganzen Welt meldeten am Samstag eine Störung beim Kurznachrichtendienst X – am Nachmittag war das Netzwerk nach kurzer Zeit wieder erreichbar.Es ist nicht der erste Ausfall der Plattform in der jüngeren Vergangenheit.
Nutzer auf der ganzen Welt meldeten am Samstag eine Störung beim Kurznachrichtendienst X – am Nachmittag war das Netzwerk nach kurzer Zeit wieder erreichbar.Es ist nicht der erste Ausfall der Plattform in der jüngeren Vergangenheit.
 Der Bundesgerichtshof hat entschieden, wann die Polizei auch ohne Richterbeschluss zu Zwangsmaßnahmen greifen darf, um biometrisch gesicherte Geräte zu entsperren. Bürgerrechtler sehen darin einen Eingriff in die Grundrechte.
Der Bundesgerichtshof hat entschieden, wann die Polizei auch ohne Richterbeschluss zu Zwangsmaßnahmen greifen darf, um biometrisch gesicherte Geräte zu entsperren. Bürgerrechtler sehen darin einen Eingriff in die Grundrechte.
 Er sei vom Auslandsgeheimdienst gebeten worden, »konservative Stimmen« vor der Wahl in Rumänien zu unterdrücken, behauptet Telegram-CEO Pawel Durow. Die Franzosen weisen den Vorwurf kategorisch zurück.
Er sei vom Auslandsgeheimdienst gebeten worden, »konservative Stimmen« vor der Wahl in Rumänien zu unterdrücken, behauptet Telegram-CEO Pawel Durow. Die Franzosen weisen den Vorwurf kategorisch zurück.
 Dicke Eiskruste und bis zu minus 200 Grad - klingt nicht gerade angenehm. Warum der Saturnmond Enceladus auf der Suche nach außerirdischem Leben trotzdem vielversprechend ist.
Dicke Eiskruste und bis zu minus 200 Grad - klingt nicht gerade angenehm. Warum der Saturnmond Enceladus auf der Suche nach außerirdischem Leben trotzdem vielversprechend ist.
 Mara leidet unter der vermeidend-restriktiven Ernährungsstörung, kurz Arfid, welche Essen für sie zur Herausforderung macht. Sie kann kaum festes Obst, Gemüse oder kaltes gegartes Fleisch essen. Trotz der Herausforderungen erweitert sie langsam ihren Speiseplan - und hofft, ihre Tochter nicht mit ihrem Essverhalten zu belasten.
Mara leidet unter der vermeidend-restriktiven Ernährungsstörung, kurz Arfid, welche Essen für sie zur Herausforderung macht. Sie kann kaum festes Obst, Gemüse oder kaltes gegartes Fleisch essen. Trotz der Herausforderungen erweitert sie langsam ihren Speiseplan - und hofft, ihre Tochter nicht mit ihrem Essverhalten zu belasten.
 Der Kurznachrichtendienst X war am Samstag zwischenzeitlich nicht zu erreichen, angeblich stecken Hacker hinter der Störung. Firmenchef Elon Musk will nun »wieder rund um die Uhr bei der Arbeit« sein.
Der Kurznachrichtendienst X war am Samstag zwischenzeitlich nicht zu erreichen, angeblich stecken Hacker hinter der Störung. Firmenchef Elon Musk will nun »wieder rund um die Uhr bei der Arbeit« sein.
 Es ist so verlockend: Der Wecker klingelt und man haut auf die Schlummertaste, um noch etwas Zeit zu schinden. Sinnvoll ist das allerdings nicht.
Es ist so verlockend: Der Wecker klingelt und man haut auf die Schlummertaste, um noch etwas Zeit zu schinden. Sinnvoll ist das allerdings nicht.
 Frauen verlieren in den Wechseljahren oftmals die Lust auf Sex. Hier erklärt der Gynäkologe Markus Valk, wie Paare sich seelisch und körperlich wieder annähern können.
Frauen verlieren in den Wechseljahren oftmals die Lust auf Sex. Hier erklärt der Gynäkologe Markus Valk, wie Paare sich seelisch und körperlich wieder annähern können.
 In Uganda arbeiten Forscher an einem weltweit einzigartigen Projekt: Mit genetisch veränderten Moskitos soll die Verbreitung von Malaria gestoppt werden. Fast jede Minute stirbt weltweit ein Kind unter fünf Jahren an dem Fieber. Nun sollen die Gen-Mücken erstmals im Freien getestet werden.
In Uganda arbeiten Forscher an einem weltweit einzigartigen Projekt: Mit genetisch veränderten Moskitos soll die Verbreitung von Malaria gestoppt werden. Fast jede Minute stirbt weltweit ein Kind unter fünf Jahren an dem Fieber. Nun sollen die Gen-Mücken erstmals im Freien getestet werden.
 Ab dem 27. Mai will der US-Konzern Meta Beiträge auf seinen Plattformen nutzen, um seine KI zu trainieren. So können Nutzerinnen und Nutzer von Instagram, WhatsApp und Facebook widersprechen.
Ab dem 27. Mai will der US-Konzern Meta Beiträge auf seinen Plattformen nutzen, um seine KI zu trainieren. So können Nutzerinnen und Nutzer von Instagram, WhatsApp und Facebook widersprechen.
 Die Frage ist nicht ob, sondern wann sich ein neuer Krankheitserreger weltweit ausbreiten wird. Die Gesundheitsexpertin Branwen Hennig erklärt, warum die Welt nun besser vorbereitet ist.
Die Frage ist nicht ob, sondern wann sich ein neuer Krankheitserreger weltweit ausbreiten wird. Die Gesundheitsexpertin Branwen Hennig erklärt, warum die Welt nun besser vorbereitet ist.
 Immer mehr Menschen in Deutschland lassen sich wegen einer Tabaksucht behandeln, wie aus einer Analyse der KKH Kaufmännischen Krankenkasse hervorgeht. Unter den Betroffenen leidet ein steigender Anteil zudem an der chronischen Lungenerkrankung COPD. Experten betonen: Aufhören lohnt sich in jedem Alter.
Immer mehr Menschen in Deutschland lassen sich wegen einer Tabaksucht behandeln, wie aus einer Analyse der KKH Kaufmännischen Krankenkasse hervorgeht. Unter den Betroffenen leidet ein steigender Anteil zudem an der chronischen Lungenerkrankung COPD. Experten betonen: Aufhören lohnt sich in jedem Alter.
 In der Not frisst der Megalodon auch kleine Fische. Das hat ein Forschungsteam jetzt herausgefunden. Die Analyse der Zähne des größte Raubfisches der Erdgeschichte zeigt: Der Meeres-Gigant ernährte sich keineswegs nur einseitig. Vielmehr sei er ein "ökologisch vielseitiger Generalist" gewesen.
In der Not frisst der Megalodon auch kleine Fische. Das hat ein Forschungsteam jetzt herausgefunden. Die Analyse der Zähne des größte Raubfisches der Erdgeschichte zeigt: Der Meeres-Gigant ernährte sich keineswegs nur einseitig. Vielmehr sei er ein "ökologisch vielseitiger Generalist" gewesen.
 Eine neue Studie zeigt, dass Jupiter kurz nach der Entstehung des Sonnensystems doppelt so groß war wie heute. Auch sein Magnetfeld war deutlich stärker. Die Erkenntnisse gelangen mit zwei Zeitzeugen - kleinen Monden, die ganz nah an dem Gasriesen ihre Bahnen ziehen.
Eine neue Studie zeigt, dass Jupiter kurz nach der Entstehung des Sonnensystems doppelt so groß war wie heute. Auch sein Magnetfeld war deutlich stärker. Die Erkenntnisse gelangen mit zwei Zeitzeugen - kleinen Monden, die ganz nah an dem Gasriesen ihre Bahnen ziehen.
 Eine Samenbank nutzte in Dutzenden Fällen unwissentlich Spenden eines Mannes, der eine krebserregende Mutation in sich trug. Wie konnte es dazu kommen? Ein Überblick über Spermaspenden und künstliche Befruchtungen in Deutschland.
Eine Samenbank nutzte in Dutzenden Fällen unwissentlich Spenden eines Mannes, der eine krebserregende Mutation in sich trug. Wie konnte es dazu kommen? Ein Überblick über Spermaspenden und künstliche Befruchtungen in Deutschland.
 Sie sind über 80 Jahre alt, doch ihre Gedächtnisleistung entspricht bis zu 30 Jahre jüngeren Menschen: Die »Super-Ager«. In Magdeburg untersuchen Forschende, woran das liegt. Eine »Arte Re:«-Reportage von SPIEGEL TV.
Sie sind über 80 Jahre alt, doch ihre Gedächtnisleistung entspricht bis zu 30 Jahre jüngeren Menschen: Die »Super-Ager«. In Magdeburg untersuchen Forschende, woran das liegt. Eine »Arte Re:«-Reportage von SPIEGEL TV.
 Mit der Seagate Ultra Compact SSD ist es möglich, ein oder zwei Terabyte Speicher am Schlüsselbund zu tragen. Im Praxistest erweist sie sich als robust, praktisch und mehr als schnell genug für den Alltagseinsatz.
Mit der Seagate Ultra Compact SSD ist es möglich, ein oder zwei Terabyte Speicher am Schlüsselbund zu tragen. Im Praxistest erweist sie sich als robust, praktisch und mehr als schnell genug für den Alltagseinsatz.
 An der uneingeschränkten Echtheit von Bewertungen auf Trustpilot gibt es Zweifel. Die Wettbewerbszentrale sieht darin einen möglichen Verstoß gegen das Gesetz gegen den unlauteren Wettbewerb.
An der uneingeschränkten Echtheit von Bewertungen auf Trustpilot gibt es Zweifel. Die Wettbewerbszentrale sieht darin einen möglichen Verstoß gegen das Gesetz gegen den unlauteren Wettbewerb.
 Vier der größten Online-Pornoportale verstoßen nach Ansicht der EU-Kommission möglicherweise gegen Jugendschutzvorgaben. Im Zentrum steht die unzureichende Altersverifikation.
Vier der größten Online-Pornoportale verstoßen nach Ansicht der EU-Kommission möglicherweise gegen Jugendschutzvorgaben. Im Zentrum steht die unzureichende Altersverifikation.
 Mit einer Rekordzahl an Drohnen greift Russland Nacht für Nacht die Ukraine an, dazu kommen Attacken mit Marschflugkörpern und Raketen. Die Ukrainer wehren sich nach Kräften, doch diese schwinden zusehends.
Mit einer Rekordzahl an Drohnen greift Russland Nacht für Nacht die Ukraine an, dazu kommen Attacken mit Marschflugkörpern und Raketen. Die Ukrainer wehren sich nach Kräften, doch diese schwinden zusehends.
 Kidnappen statt Hacken: Die französische Polizei hat einen weiteren Versuch verhindert, eine Person mit Verbindungen zu Bitcoin-Unternehmern zu entführen. 20 Personen wurden festgenommen.
Kidnappen statt Hacken: Die französische Polizei hat einen weiteren Versuch verhindert, eine Person mit Verbindungen zu Bitcoin-Unternehmern zu entführen. 20 Personen wurden festgenommen.
 Im Ersten Weltkrieg sinkt nach einem Unglück ein U-Boot der US-Marine vor der Küste Kaliforniens auf den Meeresboden. Über die Jahrzehnte gerät das Schiff in Vergessenheit - bis ein Forschungsteam jetzt das erste Mal zum Wrack taucht und dort erstaunliche Bilder festhält.
Im Ersten Weltkrieg sinkt nach einem Unglück ein U-Boot der US-Marine vor der Küste Kaliforniens auf den Meeresboden. Über die Jahrzehnte gerät das Schiff in Vergessenheit - bis ein Forschungsteam jetzt das erste Mal zum Wrack taucht und dort erstaunliche Bilder festhält.
 Ein US-Autor geißelt die bizarren Zukunftsfantastereien der Tech-Elite. Ob nun Menschen mit Computern verschmelzen oder KI-gestählte Wesen das All kolonialisieren sollen – der Kosmologe Adam Becker hält das für reinen Humbug von Angebern.
Ein US-Autor geißelt die bizarren Zukunftsfantastereien der Tech-Elite. Ob nun Menschen mit Computern verschmelzen oder KI-gestählte Wesen das All kolonialisieren sollen – der Kosmologe Adam Becker hält das für reinen Humbug von Angebern.
 Mit Strom fliegen? Bisher nur für kurze Strecken denkbar - moderne Akkus sind nicht leistungsfähig genug. US-Forscher präsentieren nun eine Alternative: eine Brennstoffzelle, die mit Natrium betankt wird. Das Ganze soll sogar einen weiteren klimaschonenden Nebeneffekt haben.
Mit Strom fliegen? Bisher nur für kurze Strecken denkbar - moderne Akkus sind nicht leistungsfähig genug. US-Forscher präsentieren nun eine Alternative: eine Brennstoffzelle, die mit Natrium betankt wird. Das Ganze soll sogar einen weiteren klimaschonenden Nebeneffekt haben.
 Obwohl er ein tragbarer Laser-Beamer ist, wirft der Anker Nebula X1 ein gestochen scharfes und sehr helles Bild an die Wand. Außerdem ist er kinderleicht zu bedienen und vielseitig. Lediglich ein happig hoher Preis trübt das Sehvergnügen.
Obwohl er ein tragbarer Laser-Beamer ist, wirft der Anker Nebula X1 ein gestochen scharfes und sehr helles Bild an die Wand. Außerdem ist er kinderleicht zu bedienen und vielseitig. Lediglich ein happig hoher Preis trübt das Sehvergnügen.
 Die US-Regierung lässt nicht locker: Laut Medienberichten hat sie angekündigt, Bundesbehörden zur Kündigung bestehender Verträge mit der Eliteuniversität aufzurufen. Harvard wehrt sich juristisch gegen das Vorgehen Trumps.
Die US-Regierung lässt nicht locker: Laut Medienberichten hat sie angekündigt, Bundesbehörden zur Kündigung bestehender Verträge mit der Eliteuniversität aufzurufen. Harvard wehrt sich juristisch gegen das Vorgehen Trumps.
 1,5 Kilogramm schwer, 85 Zentimeter lang: Bisher gab es keine Aufnahmen der Hochland-Riesenbaumratte, nun konnte ein tschechischer Biologe die Tiere erstmals fotografieren. Hier erzählt er, wie er das geschafft hat.
1,5 Kilogramm schwer, 85 Zentimeter lang: Bisher gab es keine Aufnahmen der Hochland-Riesenbaumratte, nun konnte ein tschechischer Biologe die Tiere erstmals fotografieren. Hier erzählt er, wie er das geschafft hat.
 Die Starship Rakete von Elon Musk soll irgendwann eine wiederverwendbare und kostengünstige Alternative sein. Bisher ist die Bilanz der Testflüge aber eher durchwachsen. Auch diesmal verliert das Team schnell den Kontakt zur Riesenrakete.
Die Starship Rakete von Elon Musk soll irgendwann eine wiederverwendbare und kostengünstige Alternative sein. Bisher ist die Bilanz der Testflüge aber eher durchwachsen. Auch diesmal verliert das Team schnell den Kontakt zur Riesenrakete.
 Weil die RWE-Kraftwerke besonders viel CO₂ ausstoßen, hat ein Bauer aus Peru geklagt. Nun hat ein Gericht entschieden: Der Energiekonzern muss nicht für Klimaanpassungen in den Anden zahlen. Die Kläger werten das Urteil dennoch als Erfolg.
Weil die RWE-Kraftwerke besonders viel CO₂ ausstoßen, hat ein Bauer aus Peru geklagt. Nun hat ein Gericht entschieden: Der Energiekonzern muss nicht für Klimaanpassungen in den Anden zahlen. Die Kläger werten das Urteil dennoch als Erfolg.
 Die US-Regierung will offenbar, dass die Bundesbehörden die letzten bestehenden Verträge mit Harvard streichen. Zudem sollen Visa-Interviews mit Studierenden gestoppt werden, die sich in den USA immatrikulieren möchten.
Die US-Regierung will offenbar, dass die Bundesbehörden die letzten bestehenden Verträge mit Harvard streichen. Zudem sollen Visa-Interviews mit Studierenden gestoppt werden, die sich in den USA immatrikulieren möchten.
 Nutzerinnen und Nutzer haben jahrelang auf eine eigenständige iPad-Version für WhatsApp gewartet. Nun hat Meta ihnen den Wunsch erfüllt. Die Funktionen sind bekannt, aber der große Bildschirm hat seine Vorteile.
Nutzerinnen und Nutzer haben jahrelang auf eine eigenständige iPad-Version für WhatsApp gewartet. Nun hat Meta ihnen den Wunsch erfüllt. Die Funktionen sind bekannt, aber der große Bildschirm hat seine Vorteile.
 Derzeit ist noch 2024 das wärmste Jahr der Messgeschichte. Doch der Rekord wird laut einer Prognose wohl nicht lange halten. Auch ein wichtiges Klimaziel wackelt zunehmend.
Derzeit ist noch 2024 das wärmste Jahr der Messgeschichte. Doch der Rekord wird laut einer Prognose wohl nicht lange halten. Auch ein wichtiges Klimaziel wackelt zunehmend.
 2024 gilt als heißestes Jahr seit Beginn der Wetter-Aufzeichnungen. Der Rekord könnte laut einem Uno-Bericht schon bald gebrochen werden. Leise Hoffnung machen Zahlen aus der EU. Die sind aber womöglich nicht von Dauer.
2024 gilt als heißestes Jahr seit Beginn der Wetter-Aufzeichnungen. Der Rekord könnte laut einem Uno-Bericht schon bald gebrochen werden. Leise Hoffnung machen Zahlen aus der EU. Die sind aber womöglich nicht von Dauer.
 Eine Baustelle in Baden-Württemberg erweist sich als archäologische Schatzgrube. Während Erdarbeiten finden Arbeiter einen 1,20 Meter langen Mammutzahn. Aber er ist nicht das einzige Relikt aus der Vergangenheit.
Eine Baustelle in Baden-Württemberg erweist sich als archäologische Schatzgrube. Während Erdarbeiten finden Arbeiter einen 1,20 Meter langen Mammutzahn. Aber er ist nicht das einzige Relikt aus der Vergangenheit.
 Die Merz-Regierung nutzt eine Vorlage der Ampelkoalition, um die Digitalisierung voranzubringen. Wer Glasfaser verlegt, kann sich künftig auf »überragendes öffentliches Interesse« berufen.
Die Merz-Regierung nutzt eine Vorlage der Ampelkoalition, um die Digitalisierung voranzubringen. Wer Glasfaser verlegt, kann sich künftig auf »überragendes öffentliches Interesse« berufen.
 Über 15 Jahre nach dem Start von Whatsapp kann man den Messenger jetzt auch mit einer offiziellen App auf iPads nutzen, ab sofort steht sie zum Download zur Verfügung. Die Anwendung ist schnell eingerichtet, funktioniert auch mit Android-Smartphones und bringt zusätzliche Möglichkeiten.
Über 15 Jahre nach dem Start von Whatsapp kann man den Messenger jetzt auch mit einer offiziellen App auf iPads nutzen, ab sofort steht sie zum Download zur Verfügung. Die Anwendung ist schnell eingerichtet, funktioniert auch mit Android-Smartphones und bringt zusätzliche Möglichkeiten.
 2024 gilt als heißestes Jahr seit Beginn der Wetteraufzeichnungen. Der Rekord könnte laut einem Uno-Bericht schon bald gebrochen werden. Zahlen aus der EU machen Hoffnung, die ist aber womöglich nicht von Dauer.
2024 gilt als heißestes Jahr seit Beginn der Wetteraufzeichnungen. Der Rekord könnte laut einem Uno-Bericht schon bald gebrochen werden. Zahlen aus der EU machen Hoffnung, die ist aber womöglich nicht von Dauer.
 Mit Musikstreaming lassen sich nur Peanuts verdienen? Spotifys Daten zu Lizenzzahlungen für 2024 sollen diesen Eindruck entkräften. Sie zeigen auch, wie hoch der Konkurrenzdruck ist.
Mit Musikstreaming lassen sich nur Peanuts verdienen? Spotifys Daten zu Lizenzzahlungen für 2024 sollen diesen Eindruck entkräften. Sie zeigen auch, wie hoch der Konkurrenzdruck ist.
 Ein weiteres Starship von Elon Musk ist bei einem Test zerstört worden. Würden der Nasa nur halb so viele Raketen explodieren wie SpaceX, sie wäre am Ende. Doch der Milliardär träumt weiter vom Mars.
Ein weiteres Starship von Elon Musk ist bei einem Test zerstört worden. Würden der Nasa nur halb so viele Raketen explodieren wie SpaceX, sie wäre am Ende. Doch der Milliardär träumt weiter vom Mars.
 Elon Musks KI-Chatbot Grok soll für ein Jahr in den Messenger Telegram integriert werden. Das hat Telegram-Gründer Pawel Durow bekannt gegeben. Nutzerdaten für das Training der KI will Telegram demnach nicht mit Grok teilen.
Elon Musks KI-Chatbot Grok soll für ein Jahr in den Messenger Telegram integriert werden. Das hat Telegram-Gründer Pawel Durow bekannt gegeben. Nutzerdaten für das Training der KI will Telegram demnach nicht mit Grok teilen.
 Ungeachtet der Attacken der Trump-Regierung feiert die Harvard-Universität ihre Absolventen, Studierende solidarisieren sich. Aber die Angreifer sitzen am längeren Hebel. Sie können Harvard den Nachwuchs entziehen.
Ungeachtet der Attacken der Trump-Regierung feiert die Harvard-Universität ihre Absolventen, Studierende solidarisieren sich. Aber die Angreifer sitzen am längeren Hebel. Sie können Harvard den Nachwuchs entziehen.
 Mit seinem Ausländerbann an der Eliteuni Harvard schadet Trump sich selbst. Gleichzeitig eröffnet er dem Forschungsstandort Deutschland eine große Chance. Die neue Regierung sollte sie nutzen.
Mit seinem Ausländerbann an der Eliteuni Harvard schadet Trump sich selbst. Gleichzeitig eröffnet er dem Forschungsstandort Deutschland eine große Chance. Die neue Regierung sollte sie nutzen.
 Die Volksrepublik hat ambitionierte Pläne für das Weltall. Erstmals startet China jetzt eine Mission zur Sammlung von Gesteinsproben auf einem rund 40 Millionen Kilometer entfernten Asteroiden. Die Reise wird Jahre dauern.
Die Volksrepublik hat ambitionierte Pläne für das Weltall. Erstmals startet China jetzt eine Mission zur Sammlung von Gesteinsproben auf einem rund 40 Millionen Kilometer entfernten Asteroiden. Die Reise wird Jahre dauern.
 Sie sind klein, platt und lieben Menschenblut: Bettwanzen sind bereits seit Jahrtausenden ein lästiger Begleiter des Menschen. Eine neue Studie zeigt, wann diese Verbindung ihren Anfang nahm - und wie sich die Parasiten vor allem mit der Urbanisierung explosionsartig verbreiteten.
Sie sind klein, platt und lieben Menschenblut: Bettwanzen sind bereits seit Jahrtausenden ein lästiger Begleiter des Menschen. Eine neue Studie zeigt, wann diese Verbindung ihren Anfang nahm - und wie sich die Parasiten vor allem mit der Urbanisierung explosionsartig verbreiteten.
 Mitte Februar schlug eine Drohne im abgeschalteten AKW Tschernobyl ein. Zunächst schienen die Schäden überschaubar zu sein, doch nun wird klar, wie dramatisch die Folgen des Angriffs sind. Die große Grafikanalyse.
Mitte Februar schlug eine Drohne im abgeschalteten AKW Tschernobyl ein. Zunächst schienen die Schäden überschaubar zu sein, doch nun wird klar, wie dramatisch die Folgen des Angriffs sind. Die große Grafikanalyse.
 Viele Menschen nutzen Himmelfahrt und das lange Wochenende zum Wegfahren. Wer sich bei der Routenplanung blind auf Google Maps verlässt, hat ein Problem. Dort sind einige Autobahnen gesperrt, obwohl sie eigentlich freigegeben sind.
Viele Menschen nutzen Himmelfahrt und das lange Wochenende zum Wegfahren. Wer sich bei der Routenplanung blind auf Google Maps verlässt, hat ein Problem. Dort sind einige Autobahnen gesperrt, obwohl sie eigentlich freigegeben sind.
 In Freiburg wurden Knochen von Lepra-Kranken und anderen »Aussätzigen« aus dem Mittelalter ausgegraben. Sie verraten, wie der Alltag dieser gefürchteten Menschen aussah.
In Freiburg wurden Knochen von Lepra-Kranken und anderen »Aussätzigen« aus dem Mittelalter ausgegraben. Sie verraten, wie der Alltag dieser gefürchteten Menschen aussah.
 Flavio Anselmetti ist Geologe an der Universität Bern. Hier erklärt er, wie wahrscheinlich ein Dammbruch ist – und warum er zögert, bei dem Bergrutsch in Blatten von einer direkten Folge des Klimawandels zu sprechen.
Flavio Anselmetti ist Geologe an der Universität Bern. Hier erklärt er, wie wahrscheinlich ein Dammbruch ist – und warum er zögert, bei dem Bergrutsch in Blatten von einer direkten Folge des Klimawandels zu sprechen.
 In der Nähe der guatemaltekisch-mexikanischen Grenze entdecken Wissenschaftler eine jahrtausendealte Stätte der Maya. Sie sprechen von einem bedeutenden kulturellen Zentrum der Zivilisation - und graben verschiedene Figuren, Keramiken und ein Observatorium aus.
In der Nähe der guatemaltekisch-mexikanischen Grenze entdecken Wissenschaftler eine jahrtausendealte Stätte der Maya. Sie sprechen von einem bedeutenden kulturellen Zentrum der Zivilisation - und graben verschiedene Figuren, Keramiken und ein Observatorium aus.
 Mit seinem »MAHA Report« wollte Robert F. Kennedy die US-Wissenschaftspolitik neu definieren. Doch der Report gibt Quellen falsch wieder, einige Studien existieren gar nicht. Haben sich die Autoren auf KI verlassen?
Mit seinem »MAHA Report« wollte Robert F. Kennedy die US-Wissenschaftspolitik neu definieren. Doch der Report gibt Quellen falsch wieder, einige Studien existieren gar nicht. Haben sich die Autoren auf KI verlassen?
 Flavio Anselmetti ist Geologe an der Universität Bern. Hier erklärt er, wie sich ein Dammbruch vermeiden ließe – und warum er zögert, bei dem Bergrutsch in Blatten von einer direkten Folge des Klimawandels zu sprechen.
Flavio Anselmetti ist Geologe an der Universität Bern. Hier erklärt er, wie sich ein Dammbruch vermeiden ließe – und warum er zögert, bei dem Bergrutsch in Blatten von einer direkten Folge des Klimawandels zu sprechen.
 Astronomen haben zufällig einen einzigartigen Stern in der Milchstraße entdeckt. Anders als ähnliche Himmelskörper sendet er Radiowellen und Röntgenstrahlen aus. Nun rätseln Forscher, worum genau es sich bei dem Objekt handelt.
Astronomen haben zufällig einen einzigartigen Stern in der Milchstraße entdeckt. Anders als ähnliche Himmelskörper sendet er Radiowellen und Röntgenstrahlen aus. Nun rätseln Forscher, worum genau es sich bei dem Objekt handelt.
 Während USA und China ambitionierte Mondmissionen planen, hängt Europa weiterhin von der Nasa ab. Esa-Chef Aschbacher fordert mehr Eigenständigkeit in der Raumfahrt - doch die Konkurrenz aus dem Privatsektor setzt den Kontinent zusätzlich unter Druck.
Während USA und China ambitionierte Mondmissionen planen, hängt Europa weiterhin von der Nasa ab. Esa-Chef Aschbacher fordert mehr Eigenständigkeit in der Raumfahrt - doch die Konkurrenz aus dem Privatsektor setzt den Kontinent zusätzlich unter Druck.
 Neben Social-Media-Apps wird Meta künftig moderne Militärtechnik wie Datenbrillen und Helme entwickeln. Der Konzern von Mark Zuckerberg kooperiert dafür mit einem Unternehmer, den er einst vom Hof gejagt hat.
Neben Social-Media-Apps wird Meta künftig moderne Militärtechnik wie Datenbrillen und Helme entwickeln. Der Konzern von Mark Zuckerberg kooperiert dafür mit einem Unternehmer, den er einst vom Hof gejagt hat.
 Was signalisieren Pferde, wenn sie das Maul aufreißen und die Ohren anlegen? Forschende haben die vielseitige Mimik der Tiere in Videostudien untersucht. Und dabei erstaunliche Ähnlichkeiten mit Primaten entdeckt.
Was signalisieren Pferde, wenn sie das Maul aufreißen und die Ohren anlegen? Forschende haben die vielseitige Mimik der Tiere in Videostudien untersucht. Und dabei erstaunliche Ähnlichkeiten mit Primaten entdeckt.
 Weniger ist manchmal mehr: Das Samsung Galaxy S25 Edge ist im Vergleich zu anderen großen Smartphones ein herrlich leichtes und dünnes Ding, das man gerne hält. Für seine extrem schlanken Maße ist die Ausdauer des Geräts zudem überraschend gut, doch leider bezahlt man für weniger auch mehr.
Weniger ist manchmal mehr: Das Samsung Galaxy S25 Edge ist im Vergleich zu anderen großen Smartphones ein herrlich leichtes und dünnes Ding, das man gerne hält. Für seine extrem schlanken Maße ist die Ausdauer des Geräts zudem überraschend gut, doch leider bezahlt man für weniger auch mehr.
 Experten hoffen, dass das Wasser in Blatten allmählich abläuft. Doch was, wenn doch plötzlich eine Flut losbricht? Besondere Sorgen bereiten der weiche Damm aus Eis und Geröll und große Mengen Schlamm.
Experten hoffen, dass das Wasser in Blatten allmählich abläuft. Doch was, wenn doch plötzlich eine Flut losbricht? Besondere Sorgen bereiten der weiche Damm aus Eis und Geröll und große Mengen Schlamm.
 Seine Erfindung revolutionierte das Leben von Millionen Frauen auf der ganzen Welt: Anfang der 1980er Jahre entwickelte Émile Baulieu die Abtreibungspille RU 486. Später entwickelte der Franzose eine Behandlung gegen Depressionen. Nun ist der Wissenschaftler in Paris verstorben.
Seine Erfindung revolutionierte das Leben von Millionen Frauen auf der ganzen Welt: Anfang der 1980er Jahre entwickelte Émile Baulieu die Abtreibungspille RU 486. Später entwickelte der Franzose eine Behandlung gegen Depressionen. Nun ist der Wissenschaftler in Paris verstorben.
 Seine Forschung führte zur Entwicklung der Abtreibungspille. Nun ist Étienne-Émile Baulieu, der Erfinder des medikamentösen Schwangerschaftsabbruchs, im Alter von 98 Jahren gestorben.
Seine Forschung führte zur Entwicklung der Abtreibungspille. Nun ist Étienne-Émile Baulieu, der Erfinder des medikamentösen Schwangerschaftsabbruchs, im Alter von 98 Jahren gestorben.
 Mara leidet unter der vermeidend-restriktiven Ernährungsstörung, kurz Arfid, welche Essen für sie zur Herausforderung macht. Sie kann kaum festes Obst, Gemüse oder kaltes gegartes Fleisch essen. Trotz der Herausforderungen erweitert sie langsam ihren Speiseplan - und hofft, ihre Tochter nicht mit ihrem Essverhalten zu belasten.
Mara leidet unter der vermeidend-restriktiven Ernährungsstörung, kurz Arfid, welche Essen für sie zur Herausforderung macht. Sie kann kaum festes Obst, Gemüse oder kaltes gegartes Fleisch essen. Trotz der Herausforderungen erweitert sie langsam ihren Speiseplan - und hofft, ihre Tochter nicht mit ihrem Essverhalten zu belasten.
 Rauchen galt einst als Zeichen von Coolness und Emanzipation. Heute sinkt der Anteil der Raucher in Deutschland auf historische Tiefstände. Besonders die junge Generation wendet sich zunehmend vom Tabakkonsum ab.
Rauchen galt einst als Zeichen von Coolness und Emanzipation. Heute sinkt der Anteil der Raucher in Deutschland auf historische Tiefstände. Besonders die junge Generation wendet sich zunehmend vom Tabakkonsum ab.
 Rund 1200 Schädel lagern in einer Sammlung an der Leipziger Universität. Sie wurden einst für rassistische Untersuchungen benutzt. Jetzt sind 19 von ihnen zurück in die USA zurückgebracht worden.
Rund 1200 Schädel lagern in einer Sammlung an der Leipziger Universität. Sie wurden einst für rassistische Untersuchungen benutzt. Jetzt sind 19 von ihnen zurück in die USA zurückgebracht worden.
 Mit KI erschaffene Influencer erobern soziale Netzwerke. Die Avatare sind so perfekt wie willenlos und überwiegend weiblich. Wer verdient an den Geschöpfen?
Mit KI erschaffene Influencer erobern soziale Netzwerke. Die Avatare sind so perfekt wie willenlos und überwiegend weiblich. Wer verdient an den Geschöpfen?
 Rund 1200 Schädel lagern in einer Sammlung an der Leipziger Universität. Sie wurden einst für rassistische Untersuchungen benutzt. Jetzt sind 19 von ihnen in die USA zurückgebracht worden.
Rund 1200 Schädel lagern in einer Sammlung an der Leipziger Universität. Sie wurden einst für rassistische Untersuchungen benutzt. Jetzt sind 19 von ihnen in die USA zurückgebracht worden.
 Die eingeschleppte Ameise Tapinoma magnum bedroht Gebäude und verursacht Stromausfälle. Um solch invasiven Arten besser vorbeugen zu können, wollen die Umweltminister der Länder nun eine neue »nationale Liste« einführen.
Die eingeschleppte Ameise Tapinoma magnum bedroht Gebäude und verursacht Stromausfälle. Um solch invasiven Arten besser vorbeugen zu können, wollen die Umweltminister der Länder nun eine neue »nationale Liste« einführen.
 Wer sind meine biologischen Eltern? Diese Frage lässt einige Menschen ein Leben lang nicht los. Alexander Alberts-Dakash sucht die Ahnen mit Speichelproben und klassischer Detektivarbeit. Und findet Spuren auf der ganzen Welt.
Wer sind meine biologischen Eltern? Diese Frage lässt einige Menschen ein Leben lang nicht los. Alexander Alberts-Dakash sucht die Ahnen mit Speichelproben und klassischer Detektivarbeit. Und findet Spuren auf der ganzen Welt.
 Die Sonne hat bei einer Eruption große Mengen geladener Teilchen in Richtung Erde geschleudert. Fachleute sehen gute Chancen auf Polarlichter. Nicht überall in Deutschland ist die Sicht auf den Himmel jedoch klar.
Die Sonne hat bei einer Eruption große Mengen geladener Teilchen in Richtung Erde geschleudert. Fachleute sehen gute Chancen auf Polarlichter. Nicht überall in Deutschland ist die Sicht auf den Himmel jedoch klar.
 Beim Klatschen entsteht ein für jeden Menschen einzigartiger Klang, finden Forscher heraus. Ihre Studie liefert zudem neue Einblicke in die Physik dieser alltäglichen Geste: Nicht nur der Aufprall der Hände, sondern auch ein spezieller Luftstrom sind demnach Ursache für den charakteristischen Klang
Beim Klatschen entsteht ein für jeden Menschen einzigartiger Klang, finden Forscher heraus. Ihre Studie liefert zudem neue Einblicke in die Physik dieser alltäglichen Geste: Nicht nur der Aufprall der Hände, sondern auch ein spezieller Luftstrom sind demnach Ursache für den charakteristischen Klang
 Mit KI wollen Programmierer die Laute von Tieren in menschliche Sprache überführen. Erste Anwendungen gibt es bereits, bisher vorwiegend für zwei Tierarten.
Mit KI wollen Programmierer die Laute von Tieren in menschliche Sprache überführen. Erste Anwendungen gibt es bereits, bisher vorwiegend für zwei Tierarten.
 Die Bundesnetzagentur will das Vorgehen gegen verbotene Postings auf Social Media stärken. Drei neue Meldestellen sollen helfen, der Flut an Inhalten auf Facebook, X oder TikTok Herr zu werden.
Die Bundesnetzagentur will das Vorgehen gegen verbotene Postings auf Social Media stärken. Drei neue Meldestellen sollen helfen, der Flut an Inhalten auf Facebook, X oder TikTok Herr zu werden.
 Das Landleben hat nicht zwangsläufig einen positiven Effekt auf die Gesundheit von Kindern. Laut einer Studie leiden Stadtkinder seltener an Übergewicht als Landkinder. Besonders Bildschirmzeit und die Erreichbarkeit von Sportangeboten spielen dabei laut Experten eine Rolle.
Das Landleben hat nicht zwangsläufig einen positiven Effekt auf die Gesundheit von Kindern. Laut einer Studie leiden Stadtkinder seltener an Übergewicht als Landkinder. Besonders Bildschirmzeit und die Erreichbarkeit von Sportangeboten spielen dabei laut Experten eine Rolle.
 Angekündigt war ein seltenes Lichtspektakel am nächtlichen Firmament: Nordlichter sollten sogar in den Alpen zu sehen sein. Woher kommt das Himmelsphänomen? Warum gibt es das sonst nur am Polarkreis?
Angekündigt war ein seltenes Lichtspektakel am nächtlichen Firmament: Nordlichter sollten sogar in den Alpen zu sehen sein. Woher kommt das Himmelsphänomen? Warum gibt es das sonst nur am Polarkreis?
 Die Anker Docking Station TB5 ist mit Thunderbolt 5 und insgesamt 14 Anschlussmöglichkeiten auf Höchstleistung getrimmt. Sie ermöglicht die aktuell schnellste Datenübertragung über USB-C und macht auch bei Profi- und Gaming-Laptops zusätzliche Ladegeräte überflüssig.
Die Anker Docking Station TB5 ist mit Thunderbolt 5 und insgesamt 14 Anschlussmöglichkeiten auf Höchstleistung getrimmt. Sie ermöglicht die aktuell schnellste Datenübertragung über USB-C und macht auch bei Profi- und Gaming-Laptops zusätzliche Ladegeräte überflüssig.
 Rund 600.000 Menschen in Deutschland leiden an ME/CFS – oft mit dramatischen Folgen. Noch fehlt eine anerkannte Therapie. SPIEGEL-Redakteurin Nina Weber berichtet, warum Betroffene jetzt auf einen Durchbruch hoffen.
Rund 600.000 Menschen in Deutschland leiden an ME/CFS – oft mit dramatischen Folgen. Noch fehlt eine anerkannte Therapie. SPIEGEL-Redakteurin Nina Weber berichtet, warum Betroffene jetzt auf einen Durchbruch hoffen.
 Die Trump-Regierung wütet bei der Nasa: Das Budget der US-Weltraumbehörde soll zusammengestrichen werden, etliche Mitarbeiter müssen gehen. Das hat auch Folgen für Europa.
Die Trump-Regierung wütet bei der Nasa: Das Budget der US-Weltraumbehörde soll zusammengestrichen werden, etliche Mitarbeiter müssen gehen. Das hat auch Folgen für Europa.
 Elon Musks KI-Chatbot Grok soll für ein Jahr in den Messenger Telegram integriert werden. Das hat Telegram-Gründer Pawel Durow bekannt gegeben. Nutzerdaten für das Training der KI will Telegram demnach nicht mit Grok teilen.
Elon Musks KI-Chatbot Grok soll für ein Jahr in den Messenger Telegram integriert werden. Das hat Telegram-Gründer Pawel Durow bekannt gegeben. Nutzerdaten für das Training der KI will Telegram demnach nicht mit Grok teilen.
 Nutzerinnen und Nutzer haben jahrelang auf eine eigenständige iPad-Version für WhatsApp gewartet. Nun hat Meta ihnen den Wunsch erfüllt. Die Funktionen sind bekannt, aber der große Bildschirm hat seine Vorteile.
Nutzerinnen und Nutzer haben jahrelang auf eine eigenständige iPad-Version für WhatsApp gewartet. Nun hat Meta ihnen den Wunsch erfüllt. Die Funktionen sind bekannt, aber der große Bildschirm hat seine Vorteile.
 Gestohlene und verlorene Smartphones lassen sich oft selbst dann noch orten, wenn sie ausgeschaltet sind. Der Polizei hilft das allerdings nur unter bestimmten Umständen.
Gestohlene und verlorene Smartphones lassen sich oft selbst dann noch orten, wenn sie ausgeschaltet sind. Der Polizei hilft das allerdings nur unter bestimmten Umständen.
 Die Anopheles hycranus ist eigentlich in südlichen Regionen der Welt heimisch. Jetzt entdecken Forscher Dutzende Exemplare der Stechmückenart in Brandenburg. Sie sehen einen Zusammenhang mit dem Klimawandel. Die Mückenart ist nicht ungefährlich.
Die Anopheles hycranus ist eigentlich in südlichen Regionen der Welt heimisch. Jetzt entdecken Forscher Dutzende Exemplare der Stechmückenart in Brandenburg. Sie sehen einen Zusammenhang mit dem Klimawandel. Die Mückenart ist nicht ungefährlich.
 Neue Simulationen zeigen: Die Milchstraße könnte der drohenden Kollision mit der Andromeda-Galaxie entgehen. Die Anziehungskraft der Großen Magellanschen Wolke spielt dabei eine entscheidende Rolle. Ganz gebannt ist die Gefahr allerdings nicht.
Neue Simulationen zeigen: Die Milchstraße könnte der drohenden Kollision mit der Andromeda-Galaxie entgehen. Die Anziehungskraft der Großen Magellanschen Wolke spielt dabei eine entscheidende Rolle. Ganz gebannt ist die Gefahr allerdings nicht.
 Auf der Oberfläche von WASP-121b wird es über 3000 Grad heiß. Doch das war nicht immer so. Forschende haben untersucht, wo der Planet entstanden ist. Es zeigen sich Ähnlichkeiten mit unserem Sonnensystem.
Auf der Oberfläche von WASP-121b wird es über 3000 Grad heiß. Doch das war nicht immer so. Forschende haben untersucht, wo der Planet entstanden ist. Es zeigen sich Ähnlichkeiten mit unserem Sonnensystem.
 Lodern Feuer in Wäldern besonders intensiv, kann der Rauch in große Höhen getrieben werden – und dann über weite Strecken reisen. Was das für die Luftqualität in Bodennähe bedeutet.
Lodern Feuer in Wäldern besonders intensiv, kann der Rauch in große Höhen getrieben werden – und dann über weite Strecken reisen. Was das für die Luftqualität in Bodennähe bedeutet.
 Das Balkonkraftwerk-Speichersystem Ecoflow Stream ist nicht nur in der Lage, Geräte mit mehr als 800 Watt selbst produzierten Strom zu versorgen. Es bindet auch dynamische Tarife intelligent ein und verteilt Energie nach Bedarf im Hausnetz. Schlau eingesetzt kann es sich so schnell bezahlt machen.
Das Balkonkraftwerk-Speichersystem Ecoflow Stream ist nicht nur in der Lage, Geräte mit mehr als 800 Watt selbst produzierten Strom zu versorgen. Es bindet auch dynamische Tarife intelligent ein und verteilt Energie nach Bedarf im Hausnetz. Schlau eingesetzt kann es sich so schnell bezahlt machen.
 Bisher waren sich Astronomen sicher, dass die Milchstraße und unsere Nachbargalaxie Andromeda zusammenstoßen werden. Sogar den Zeitpunkt hatten sie errechnet. Doch nun gibt es Zweifel an der Megakollision.
Bisher waren sich Astronomen sicher, dass die Milchstraße und unsere Nachbargalaxie Andromeda zusammenstoßen werden. Sogar den Zeitpunkt hatten sie errechnet. Doch nun gibt es Zweifel an der Megakollision.
 In den Sechzigerjahren waren westdeutsche Psychiatrien düstere Orte voller Gewalt und Strenge. Erst dann setzte ein Wandel ein. Dabei könnte der Zivildienst eine bislang unterschätzte Rolle gespielt haben.
In den Sechzigerjahren waren westdeutsche Psychiatrien düstere Orte voller Gewalt und Strenge. Erst dann setzte ein Wandel ein. Dabei könnte der Zivildienst eine bislang unterschätzte Rolle gespielt haben.
 Einer der »Unsterblichen« ist tot: Pierre Nora prägte über viele Jahrzehnte die französische Geschichtswissenschaft. Nun ist der Historiker im Alter von 93 Jahren gestorben.
Einer der »Unsterblichen« ist tot: Pierre Nora prägte über viele Jahrzehnte die französische Geschichtswissenschaft. Nun ist der Historiker im Alter von 93 Jahren gestorben.
 Menschen aus aller Welt wollten ihre familiäre Abstammung klären oder mehr über Krankheitsrisiken wissen – jetzt werden ihre Daten und DNA-Proben verkauft. Der Grund: Das einst gehypte Start-up 23andMe ist gescheitert.
Menschen aus aller Welt wollten ihre familiäre Abstammung klären oder mehr über Krankheitsrisiken wissen – jetzt werden ihre Daten und DNA-Proben verkauft. Der Grund: Das einst gehypte Start-up 23andMe ist gescheitert.
 Seit Wochen lodern die Flammen in Kanadas Wäldern. Die Brände sind so intensiv, dass der Rauch in große Höhen getrieben wird und dort weite Strecken reist. Inzwischen schafften es die Rauchwolken sogar über den Atlantik. Das macht sich nun in Europa bemerkbar.
Seit Wochen lodern die Flammen in Kanadas Wäldern. Die Brände sind so intensiv, dass der Rauch in große Höhen getrieben wird und dort weite Strecken reist. Inzwischen schafften es die Rauchwolken sogar über den Atlantik. Das macht sich nun in Europa bemerkbar.
 Mitten im Pazifik, keine Zivilisation weit und breit - und dennoch finden sich auch hier Spuren menschlicher Verschmutzung. Wie ein Forschungsteam nun herausfindet, gelangt Eisen aus industrieller Luftverschmutzung in entlegenste Teile der Ozeane und wirbelt dort das Ökosystem durcheinander.
Mitten im Pazifik, keine Zivilisation weit und breit - und dennoch finden sich auch hier Spuren menschlicher Verschmutzung. Wie ein Forschungsteam nun herausfindet, gelangt Eisen aus industrieller Luftverschmutzung in entlegenste Teile der Ozeane und wirbelt dort das Ökosystem durcheinander.
 Die Kurzvideo-Plattform TikTok reagiert auf Kritik mehrerer EU-Länder, dass sie Essstörungen verherrlichen würde. Statt magerer Körper und Abnehmtipps gibt es bei der Suche nach »skinnytok« nun Information und Beratung.
Die Kurzvideo-Plattform TikTok reagiert auf Kritik mehrerer EU-Länder, dass sie Essstörungen verherrlichen würde. Statt magerer Körper und Abnehmtipps gibt es bei der Suche nach »skinnytok« nun Information und Beratung.
 Zum Start der Nintendo Switch 2 erscheint ein neues »Mario Kart«. Hier spricht Psychologe Benjamin Strobel über Familienduelle, fliegende Gamepads und die Angst, kurz vor dem Ziel noch abgeballert zu werden.
Zum Start der Nintendo Switch 2 erscheint ein neues »Mario Kart«. Hier spricht Psychologe Benjamin Strobel über Familienduelle, fliegende Gamepads und die Angst, kurz vor dem Ziel noch abgeballert zu werden.
 Was Menschen zu sich nehmen, woran sie leiden und welche anderen Lebewesen sich an einem Ort aufhalten, hinterlässt Spuren in der Luft. Technik, die an ein Gerät aus »Star Trek« erinnert, macht sie lesbar.
Was Menschen zu sich nehmen, woran sie leiden und welche anderen Lebewesen sich an einem Ort aufhalten, hinterlässt Spuren in der Luft. Technik, die an ein Gerät aus »Star Trek« erinnert, macht sie lesbar.
 Mithilfe von Sonnen- und Windkraft hergestellter Wasserstoff aus Afrika galt lange als günstige Lösung für Europas Energieproblem. Doch eine neue Studie warnt: Ohne Garantien sind die Projekte nicht wettbewerbsfähig. Unter anderem treiben politische Risiken die Kosten in die Höhe.
Mithilfe von Sonnen- und Windkraft hergestellter Wasserstoff aus Afrika galt lange als günstige Lösung für Europas Energieproblem. Doch eine neue Studie warnt: Ohne Garantien sind die Projekte nicht wettbewerbsfähig. Unter anderem treiben politische Risiken die Kosten in die Höhe.
 Kosten in Milliardenhöhe und Aufrüstung im Weltall: Donald Trump träumt von einem gigantischen Raketenabwehrsystem für die USA. Wie realistisch ist das? Einschätzungen von SPIEGEL-Redakteur Christoph Seidler.
Kosten in Milliardenhöhe und Aufrüstung im Weltall: Donald Trump träumt von einem gigantischen Raketenabwehrsystem für die USA. Wie realistisch ist das? Einschätzungen von SPIEGEL-Redakteur Christoph Seidler.
 Donald Trump will sich Amerikas Eliteunis unterwerfen, Harvard leistet erbitterten Widerstand. Hier spricht Protest-Initiator Ryan Enos über den Kampf gegen das Weiße Haus, Angst auf dem Campus – und die Zukunft deutscher Studenten.
Donald Trump will sich Amerikas Eliteunis unterwerfen, Harvard leistet erbitterten Widerstand. Hier spricht Protest-Initiator Ryan Enos über den Kampf gegen das Weiße Haus, Angst auf dem Campus – und die Zukunft deutscher Studenten.
 Kriminelle sollen Steuerrückzahlungen für nichts ahnende Briten angefordert und damit Millionen erbeutet haben. Immerhin versichert die Behörde, dass der Schaden nicht an den Betroffenen hängen bleibt.
Kriminelle sollen Steuerrückzahlungen für nichts ahnende Briten angefordert und damit Millionen erbeutet haben. Immerhin versichert die Behörde, dass der Schaden nicht an den Betroffenen hängen bleibt.
 Seit heute gibt es den lang erwarteten Nachfolger der Konsole Nintendo Switch, dazu erscheint das neue Spiel »Mario Kart World«. Lohnt es sich, für beides 500 Euro auszugeben? Hier die ersten Eindrücke.
Seit heute gibt es den lang erwarteten Nachfolger der Konsole Nintendo Switch, dazu erscheint das neue Spiel »Mario Kart World«. Lohnt es sich, für beides 500 Euro auszugeben? Hier die ersten Eindrücke.
 Obwohl sie nur knapp 60 Euro kosten, klingen die CMF Buds 2 Plus ausgezeichnet und bieten ein effektives adaptives ANC. Dazu sind sie bequem und ausdauernd und bieten in der App Einstellungen, die man sonst nur bei viel teureren Stöpseln erwartet. Verzichtet man auf das Plus, zahlt man sogar nur 50 Euro.
Obwohl sie nur knapp 60 Euro kosten, klingen die CMF Buds 2 Plus ausgezeichnet und bieten ein effektives adaptives ANC. Dazu sind sie bequem und ausdauernd und bieten in der App Einstellungen, die man sonst nur bei viel teureren Stöpseln erwartet. Verzichtet man auf das Plus, zahlt man sogar nur 50 Euro.
 Nashörner sind häufig Ziel von Wilderern, weil sich die Hörner der Tiere in Asien teuer verkaufen lassen. Eine Schutzmaßnahme: das Horn vorsorglich entfernen. Doch es bleiben Zweifel an der Methode.
Nashörner sind häufig Ziel von Wilderern, weil sich die Hörner der Tiere in Asien teuer verkaufen lassen. Eine Schutzmaßnahme: das Horn vorsorglich entfernen. Doch es bleiben Zweifel an der Methode.
 Die private japanische Firma Ispace meldet, dass nach einem Touchdown-Versuch kein Kontakt mehr mit ihrem Mondlander besteht. Als Landeplatz war das »Meer der Kälte« auf dem Erdtrabanten vorgesehen.
Die private japanische Firma Ispace meldet, dass nach einem Touchdown-Versuch kein Kontakt mehr mit ihrem Mondlander besteht. Als Landeplatz war das »Meer der Kälte« auf dem Erdtrabanten vorgesehen.
 Im Streit mit der Trump-Regierung hat die Universität Harvard einen Etappensieg errungen: Eine Bundesrichterin hat Einreiseverbote für ausländische Studierende geblockt, bislang geltende Regeln bleiben vorerst in Kraft.
Im Streit mit der Trump-Regierung hat die Universität Harvard einen Etappensieg errungen: Eine Bundesrichterin hat Einreiseverbote für ausländische Studierende geblockt, bislang geltende Regeln bleiben vorerst in Kraft.
 Bereits zum zweiten Mal geht die Mondlandung des japanischen Unternehmens Ispace schief. Der Vorsprung der US-Unternehmen beim Wettlauf um den Mond wächst.
Bereits zum zweiten Mal geht die Mondlandung des japanischen Unternehmens Ispace schief. Der Vorsprung der US-Unternehmen beim Wettlauf um den Mond wächst.
 Astronomen entdecken bei einem winzigen Zwergstern einen gigantischen Gasplaneten. Die Entdeckung stellt bisherige Modelle der Planetenentstehung infrage. Nun soll das James-Webb-Teleskop Aufklärung bringen.
Astronomen entdecken bei einem winzigen Zwergstern einen gigantischen Gasplaneten. Die Entdeckung stellt bisherige Modelle der Planetenentstehung infrage. Nun soll das James-Webb-Teleskop Aufklärung bringen.
 Vor allem wegen ihrer Brennhaare ist diese Raupe ein Problem: Der Eichenprozessionsspinner ist in immer mehr Bundesländern heimisch. Der Klimawandel begünstigt seine Ausbreitung. Doch eine neue Bekämpfungsmethode zeigt erste Erfolge.
Vor allem wegen ihrer Brennhaare ist diese Raupe ein Problem: Der Eichenprozessionsspinner ist in immer mehr Bundesländern heimisch. Der Klimawandel begünstigt seine Ausbreitung. Doch eine neue Bekämpfungsmethode zeigt erste Erfolge.
 Am 9. Juni beginnt Apples Entwicklerkonferenz WWDC, und wie immer geben Tim Cook & Co. am ersten Tag erste Einblicke in die kommenden Betriebssysteme des Unternehmens. Einiges davon ist schon bekannt, unter anderem soll nicht nur iOS für iPhones ein völlig neues Design erhalten.
Am 9. Juni beginnt Apples Entwicklerkonferenz WWDC, und wie immer geben Tim Cook & Co. am ersten Tag erste Einblicke in die kommenden Betriebssysteme des Unternehmens. Einiges davon ist schon bekannt, unter anderem soll nicht nur iOS für iPhones ein völlig neues Design erhalten.
 Der Jagdverband zählt bereits in mehr als der Hälfte seiner Reviere Nilgänse - die damit die heimischen Graugänse überholt haben. Bei der Gesamtzahl sind Letztere aber noch weit überlegen. Die Jäger wollen die invasive Art trotzdem eindämmen.
Der Jagdverband zählt bereits in mehr als der Hälfte seiner Reviere Nilgänse - die damit die heimischen Graugänse überholt haben. Bei der Gesamtzahl sind Letztere aber noch weit überlegen. Die Jäger wollen die invasive Art trotzdem eindämmen.
 Erst die Mülltonnen, jetzt die Wasserspender: In Sydney machen clevere Vögel den Anwohnern zu schaffen. Sie hebeln Sicherheitsmechanismen aus, indem sie Artgenossen ganz genau beobachten.
Erst die Mülltonnen, jetzt die Wasserspender: In Sydney machen clevere Vögel den Anwohnern zu schaffen. Sie hebeln Sicherheitsmechanismen aus, indem sie Artgenossen ganz genau beobachten.
 Eine Schokoladenkrise droht: Der Kakao kommt mit der Erderwärmung schlecht zurecht. Doch es gibt Hoffnung.
Eine Schokoladenkrise droht: Der Kakao kommt mit der Erderwärmung schlecht zurecht. Doch es gibt Hoffnung.
 US-Präsident Donald Trump zerschlägt Amerikas Meteorologie und Klimaforschung. Schon für die anbrechende Hurrikan-Saison sind die Folgen fatal.
US-Präsident Donald Trump zerschlägt Amerikas Meteorologie und Klimaforschung. Schon für die anbrechende Hurrikan-Saison sind die Folgen fatal.
 Eine Studie von 2023 macht Taurin als mögliches Anti-Aging-Mittel bekannt. Doch eine aktuelle Analyse widerspricht diesen Erkenntnissen. Ist die erneute Hoffnung auf ein Lebenselixier damit verpufft?
Eine Studie von 2023 macht Taurin als mögliches Anti-Aging-Mittel bekannt. Doch eine aktuelle Analyse widerspricht diesen Erkenntnissen. Ist die erneute Hoffnung auf ein Lebenselixier damit verpufft?
 Alarmstufe Rot für die Ozeane: Sie werden wärmer, saurer, dreckiger. Die Teilnehmer der Uno-Ozeankonferenz wollen Lösungen finden. Wie es um die Meere steht, zeigen diese fünf Grafiken.
Alarmstufe Rot für die Ozeane: Sie werden wärmer, saurer, dreckiger. Die Teilnehmer der Uno-Ozeankonferenz wollen Lösungen finden. Wie es um die Meere steht, zeigen diese fünf Grafiken.
 Seit vergangenem Jahr entdecken insbesondere süddeutsche Landwirte vermehrt weiche Kartoffeln. Sie leiden an der Pflanzenkrankheit Stolbur. Auch Zuckerrüben und Gemüse wie Zwiebeln sind befallen. Die Ausbreitung beschert Bauern große Verluste hin zum Totalausfall.
Seit vergangenem Jahr entdecken insbesondere süddeutsche Landwirte vermehrt weiche Kartoffeln. Sie leiden an der Pflanzenkrankheit Stolbur. Auch Zuckerrüben und Gemüse wie Zwiebeln sind befallen. Die Ausbreitung beschert Bauern große Verluste hin zum Totalausfall.
 Gefälschte Nacktfotos von realen Frauen: Unter der dubiosen KI-App Clothoff leiden vor allem junge Mädchen. Nun packt ein Whistleblower über das skrupellose Geschäft aus.
Gefälschte Nacktfotos von realen Frauen: Unter der dubiosen KI-App Clothoff leiden vor allem junge Mädchen. Nun packt ein Whistleblower über das skrupellose Geschäft aus.
 Apple stellt zu Beginn der Entwicklungskonferenz WWDC ein einheitliches Design namens "Liquid Glass" für alle seine Betriebssysteme vor. Dazu kommen einige neue oder verbesserte KI-Funktionen, aber die geplante Siri-Revolution wird auf kommendes Jahr verschoben.
Apple stellt zu Beginn der Entwicklungskonferenz WWDC ein einheitliches Design namens "Liquid Glass" für alle seine Betriebssysteme vor. Dazu kommen einige neue oder verbesserte KI-Funktionen, aber die geplante Siri-Revolution wird auf kommendes Jahr verschoben.
 Im Jahr 1337 ließ Ela Fitzpayne mutmaßlich einen Priester nahe der Londoner St. Paul’s Cathedral erstechen. Es handelte sich um ihre einstige Affäre. Nun haben Forschende die Tat rekonstruiert.
Im Jahr 1337 ließ Ela Fitzpayne mutmaßlich einen Priester nahe der Londoner St. Paul’s Cathedral erstechen. Es handelte sich um ihre einstige Affäre. Nun haben Forschende die Tat rekonstruiert.
 Apple hat am Dienstag Dutzende neue Funktionen für seine Gadgets angekündigt. Wir haben die wichtigsten Veränderungen zusammengestellt – samt solchen, die Apple auf der Bühne gar nicht erwähnte.
Apple hat am Dienstag Dutzende neue Funktionen für seine Gadgets angekündigt. Wir haben die wichtigsten Veränderungen zusammengestellt – samt solchen, die Apple auf der Bühne gar nicht erwähnte.
 Wer auf der Couch zum Beispiel das Topspiel der Bundesliga live sehen will, benötigt ein Abo bei Sky oder dessen Streaming-Schwesterdienst Wow. Letzterer erhöht jetzt die Preise.
Wer auf der Couch zum Beispiel das Topspiel der Bundesliga live sehen will, benötigt ein Abo bei Sky oder dessen Streaming-Schwesterdienst Wow. Letzterer erhöht jetzt die Preise.
 Wenn Apple im September das Update auf iOS 26 verteilt, kommt nicht nur ein stark verändertes Design der Benutzeroberfläche auf iPhones. Die Geräte erhalten auch einige praktische neue Funktionen wie Live-Übersetzungen oder einen intelligenten Anrufbeantworter.
Wenn Apple im September das Update auf iOS 26 verteilt, kommt nicht nur ein stark verändertes Design der Benutzeroberfläche auf iPhones. Die Geräte erhalten auch einige praktische neue Funktionen wie Live-Übersetzungen oder einen intelligenten Anrufbeantworter.
 Wenn Politiker einfacher sprechen, suggerieren sie damit Verbundenheit mit den Bürgern. Politikwissenschaftler Daniel Bischof erklärt, welche Vorteile das hat – und wann es problematisch sein kann.
Wenn Politiker einfacher sprechen, suggerieren sie damit Verbundenheit mit den Bürgern. Politikwissenschaftler Daniel Bischof erklärt, welche Vorteile das hat – und wann es problematisch sein kann.
 Donald Trump und Elon Musk werden als »hysterische Reality-TV-Hausfrauen« verspottet, ihr Streit zum »Zickenkrieg« erklärt. Wie die Meme-Kultur alte Klischees stärkt – und den echten Skandal verdrängt.
Donald Trump und Elon Musk werden als »hysterische Reality-TV-Hausfrauen« verspottet, ihr Streit zum »Zickenkrieg« erklärt. Wie die Meme-Kultur alte Klischees stärkt – und den echten Skandal verdrängt.
 Europäische Politiker drohen mit einer Digitalsteuer, Firmen wollen unabhängiger werden von amerikanischen Techriesen: Wie vergiftet ist das transatlantische Klima? Microsoft-Vize Brad Smith über Sicherheitszusagen und Vertrauen in die USA.
Europäische Politiker drohen mit einer Digitalsteuer, Firmen wollen unabhängiger werden von amerikanischen Techriesen: Wie vergiftet ist das transatlantische Klima? Microsoft-Vize Brad Smith über Sicherheitszusagen und Vertrauen in die USA.
 Juni ist Erdbeerzeit, auch am Nachthimmel. Dort können Schaulustige am Abend mit ein wenig Glück einen rötlichen Mond sehen. Die Färbung ist allerdings nicht der Grund für seinen ungewöhnlichen Namen.
Juni ist Erdbeerzeit, auch am Nachthimmel. Dort können Schaulustige am Abend mit ein wenig Glück einen rötlichen Mond sehen. Die Färbung ist allerdings nicht der Grund für seinen ungewöhnlichen Namen.
 Über die Chancen der Switch 2, an den großen Erfolg des Vorgängergeräts anzuschließen, wurde viel diskutiert. Hersteller Nintendo meldet jetzt Rekordverkäufe.
Über die Chancen der Switch 2, an den großen Erfolg des Vorgängergeräts anzuschließen, wurde viel diskutiert. Hersteller Nintendo meldet jetzt Rekordverkäufe.
 Der menschengemachte Klimawandel treibt die Temperaturen weltweit in die Höhe. In Grönland und Island wirkte sich der überdurchschnittlich warme Mai besonders fatal aus.
Der menschengemachte Klimawandel treibt die Temperaturen weltweit in die Höhe. In Grönland und Island wirkte sich der überdurchschnittlich warme Mai besonders fatal aus.
 Auf Sylt läuft die Jagd auf einen Goldschakal. Weshalb das Tier zum Wohle anderer Schakale sterben muss und warum sich die Tiere in Europa ausbreiten, aber schwer zu finden sind, erklärt der Genetiker Carsten Nowak.
Auf Sylt läuft die Jagd auf einen Goldschakal. Weshalb das Tier zum Wohle anderer Schakale sterben muss und warum sich die Tiere in Europa ausbreiten, aber schwer zu finden sind, erklärt der Genetiker Carsten Nowak.
 Nach den Drohungen der Trump-Regierung gegen die Harvard University lancierte Kulturstaatsminister Wolfram Weimer die Idee, in Deutschland eine Zweigstelle zu gründen. Doch Harvard will davon derzeit nichts wissen.
Nach den Drohungen der Trump-Regierung gegen die Harvard University lancierte Kulturstaatsminister Wolfram Weimer die Idee, in Deutschland eine Zweigstelle zu gründen. Doch Harvard will davon derzeit nichts wissen.
 Mehr Winterstürme, die Inseln des Wattenmeers mit einer Eisschicht bedeckt: Dieses Szenario entwirft eine Studie für Europa, sollte die Atlantische Umwälzzirkulation kollabieren. Auch in Berlin könnte es kalt werden.
Mehr Winterstürme, die Inseln des Wattenmeers mit einer Eisschicht bedeckt: Dieses Szenario entwirft eine Studie für Europa, sollte die Atlantische Umwälzzirkulation kollabieren. Auch in Berlin könnte es kalt werden.
 Ein in der Mongolei entdecktes Fossil wirft ein neues Licht auf die Herkunft des berühmten Tyrannosaurus rex. Forscher bestimmen einen schlanken Raubsaurier aus Asien als seinen Vorfahren. Auch wenn die beiden Arten auf den ersten Blick nur wenig gemeinsam zu haben scheinen.
Ein in der Mongolei entdecktes Fossil wirft ein neues Licht auf die Herkunft des berühmten Tyrannosaurus rex. Forscher bestimmen einen schlanken Raubsaurier aus Asien als seinen Vorfahren. Auch wenn die beiden Arten auf den ersten Blick nur wenig gemeinsam zu haben scheinen.
 Personal Assistants und Privatköchinnen präsentieren auf Social Media, wie die New Yorker Schickeria lebt. Nun nehmen sie ihre Follower sogar mit Richtung Sommerfrische in den Hamptons. Warum ist der Content so beliebt?
Personal Assistants und Privatköchinnen präsentieren auf Social Media, wie die New Yorker Schickeria lebt. Nun nehmen sie ihre Follower sogar mit Richtung Sommerfrische in den Hamptons. Warum ist der Content so beliebt?
 Forscher haben eine neue Dinoart identifiziert – und sich über den Namen viele Gedanken gemacht. Die Entdeckung gibt Hinweise auf die Herkunft des Tyrannosaurus rex.
Forscher haben eine neue Dinoart identifiziert – und sich über den Namen viele Gedanken gemacht. Die Entdeckung gibt Hinweise auf die Herkunft des Tyrannosaurus rex.
 Die US-Einwanderungsbehörde geht hart gegen Menschen vor, die sich ohne gültige Papiere im Land aufhalten. Das hat nun auch der weltweit größte TikTok-Star zu spüren bekommen.
Die US-Einwanderungsbehörde geht hart gegen Menschen vor, die sich ohne gültige Papiere im Land aufhalten. Das hat nun auch der weltweit größte TikTok-Star zu spüren bekommen.
 Die WHO nimmt eine neue Variante des Coronavirus genauer unter die Lupe. In China ist "Nimbus" sogar bereits dominant. Auch in Deutschland gibt es erste Fälle.
Die WHO nimmt eine neue Variante des Coronavirus genauer unter die Lupe. In China ist "Nimbus" sogar bereits dominant. Auch in Deutschland gibt es erste Fälle.
 Seit 1946 entscheidet das Austausch- und Stipendienprogramm Fulbright unabhängig, wer gefördert werden soll. Nun hat die Administration von Donald Trump sich offenbar eingemischt. Der Fulbright-Vorstand hat reagiert.
Seit 1946 entscheidet das Austausch- und Stipendienprogramm Fulbright unabhängig, wer gefördert werden soll. Nun hat die Administration von Donald Trump sich offenbar eingemischt. Der Fulbright-Vorstand hat reagiert.
 Jeder Mensch hat offenbar eine sehr eigene Art, Luft durch die Nase ein- und auszuatmen, berichten Forscher in einer Studie. Sie erhoffen sich von der Erkenntnis unter anderem neue Ansätze zur Therapie von Depressionen.
Jeder Mensch hat offenbar eine sehr eigene Art, Luft durch die Nase ein- und auszuatmen, berichten Forscher in einer Studie. Sie erhoffen sich von der Erkenntnis unter anderem neue Ansätze zur Therapie von Depressionen.
 Zum ersten Mal in der Geschichte gelingen einem Raumfahrzeug Aufnahmen des Südpols der Sonne. Die Bilder der Sonde "Solar Orbiter" könnten helfen, das Magnetfeld der Sonne besser zu verstehen. Die Aufnahmen zeigen, wie sehr es sich von dem der Erde unterscheidet.
Zum ersten Mal in der Geschichte gelingen einem Raumfahrzeug Aufnahmen des Südpols der Sonne. Die Bilder der Sonde "Solar Orbiter" könnten helfen, das Magnetfeld der Sonne besser zu verstehen. Die Aufnahmen zeigen, wie sehr es sich von dem der Erde unterscheidet.
 Zahlreiche Nutzer weltweit registrierten Störungen bei der Google-Cloud und anderen cloudbasierten Diensten. Die Ursache wurde offenbar gefunden.
Zahlreiche Nutzer weltweit registrierten Störungen bei der Google-Cloud und anderen cloudbasierten Diensten. Die Ursache wurde offenbar gefunden.
 Schuppentiere werden häufiger gewildert als Nashörner, Elefanten und Tiger zusammen. Bisher wurde angenommen, dass sie wegen der angeblich heilenden Kräfte ihrer Schuppen gejagt werden. Laut einer Studie ist dem nicht so.
Schuppentiere werden häufiger gewildert als Nashörner, Elefanten und Tiger zusammen. Bisher wurde angenommen, dass sie wegen der angeblich heilenden Kräfte ihrer Schuppen gejagt werden. Laut einer Studie ist dem nicht so.
 In »F1 The Movie« mit Brad Pitt geht es ohnehin schon rasant zu. Um den Film auf ungewöhnliche Weise zu bewerben, greift Apple zu einem Trick, der die Action fühlbar macht.
In »F1 The Movie« mit Brad Pitt geht es ohnehin schon rasant zu. Um den Film auf ungewöhnliche Weise zu bewerben, greift Apple zu einem Trick, der die Action fühlbar macht.
 Ein Ingenieur lässt ChatGPT gegen die Schach-Engine eines Atari 2600 aus dem Jahr 1977 antreten. Das Sprachmodell liefert dabei desolate Leistungen ab und verliert haushoch. Der Versuch zeigt die Grenzen der heute omnipräsenten KI-Chatbots auf.
Ein Ingenieur lässt ChatGPT gegen die Schach-Engine eines Atari 2600 aus dem Jahr 1977 antreten. Das Sprachmodell liefert dabei desolate Leistungen ab und verliert haushoch. Der Versuch zeigt die Grenzen der heute omnipräsenten KI-Chatbots auf.
 Wenn von Chips die Rede ist, sind immer häufiger Kombinationen von Chiplets gemeint. Das sind Mini-Module, die sich wie Legosteine zusammensetzen lassen und so flexibler, leistungsfähiger und effizienter als ein monolithisches System sind. Das macht sie unter anderem für die automobile Zukunft unersetzlich.
Wenn von Chips die Rede ist, sind immer häufiger Kombinationen von Chiplets gemeint. Das sind Mini-Module, die sich wie Legosteine zusammensetzen lassen und so flexibler, leistungsfähiger und effizienter als ein monolithisches System sind. Das macht sie unter anderem für die automobile Zukunft unersetzlich.
 Iran steht seit Jahren im Verdacht, verstärkt Uran anzureichern. Die Führung will nun eine dritte Anlage dafür bauen. Was fehlt ihr noch für die Fertigung von Atomwaffen?
Iran steht seit Jahren im Verdacht, verstärkt Uran anzureichern. Die Führung will nun eine dritte Anlage dafür bauen. Was fehlt ihr noch für die Fertigung von Atomwaffen?
 Im Südpolarmeer gelingt eine spektakuläre Premiere: Erstmals wird ein seltener Tiefsee-Tintenfisch lebend gefilmt. Die Aufnahmen geben Rätsel auf – und könnten unser Wissen über die Ozeane revolutionieren.
Im Südpolarmeer gelingt eine spektakuläre Premiere: Erstmals wird ein seltener Tiefsee-Tintenfisch lebend gefilmt. Die Aufnahmen geben Rätsel auf – und könnten unser Wissen über die Ozeane revolutionieren.
 Nach den schweren Attacken auf Irans Atomanlagen warnen Experten vor möglichen Folgen für Mensch und Umwelt. Die wichtige Anlage in Natans soll schwer beschädigt worden sein. Welche radioaktiven Gefahren gehen von ihr aus?
Nach den schweren Attacken auf Irans Atomanlagen warnen Experten vor möglichen Folgen für Mensch und Umwelt. Die wichtige Anlage in Natans soll schwer beschädigt worden sein. Welche radioaktiven Gefahren gehen von ihr aus?
 Alle 242 Menschen an Bord von Air India Flug 171 sind tot, nur ein Passagier überlebte: Vishwash Kumar Ramesh saß auf Platz 11A und es war nicht nur Zufall, dass er sich retten konnte.
Alle 242 Menschen an Bord von Air India Flug 171 sind tot, nur ein Passagier überlebte: Vishwash Kumar Ramesh saß auf Platz 11A und es war nicht nur Zufall, dass er sich retten konnte.
 Stiftung Warentest prüft 14 neue Smartphones, unter ihnen starke Mittelklasse-Geräte, die Top-Platzierungen unter den besten Smartphones bis 400 Euro einnehmen. Der besonders günstige Spitzenreiter in dieser Liste verteidigt aber seine Position, was auch seinen noch besseren Nachfolger interessant macht.
Stiftung Warentest prüft 14 neue Smartphones, unter ihnen starke Mittelklasse-Geräte, die Top-Platzierungen unter den besten Smartphones bis 400 Euro einnehmen. Der besonders günstige Spitzenreiter in dieser Liste verteidigt aber seine Position, was auch seinen noch besseren Nachfolger interessant macht.
 Hochseegebiete, Plastikmüll, Tiefseebergbau: Auf der Uno-Ozeankonferenz konnten einige Fortschritte beim Meeresschutz erzielt werden. Umweltorganisationen mahnen, die Zusagen schnell umzusetzen.
Hochseegebiete, Plastikmüll, Tiefseebergbau: Auf der Uno-Ozeankonferenz konnten einige Fortschritte beim Meeresschutz erzielt werden. Umweltorganisationen mahnen, die Zusagen schnell umzusetzen.
 Am Colaglas, auf dem Grillteller oder dem Kuchen: Wespen sind im Sommer unangenehme Begleiter. Wie halte ich sie mir vom Leib? Was tue ich mit einem Wespennest, und wie behandle ich einen Stich? Fragen und Antworten.
Am Colaglas, auf dem Grillteller oder dem Kuchen: Wespen sind im Sommer unangenehme Begleiter. Wie halte ich sie mir vom Leib? Was tue ich mit einem Wespennest, und wie behandle ich einen Stich? Fragen und Antworten.
 Viele Promis schwören auf die Abnehmwirkung des Diabetesmedikament Ozempic. Doch die Liste der möglichen Nebenwirkungen der "Abnehmspritze" ist lang. Zwei Diabetologen ordnen den Hype für ntv.de ein.
Viele Promis schwören auf die Abnehmwirkung des Diabetesmedikament Ozempic. Doch die Liste der möglichen Nebenwirkungen der "Abnehmspritze" ist lang. Zwei Diabetologen ordnen den Hype für ntv.de ein.
 Fast alle 242 Menschen an Bord von Air-India-Flug 171 sind gestorben, nur ein Passagier überlebte: Vishwash Kumar Ramesh saß auf Platz 11A, und es war nicht nur Zufall, dass er sich retten konnte.
Fast alle 242 Menschen an Bord von Air-India-Flug 171 sind gestorben, nur ein Passagier überlebte: Vishwash Kumar Ramesh saß auf Platz 11A, und es war nicht nur Zufall, dass er sich retten konnte.
 Israel hat Irans Atom-Anreicherungsanlagen mitunter beschädigt. Das Vorgehen sei aggressiv und hochriskant gewesen, sagt Jim Walsh, der zu Atomwaffenprogrammen am MIT forscht. Wie geht es im Nahen Osten weiter?
Israel hat Irans Atom-Anreicherungsanlagen mitunter beschädigt. Das Vorgehen sei aggressiv und hochriskant gewesen, sagt Jim Walsh, der zu Atomwaffenprogrammen am MIT forscht. Wie geht es im Nahen Osten weiter?
 Virologen schlagen Alarm. Müdigkeit, Fieber, Muskelschmerzen und Halsschmerzen sind die Symptome eines neuen Corona-Stamms namens Nimbus. Warmes Wetter soll einem Bericht zufolge seine Ausbreitung begünstigen. Experten erwarten einen hohen Anstieg der Fälle.
Virologen schlagen Alarm. Müdigkeit, Fieber, Muskelschmerzen und Halsschmerzen sind die Symptome eines neuen Corona-Stamms namens Nimbus. Warmes Wetter soll einem Bericht zufolge seine Ausbreitung begünstigen. Experten erwarten einen hohen Anstieg der Fälle.
 Wer einen Maulwurf im Garten hat, darf sich freuen: Der Boden wird gut durchgelüftet. Trotzdem möchten manche die Tiere loswerden. Doch viele Tipps sind unbrauchbar, manche können richtig teuer werden.
Wer einen Maulwurf im Garten hat, darf sich freuen: Der Boden wird gut durchgelüftet. Trotzdem möchten manche die Tiere loswerden. Doch viele Tipps sind unbrauchbar, manche können richtig teuer werden.
 Auch dienstliche E-Mails sollen betroffen sein: Bei der »Washington Post« hat es nach Medienberichten einen Hackerangriff gegeben. Die Spur könnte nach China führen.
Auch dienstliche E-Mails sollen betroffen sein: Bei der »Washington Post« hat es nach Medienberichten einen Hackerangriff gegeben. Die Spur könnte nach China führen.
 Im Frühjahr galt Asteroid 2024 YR4 noch als mögliche Gefahr für die Erde. Das ist passé - aber nun wird eine erhöhte Wahrscheinlichkeit berechnet, dass der 60-Meter-Brocken im Jahr 2032 den Mond trifft. Ob es wirklich dazu kommt, werden wir laut Nasa wohl erst in ein paar Jahren wissen.
Im Frühjahr galt Asteroid 2024 YR4 noch als mögliche Gefahr für die Erde. Das ist passé - aber nun wird eine erhöhte Wahrscheinlichkeit berechnet, dass der 60-Meter-Brocken im Jahr 2032 den Mond trifft. Ob es wirklich dazu kommt, werden wir laut Nasa wohl erst in ein paar Jahren wissen.
 Regnet es in Regionen über Jahre zu wenig, droht nachhaltige Trockenheit. Einer Studie zufolge steht die Hälfte aller Landkreise bereits unter "Wasserstress", entnimmt also mehr Wasser, als durch Niederschläge hinzukommt. In knapp einem Viertel der Regionen sinkt der Grundwasserspiegel bereits "signifikant".
Regnet es in Regionen über Jahre zu wenig, droht nachhaltige Trockenheit. Einer Studie zufolge steht die Hälfte aller Landkreise bereits unter "Wasserstress", entnimmt also mehr Wasser, als durch Niederschläge hinzukommt. In knapp einem Viertel der Regionen sinkt der Grundwasserspiegel bereits "signifikant".
 Ein Deutscher soll aus Spanien heraus eine der wichtigsten Drogenplattformen des Darknets gesteuert haben. Nun ist er in Barcelona verhaftet worden. Die deutsche Polizei feiert die Aktion mit einem Netflix-reifen Video.
Ein Deutscher soll aus Spanien heraus eine der wichtigsten Drogenplattformen des Darknets gesteuert haben. Nun ist er in Barcelona verhaftet worden. Die deutsche Polizei feiert die Aktion mit einem Netflix-reifen Video.
 Chronische, also andauernde Rückenschmerzen plagen viele. In Deutschland leidet etwa jeder Sechste daran. Dabei gibt es ein simples Mittel dagegen: Spaziergänge. Einer großen Studie aus Norwegen zufolge hilft Gehen und senkt das Schmerzrisiko deutlich - dabei ist auch die Länge entscheidend.
Chronische, also andauernde Rückenschmerzen plagen viele. In Deutschland leidet etwa jeder Sechste daran. Dabei gibt es ein simples Mittel dagegen: Spaziergänge. Einer großen Studie aus Norwegen zufolge hilft Gehen und senkt das Schmerzrisiko deutlich - dabei ist auch die Länge entscheidend.
 Forschende nutzten GPS, um die Flüge von 18 Tieren über mehrere Monate zu verfolgen. In den aufgezeichneten Daten stießen sie auf eine besondere Leistung. Als Rekordhalter gilt aber eine andere Vogelart.
Forschende nutzten GPS, um die Flüge von 18 Tieren über mehrere Monate zu verfolgen. In den aufgezeichneten Daten stießen sie auf eine besondere Leistung. Als Rekordhalter gilt aber eine andere Vogelart.
 »Keine Werbung!« gehörte einst zum Mantra der WhatsApp-Gründer. Jetzt kündigt der Messenger die Einführung von Anzeigen an. Chats sollen aber werbefrei bleiben. Und noch etwas verspricht Firmenchef Will Cathcart.
»Keine Werbung!« gehörte einst zum Mantra der WhatsApp-Gründer. Jetzt kündigt der Messenger die Einführung von Anzeigen an. Chats sollen aber werbefrei bleiben. Und noch etwas verspricht Firmenchef Will Cathcart.
 Das Misstrauen vor amerikanischer Technikabhängigkeit wächst. Microsoft-Chef Satya Nadella stellte nun neue Möglichkeiten vor, wie EU-Unternehmen ihre Daten vor der Regierung Trump schützen können.
Das Misstrauen vor amerikanischer Technikabhängigkeit wächst. Microsoft-Chef Satya Nadella stellte nun neue Möglichkeiten vor, wie EU-Unternehmen ihre Daten vor der Regierung Trump schützen können.
 Eine Studie zeigt, wie künstliches Licht und höhere Temperaturen in Städten die Wachstumszeiten von Pflanzen beeinflussen. Der Frühling beginnt früher und der Herbst dauert länger. Die Umstellung auf neue LED-Technologien könnte ebenfalls einen Einfluss haben.
Eine Studie zeigt, wie künstliches Licht und höhere Temperaturen in Städten die Wachstumszeiten von Pflanzen beeinflussen. Der Frühling beginnt früher und der Herbst dauert länger. Die Umstellung auf neue LED-Technologien könnte ebenfalls einen Einfluss haben.
 Die europäische Sonde "Proba-3" erzeugt durch einen Formationsflug eine künstliche Sonnenfinsternis, mit deren Hilfe Fotos der Sonnenkorona geschossen werden können. Die Beobachtungen sollen helfen, ein großes Rätsel der Sonne zu lösen.
Die europäische Sonde "Proba-3" erzeugt durch einen Formationsflug eine künstliche Sonnenfinsternis, mit deren Hilfe Fotos der Sonnenkorona geschossen werden können. Die Beobachtungen sollen helfen, ein großes Rätsel der Sonne zu lösen.
 Der Sony Reon Pocket 5 Pro ist eine tragbare Klimaanlage, die den Nacken kühlen soll, ohne ihn steif zu machen. Im Praxistest funktioniert das überraschend gut und angenehm. Obendrein ist das Gerät auch im Winter nützlich - und fällt da unter dicken Jacken auch weniger auf.
Der Sony Reon Pocket 5 Pro ist eine tragbare Klimaanlage, die den Nacken kühlen soll, ohne ihn steif zu machen. Im Praxistest funktioniert das überraschend gut und angenehm. Obendrein ist das Gerät auch im Winter nützlich - und fällt da unter dicken Jacken auch weniger auf.
 Nach den Angriffen Israels auf Irans Atomanlagen sind Strahlenschutzexperten vergleichsweise ruhig. Und doch könnten die Attacken am Ende brandgefährlich sein.
Nach den Angriffen Israels auf Irans Atomanlagen sind Strahlenschutzexperten vergleichsweise ruhig. Und doch könnten die Attacken am Ende brandgefährlich sein.
 Vor etwa 13.000 Jahren haben sich Bettwanzen, die bevorzugt menschliches Blut tranken, schlagartig vermehrt. Forscher vermuten, dass die Parasiten von einer grundlegend neuen Lebensweise ihrer Opfer profitierten.
Vor etwa 13.000 Jahren haben sich Bettwanzen, die bevorzugt menschliches Blut tranken, schlagartig vermehrt. Forscher vermuten, dass die Parasiten von einer grundlegend neuen Lebensweise ihrer Opfer profitierten.
 Aktuell werden in Deutschland jährlich mehr als 2000 Nieren transplantiert. Doch auf der Warteliste des Landes stehen mehr als 6000 Personen - nicht alle überleben die langen Wartezeiten.
Aktuell werden in Deutschland jährlich mehr als 2000 Nieren transplantiert. Doch auf der Warteliste des Landes stehen mehr als 6000 Personen - nicht alle überleben die langen Wartezeiten.
 Die Art steht als gefährdet auf der Roten Liste, doch in den Sümpfen Floridas gilt der Dunkle Tigerpython als Gefahr für die Vielfalt anderer Tiere. Umweltschützer melden nun einen Fortschritt im Kampf gegen die Reptilien.
Die Art steht als gefährdet auf der Roten Liste, doch in den Sümpfen Floridas gilt der Dunkle Tigerpython als Gefahr für die Vielfalt anderer Tiere. Umweltschützer melden nun einen Fortschritt im Kampf gegen die Reptilien.
 Tausende Gemälde verstauben in Museen, sie zu restaurieren würde Jahre dauern. Nun hat ein Ingenieur ein Bild mit KI ausgebessert – in Rekordzeit. Was bedeutet das für ein Handwerk, das sonst auf Pinsel und Geduld setzt?
Tausende Gemälde verstauben in Museen, sie zu restaurieren würde Jahre dauern. Nun hat ein Ingenieur ein Bild mit KI ausgebessert – in Rekordzeit. Was bedeutet das für ein Handwerk, das sonst auf Pinsel und Geduld setzt?
 Auf ausreichend Wasser können sich die Menschen nicht mehr verlassen, warnen Experten. Laut einem neuen Bericht kämpfen immer mehr Weltregionen mit extremer Trockenheit. Auch in Deutschland fehlt Regen.
Auf ausreichend Wasser können sich die Menschen nicht mehr verlassen, warnen Experten. Laut einem neuen Bericht kämpfen immer mehr Weltregionen mit extremer Trockenheit. Auch in Deutschland fehlt Regen.
 Nach der Katastrophe von Blatten fürchtet ein weiterer Schweizer Ort einen Bergrutsch. Die Bewohner von Brienz mussten ihre Häuser schon vor Monaten verlassen, dürfen das Gebiet nun aber gar nicht mehr betreten.
Nach der Katastrophe von Blatten fürchtet ein weiterer Schweizer Ort einen Bergrutsch. Die Bewohner von Brienz mussten ihre Häuser schon vor Monaten verlassen, dürfen das Gebiet nun aber gar nicht mehr betreten.
 Bei einem Test von 19 Antivirus-Programmen für Windows 11 schützen elf zuverlässig vor Bedrohungen, ohne zu viele Fehlalarme auszulösen. Unter ihnen sind auch zwei Gratis-Lösungen, von denen eine nicht einmal mit Werbung nervt.
Bei einem Test von 19 Antivirus-Programmen für Windows 11 schützen elf zuverlässig vor Bedrohungen, ohne zu viele Fehlalarme auszulösen. Unter ihnen sind auch zwei Gratis-Lösungen, von denen eine nicht einmal mit Werbung nervt.
 Vom weltweiten Artensterben sind auch große Aasfresser wie Geier, Bären und Haie betroffen. Das hat zum Teil schwerwiegende Folgen, auch für die Gesundheit der Menschen. Ein Forschungsteam warnt davor - und liefert gleich noch eine Reihe von Lösungsansätzen.
Vom weltweiten Artensterben sind auch große Aasfresser wie Geier, Bären und Haie betroffen. Das hat zum Teil schwerwiegende Folgen, auch für die Gesundheit der Menschen. Ein Forschungsteam warnt davor - und liefert gleich noch eine Reihe von Lösungsansätzen.
 Wer für ein gutes Smartphone weniger als 250 Euro ausgeben möchte, findet bei Stiftung Warentest immerhin acht aktuelle Geräte in dieser Preisklasse. Kompromisse muss man allerdings eingehen, kleinere Schwächen haben alle aufgelisteten Handys.
Wer für ein gutes Smartphone weniger als 250 Euro ausgeben möchte, findet bei Stiftung Warentest immerhin acht aktuelle Geräte in dieser Preisklasse. Kompromisse muss man allerdings eingehen, kleinere Schwächen haben alle aufgelisteten Handys.
 Wie benutzt man einen Pömpel oder wäscht die Wäsche richtig? Eine Uni in Kanada gibt Studierenden Tipps für den Haushalt. Studienkoordinatorin Pam Charbonneau erklärt, warum das auch eine psychologische Funktion erfüllt.
Wie benutzt man einen Pömpel oder wäscht die Wäsche richtig? Eine Uni in Kanada gibt Studierenden Tipps für den Haushalt. Studienkoordinatorin Pam Charbonneau erklärt, warum das auch eine psychologische Funktion erfüllt.
 Die Trump-Familie kündigt einen eigenen Mobilfunktarif und ein Trump-Handy an, das in den USA hergestellt werden soll. Was steckt dahinter? Und geht das überhaupt?
Die Trump-Familie kündigt einen eigenen Mobilfunktarif und ein Trump-Handy an, das in den USA hergestellt werden soll. Was steckt dahinter? Und geht das überhaupt?
 Gewissheit über die Ursache für den Absturz von Flug 171 in Indien werden erst genaue Untersuchungen bringen. Doch Videoaufnahmen legen schon jetzt nahe, dass im Cockpit etwas schiefgegangen sein könnte.
Gewissheit über die Ursache für den Absturz von Flug 171 in Indien werden erst genaue Untersuchungen bringen. Doch Videoaufnahmen legen schon jetzt nahe, dass im Cockpit etwas schiefgegangen sein könnte.
 Jeder Mensch hat offenbar eine sehr eigene Art, Luft durch die Nase ein- und auszuatmen, berichten Forscher in einer Studie. Sie erhoffen sich von der Erkenntnis unter anderem neue Ansätze zur Therapie von Depressionen.
Jeder Mensch hat offenbar eine sehr eigene Art, Luft durch die Nase ein- und auszuatmen, berichten Forscher in einer Studie. Sie erhoffen sich von der Erkenntnis unter anderem neue Ansätze zur Therapie von Depressionen.
 TikTok soll in den USA verkauft oder abgeschaltet werden. Doch der US-Präsident will laut seiner Sprecherin nicht, dass die App »von der Bildfläche verschwindet«. Er werde ein entsprechendes Dekret unterzeichnen.
TikTok soll in den USA verkauft oder abgeschaltet werden. Doch der US-Präsident will laut seiner Sprecherin nicht, dass die App »von der Bildfläche verschwindet«. Er werde ein entsprechendes Dekret unterzeichnen.
 Erst vor wenigen Monaten wurde in Iran ein WhatsApp-Verbot aufgehoben. Doch jetzt, im Krieg mit Israel, sieht die Regierung die App offenbar wieder skeptisch. Zugleich drosselt sie das Internet.
Erst vor wenigen Monaten wurde in Iran ein WhatsApp-Verbot aufgehoben. Doch jetzt, im Krieg mit Israel, sieht die Regierung die App offenbar wieder skeptisch. Zugleich drosselt sie das Internet.
 Der SPIEGEL hatte kürzlich über einen 20-Jährigen berichtet, der Teil einer gewaltverherrlichenden Online-Szene sein soll. Nun verkündete die Hamburger Polizei, ihn des Mordes an einem Kind zu beschuldigen.
Der SPIEGEL hatte kürzlich über einen 20-Jährigen berichtet, der Teil einer gewaltverherrlichenden Online-Szene sein soll. Nun verkündete die Hamburger Polizei, ihn des Mordes an einem Kind zu beschuldigen.
 Erst Russland gegen die Ukraine, nun Israel gegen Iran: Wegen der Kriege sperren Staaten ihre Lufträume. Das bedeutet, dass Passagierjets gewaltige und teils skurrile Umwege fliegen müssen – wie etwa eine Finnair-Maschine.
Erst Russland gegen die Ukraine, nun Israel gegen Iran: Wegen der Kriege sperren Staaten ihre Lufträume. Das bedeutet, dass Passagierjets gewaltige und teils skurrile Umwege fliegen müssen – wie etwa eine Finnair-Maschine.
 Der SPIEGEL hatte kürzlich über einen 20-Jährigen berichtet, der Teil einer gewaltverherrlichenden Onlineszene sein soll. Nun verkündete die Hamburger Polizei, ihn des Mordes an einem Kind zu beschuldigen.
Der SPIEGEL hatte kürzlich über einen 20-Jährigen berichtet, der Teil einer gewaltverherrlichenden Onlineszene sein soll. Nun verkündete die Hamburger Polizei, ihn des Mordes an einem Kind zu beschuldigen.
 Über schwimmende Plattformen sollen gefährliche Munitionsreste aus der Ostsee entfernt werden. Das Projekt ist ambitioniert, aus Sicht von Experten aber machbar. Fehlt nur noch das Geld.
Über schwimmende Plattformen sollen gefährliche Munitionsreste aus der Ostsee entfernt werden. Das Projekt ist ambitioniert, aus Sicht von Experten aber machbar. Fehlt nur noch das Geld.
 Ein erneuter Ausbruch des Lewotobi Laki-Laki auf der Insel Flores sorgt für Unruhe in Indonesien. Wegen der gewaltigen Aschewolke ist der Flugverkehr gestört, auch auf der Nachbarinsel Bali. Tausende Passagiere sind betroffen.
Ein erneuter Ausbruch des Lewotobi Laki-Laki auf der Insel Flores sorgt für Unruhe in Indonesien. Wegen der gewaltigen Aschewolke ist der Flugverkehr gestört, auch auf der Nachbarinsel Bali. Tausende Passagiere sind betroffen.
 Fantasy-Fossilie: In den USA wird eine neue Echsenart aus der späten Kreidezeit entdeckt. Das "kleine Monster", wie die Forscher es nennen, hat einen Kopfpanzer und spitze Zähne und erinnert sie an Goblins. Darum bekommt der Räuber einen Namen aus Tolkiens "Hobbit".
Fantasy-Fossilie: In den USA wird eine neue Echsenart aus der späten Kreidezeit entdeckt. Das "kleine Monster", wie die Forscher es nennen, hat einen Kopfpanzer und spitze Zähne und erinnert sie an Goblins. Darum bekommt der Räuber einen Namen aus Tolkiens "Hobbit".
 Nach dem Absturz von Flug 171 gibt es Hinweise, dass die Piloten das Notstromsystem der Maschine aktiviert haben könnten. Luftfahrtexperte Jens Friedrichs erklärt, was das über die mögliche Ursache des Unglücks aussagt.
Nach dem Absturz von Flug 171 gibt es Hinweise, dass die Piloten das Notstromsystem der Maschine aktiviert haben könnten. Luftfahrtexperte Jens Friedrichs erklärt, was das über die mögliche Ursache des Unglücks aussagt.
 Täter, die sich das Vertrauen von Kindern und Jugendlichen erschleichen, um sie zu Straftaten oder Selbstverletzungen zu drängen? Was schrecklich klingt, ist ein ernst zu nehmendes Onlinephänomen.
Täter, die sich das Vertrauen von Kindern und Jugendlichen erschleichen, um sie zu Straftaten oder Selbstverletzungen zu drängen? Was schrecklich klingt, ist ein ernst zu nehmendes Onlinephänomen.
 Vor dem Landgericht Koblenz stritten Auftraggeber und Kunde um die Bezahlung für den Bau eines Gartenzauns. Das Geld hatten Onlinebetrüger abgezweigt. Beide Seiten hatten es den Kriminellen zu einfach gemacht.
Vor dem Landgericht Koblenz stritten Auftraggeber und Kunde um die Bezahlung für den Bau eines Gartenzauns. Das Geld hatten Onlinebetrüger abgezweigt. Beide Seiten hatten es den Kriminellen zu einfach gemacht.
 Im Süden Utahs haben Paläontologen eine neue Echsenart aus der späten Kreidezeit identifiziert. Das Tier besaß einen Kopfpanzer, spitze Zähne und trägt nun den Namen Bolg aus dem Fantasy-Klassiker »Der Hobbit«.
Im Süden Utahs haben Paläontologen eine neue Echsenart aus der späten Kreidezeit identifiziert. Das Tier besaß einen Kopfpanzer, spitze Zähne und trägt nun den Namen Bolg aus dem Fantasy-Klassiker »Der Hobbit«.
 Die Ecoflow Wave 3 ist eine der wenigen mobilen Klimaanlagen, die zwei Schläuche hat. Im Praxistest beweist sie, dass sie Wohnmobile, Gartenlauben oder kleine Räume unter den richtigen Voraussetzungen effektiv kühlen kann. Mit fest installierten Geräten kann sie allerdings nicht konkurrieren.
Die Ecoflow Wave 3 ist eine der wenigen mobilen Klimaanlagen, die zwei Schläuche hat. Im Praxistest beweist sie, dass sie Wohnmobile, Gartenlauben oder kleine Räume unter den richtigen Voraussetzungen effektiv kühlen kann. Mit fest installierten Geräten kann sie allerdings nicht konkurrieren.
 Wassermangel setzt Pflanzen, Tiere und Menschen unter großen Stress. Der Klimawandel verschärft die Lage auch in Deutschland. Doch SPIEGEL-Redakteurin Susanne Götze weiß, was bei Dürren hilft.
Wassermangel setzt Pflanzen, Tiere und Menschen unter großen Stress. Der Klimawandel verschärft die Lage auch in Deutschland. Doch SPIEGEL-Redakteurin Susanne Götze weiß, was bei Dürren hilft.
 Was aussieht wie ein Kunstwerk, ist tatsächlich ein aus riesigen Datenmengen zusammengesetztes Abbild einer Galaxie. Die opulente Optik aus dem Sternbild Sculptor soll Astronomen helfen, Neues im All zu finden.
Was aussieht wie ein Kunstwerk, ist tatsächlich ein aus riesigen Datenmengen zusammengesetztes Abbild einer Galaxie. Die opulente Optik aus dem Sternbild Sculptor soll Astronomen helfen, Neues im All zu finden.
 In »F1 The Movie« mit Brad Pitt geht es ohnehin schon rasant zu. Um den Film auf ungewöhnliche Weise zu bewerben, greift Apple zu einem Trick, der die Action fühlbar macht.
In »F1 The Movie« mit Brad Pitt geht es ohnehin schon rasant zu. Um den Film auf ungewöhnliche Weise zu bewerben, greift Apple zu einem Trick, der die Action fühlbar macht.
 Im Südpolarmeer gelingt eine spektakuläre Premiere: Erstmals wird ein seltener Tiefsee-Tintenfisch lebend gefilmt. Die Aufnahmen geben Rätsel auf – und könnten unser Wissen über die Ozeane revolutionieren.
Im Südpolarmeer gelingt eine spektakuläre Premiere: Erstmals wird ein seltener Tiefsee-Tintenfisch lebend gefilmt. Die Aufnahmen geben Rätsel auf – und könnten unser Wissen über die Ozeane revolutionieren.
 Fachleute sind sich einig: Die Zeit drängt, denn die Altmunition, die in Nord- und Ostsee liegt, ist gefährlich. Wie brisant die beträchtlichen Mengen an Granaten, Torpedos, Bomben, Minen und Patronen sind, versteht auch die Bundesregierung und stellt Geld zur Bergung zur Verfügung.
Fachleute sind sich einig: Die Zeit drängt, denn die Altmunition, die in Nord- und Ostsee liegt, ist gefährlich. Wie brisant die beträchtlichen Mengen an Granaten, Torpedos, Bomben, Minen und Patronen sind, versteht auch die Bundesregierung und stellt Geld zur Bergung zur Verfügung.
 Soll die Erderwärmung wie in Paris vereinbart auf 1,5 Grad beschränkt werden, müssen die Anstrengungen deutlich hochgeschraubt werden. Denn das dafür verbleibende Kontingent an Emissionen schrumpft rapide, betonen Wissenschaftler nun. Macht die Welt weiter wie bisher, ist es bald aufgebraucht.
Soll die Erderwärmung wie in Paris vereinbart auf 1,5 Grad beschränkt werden, müssen die Anstrengungen deutlich hochgeschraubt werden. Denn das dafür verbleibende Kontingent an Emissionen schrumpft rapide, betonen Wissenschaftler nun. Macht die Welt weiter wie bisher, ist es bald aufgebraucht.
 Eigentlich sollte die Starship 36 von SpaceX bald ihren zehnten Testflug starten. Dazu wird es jedoch nicht mehr kommen: Die Rakete explodiert noch am Boden. Es ist bereits der zweite Rückschlag innerhalb kurzer Zeit für das Raumfahrtunternehmen von Elon Musk.
Eigentlich sollte die Starship 36 von SpaceX bald ihren zehnten Testflug starten. Dazu wird es jedoch nicht mehr kommen: Die Rakete explodiert noch am Boden. Es ist bereits der zweite Rückschlag innerhalb kurzer Zeit für das Raumfahrtunternehmen von Elon Musk.
 Ein Starship von SpaceX ist am Mittwoch in den USA in Rauch aufgegangen. Dieses Mal explodierte die Riesenrakete bereits vor dem Start, laut dem Raumfahrtunternehmen eine »schwerwiegende Anomalie«.
Ein Starship von SpaceX ist am Mittwoch in den USA in Rauch aufgegangen. Dieses Mal explodierte die Riesenrakete bereits vor dem Start, laut dem Raumfahrtunternehmen eine »schwerwiegende Anomalie«.
 Beziehungszufriedenheit wird aus wissenschaftlicher Sicht bisher nur langfristig betrachtet. Doch ein Team der Uni Mainz schaut sich diese auch in unterschiedlichen Abschnitten eines Tages an und entdeckt Schwankungen, die aber nichts über die Qualität der Beziehung aussagen müssen.
Beziehungszufriedenheit wird aus wissenschaftlicher Sicht bisher nur langfristig betrachtet. Doch ein Team der Uni Mainz schaut sich diese auch in unterschiedlichen Abschnitten eines Tages an und entdeckt Schwankungen, die aber nichts über die Qualität der Beziehung aussagen müssen.
 Wenn die Erderwärmung bei 1,5 Grad gestoppt werden soll, müssen die CO₂-Emissionen aus fossilen Brennstoffen massiv heruntergefahren werden. Eine aktuelle Berechnung zeigt, dass dafür nicht mehr viel Zeit bleibt.
Wenn die Erderwärmung bei 1,5 Grad gestoppt werden soll, müssen die CO₂-Emissionen aus fossilen Brennstoffen massiv heruntergefahren werden. Eine aktuelle Berechnung zeigt, dass dafür nicht mehr viel Zeit bleibt.
 Beachtliche Mengen der sichtbaren Materie, aus der etwa Sterne und Planeten bestehen, konnten Forschende bisher nicht im All beobachten. Jetzt wollen sie die Stoffe in zehn Millionen Grad heißem Gas entdeckt haben.
Beachtliche Mengen der sichtbaren Materie, aus der etwa Sterne und Planeten bestehen, konnten Forschende bisher nicht im All beobachten. Jetzt wollen sie die Stoffe in zehn Millionen Grad heißem Gas entdeckt haben.
 Der treffsicherste Apple-Kenner erwartet, dass die Vorbereitungen für ein faltbares iPhone noch in diesem Jahr beginnen. 2026 sollen erste Geräte auf den Markt kommen. Der Analyst nennt zwei bekannte involvierte Hersteller, stellt aber fest, dass es noch viele offene Fragen gibt.
Der treffsicherste Apple-Kenner erwartet, dass die Vorbereitungen für ein faltbares iPhone noch in diesem Jahr beginnen. 2026 sollen erste Geräte auf den Markt kommen. Der Analyst nennt zwei bekannte involvierte Hersteller, stellt aber fest, dass es noch viele offene Fragen gibt.
 Grüneres Grün, blaueres Blau: Die Farbe unserer Ozeane verändert sich laut einer aktuellen Studie. Der Wandel könnte die Tierwelt und die Fischerei weltweit beeinflussen.
Grüneres Grün, blaueres Blau: Die Farbe unserer Ozeane verändert sich laut einer aktuellen Studie. Der Wandel könnte die Tierwelt und die Fischerei weltweit beeinflussen.
 Eigentlich ist der Anstieg der Ozonwerte im Laufe des Sommers normal. Doch nun weisen Fachleute auf ungewöhnlich hohe Werte bereits zu Beginn der Jahreszeit in Europa hin. Sie liefern auch eine mögliche Erklärung dafür.
Eigentlich ist der Anstieg der Ozonwerte im Laufe des Sommers normal. Doch nun weisen Fachleute auf ungewöhnlich hohe Werte bereits zu Beginn der Jahreszeit in Europa hin. Sie liefern auch eine mögliche Erklärung dafür.
 Der Patient liegt in Angola, der Arzt operiert von den USA aus: Mittels Robotertechnik hat ein Chirurg den Prostatakrebs eines 67-Jährigen behandelt. Der Eingriff gilt als erster dieser Art weltweit.
Der Patient liegt in Angola, der Arzt operiert von den USA aus: Mittels Robotertechnik hat ein Chirurg den Prostatakrebs eines 67-Jährigen behandelt. Der Eingriff gilt als erster dieser Art weltweit.
 Sicherheitsforscher entdecken Datenbanken mit insgesamt rund 16 Milliarden gestohlenen Anmeldeinformationen. Die meisten davon waren bisher nicht bekannt. Auch wenn es Überschneidungen gibt, ist die Zahl gigantisch und Nutzer sollten handeln.
Sicherheitsforscher entdecken Datenbanken mit insgesamt rund 16 Milliarden gestohlenen Anmeldeinformationen. Die meisten davon waren bisher nicht bekannt. Auch wenn es Überschneidungen gibt, ist die Zahl gigantisch und Nutzer sollten handeln.
 Archäologen beschreiben es als »schwerstes Puzzle der Welt«. In mühsamer Kleinarbeit haben sie die Innenbemalung einer antiken Villa zusammengesetzt. Nun hoffen sie, sogar den Namen des Künstlers zu entdecken.
Archäologen beschreiben es als »schwerstes Puzzle der Welt«. In mühsamer Kleinarbeit haben sie die Innenbemalung einer antiken Villa zusammengesetzt. Nun hoffen sie, sogar den Namen des Künstlers zu entdecken.
 Ergebnisse aus Gehirnscans zeigen: Auch die Gehirne von Männern bauen sich nach der Geburt eines Kindes um - wenngleich subtiler als bei Müttern. Der "Dad Brain" bringt dabei durchaus Vorteile mit sich.
Ergebnisse aus Gehirnscans zeigen: Auch die Gehirne von Männern bauen sich nach der Geburt eines Kindes um - wenngleich subtiler als bei Müttern. Der "Dad Brain" bringt dabei durchaus Vorteile mit sich.
 Bauarbeiter sind in der peruanischen Hauptstadt Lima zufällig auf die Überreste eines Teenagers gestoßen. Zusätzlich zu den Knochen fanden sie wertvolle Beigaben.
Bauarbeiter sind in der peruanischen Hauptstadt Lima zufällig auf die Überreste eines Teenagers gestoßen. Zusätzlich zu den Knochen fanden sie wertvolle Beigaben.
 Am Wochenende wird es sommerlich, da brauchen nicht nur Menschen eine Abkühlung. Wie Sie Ihrem Vierbeiner helfen, gut durch die heißen Tage zu kommen.
Am Wochenende wird es sommerlich, da brauchen nicht nur Menschen eine Abkühlung. Wie Sie Ihrem Vierbeiner helfen, gut durch die heißen Tage zu kommen.
 Ergebnisse aus Gehirnscans zeigen: Auch die Gehirne von Männern bauen sich nach der Geburt eines Kindes um - wenngleich subtiler als bei Müttern. "Dad Brain" bringt dabei durchaus Vorteile mit sich.
Ergebnisse aus Gehirnscans zeigen: Auch die Gehirne von Männern bauen sich nach der Geburt eines Kindes um - wenngleich subtiler als bei Müttern. "Dad Brain" bringt dabei durchaus Vorteile mit sich.
 Mehr Akkulaufzeit und eine neue Kamera: In Kooperation mit der Brillenmarke Oakley hat Meta neue Smartglasses vorgestellt. Eine Revolution sind die nicht. Aber sie zeigen die Ansprüche des Unternehmens.
Mehr Akkulaufzeit und eine neue Kamera: In Kooperation mit der Brillenmarke Oakley hat Meta neue Smartglasses vorgestellt. Eine Revolution sind die nicht. Aber sie zeigen die Ansprüche des Unternehmens.
 Pünktlich zum Sommer bewerten Fachleute den Zustand der europäischen Badegewässer. Das Ergebnis: Die meisten Seen, Flüsse und Meere sind hervorragend zum Schwimmen geeignet. Aber es gibt Ausnahmen, auch in Deutschland.
Pünktlich zum Sommer bewerten Fachleute den Zustand der europäischen Badegewässer. Das Ergebnis: Die meisten Seen, Flüsse und Meere sind hervorragend zum Schwimmen geeignet. Aber es gibt Ausnahmen, auch in Deutschland.
 Wer ein Smartphone mit guten Kameras sucht, muss kein Vermögen ausgeben, auch in der Mittel- und sogar der Einsteigerklasse findet man inzwischen Geräte mit mehr als akzeptablen Knipsen, wie die Rangliste bei Stiftung Warentest zeigt. Sehr gute Kameras findet man aber nur in der Oberklasse.
Wer ein Smartphone mit guten Kameras sucht, muss kein Vermögen ausgeben, auch in der Mittel- und sogar der Einsteigerklasse findet man inzwischen Geräte mit mehr als akzeptablen Knipsen, wie die Rangliste bei Stiftung Warentest zeigt. Sehr gute Kameras findet man aber nur in der Oberklasse.
 Weltweit breitet sich eine neue Coronavariante aus. Der Infektiologe Leif Erik Sander sagt, was inzwischen über die Risiken einer Covid-Erkrankung bekannt ist und wer sich noch mal impfen lassen sollte.
Weltweit breitet sich eine neue Coronavariante aus. Der Infektiologe Leif Erik Sander sagt, was inzwischen über die Risiken einer Covid-Erkrankung bekannt ist und wer sich noch mal impfen lassen sollte.
 Schnarchen und nächtliche Unruhe belasten viele Paare. Frauen schlafen oft schlechter, bleiben aber dennoch im gemeinsamen Bett. Dabei können getrennte Betten eine echte Lösung sein, ohne die Beziehung zu gefährden.
Schnarchen und nächtliche Unruhe belasten viele Paare. Frauen schlafen oft schlechter, bleiben aber dennoch im gemeinsamen Bett. Dabei können getrennte Betten eine echte Lösung sein, ohne die Beziehung zu gefährden.
 Was ist der kalendarische und was der meteorologische Sommeranfang? Und warum ist es im Sommer in Deutschland länger hell? Die wichtigsten Antworten zur Sommersonnenwende finden Sie hier.
Was ist der kalendarische und was der meteorologische Sommeranfang? Und warum ist es im Sommer in Deutschland länger hell? Die wichtigsten Antworten zur Sommersonnenwende finden Sie hier.
 Ein schöner Vollmond steht oft sehr beeindruckend am klaren Himmel. Aber wenn man ihn mit dem Smartphone fotografiert, ist er nur ein kleiner heller Punkt auf einem riesigen schwarzen Hintergrund. Warum das so ist und was man dagegen machen kann, erklärt ein Experte ntv.de.
Ein schöner Vollmond steht oft sehr beeindruckend am klaren Himmel. Aber wenn man ihn mit dem Smartphone fotografiert, ist er nur ein kleiner heller Punkt auf einem riesigen schwarzen Hintergrund. Warum das so ist und was man dagegen machen kann, erklärt ein Experte ntv.de.
 Auf amerikanischen Bauernhöfen sollen Abhängige lernen, ohne Rauschmittel zu leben. Der US-Gesundheitsminister plant, Hunderte dieser Projekte zu fördern. Ein Besuch auf der Modellfarm in Texas.
Auf amerikanischen Bauernhöfen sollen Abhängige lernen, ohne Rauschmittel zu leben. Der US-Gesundheitsminister plant, Hunderte dieser Projekte zu fördern. Ein Besuch auf der Modellfarm in Texas.
 Das Vera C. Rubin Observatory in Chile wird ab Montag mithilfe der weltweit größten Digitalkamera den Blick der Menschheit auf das Universum verändern. Sie soll etwa Sternenexplosionen in nie dagewesener Schärfe einfangen.
Das Vera C. Rubin Observatory in Chile wird ab Montag mithilfe der weltweit größten Digitalkamera den Blick der Menschheit auf das Universum verändern. Sie soll etwa Sternenexplosionen in nie dagewesener Schärfe einfangen.
 Wissenschaftler haben ein neues Blutgruppensystem identifiziert. Die Trägerin ist die bisher einzige weltweit. Aufgefallen war ihr Blut bereits 2011, bei einer Routineuntersuchung.
Wissenschaftler haben ein neues Blutgruppensystem identifiziert. Die Trägerin ist die bisher einzige weltweit. Aufgefallen war ihr Blut bereits 2011, bei einer Routineuntersuchung.
 Immer öfter melden sich Streamer live aus dem Auto oder Wohnmobil während der Fahrt. Drei Experten erklären, ob das erlaubt ist – und ob das sicher sein kann.
Immer öfter melden sich Streamer live aus dem Auto oder Wohnmobil während der Fahrt. Drei Experten erklären, ob das erlaubt ist – und ob das sicher sein kann.
 Die Erderwärmung gefährdet auch die Lebensmittelproduktion. Forschende prognostizieren bis zu 24 Prozent weniger Erträge bis 2100, sogar bei Anpassungen. Besonders groß werden demzufolge die Einbußen beim Mais- und Soja-Anbau in den USA sein. Aber es gibt auch Gewinner.
Die Erderwärmung gefährdet auch die Lebensmittelproduktion. Forschende prognostizieren bis zu 24 Prozent weniger Erträge bis 2100, sogar bei Anpassungen. Besonders groß werden demzufolge die Einbußen beim Mais- und Soja-Anbau in den USA sein. Aber es gibt auch Gewinner.
 Um die großen Mengen an CO2 auszugleichen, die durch die Verbrennung von Kohle, Öl und Gas entstehen, ist eine gängige Maßnahme die Aufforstung. Doch die hat ihre Grenzen: Um alle CO2-Emissionen auszugleichen, müsste man einer Studie zufolge über die Hälfte der bewohnbaren Fläche mit Bäumen bepflanzen. Auch ökonomisch sei es nicht sinnvoll.
Um die großen Mengen an CO2 auszugleichen, die durch die Verbrennung von Kohle, Öl und Gas entstehen, ist eine gängige Maßnahme die Aufforstung. Doch die hat ihre Grenzen: Um alle CO2-Emissionen auszugleichen, müsste man einer Studie zufolge über die Hälfte der bewohnbaren Fläche mit Bäumen bepflanzen. Auch ökonomisch sei es nicht sinnvoll.
 Hartmut Neven möchte für Google den ersten echten Quantenrechner der Welt bauen. Er weiß auch schon, auf welches Problem er die Maschine zuerst ansetzen wird. Und wie er mit ihr das menschliche Bewusstsein entschlüsseln will.
Hartmut Neven möchte für Google den ersten echten Quantenrechner der Welt bauen. Er weiß auch schon, auf welches Problem er die Maschine zuerst ansetzen wird. Und wie er mit ihr das menschliche Bewusstsein entschlüsseln will.
 Kleines Insekt, große Wirkung: An immer mehr Orten in Deutschland wird die eingeschleppte Ameisenart Tapinoma magnum entdeckt, die meist über mediterrane Kübelpflanzen verbreitet wird. Und sie richtet Schäden technischer Art an. Wie ist sie zu erkennen? Und was kann man tun, wenn man sie findet?
Kleines Insekt, große Wirkung: An immer mehr Orten in Deutschland wird die eingeschleppte Ameisenart Tapinoma magnum entdeckt, die meist über mediterrane Kübelpflanzen verbreitet wird. Und sie richtet Schäden technischer Art an. Wie ist sie zu erkennen? Und was kann man tun, wenn man sie findet?
 Irreführende Reisetipps, lieblose Kinderbücher, generische Ratgeber: Auf Amazon floriert der Handel mit KI-Werken. Der Konzern könnte für Transparenz sorgen, drückt sich aber.
Irreführende Reisetipps, lieblose Kinderbücher, generische Ratgeber: Auf Amazon floriert der Handel mit KI-Werken. Der Konzern könnte für Transparenz sorgen, drückt sich aber.
 Vor dem Landgericht Koblenz stritten eine Firma und ihr Kunde um die Bezahlung für den Bau eines Gartenzauns. Das Geld hatten Onlinebetrüger abgezweigt. Beide Seiten hatten es den Kriminellen zu einfach gemacht.
Vor dem Landgericht Koblenz stritten eine Firma und ihr Kunde um die Bezahlung für den Bau eines Gartenzauns. Das Geld hatten Onlinebetrüger abgezweigt. Beide Seiten hatten es den Kriminellen zu einfach gemacht.
 Das Rubin-Observatorium in Chile liefert erste spektakuläre Bilder von Nebeln in der Milchstraße und einem Galaxienhaufen. Forschende sind »begeistert von der Tiefe und Größe der Aufnahmen«.
Das Rubin-Observatorium in Chile liefert erste spektakuläre Bilder von Nebeln in der Milchstraße und einem Galaxienhaufen. Forschende sind »begeistert von der Tiefe und Größe der Aufnahmen«.
 Wenige Games polarisieren so sehr wie »Death Stranding«: Manche sehen das Spiel von Hideo Kojima als Kunst- und Meisterwerk, andere als misslungenes Experiment. Nun erscheint der Nachfolger.
Wenige Games polarisieren so sehr wie »Death Stranding«: Manche sehen das Spiel von Hideo Kojima als Kunst- und Meisterwerk, andere als misslungenes Experiment. Nun erscheint der Nachfolger.
 Schräg? Polarisierend? Aufregend? Die Adjektiv-Wahl fällt bei "Death Stranding 2" schwer. Klar ist aber: Das Spiel, das aus der blühenden Fantasie des japanischen Videospieleentwicklers Hideo Kojima auf die Bildschirme übersetzt wurde, ist ein ganz besonderes - und voller bekannter Namen.
Schräg? Polarisierend? Aufregend? Die Adjektiv-Wahl fällt bei "Death Stranding 2" schwer. Klar ist aber: Das Spiel, das aus der blühenden Fantasie des japanischen Videospieleentwicklers Hideo Kojima auf die Bildschirme übersetzt wurde, ist ein ganz besonderes - und voller bekannter Namen.
 Wer einen der besten von Stiftung Warentest geprüften aktuellen Fernseher kaufen möchte, muss viel bezahlen, nicht selten mehr als 2000 Euro. Doch es gibt in allen Preis- und Größenklassen auch gute und wesentlich günstigere Geräte.
Wer einen der besten von Stiftung Warentest geprüften aktuellen Fernseher kaufen möchte, muss viel bezahlen, nicht selten mehr als 2000 Euro. Doch es gibt in allen Preis- und Größenklassen auch gute und wesentlich günstigere Geräte.
 Die US-Regierung will ihrer Weltraumbehörde massiv Gelder kürzen, auch internationale Projekte sind vom Aus bedroht. Nasa-Interimschefin Janet Petro wirbt für Zusammenarbeit und verteidigt zugleich den Sparkurs.
Die US-Regierung will ihrer Weltraumbehörde massiv Gelder kürzen, auch internationale Projekte sind vom Aus bedroht. Nasa-Interimschefin Janet Petro wirbt für Zusammenarbeit und verteidigt zugleich den Sparkurs.
 In Mittelfranken hat ein Wels mehrere Badegäste in einem Baggersee verletzt. Berichte über enorme Exemplare in deutschen Seen häufen sich. Auf Abkühlung im Sommer müssen Sie dennoch nicht verzichten.
In Mittelfranken hat ein Wels mehrere Badegäste in einem Baggersee verletzt. Berichte über enorme Exemplare in deutschen Seen häufen sich. Auf Abkühlung im Sommer müssen Sie dennoch nicht verzichten.
 An einem Badesee in Bayern kommt es zu einem Zwischenfall mit einem großen Fisch: Ein Wels beißt um sich und verletzt mehrere Badegäste. Wie gefährlich sind diese Tiere, die mehr als zwei Meter lang werden können - und sich in Deutschland ausbreiten? ntv.de fragt einen Experten.
An einem Badesee in Bayern kommt es zu einem Zwischenfall mit einem großen Fisch: Ein Wels beißt um sich und verletzt mehrere Badegäste. Wie gefährlich sind diese Tiere, die mehr als zwei Meter lang werden können - und sich in Deutschland ausbreiten? ntv.de fragt einen Experten.
 Nicht nur der Mensch nutzt Algen für kosmetische Zwecke, auch Wale verwenden Seetang für die Körperpflege. Offenbar fertigen Orcas aus dem Material sogar Einwegbürsten, um sich gegenseitig zu reinigen.
Nicht nur der Mensch nutzt Algen für kosmetische Zwecke, auch Wale verwenden Seetang für die Körperpflege. Offenbar fertigen Orcas aus dem Material sogar Einwegbürsten, um sich gegenseitig zu reinigen.
 Gesicherte Handys sollten die Landespolizei Mecklenburg-Vorpommern »mobiler und digitaler« machen. Ein Hackerangriff jedoch hat diese Pläne durchkreuzt, bei manchen Aufgaben feiert der Funk ein Comeback.
Gesicherte Handys sollten die Landespolizei Mecklenburg-Vorpommern »mobiler und digitaler« machen. Ein Hackerangriff jedoch hat diese Pläne durchkreuzt, bei manchen Aufgaben feiert der Funk ein Comeback.
 Die USA nutzten für ihre Angriffe auf Irans Atomanlagen extrem teure Kampfflugzeuge mit außergewöhnlichen Fähigkeiten. Für deren Tarnung sorgen ihre Form und eine spezielle Beschichtung.
Die USA nutzten für ihre Angriffe auf Irans Atomanlagen extrem teure Kampfflugzeuge mit außergewöhnlichen Fähigkeiten. Für deren Tarnung sorgen ihre Form und eine spezielle Beschichtung.
 Keine Chat-App ist so populär wie WhatsApp. Doch manche Nutzer sind verärgert, weil die App mit neuen Funktionen wie Werbung, Kanälen und Meta AI überfrachtet wird. Hier sind vier Alternativen.
Keine Chat-App ist so populär wie WhatsApp. Doch manche Nutzer sind verärgert, weil die App mit neuen Funktionen wie Werbung, Kanälen und Meta AI überfrachtet wird. Hier sind vier Alternativen.
 Dem neuen Cybersicherheitsmonitor zufolge schützen sich wieder mehr Bundesbürger nicht ausreichend vor Cyberkriminalität. Trotz anhaltend hoher Bedrohungslage verwendet unter anderem nur etwa ein Drittel der Befragten eine Zwei-Faktor-Authentifizierung. Checklisten sollen Opfern im Notfall helfen.
Dem neuen Cybersicherheitsmonitor zufolge schützen sich wieder mehr Bundesbürger nicht ausreichend vor Cyberkriminalität. Trotz anhaltend hoher Bedrohungslage verwendet unter anderem nur etwa ein Drittel der Befragten eine Zwei-Faktor-Authentifizierung. Checklisten sollen Opfern im Notfall helfen.
 Orcas zeigen ein bisher unbekanntes Verhalten: Sie nutzen Algenstiele als Pflegewerkzeug. Forscher vermuten jedoch, dass dies nicht nur der Hautgesundheit dient, sondern auch ein wichtiger Teil ihres Soziallebens ist.
Orcas zeigen ein bisher unbekanntes Verhalten: Sie nutzen Algenstiele als Pflegewerkzeug. Forscher vermuten jedoch, dass dies nicht nur der Hautgesundheit dient, sondern auch ein wichtiger Teil ihres Soziallebens ist.
 Zoom, zoom, ZOOM! Die ersten Bilder des Rubin-Observatoriums sind da. Mit einer App können Hobby-Astronomen darin bisher unbekannte Galaxien und Sterne finden. Der SPIEGEL hat es ausprobiert.
Zoom, zoom, ZOOM! Die ersten Bilder des Rubin-Observatoriums sind da. Mit einer App können Hobby-Astronomen darin bisher unbekannte Galaxien und Sterne finden. Der SPIEGEL hat es ausprobiert.
 Täter, die sich das Vertrauen von Kindern und Jugendlichen erschleichen, um sie zu Straftaten oder Selbstverletzungen zu drängen? Was schrecklich klingt, ist ein ernst zu nehmendes Onlinephänomen.
Täter, die sich das Vertrauen von Kindern und Jugendlichen erschleichen, um sie zu Straftaten oder Selbstverletzungen zu drängen? Was schrecklich klingt, ist ein ernst zu nehmendes Onlinephänomen.
 Erst vor wenigen Monaten wurde in Iran ein WhatsApp-Verbot aufgehoben. Doch jetzt, im Krieg mit Israel, sieht die Regierung die App offenbar wieder skeptisch. Zugleich drosselt sie das Internet.
Erst vor wenigen Monaten wurde in Iran ein WhatsApp-Verbot aufgehoben. Doch jetzt, im Krieg mit Israel, sieht die Regierung die App offenbar wieder skeptisch. Zugleich drosselt sie das Internet.
 TikTok soll in den USA verkauft oder abgeschaltet werden. Doch der US-Präsident will laut seiner Sprecherin nicht, dass die App »von der Bildfläche verschwindet«. Er werde ein entsprechendes Dekret unterzeichnen.
TikTok soll in den USA verkauft oder abgeschaltet werden. Doch der US-Präsident will laut seiner Sprecherin nicht, dass die App »von der Bildfläche verschwindet«. Er werde ein entsprechendes Dekret unterzeichnen.
 Fantasy-Fossilie: In den USA wird eine neue Echsenart aus der späten Kreidezeit entdeckt. Das "kleine Monster", wie die Forscher es nennen, hat einen Kopfpanzer und spitze Zähne und erinnert sie an Goblins. Darum bekommt der Räuber einen Namen aus Tolkiens "Hobbit".
Fantasy-Fossilie: In den USA wird eine neue Echsenart aus der späten Kreidezeit entdeckt. Das "kleine Monster", wie die Forscher es nennen, hat einen Kopfpanzer und spitze Zähne und erinnert sie an Goblins. Darum bekommt der Räuber einen Namen aus Tolkiens "Hobbit".
 Eine deutsche Firma wirbt für einen »Drohnenwall« zum Schutz gegen Russland. Tatsächlich haben die ferngesteuerten Flugobjekte den Krieg revolutioniert. Aber sie haben entscheidende Schwachpunkte.
Eine deutsche Firma wirbt für einen »Drohnenwall« zum Schutz gegen Russland. Tatsächlich haben die ferngesteuerten Flugobjekte den Krieg revolutioniert. Aber sie haben entscheidende Schwachpunkte.
 Zoom, zoom, ZOOM! Die ersten Bilder des Rubin-Observatoriums sind da. Mit einer App können Hobbyastronomen darin bisher unbekannte Galaxien und Sterne finden. Der SPIEGEL hat es ausprobiert.
Zoom, zoom, ZOOM! Die ersten Bilder des Rubin-Observatoriums sind da. Mit einer App können Hobbyastronomen darin bisher unbekannte Galaxien und Sterne finden. Der SPIEGEL hat es ausprobiert.
 In Mittelfranken hat ein Wels mehrere Badegäste in einem Badesee verletzt. Berichte über enorme Exemplare in deutschen Seen häufen sich. Auf Abkühlung im Sommer müssen Sie dennoch nicht verzichten.
In Mittelfranken hat ein Wels mehrere Badegäste in einem Badesee verletzt. Berichte über enorme Exemplare in deutschen Seen häufen sich. Auf Abkühlung im Sommer müssen Sie dennoch nicht verzichten.
 Verändert man bestimmte Gene von Escherichia coli, kann das Darmbakterium gebrauchte Plastikflaschen zerlegen. Dabei entsteht ein bekanntes Schmerzmittel, findet ein Team von Chemikern heraus. Bis zur industriellen Anwendung des Verfahrens ist der Weg jedoch noch weit.
Verändert man bestimmte Gene von Escherichia coli, kann das Darmbakterium gebrauchte Plastikflaschen zerlegen. Dabei entsteht ein bekanntes Schmerzmittel, findet ein Team von Chemikern heraus. Bis zur industriellen Anwendung des Verfahrens ist der Weg jedoch noch weit.
 Millionen von Galaxien und neue Asteroiden – das zeigen spektakuläre Aufnahmen der weltgrößten Digitalkamera im Rubin-Observatorium Chiles. Forscher wollen damit dunkle Materie und dunkle Energie besser verstehen lernen.
Millionen von Galaxien und neue Asteroiden – das zeigen spektakuläre Aufnahmen der weltgrößten Digitalkamera im Rubin-Observatorium Chiles. Forscher wollen damit dunkle Materie und dunkle Energie besser verstehen lernen.
 Schlaf ist wichtig für die Regeneration. Wenn er häufig durch angsteinflößende Träume gestört wird, hat das massivere gesundheitliche Auswirkungen als Rauchen oder Bewegungsmangel. Doch es gibt Wege aus dem Albtraumstress heraus.
Schlaf ist wichtig für die Regeneration. Wenn er häufig durch angsteinflößende Träume gestört wird, hat das massivere gesundheitliche Auswirkungen als Rauchen oder Bewegungsmangel. Doch es gibt Wege aus dem Albtraumstress heraus.
 Die Herstellung von Medikamenten könnte durch die Entdeckung revolutioniert werden: Ein Bakterium kann aus Kunststoff ein Schmerzmittel herstellen. Das Verfahren müsste allerdings verfeinert werden.
Die Herstellung von Medikamenten könnte durch die Entdeckung revolutioniert werden: Ein Bakterium kann aus Kunststoff ein Schmerzmittel herstellen. Das Verfahren müsste allerdings verfeinert werden.
 Betroffene wissen, wie sehr Lärm nerven kann. Doch auch die Gesundheit ist gefährdet. Wie viele Menschen in Europa davon betroffen sind und wieso auch die Umwelt und die Wirtschaft unter zu hohen Pegeln von Verkehrslärm leiden, wird in einem aktuellen Bericht beschrieben.
Betroffene wissen, wie sehr Lärm nerven kann. Doch auch die Gesundheit ist gefährdet. Wie viele Menschen in Europa davon betroffen sind und wieso auch die Umwelt und die Wirtschaft unter zu hohen Pegeln von Verkehrslärm leiden, wird in einem aktuellen Bericht beschrieben.
 Tabak sorgt jährlich für Millionen Todesfälle, und die Zahlen steigen. Besonders Männer sind gefährdet. Die WHO drängt Deutschland daher zu deutlich höheren Tabaksteuern und warnt ausdrücklich vor E-Zigaretten.
Tabak sorgt jährlich für Millionen Todesfälle, und die Zahlen steigen. Besonders Männer sind gefährdet. Die WHO drängt Deutschland daher zu deutlich höheren Tabaksteuern und warnt ausdrücklich vor E-Zigaretten.
 Eine proisraelische Hackergruppe hat einer der größten iranischen Kryptowährungsbörsen offenbar 90 Millionen Dollar gestohlen. Ein Raubzug soll die Aktion nicht gewesen sein.
Eine proisraelische Hackergruppe hat einer der größten iranischen Kryptowährungsbörsen offenbar 90 Millionen Dollar gestohlen. Ein Raubzug soll die Aktion nicht gewesen sein.
 In Afrika kommt es zu einer medizinischen Sensation. Ein Patient wird dort operiert - von einem Arzt, der sich in den USA befindet. Möglich wurde das dank der sogenannten Tele-Chirurgie. Der Klinik zufolge hat es eine Behandlung über eine solch große Distanz zuvor noch nie gegeben.
In Afrika kommt es zu einer medizinischen Sensation. Ein Patient wird dort operiert - von einem Arzt, der sich in den USA befindet. Möglich wurde das dank der sogenannten Tele-Chirurgie. Der Klinik zufolge hat es eine Behandlung über eine solch große Distanz zuvor noch nie gegeben.
 Die Polizei hat 65 Wohnungen von Online-Nutzern durchsucht, die illegale Beiträge im Netz veröffentlicht haben sollen. Das Bundeskriminalamt verzeichnet immer mehr Fälle digitaler Hasskriminalität.
Die Polizei hat 65 Wohnungen von Online-Nutzern durchsucht, die illegale Beiträge im Netz veröffentlicht haben sollen. Das Bundeskriminalamt verzeichnet immer mehr Fälle digitaler Hasskriminalität.
 Tabak sorgt jährlich für Millionen Todesfälle, und die Zahlen steigen. Besonders Männer sind betroffen. Die WHO drängt Deutschland daher zu deutlich höheren Tabaksteuern und warnt ausdrücklich vor E-Zigaretten.
Tabak sorgt jährlich für Millionen Todesfälle, und die Zahlen steigen. Besonders Männer sind betroffen. Die WHO drängt Deutschland daher zu deutlich höheren Tabaksteuern und warnt ausdrücklich vor E-Zigaretten.
 Die deutsch-französische Firma The Exploration Company hat eine neue private Weltraumkapsel getestet. Das Fazit: Teils erfolgreich, teils gescheitert. Eine Tasse von Markus Söder musste wohl dran glauben.
Die deutsch-französische Firma The Exploration Company hat eine neue private Weltraumkapsel getestet. Das Fazit: Teils erfolgreich, teils gescheitert. Eine Tasse von Markus Söder musste wohl dran glauben.
 Als Torfstecher bei Bremen eine mumifizierte Hand und andere Leichenteile fanden, führte das die Polizei auf eine vollkommen falsche Fährte. Erst eine Wissenschaftlerin gab den entscheidenden Tipp.
Als Torfstecher bei Bremen eine mumifizierte Hand und andere Leichenteile fanden, führte das die Polizei auf eine vollkommen falsche Fährte. Erst eine Wissenschaftlerin gab den entscheidenden Tipp.
 Die Zahl der weltweiten Impfungen stockt, heißt es in einer neuen Studie. Dadurch erhöhe sich die Gefahr künftiger Ausbrüche vermeidbarer Krankheiten, prophezeien die Wissenschaftler.
Die Zahl der weltweiten Impfungen stockt, heißt es in einer neuen Studie. Dadurch erhöhe sich die Gefahr künftiger Ausbrüche vermeidbarer Krankheiten, prophezeien die Wissenschaftler.
 Forscher aus Gießen stellen mit Hexastickstoff das energiereichste Molekül der Welt her. Es könnte als effizienter Energiespeicher oder Raketentreibstoff dienen. Andere Forscher sprechen von einer "nobelpreiswürdigen" Leistung. Doch die Herstellung bleibt eine Herausforderung.
Forscher aus Gießen stellen mit Hexastickstoff das energiereichste Molekül der Welt her. Es könnte als effizienter Energiespeicher oder Raketentreibstoff dienen. Andere Forscher sprechen von einer "nobelpreiswürdigen" Leistung. Doch die Herstellung bleibt eine Herausforderung.
 Überfischung lässt den Bestand von Dorschen in der Ostsee schrumpfen. Das beeinflusst die körperliche Entwicklung der auch als Kabeljau bekannten Tiere. Forscher sprechen von einer »durch Menschen ausgelösten Evolution«.
Überfischung lässt den Bestand von Dorschen in der Ostsee schrumpfen. Das beeinflusst die körperliche Entwicklung der auch als Kabeljau bekannten Tiere. Forscher sprechen von einer »durch Menschen ausgelösten Evolution«.
 Dorsche kommen in der Ostsee nicht nur seltener vor als früher, sie sind auch bedeutend kleiner: Ihr Erbgut hat sich durch jahrzehntelange Überfischung verändert. Nun pflanzen sich die Dorsche bei immer geringerer Größe fort - das ist ein Überlebensvorteil, aber "ökologisch hochdramatisch".
Dorsche kommen in der Ostsee nicht nur seltener vor als früher, sie sind auch bedeutend kleiner: Ihr Erbgut hat sich durch jahrzehntelange Überfischung verändert. Nun pflanzen sich die Dorsche bei immer geringerer Größe fort - das ist ein Überlebensvorteil, aber "ökologisch hochdramatisch".
 Wie lassen sich Datenkabel und Leitungen für Strom und Gas in Nord- und Ostsee gegen russische Sabotage schützen? Forscher, Firmen und Militärs rücken zusammen. Sie planen eine Rundum-Überwachung mit viel autonomer Technik.
Wie lassen sich Datenkabel und Leitungen für Strom und Gas in Nord- und Ostsee gegen russische Sabotage schützen? Forscher, Firmen und Militärs rücken zusammen. Sie planen eine Rundum-Überwachung mit viel autonomer Technik.
 EU-Digitalgesetze wie die KI-Verordnung und das Digitale Dienste Gesetz stehen zunehmend in der Kritik. Die zuständige Kommissarin Henna Virkkunen über Zensurvorwürfe und ihren Umgang mit Elon Musk.
EU-Digitalgesetze wie die KI-Verordnung und das Digitale Dienste Gesetz stehen zunehmend in der Kritik. Die zuständige Kommissarin Henna Virkkunen über Zensurvorwürfe und ihren Umgang mit Elon Musk.
 Eine Woche nach der Ankündigung des Trump-Telefons ist von »Made in the USA« plötzlich nicht mehr die Rede. Auch die Größe des Bildschirmes wurde ohne weitere Erklärung kleiner.
Eine Woche nach der Ankündigung des Trump-Telefons ist von »Made in the USA« plötzlich nicht mehr die Rede. Auch die Größe des Bildschirmes wurde ohne weitere Erklärung kleiner.
 Wenn im Oktober der Support für Windows 10 endet, können private Nutzerinnen und Nutzer an einem Programm teilnehmen, mit dem sie ein weiteres Jahr Sicherheitsupdates für das Betriebssystem erhalten. Das Angebot ist kostenlos, falls Microsoft keinen Haken eingebaut hat.
Wenn im Oktober der Support für Windows 10 endet, können private Nutzerinnen und Nutzer an einem Programm teilnehmen, mit dem sie ein weiteres Jahr Sicherheitsupdates für das Betriebssystem erhalten. Das Angebot ist kostenlos, falls Microsoft keinen Haken eingebaut hat.
 Der Wert war so hoch, dass sie dachten, ihr Messgerät sei kaputt: US-Forscher haben im Dampf von Einweg-Vapes beliebter Hersteller Blei nachgewiesen. Das Problem liegt wohl nicht nur in der Flüssigkeit.
Der Wert war so hoch, dass sie dachten, ihr Messgerät sei kaputt: US-Forscher haben im Dampf von Einweg-Vapes beliebter Hersteller Blei nachgewiesen. Das Problem liegt wohl nicht nur in der Flüssigkeit.
 Die Straße von Hormus ist nicht das einzige Nadelöhr, dessen Blockade die weltweite Erdöl- und Erdgasversorgung gefährden würde. Der SPIEGEL zeigt die riskantesten Passagen der Weltmeere.
Die Straße von Hormus ist nicht das einzige Nadelöhr, dessen Blockade die weltweite Erdöl- und Erdgasversorgung gefährden würde. Der SPIEGEL zeigt die riskantesten Passagen der Weltmeere.
 Er habe »keine andere Wahl« gehabt, als die Klage abzuweisen: Ein Bundesrichter hat geurteilt, dass Meta urheberrechtlich geschützte Bücher von 13 Autoren für das KI-Training des Konzerns verwenden durfte.
Er habe »keine andere Wahl« gehabt, als die Klage abzuweisen: Ein Bundesrichter hat geurteilt, dass Meta urheberrechtlich geschützte Bücher von 13 Autoren für das KI-Training des Konzerns verwenden durfte.
 Katzenhalter wissen, dass ihre Lieblinge sehr viele Stunden am Tag schlafen. Ungewöhnlich viele liegen dabei auf der linken Körperhälfte, findet ein Forschungsteam heraus und liefert eine mögliche Begründung dazu.
Katzenhalter wissen, dass ihre Lieblinge sehr viele Stunden am Tag schlafen. Ungewöhnlich viele liegen dabei auf der linken Körperhälfte, findet ein Forschungsteam heraus und liefert eine mögliche Begründung dazu.
 Buchen suchen, alle Stecker ziehen, nicht telefonieren und bloß nicht duschen – welche Bauernregeln und Merksätze über Gewitter stimmen und welche nur ein Mythos sind. Die Blitzanalyse.
Buchen suchen, alle Stecker ziehen, nicht telefonieren und bloß nicht duschen – welche Bauernregeln und Merksätze über Gewitter stimmen und welche nur ein Mythos sind. Die Blitzanalyse.
 Stiftung Warentest prüft 15 neue E-Book-Reader, von denen viele gut abschneiden und drei Geräte die Spitze ihrer jeweiligen Kategorie übernehmen. Außerdem stellen die Tester fest, dass E-Books weit umweltfreundlicher als herkömmliche Bücher sind.
Stiftung Warentest prüft 15 neue E-Book-Reader, von denen viele gut abschneiden und drei Geräte die Spitze ihrer jeweiligen Kategorie übernehmen. Außerdem stellen die Tester fest, dass E-Books weit umweltfreundlicher als herkömmliche Bücher sind.
 Der iPhone-Hersteller reagiert auf Druck aus Brüssel: Im Streit mit der EU-Kommission passt Apple die Regeln für App-Entwickler an. Gegen eine Strafe in Höhe von 500 Millionen Euro will sich das Unternehmen wehren.
Der iPhone-Hersteller reagiert auf Druck aus Brüssel: Im Streit mit der EU-Kommission passt Apple die Regeln für App-Entwickler an. Gegen eine Strafe in Höhe von 500 Millionen Euro will sich das Unternehmen wehren.
 Stiftung Warentest prüft 21 aktuelle Tablets. Erstaunlicherweise stammt nicht nur der neue Spitzenreiter von Apple, auch der Preis-Leistungs-Sieger ist ein iPad.
Stiftung Warentest prüft 21 aktuelle Tablets. Erstaunlicherweise stammt nicht nur der neue Spitzenreiter von Apple, auch der Preis-Leistungs-Sieger ist ein iPad.
 Bis in die 80er Jahre entsorgen viele Staaten ihre nuklearen Abfälle im Meer. Nun wollen Forscher die radioaktiven Altlasten aufspüren und systematisch erfassen. Im Atlantik haben sie bereits Hunderte Fässer aufgespürt.
Bis in die 80er Jahre entsorgen viele Staaten ihre nuklearen Abfälle im Meer. Nun wollen Forscher die radioaktiven Altlasten aufspüren und systematisch erfassen. Im Atlantik haben sie bereits Hunderte Fässer aufgespürt.
 Weil die KI-App nicht mit europäischen Datenschutzregeln vereinbar sei, sollen Apple und Google Deepseek in Deutschland aus ihren Angeboten entfernen. Die Forderung ist ein Testballon der Berliner Behörde.
Weil die KI-App nicht mit europäischen Datenschutzregeln vereinbar sei, sollen Apple und Google Deepseek in Deutschland aus ihren Angeboten entfernen. Die Forderung ist ein Testballon der Berliner Behörde.
 Mithilfe der sogenannten Coffer-Illusion untersucht ein Forschungsteam, welchen Einfluss die kulturelle Prägung auf die Wahrnehmung hat. Menschen aus den USA, Großbritannien und Namibia werden gefragt, was sie sehen. Die Antworten überraschen.
Mithilfe der sogenannten Coffer-Illusion untersucht ein Forschungsteam, welchen Einfluss die kulturelle Prägung auf die Wahrnehmung hat. Menschen aus den USA, Großbritannien und Namibia werden gefragt, was sie sehen. Die Antworten überraschen.
 Seit vier Wochen suchen Wissenschaftler nach Atomabfällen, die seit den Fünfzigerjahren im Meer entsorgt wurden. Sie vermuten noch Hunderttausende der Behälter in teils Tausenden Meter Tiefe.
Seit vier Wochen suchen Wissenschaftler nach Atomabfällen, die seit den Fünfzigerjahren im Meer entsorgt wurden. Sie vermuten noch Hunderttausende der Behälter in teils Tausenden Meter Tiefe.
 Ein in vielen Kopfhörern verbauter Bluetooth-Chip ist angreifbar. Bisher sind zwar keine Attacken bekannt, doch theoretisch könnten Hacker Anrufe starten und die Mikrofone abhören.
Ein in vielen Kopfhörern verbauter Bluetooth-Chip ist angreifbar. Bisher sind zwar keine Attacken bekannt, doch theoretisch könnten Hacker Anrufe starten und die Mikrofone abhören.
 Es gibt nur 280 Plätze, aber Tausende haben sich um eine dauerhafte Übersiedlung von Tuvalu nach Australien beworben. Die Atolle könnten in den kommenden Jahrzehnten unbewohnbar werden.
Es gibt nur 280 Plätze, aber Tausende haben sich um eine dauerhafte Übersiedlung von Tuvalu nach Australien beworben. Die Atolle könnten in den kommenden Jahrzehnten unbewohnbar werden.
 Schwächelnde Konjunktur, aktuelle Krisen, ambivalente Ansagen der neuen Regierung: Klimaschutz ist auf der To-do-Liste nach unten gerutscht. Das könnte den notwendigen Umbau um Jahre verzögern.
Schwächelnde Konjunktur, aktuelle Krisen, ambivalente Ansagen der neuen Regierung: Klimaschutz ist auf der To-do-Liste nach unten gerutscht. Das könnte den notwendigen Umbau um Jahre verzögern.
 Für den Sommeranfang ungewöhnlich hohe Temperaturen erwarten Meteorologen am Wochenende in Italien, Frankreich und Spanien. Die Behörden haben vielerorts Hitzewarnungen ausgegeben. Auch in Deutschland wird es heiß.
Für den Sommeranfang ungewöhnlich hohe Temperaturen erwarten Meteorologen am Wochenende in Italien, Frankreich und Spanien. Die Behörden haben vielerorts Hitzewarnungen ausgegeben. Auch in Deutschland wird es heiß.
 Der Jackery HomePower 2000 Ultra ist ein hochwertiger Balkonkraftwerk-Speicher, der nicht nur souverän erzeugten Solarstrom speichert und verteilt. In Verbindung mit einem dynamischen Stromtarif kann er sich auch bezahlt machen, wenn die Sonne nicht scheint.
Der Jackery HomePower 2000 Ultra ist ein hochwertiger Balkonkraftwerk-Speicher, der nicht nur souverän erzeugten Solarstrom speichert und verteilt. In Verbindung mit einem dynamischen Stromtarif kann er sich auch bezahlt machen, wenn die Sonne nicht scheint.
 Mit einer innovativen Operationstechnik rettet ein Ärzteteam der Medizinischen Hochschule Hannover das Leben einer Frau, die eigentlich unheilbar an Krebs erkrankt ist. Der Tumor wird vollständig entfernt. Die heute 62-Jährige ist nun krebsfrei und macht wieder Pläne für die Zukunft.
Mit einer innovativen Operationstechnik rettet ein Ärzteteam der Medizinischen Hochschule Hannover das Leben einer Frau, die eigentlich unheilbar an Krebs erkrankt ist. Der Tumor wird vollständig entfernt. Die heute 62-Jährige ist nun krebsfrei und macht wieder Pläne für die Zukunft.
 Katzen schlummern täglich bis zu 16 Stunden – und das offenbar überwiegend auf der linken Seite liegend. Laut einer Studie aus Bochum könnte das eine Überlebensstrategie sein. Weitere Forschung sei aber nötig.
Katzen schlummern täglich bis zu 16 Stunden – und das offenbar überwiegend auf der linken Seite liegend. Laut einer Studie aus Bochum könnte das eine Überlebensstrategie sein. Weitere Forschung sei aber nötig.
 Mit der Sommerferienzeit kommt auch der Stau: Reisende müssen auf den meisten Strecken mehr Zeit einplanen. Doch kann man Stau nicht schon bei der Planung von Straßen und Autobahnen verhindern? Ein Verkehrswissenschaftler spricht mit ntv.de über mögliche Anti-Stau-Maßnahmen.
Mit der Sommerferienzeit kommt auch der Stau: Reisende müssen auf den meisten Strecken mehr Zeit einplanen. Doch kann man Stau nicht schon bei der Planung von Straßen und Autobahnen verhindern? Ein Verkehrswissenschaftler spricht mit ntv.de über mögliche Anti-Stau-Maßnahmen.
 Mehr als 70 Prozent aller Antibiotika weltweit kommen in der Viehzucht zum Einsatz. Aus diesem Grund untersuchen Forschende die Hinterlassenschaften von Schweinen, Rindern und Hühnern und finden darin massenhaft genetische Hinweise auf Krankheitserreger, gegen die Antibiotika nichts mehr ausrichten können.
Mehr als 70 Prozent aller Antibiotika weltweit kommen in der Viehzucht zum Einsatz. Aus diesem Grund untersuchen Forschende die Hinterlassenschaften von Schweinen, Rindern und Hühnern und finden darin massenhaft genetische Hinweise auf Krankheitserreger, gegen die Antibiotika nichts mehr ausrichten können.
 Ein voller Handyakku ist im Alltag unverzichtbar – doch was, wenn unterwegs die Steckdose fürs Ladekabel fehlt? Wer auf eine gute Powerbank setzt, bleibt unabhängig. Die ntv/RTL-Testredaktion hat fünf Geräte auf Leistung, Anwendung und Preis hin getestet.
Ein voller Handyakku ist im Alltag unverzichtbar – doch was, wenn unterwegs die Steckdose fürs Ladekabel fehlt? Wer auf eine gute Powerbank setzt, bleibt unabhängig. Die ntv/RTL-Testredaktion hat fünf Geräte auf Leistung, Anwendung und Preis hin getestet.
 Auf der Uno-Ozeankonferenz hat sich Deutschland zu ambitioniertem Meeresschutz bekannt. Doch zerstörerische Schleppnetzfischerei in Schutzgebieten bleibt erlaubt. Das hat Folgen für die Ökosysteme – und den Fischkonsum.
Auf der Uno-Ozeankonferenz hat sich Deutschland zu ambitioniertem Meeresschutz bekannt. Doch zerstörerische Schleppnetzfischerei in Schutzgebieten bleibt erlaubt. Das hat Folgen für die Ökosysteme – und den Fischkonsum.
 Die internationale Gemeinschaft will die Erderwärmung bei 1,5 Grad stoppen - und schon bisher ging der Deutsche Wetterdienst davon aus, das sich Deutschland seit 1881 um 1,9 Grad erwärmt hat. Doch jetzt ändern die Meteorologen die Berechnungsweise - und kommen auf eine beunruhigendere Zahl.
Die internationale Gemeinschaft will die Erderwärmung bei 1,5 Grad stoppen - und schon bisher ging der Deutsche Wetterdienst davon aus, das sich Deutschland seit 1881 um 1,9 Grad erwärmt hat. Doch jetzt ändern die Meteorologen die Berechnungsweise - und kommen auf eine beunruhigendere Zahl.
 Alle 12 Minuten erkrankt ein Mensch in Deutschland an Blutkrebs, eine Stammzellspende kann für Betroffene eine lebensrettende Therapie sein. Doch die Deutsche Knochenmarkspenderdatei hat - aus einem bisher wenig beachteten Grund - mit Problemen zu kämpfen.
Alle 12 Minuten erkrankt ein Mensch in Deutschland an Blutkrebs, eine Stammzellspende kann für Betroffene eine lebensrettende Therapie sein. Doch die Deutsche Knochenmarkspenderdatei hat - aus einem bisher wenig beachteten Grund - mit Problemen zu kämpfen.
 Der Asteroid 2024 YR4 ist zwar keine Gefahr für die Erde - aber der Mond könnte im Jahr 2032 einen Treffer abbekommen. Experten gehen davon aus, dass dies von der Erde aus sichtbar wäre. Bei gutem Wetter wohl ein globales Mega-Event. Doch welche Folgen hätte der Einschlag für den Erdtrabanten?
Der Asteroid 2024 YR4 ist zwar keine Gefahr für die Erde - aber der Mond könnte im Jahr 2032 einen Treffer abbekommen. Experten gehen davon aus, dass dies von der Erde aus sichtbar wäre. Bei gutem Wetter wohl ein globales Mega-Event. Doch welche Folgen hätte der Einschlag für den Erdtrabanten?
 Klimaneutrale, unerschöpfliche Energie - und das rund um die Uhr: Kernfusion ist ein bisher unerreichter Traum der Menschheit. Immer mehr Unternehmen setzen dennoch darauf, auch Gauss Fusion. Mit der Chefin sprach ntv.de darüber, warum es mit der Kernfusion nun endlich klappen soll.
Klimaneutrale, unerschöpfliche Energie - und das rund um die Uhr: Kernfusion ist ein bisher unerreichter Traum der Menschheit. Immer mehr Unternehmen setzen dennoch darauf, auch Gauss Fusion. Mit der Chefin sprach ntv.de darüber, warum es mit der Kernfusion nun endlich klappen soll.
 Wenn der Handy-Akku unterwegs schlappmacht, greifen viele zu Powerbanks. Damit ist das Unternehmen Anker weltweit dick im Geschäft. Doch jetzt rufen die Batterie-Bauer fünf Modelle zurück, von denen eine hohe Gefahr ausgeht.
Wenn der Handy-Akku unterwegs schlappmacht, greifen viele zu Powerbanks. Damit ist das Unternehmen Anker weltweit dick im Geschäft. Doch jetzt rufen die Batterie-Bauer fünf Modelle zurück, von denen eine hohe Gefahr ausgeht.
 »So schlecht, dass es schon wieder gut ist«: Dieser Ruf und seine ungewöhnliche Prämisse machte ein 2019 angekündigtes Jesus-Spiel zum Netzphänomen. Ein neues Team will das Projekt aus der Cringe-Zone holen.
»So schlecht, dass es schon wieder gut ist«: Dieser Ruf und seine ungewöhnliche Prämisse machte ein 2019 angekündigtes Jesus-Spiel zum Netzphänomen. Ein neues Team will das Projekt aus der Cringe-Zone holen.
 Nord- und Ostsee sind voller Weltkriegsmunition. Millionen Tonnen an Bomben, Granaten und Raketen liegen auf dem Meeresboden. Ihre giftige Ladung breitet sich im Wasser und in Meeresfrüchten aus. Die Bergung soll jetzt endlich in Angriff genommen werden.
Nord- und Ostsee sind voller Weltkriegsmunition. Millionen Tonnen an Bomben, Granaten und Raketen liegen auf dem Meeresboden. Ihre giftige Ladung breitet sich im Wasser und in Meeresfrüchten aus. Die Bergung soll jetzt endlich in Angriff genommen werden.
 Rund 50 Tonnen Unrat haben sich am höchsten Berg der Welt angesammelt. Lastendrohnen sollen jetzt Abhilfe schaffen. Sie könnten auch den Job der Sherpas sicherer machen.
Rund 50 Tonnen Unrat haben sich am höchsten Berg der Welt angesammelt. Lastendrohnen sollen jetzt Abhilfe schaffen. Sie könnten auch den Job der Sherpas sicherer machen.
 Weiße Haie kommen im Mittelmeer extrem selten vor. Umso bemerkenswerter ist ein Fang in Montenegro. Dort zog ein Fischer ein junges Exemplar aus seinem Netz. Seine Reaktion ist ein Glücksfall für Meeresbiologen.
Weiße Haie kommen im Mittelmeer extrem selten vor. Umso bemerkenswerter ist ein Fang in Montenegro. Dort zog ein Fischer ein junges Exemplar aus seinem Netz. Seine Reaktion ist ein Glücksfall für Meeresbiologen.
 Unbekannte haben in Venezuela einen TikToker getötet, während der live streamte. Er hatte Korruption und Kriminalität angeprangert, auch innerhalb der Polizei.
Unbekannte haben in Venezuela einen TikToker getötet, während der live streamte. Er hatte Korruption und Kriminalität angeprangert, auch innerhalb der Polizei.
 Heimische und invasive Zeckenarten breiten sich in Europa aus – weil das Klima immer wärmer und trockener wird. Damit erhöht sich die Gefahr, dass schwere Krankheiten übertragen werden. Eine ähnelt gar Ebola.
Heimische und invasive Zeckenarten breiten sich in Europa aus – weil das Klima immer wärmer und trockener wird. Damit erhöht sich die Gefahr, dass schwere Krankheiten übertragen werden. Eine ähnelt gar Ebola.
 Sie liegen wie ein Teppich auf dem Boden, kleben sich an T-Shirts, Arme, Beine: In Südkorea machen sogenannte Lovebugs den Menschen zu schaffen. Mit Gift wollen die Behörden die Insekten aber nicht bekämpfen.
Sie liegen wie ein Teppich auf dem Boden, kleben sich an T-Shirts, Arme, Beine: In Südkorea machen sogenannte Lovebugs den Menschen zu schaffen. Mit Gift wollen die Behörden die Insekten aber nicht bekämpfen.
 Was macht Menschen wirklich cool? Eine globale Studie zeigt, dass Eigenschaften wie Abenteuerlust und Unabhängigkeit universell bewundert werden – egal, in welcher Region der Erde. Doch nicht immer sind coole Persönlichkeiten auch moralisch vorbildlich.
Was macht Menschen wirklich cool? Eine globale Studie zeigt, dass Eigenschaften wie Abenteuerlust und Unabhängigkeit universell bewundert werden – egal, in welcher Region der Erde. Doch nicht immer sind coole Persönlichkeiten auch moralisch vorbildlich.
 Extrovertiert, abenteuerlustig, unabhängig: Forscher haben Charakterzüge festgehalten, die Menschen aus den Augen anderer Personen cool wirken lassen. Über die Kontinente hinweg gibt es dabei eine Gemeinsamkeit.
Extrovertiert, abenteuerlustig, unabhängig: Forscher haben Charakterzüge festgehalten, die Menschen aus den Augen anderer Personen cool wirken lassen. Über die Kontinente hinweg gibt es dabei eine Gemeinsamkeit.
 Ein Forscherteam entwickelt eine umweltfreundliche Methode, um Gold aus Elektroschrott zu gewinnen. Bisherige Verfahren setzen auf giftige Chemikalien wie Quecksilber, die Umwelt und Gesundheit gefährden. Der neue Ansatz macht Hoffnung auf eine kostengünstige Alternative.
Ein Forscherteam entwickelt eine umweltfreundliche Methode, um Gold aus Elektroschrott zu gewinnen. Bisherige Verfahren setzen auf giftige Chemikalien wie Quecksilber, die Umwelt und Gesundheit gefährden. Der neue Ansatz macht Hoffnung auf eine kostengünstige Alternative.
 Dangbei bietet mit dem MP1 Max einen Laser-LED-Beamer an, der für vergleichsweise wenig Geld viel zu bieten hat. Im Praxistest zeigt er ein sehr gutes, helles Bild und erweist sich als vielseitig sowie äußerst flexibel.
Dangbei bietet mit dem MP1 Max einen Laser-LED-Beamer an, der für vergleichsweise wenig Geld viel zu bieten hat. Im Praxistest zeigt er ein sehr gutes, helles Bild und erweist sich als vielseitig sowie äußerst flexibel.
 Dorsche kommen in der Ostsee nicht nur seltener vor als früher, sie sind auch bedeutend kleiner: Ihr Erbgut hat sich durch jahrzehntelange Überfischung verändert. Nun pflanzen sich die Dorsche bei immer geringerer Größe fort - das ist ein Überlebensvorteil, aber "ökologisch hochdramatisch".
Dorsche kommen in der Ostsee nicht nur seltener vor als früher, sie sind auch bedeutend kleiner: Ihr Erbgut hat sich durch jahrzehntelange Überfischung verändert. Nun pflanzen sich die Dorsche bei immer geringerer Größe fort - das ist ein Überlebensvorteil, aber "ökologisch hochdramatisch".
 Ihre Tage sind anstrengend und normalerweise schlafen Orang-Utans deshalb sehr viel - 12 bis 13 Stunden pro Nacht. Wenn sie dabei gestört werden, machen sie das, was Menschen auch tun: ein Nickerchen zwischendurch. Allerdings ist das für sie auch mit extra Aufwand verbunden.
Ihre Tage sind anstrengend und normalerweise schlafen Orang-Utans deshalb sehr viel - 12 bis 13 Stunden pro Nacht. Wenn sie dabei gestört werden, machen sie das, was Menschen auch tun: ein Nickerchen zwischendurch. Allerdings ist das für sie auch mit extra Aufwand verbunden.
 Extrovertiert, abenteuerlustig, unabhängig: Forscher haben Charakterzüge festgehalten, die Menschen in den Augen anderer Personen cool wirken lassen. Über die Kontinente hinweg gibt es dabei eine Gemeinsamkeit.
Extrovertiert, abenteuerlustig, unabhängig: Forscher haben Charakterzüge festgehalten, die Menschen in den Augen anderer Personen cool wirken lassen. Über die Kontinente hinweg gibt es dabei eine Gemeinsamkeit.
 Es ist Sommer und es ist heiß: Diese Woche könnte die 40-Grad-Grenze an manchen Orten in Deutschland erreicht werden. Solche Temperaturen können lebensgefährlich werden. Was kann man tun?
Es ist Sommer und es ist heiß: Diese Woche könnte die 40-Grad-Grenze an manchen Orten in Deutschland erreicht werden. Solche Temperaturen können lebensgefährlich werden. Was kann man tun?
 "Marathousa 1" heißt eine Ausgrabungsstätte in Südgriechenland. Sie ist die bisher älteste bekannte archäologische Fundstelle des Landes. Hier werden Fachleute seit 2013 fündig. Die zuletzt analysierten Steinstücke klären, wie vor 430.000 Jahren mit kleinen Werkzeugen große Tiere zerlegt wurden.
"Marathousa 1" heißt eine Ausgrabungsstätte in Südgriechenland. Sie ist die bisher älteste bekannte archäologische Fundstelle des Landes. Hier werden Fachleute seit 2013 fündig. Die zuletzt analysierten Steinstücke klären, wie vor 430.000 Jahren mit kleinen Werkzeugen große Tiere zerlegt wurden.
 Was zuvor befürchtet worden war, ist nun Tatsache: Auch der zweite Patient, der im Krankenhaus im oberbayerischen Pfaffenhofen an der Ilm wegen einer Borna-Virus-Infektion behandelt wird, verliert den Kampf gegen die Krankheit.
Was zuvor befürchtet worden war, ist nun Tatsache: Auch der zweite Patient, der im Krankenhaus im oberbayerischen Pfaffenhofen an der Ilm wegen einer Borna-Virus-Infektion behandelt wird, verliert den Kampf gegen die Krankheit.
 Erst vor Kurzem ist eine Person in Bayern am Borna-Virus gestorben. Eine zweite Person war erkrankt, nun ist auch sie gestorben. Die Infektion mit dem Erreger gilt als selten, aber gefährlich.
Erst vor Kurzem ist eine Person in Bayern am Borna-Virus gestorben. Eine zweite Person war erkrankt, nun ist auch sie gestorben. Die Infektion mit dem Erreger gilt als selten, aber gefährlich.
 Die Hitze hat das Land in diesen Tagen im Griff. Die hohen Temperaturen haben nicht eine sondern viele Ursachen, wie ein Experte vom Deutschen Wetterdienst erklärt.
Die Hitze hat das Land in diesen Tagen im Griff. Die hohen Temperaturen haben nicht eine sondern viele Ursachen, wie ein Experte vom Deutschen Wetterdienst erklärt.
 Das KI-System MAI-DxO ist bei der Diagnose komplexer Krankheitsfälle auch erfahrenen Ärzten überlegen, zumindest behauptet das Microsoft. Unabhängige Experten sind beeindruckt. Zweifel an der Methodik aber bleiben.
Das KI-System MAI-DxO ist bei der Diagnose komplexer Krankheitsfälle auch erfahrenen Ärzten überlegen, zumindest behauptet das Microsoft. Unabhängige Experten sind beeindruckt. Zweifel an der Methodik aber bleiben.
 Auch bei seinem ersten Bügel-Kopfhörer bleibt Nothing seinem Stil treu. Zum Glück, denn der Headphone (1) begeistert nicht nur mit einem erfrischend eigenwilligen, aber zweckdienlichen Design, sondern überzeugt auch mit einem tollen Klang und einer effektiven aktiven Geräuschunterdrückung.
Auch bei seinem ersten Bügel-Kopfhörer bleibt Nothing seinem Stil treu. Zum Glück, denn der Headphone (1) begeistert nicht nur mit einem erfrischend eigenwilligen, aber zweckdienlichen Design, sondern überzeugt auch mit einem tollen Klang und einer effektiven aktiven Geräuschunterdrückung.
 Die Hitze hat das Land in diesen Tagen im Griff. Die hohen Temperaturen haben nicht eine, sondern viele Ursachen, wie ein Experte vom Deutschen Wetterdienst erklärt.
Die Hitze hat das Land in diesen Tagen im Griff. Die hohen Temperaturen haben nicht eine, sondern viele Ursachen, wie ein Experte vom Deutschen Wetterdienst erklärt.
 In vielen Gärten machen sich Blattläuse über Rosen, Gemüsepflanzen und Obstbäume her. Der Biologe Torsten Will erklärt, ab wann die Schädlinge für Pflanzen zur Gefahr werden und was am besten gegen sie wirkt.
In vielen Gärten machen sich Blattläuse über Rosen, Gemüsepflanzen und Obstbäume her. Der Biologe Torsten Will erklärt, ab wann die Schädlinge für Pflanzen zur Gefahr werden und was am besten gegen sie wirkt.
 Deutschland ächzt unter Temperaturen bis zu 40 Grad. Und dabei ist es erst der Anfang des Sommers. Hitzewellen bringen den Körper an seine Grenzen. Doch wann wird Hitze zur Lebensgefahr? Entscheidend ist nicht allein die Zahl auf dem Thermometer.
Deutschland ächzt unter Temperaturen bis zu 40 Grad. Und dabei ist es erst der Anfang des Sommers. Hitzewellen bringen den Körper an seine Grenzen. Doch wann wird Hitze zur Lebensgefahr? Entscheidend ist nicht allein die Zahl auf dem Thermometer.
 Erst Frankreich, jetzt auch die Schweiz: Weil das Kühlwasser zu warm ist, musste ein Atomkraftwerk zum Teil abgeschaltet werden. Der Betreiber des AKW Beznau gibt als Grund den Schutz des nahe gelegenen Ökosystems an.
Erst Frankreich, jetzt auch die Schweiz: Weil das Kühlwasser zu warm ist, musste ein Atomkraftwerk zum Teil abgeschaltet werden. Der Betreiber des AKW Beznau gibt als Grund den Schutz des nahe gelegenen Ökosystems an.
 Temperaturen über 30 Grad sind für Smartphones gefährlich. Sie sind dann nicht nur weniger leistungsfähig, sondern können auch schweren Schaden nehmen, wenn man sie nicht schont. ntv.de erklärt, wie man die teuren Geräte an brütend heißen Sommertagen richtig nutzt und vor dem Hitzekollaps schützt.
Temperaturen über 30 Grad sind für Smartphones gefährlich. Sie sind dann nicht nur weniger leistungsfähig, sondern können auch schweren Schaden nehmen, wenn man sie nicht schont. ntv.de erklärt, wie man die teuren Geräte an brütend heißen Sommertagen richtig nutzt und vor dem Hitzekollaps schützt.
 Die Europäische Kommission will die Treibhausgasemissionen in der EU bis 2040 um mindestens 90 Prozent im Vergleich zu 1990 senken. Auf Druck einiger Mitgliedsländer sollen die jetzt einfacher zu erreichen sein.
Die Europäische Kommission will die Treibhausgasemissionen in der EU bis 2040 um mindestens 90 Prozent im Vergleich zu 1990 senken. Auf Druck einiger Mitgliedsländer sollen die jetzt einfacher zu erreichen sein.
 Ein Dienst, mit dem sich Sichtungen von ICE-Abschiebeagenten melden lassen, stürmt die App-Charts. Weil CNN über das Angebot berichtet hat, drohen die Justizministerin und die Heimatschutzministerin dem Sender.
Ein Dienst, mit dem sich Sichtungen von ICE-Abschiebeagenten melden lassen, stürmt die App-Charts. Weil CNN über das Angebot berichtet hat, drohen die Justizministerin und die Heimatschutzministerin dem Sender.
 Bei Amazon steht der Prime Day an, die Telekom feiert 30-jähriges Firmenjubiläum als Aktiengesellschaft. Das ruft offenbar Onlinekriminelle auf den Plan. Beide Unternehmen raten zur Vorsicht und bieten Hilfe an.
Bei Amazon steht der Prime Day an, die Telekom feiert 30-jähriges Firmenjubiläum als Aktiengesellschaft. Das ruft offenbar Onlinekriminelle auf den Plan. Beide Unternehmen raten zur Vorsicht und bieten Hilfe an.
 Das Alma-Observatorium in Chile fängt die bisher detailliertesten Bilder aus der Frühzeit des Universums ein. Forscher entdecken dabei das Gas, aus dem die ersten Galaxien entstanden sind. Sie hoffen, dadurch mehr über die Entstehung von Sternen lernen zu können.
Das Alma-Observatorium in Chile fängt die bisher detailliertesten Bilder aus der Frühzeit des Universums ein. Forscher entdecken dabei das Gas, aus dem die ersten Galaxien entstanden sind. Sie hoffen, dadurch mehr über die Entstehung von Sternen lernen zu können.
 Die EU-Kommission will die Treibhausgasemissionen bis 2040 um 90 Prozent reduzieren. Das hört sich ambitionierter an, als es ist. Die Details offenbaren einen Kurswechsel, der die Klimaneutralität gefährden könnte.
Die EU-Kommission will die Treibhausgasemissionen bis 2040 um 90 Prozent reduzieren. Das hört sich ambitionierter an, als es ist. Die Details offenbaren einen Kurswechsel, der die Klimaneutralität gefährden könnte.
 Engpässe bei der Versorgung, Schwierigkeiten für die Schifffahrt, Tausende tote Tiere: Anhaltende Dürren haben einem Uno-Bericht zufolge besonders gravierende Folgen. Mit schlimmsten Auswirkungen auf die ärmsten Menschen.
Engpässe bei der Versorgung, Schwierigkeiten für die Schifffahrt, Tausende tote Tiere: Anhaltende Dürren haben einem Uno-Bericht zufolge besonders gravierende Folgen. Mit schlimmsten Auswirkungen auf die ärmsten Menschen.
 Bei Amazon steht der Prime Day an, die Telekom feiert 30-jähriges Firmenjubiläum als Aktiengesellschaft. Das ruft offenbar Onlinekriminelle auf den Plan. Beide Unternehmen raten zu Vorsicht und bieten Hilfe an.
Bei Amazon steht der Prime Day an, die Telekom feiert 30-jähriges Firmenjubiläum als Aktiengesellschaft. Das ruft offenbar Onlinekriminelle auf den Plan. Beide Unternehmen raten zu Vorsicht und bieten Hilfe an.
 In den USA ist die iOS-App ICEBlock aktuell die Nummer 1 in den Social-Media-Charts und insgesamt die drittbeliebteste Gratis-Anwendung im App Store. Der US-Regierung schmeckt das überhaupt nicht, und sie droht mit Konsequenzen. Der Entwickler zieht derweil Vergleiche zu Nazi-Deutschland.
In den USA ist die iOS-App ICEBlock aktuell die Nummer 1 in den Social-Media-Charts und insgesamt die drittbeliebteste Gratis-Anwendung im App Store. Der US-Regierung schmeckt das überhaupt nicht, und sie droht mit Konsequenzen. Der Entwickler zieht derweil Vergleiche zu Nazi-Deutschland.
 Seit Wochen ist das Mittelmeer außergewöhnlich warm. Die Rekordtemperaturen alarmieren Wissenschaftler, denn sie wissen: Die marine Hitzewelle kann europaweit für Extremwetter sorgen – sogar noch im Herbst.
Seit Wochen ist das Mittelmeer außergewöhnlich warm. Die Rekordtemperaturen alarmieren Wissenschaftler, denn sie wissen: Die marine Hitzewelle kann europaweit für Extremwetter sorgen – sogar noch im Herbst.
 Der Klimawandel erhöht auch die Waldbrandgefahr: Mittlerweile ist Hightech zu einem wichtigen Bestandteil im Kampf gegen die Flammen geworden. Moderne Technik wird dabei auf mehreren Ebenen eingesetzt: zu Land, zu Luft - und in Zukunft verstärkt auch im Weltraum.
Der Klimawandel erhöht auch die Waldbrandgefahr: Mittlerweile ist Hightech zu einem wichtigen Bestandteil im Kampf gegen die Flammen geworden. Moderne Technik wird dabei auf mehreren Ebenen eingesetzt: zu Land, zu Luft - und in Zukunft verstärkt auch im Weltraum.
 2016 erschien Lina Malys Song »Als du gingst«. Über die Jahre gewann das Lied als Trauerventil massiv an Popularität – dank TikTok, einem mitschreienden DJ und geteilten Erinnerungen an verstorbene Freunde, Eltern oder Kinder.
2016 erschien Lina Malys Song »Als du gingst«. Über die Jahre gewann das Lied als Trauerventil massiv an Popularität – dank TikTok, einem mitschreienden DJ und geteilten Erinnerungen an verstorbene Freunde, Eltern oder Kinder.
 Der Jackery HomePower 2000 Ultra ist ein hochwertiger Balkonkraftwerk-Speicher, der nicht nur souverän erzeugten Solarstrom speichert und verteilt. In Verbindung mit einem dynamischen Stromtarif kann er sich auch bezahlt machen, wenn die Sonne nicht scheint.
Der Jackery HomePower 2000 Ultra ist ein hochwertiger Balkonkraftwerk-Speicher, der nicht nur souverän erzeugten Solarstrom speichert und verteilt. In Verbindung mit einem dynamischen Stromtarif kann er sich auch bezahlt machen, wenn die Sonne nicht scheint.
 Große Momente der Raumfahrt sollen noch diesen Sommer auch auf der Streamingplattform Netflix zu sehen sein. Die soll mit den News-Kanälen der Behörde verknüpft werden.
Große Momente der Raumfahrt sollen noch diesen Sommer auch auf der Streamingplattform Netflix zu sehen sein. Die soll mit den News-Kanälen der Behörde verknüpft werden.
 Mit Emojis lassen sich auf einfache Art und Weise auch Gefühle zum Ausdruck bringen. Ein Forschungsteam wollte wissen, wie sich die digitalen Symbole in Freundschaften auswirken - und erhielt von den Befragten eindeutige Einschätzungen.
Mit Emojis lassen sich auf einfache Art und Weise auch Gefühle zum Ausdruck bringen. Ein Forschungsteam wollte wissen, wie sich die digitalen Symbole in Freundschaften auswirken - und erhielt von den Befragten eindeutige Einschätzungen.
 Elon Musk sorgte sich, dass sein Sohn mal einen Bot heiraten könnte. Wie sich durch KI die Beziehung zwischen Mensch und Maschine verändert.
Elon Musk sorgte sich, dass sein Sohn mal einen Bot heiraten könnte. Wie sich durch KI die Beziehung zwischen Mensch und Maschine verändert.
 Altern trifft jeden, aber in unterschiedlicher Geschwindigkeit. Forschenden ist es nun gelungen, mit einem Gehirnscan und Künstlicher Intelligenz die individuelle Alterungsgeschwindigkeit eines Menschen vorherzusagen - und das Risiko damit verbundener Krankheiten. Doch was bringen solche Voraussagen?
Altern trifft jeden, aber in unterschiedlicher Geschwindigkeit. Forschenden ist es nun gelungen, mit einem Gehirnscan und Künstlicher Intelligenz die individuelle Alterungsgeschwindigkeit eines Menschen vorherzusagen - und das Risiko damit verbundener Krankheiten. Doch was bringen solche Voraussagen?
 Derzeit gibt es mehr und größere Waldbrände als im langjährigen Durchschnitt. Auch in Deutschland stehen dieses Jahr bereits ungewöhnlich viele Waldstücke in Flammen, vorrangig im Osten. Der SPIEGEL zeigt, wo die Feuer wüten.
Derzeit gibt es mehr und größere Waldbrände als im langjährigen Durchschnitt. Auch in Deutschland stehen dieses Jahr bereits ungewöhnlich viele Waldstücke in Flammen, vorrangig im Osten. Der SPIEGEL zeigt, wo die Feuer wüten.
 Apples Mac-Computer bieten von Haus aus eine starke Abwehr gegen Cyberangriffe, aber dennoch kann es sinnvoll sein, zusätzliche Schutz-Software zu installieren. Welche Antivirus-Wächter für macOS empfehlenswert sind, zeigt ein aktueller Test von neun Programmen, unter ihnen auch kostenlose Lösungen.
Apples Mac-Computer bieten von Haus aus eine starke Abwehr gegen Cyberangriffe, aber dennoch kann es sinnvoll sein, zusätzliche Schutz-Software zu installieren. Welche Antivirus-Wächter für macOS empfehlenswert sind, zeigt ein aktueller Test von neun Programmen, unter ihnen auch kostenlose Lösungen.
 Als sie sprossen, gab es noch Burgfräuleins und Ritter: Methusalem-Bäume wachsen seit Jahrhunderten in Deutschland. Eine Initiative will die Gewächse als nationales Erbe schützen, der 50. Baum wurde nun ausgezeichnet.
Als sie sprossen, gab es noch Burgfräuleins und Ritter: Methusalem-Bäume wachsen seit Jahrhunderten in Deutschland. Eine Initiative will die Gewächse als nationales Erbe schützen, der 50. Baum wurde nun ausgezeichnet.
 Er stammt von außerhalb des Sonnensystems, rast mit mehr als 200.000 Kilometern pro Stunde auf die Erde zu – und kriegt zum Glück rechtzeitig die Kurve. Der Himmelskörper 3I/Atlas begeistert Forscher.
Er stammt von außerhalb des Sonnensystems, rast mit mehr als 200.000 Kilometern pro Stunde auf die Erde zu – und kriegt zum Glück rechtzeitig die Kurve. Der Himmelskörper 3I/Atlas begeistert Forscher.
 Wissenschaftler untersuchen derzeit in Bremerhaven uralte Eisschichten aus der Antarktis. Sie sind mühsam über Jahre hinweg geborgen worden. Nun sollen sie helfen, ein Klimarätsel zu lösen.
Wissenschaftler untersuchen derzeit in Bremerhaven uralte Eisschichten aus der Antarktis. Sie sind mühsam über Jahre hinweg geborgen worden. Nun sollen sie helfen, ein Klimarätsel zu lösen.
 Altern trifft jeden, aber in unterschiedlicher Geschwindigkeit. Forschenden ist es nun gelungen, mit einem Gehirnscan und einem Programm die individuelle Alterungsgeschwindigkeit eines Menschen vorherzusagen - und das Risiko damit verbundener Krankheiten. Doch was bringen solche Voraussagen?
Altern trifft jeden, aber in unterschiedlicher Geschwindigkeit. Forschenden ist es nun gelungen, mit einem Gehirnscan und einem Programm die individuelle Alterungsgeschwindigkeit eines Menschen vorherzusagen - und das Risiko damit verbundener Krankheiten. Doch was bringen solche Voraussagen?
 Der Lebensraum der wilden Vanille und ihrer Bestäuber dürfte durch die Erderwärmung schrumpfen. Das könnte die Produktion des beliebten Gewürzes gefährden.
Der Lebensraum der wilden Vanille und ihrer Bestäuber dürfte durch die Erderwärmung schrumpfen. Das könnte die Produktion des beliebten Gewürzes gefährden.
 iOS 26 kommt offenbar mit einem optimierten Filter für sensible Inhalte. Ein Beta-Tester entdeckt eine Funktion, die verhindert, dass man in Facetime-Chats aus Versehen mehr von sich zeigt, als gewünscht. Man kann aber weitermachen, wenn man möchte.
iOS 26 kommt offenbar mit einem optimierten Filter für sensible Inhalte. Ein Beta-Tester entdeckt eine Funktion, die verhindert, dass man in Facetime-Chats aus Versehen mehr von sich zeigt, als gewünscht. Man kann aber weitermachen, wenn man möchte.
 Es war ein außergewöhnlicher Fund: Ein Meteoritenjäger stieß in Niger auf einen gewaltigen Brocken vom Mars. Der soll nun bei Sotheby's für einen Millionenbetrag unter den Hammer kommen. Manche kritisieren das.
Es war ein außergewöhnlicher Fund: Ein Meteoritenjäger stieß in Niger auf einen gewaltigen Brocken vom Mars. Der soll nun bei Sotheby's für einen Millionenbetrag unter den Hammer kommen. Manche kritisieren das.
 In einem Zoo in England haben zwei männliche Humboldtpinguine ein Ei ausgebrütet. Die Tierpfleger wollten so die Überlebenschance für den Nachwuchs der gefährdeten Art erhöhen.
In einem Zoo in England haben zwei männliche Humboldtpinguine ein Ei ausgebrütet. Die Tierpfleger wollten so die Überlebenschance für den Nachwuchs der gefährdeten Art erhöhen.
 Die Erderwärmung könnte Vanillepflanzen von ihren Bestäubern trennen. Fachleute halten einen Rückgang der Bestäubung von bis zu 90 Prozent für möglich. Die Folgen bekämen auch Feinschmecker in Deutschland zu spüren.
Die Erderwärmung könnte Vanillepflanzen von ihren Bestäubern trennen. Fachleute halten einen Rückgang der Bestäubung von bis zu 90 Prozent für möglich. Die Folgen bekämen auch Feinschmecker in Deutschland zu spüren.
 Viele Nutzerinnen und Nutzer haben eine Gmail-Adresse, in der beispielsweise Vor- und Nachnahme durch einen Punkt getrennt sind. Doch das Zeichen spielt bei diesem Dienst keine Rolle. Trotzdem kann der Punkt einen Unterschied machen, was auch für ein anderes praktisches Sonderzeichen gilt.
Viele Nutzerinnen und Nutzer haben eine Gmail-Adresse, in der beispielsweise Vor- und Nachnahme durch einen Punkt getrennt sind. Doch das Zeichen spielt bei diesem Dienst keine Rolle. Trotzdem kann der Punkt einen Unterschied machen, was auch für ein anderes praktisches Sonderzeichen gilt.
 In der 160.000 Lichtjahre entfernten Gaswolke SNR 0509-67.5 stoßen Astronomen auf die Überreste einer gewaltigen Sternenexplosion. Der Tod der Sterne hilft, ein langjähriges Rätsel zu lösen.
In der 160.000 Lichtjahre entfernten Gaswolke SNR 0509-67.5 stoßen Astronomen auf die Überreste einer gewaltigen Sternenexplosion. Der Tod der Sterne hilft, ein langjähriges Rätsel zu lösen.
 Es war ein außergewöhnlicher Fund: Ein Meteoritenjäger stieß in Niger auf einen gewaltigen Brocken vom Mars. Der soll nun bei Sotheby’s für einen Millionenbetrag unter den Hammer kommen. Manche kritisieren das.
Es war ein außergewöhnlicher Fund: Ein Meteoritenjäger stieß in Niger auf einen gewaltigen Brocken vom Mars. Der soll nun bei Sotheby’s für einen Millionenbetrag unter den Hammer kommen. Manche kritisieren das.
 Wissenschaftler untersuchen derzeit in Bremerhaven eine der ältesten Eisschichten, die je auf der Erde geborgen wurden. Forscher aus ganz Europa kommen nach Deutschland, um ein Stück davon abzuholen.
Wissenschaftler untersuchen derzeit in Bremerhaven eine der ältesten Eisschichten, die je auf der Erde geborgen wurden. Forscher aus ganz Europa kommen nach Deutschland, um ein Stück davon abzuholen.
 Angst ist ansteckend: Der Psychologe Jürgen Margraf erklärt, wie schlechte Nachrichten auf uns Menschen wirken, was wir dagegen tun können – und ob Männer oder Frauen furchtsamer sind.
Angst ist ansteckend: Der Psychologe Jürgen Margraf erklärt, wie schlechte Nachrichten auf uns Menschen wirken, was wir dagegen tun können – und ob Männer oder Frauen furchtsamer sind.
 Hunde sind gut für die geistige Leistungsfähigkeit alternder Menschen, Katzen erhalten bei ihnen länger die Sprachfähigkeit. Fisch- und Vogelhalter profitieren Schweizer Forschenden zufolge weniger.
Hunde sind gut für die geistige Leistungsfähigkeit alternder Menschen, Katzen erhalten bei ihnen länger die Sprachfähigkeit. Fisch- und Vogelhalter profitieren Schweizer Forschenden zufolge weniger.
 Kommunikation, Erdbeobachtung, Wettervorhersagen: Satelliten erledigen vielfältige Aufgaben. Doch es werden immer mehr und das könnte zu einer zerstörerischen Kettenreaktion führen. Ein Fachmann studiert die möglichen Konsequenzen von einer Sternwarte in Süditalien aus.
Kommunikation, Erdbeobachtung, Wettervorhersagen: Satelliten erledigen vielfältige Aufgaben. Doch es werden immer mehr und das könnte zu einer zerstörerischen Kettenreaktion führen. Ein Fachmann studiert die möglichen Konsequenzen von einer Sternwarte in Süditalien aus.
 4000 Stück pro Quadratmeter: Die invasive Quagga-Muschel breitet sich rasant im Bodensee aus - und bedroht nicht nur das Ökosystem, sondern auch die Trinkwasserversorgung. Eine neue Studie soll nun Lösungen finden. So könnten natürliche Fressfeinde die Invasion stoppen, doch es gibt Hindernisse.
4000 Stück pro Quadratmeter: Die invasive Quagga-Muschel breitet sich rasant im Bodensee aus - und bedroht nicht nur das Ökosystem, sondern auch die Trinkwasserversorgung. Eine neue Studie soll nun Lösungen finden. So könnten natürliche Fressfeinde die Invasion stoppen, doch es gibt Hindernisse.
 Die Internationale Bodensee-Konferenz schlägt Alarm: Wissenschaftler sollen Wege finden, wie die Quagga-Muschel bekämpft werden kann. Die invasive Art stellt eine Gefahr für Mensch und Natur dar, aber es gibt Fressfeinde.
Die Internationale Bodensee-Konferenz schlägt Alarm: Wissenschaftler sollen Wege finden, wie die Quagga-Muschel bekämpft werden kann. Die invasive Art stellt eine Gefahr für Mensch und Natur dar, aber es gibt Fressfeinde.
 Die Stadt Peñico hat vor Tausenden von Jahren wohl als Handelsknotenpunkt gedient. Jetzt könnte sie neue Erkenntnisse über Caral liefern, die älteste bekannte Zivilisation auf dem amerikanischen Kontinent.
Die Stadt Peñico hat vor Tausenden von Jahren wohl als Handelsknotenpunkt gedient. Jetzt könnte sie neue Erkenntnisse über Caral liefern, die älteste bekannte Zivilisation auf dem amerikanischen Kontinent.
 Mit seiner Firma Nothing will Carl Pei Smartphones wieder spannend machen. Seine überwiegend jungen Fans lieben das. Doch der Marktanteil ist winzig. Mit einem kuriosen High-End-Handy will der Londoner das ändern.
Mit seiner Firma Nothing will Carl Pei Smartphones wieder spannend machen. Seine überwiegend jungen Fans lieben das. Doch der Marktanteil ist winzig. Mit einem kuriosen High-End-Handy will der Londoner das ändern.
 Nach einer "Verbesserung" produziert Elon Musks KI-Chatbot Grok Antworten, die bestenfalls als bizarr bezeichnet werden können. Von kruden Falschmeldungen über Egotrips bis zu antisemitischen Verschwörungserzählungen reichen die Aussetzer des Chatbots auf X. Auch Musk selbst bleibt nicht verschont.
Nach einer "Verbesserung" produziert Elon Musks KI-Chatbot Grok Antworten, die bestenfalls als bizarr bezeichnet werden können. Von kruden Falschmeldungen über Egotrips bis zu antisemitischen Verschwörungserzählungen reichen die Aussetzer des Chatbots auf X. Auch Musk selbst bleibt nicht verschont.
 Merkur gibt Forschern lange Rätsel auf: Sein Aufbau unterscheidet sich von den anderen Gesteinsplaneten im Sonnensystem. Eine Simulation von Tübinger Forschern versucht, die Entstehung nachzustellen. Am wahrscheinlichsten ist demnach eine gigantische Kollision.
Merkur gibt Forschern lange Rätsel auf: Sein Aufbau unterscheidet sich von den anderen Gesteinsplaneten im Sonnensystem. Eine Simulation von Tübinger Forschern versucht, die Entstehung nachzustellen. Am wahrscheinlichsten ist demnach eine gigantische Kollision.
 Journalisten haben in Forschungsarbeiten versteckte Prompts entdeckt. Die hatten offenbar einen Zweck: Künstliche Intelligenz sollte die Manuskripte positiv bewerten.
Journalisten haben in Forschungsarbeiten versteckte Prompts entdeckt. Die hatten offenbar einen Zweck: Künstliche Intelligenz sollte die Manuskripte positiv bewerten.
 Ein Dienst, mit dem sich Sichtungen von ICE-Abschiebeagenten melden lassen, stürmt die App-Charts. Weil CNN über das Angebot berichtet hat, drohen die Justizministerin und die Heimatschutzministerin dem Sender.
Ein Dienst, mit dem sich Sichtungen von ICE-Abschiebeagenten melden lassen, stürmt die App-Charts. Weil CNN über das Angebot berichtet hat, drohen die Justizministerin und die Heimatschutzministerin dem Sender.
 Je länger Babys weinen, umso unruhiger werden Eltern. Ein Forschungsteam macht sich auf die Suche nach den Ursachen langer Schreidauer und werden bei den Genen fündig.
Je länger Babys weinen, umso unruhiger werden Eltern. Ein Forschungsteam macht sich auf die Suche nach den Ursachen langer Schreidauer und werden bei den Genen fündig.
 Vor oder nach dem Training? Federnd oder statisch? Sekunden oder eher Minuten? Beim Dehnen scheiden sich die Geister. Eine Gruppe von Fachleuten kann sich jetzt auf einen Konsens auf wissenschaftlicher Basis einigen und macht diesen öffentlich.
Vor oder nach dem Training? Federnd oder statisch? Sekunden oder eher Minuten? Beim Dehnen scheiden sich die Geister. Eine Gruppe von Fachleuten kann sich jetzt auf einen Konsens auf wissenschaftlicher Basis einigen und macht diesen öffentlich.
 Weltweit ziehen sich Geldhäuser langsam aus dem klimaschädlichen Geschäft mit der Kohle zurück. Die Deutsche Bank gehört jedoch nach Angaben der NGO Urgewald zu den Ausnahmen. Die Bank hält dem eigene Zahlen entgegen.
Weltweit ziehen sich Geldhäuser langsam aus dem klimaschädlichen Geschäft mit der Kohle zurück. Die Deutsche Bank gehört jedoch nach Angaben der NGO Urgewald zu den Ausnahmen. Die Bank hält dem eigene Zahlen entgegen.
 Mit dem Phone (3) will das Smartphone-Start-up Nothing in die Oberklasse aufsteigen, Apple und Samsung Konkurrenz machen. Eine Glyph-Matrix soll dabei helfen. Aber was ist das eigentlich? Wir haben es getestet.
Mit dem Phone (3) will das Smartphone-Start-up Nothing in die Oberklasse aufsteigen, Apple und Samsung Konkurrenz machen. Eine Glyph-Matrix soll dabei helfen. Aber was ist das eigentlich? Wir haben es getestet.
 Ein erhöhter CO₂-Gehalt in der Atmosphäre kann sich einer Studie zufolge negativ auf die Qualität von Gemüse wie Spinat, Rucola oder Grünkohl auswirken. Forschende warnen vor den möglichen Folgen für die Gesundheit.
Ein erhöhter CO₂-Gehalt in der Atmosphäre kann sich einer Studie zufolge negativ auf die Qualität von Gemüse wie Spinat, Rucola oder Grünkohl auswirken. Forschende warnen vor den möglichen Folgen für die Gesundheit.
 Das Nothing Phone (3) ist das erste Nothing-Smartphone, das ganz oben mitspielen, aber trotzdem anders als die anderen sein soll. Der Praxistest zeigt, dass das Konzept technisch weitgehend aufgeht. Die große Frage ist, ob Nutzerinnen und Nutzer bereit sind, den Preis dafür zu bezahlen und das neue Design mögen.
Das Nothing Phone (3) ist das erste Nothing-Smartphone, das ganz oben mitspielen, aber trotzdem anders als die anderen sein soll. Der Praxistest zeigt, dass das Konzept technisch weitgehend aufgeht. Die große Frage ist, ob Nutzerinnen und Nutzer bereit sind, den Preis dafür zu bezahlen und das neue Design mögen.
 Ein Chikungunya-Fall im Elsass alarmiert Experten. Das Tropenvirus rückt durch die Ausbreitung der Tigermücke näher an Deutschland heran. Muss man sich jetzt Sorgen machen? Und wie kann man sich schützen? ntv.de beantwortet die wichtigsten Fragen.
Ein Chikungunya-Fall im Elsass alarmiert Experten. Das Tropenvirus rückt durch die Ausbreitung der Tigermücke näher an Deutschland heran. Muss man sich jetzt Sorgen machen? Und wie kann man sich schützen? ntv.de beantwortet die wichtigsten Fragen.
 Eine neue Studie zeigt: Sprachmodelle wie ChatGPT empfehlen Frauen, niedrigere Gehälter als Männer zu verlangen - trotz gleicher Qualifikation. Das kann Auswirkungen auf die Lebensrealität der Nutzerinnen haben, mahnen Experten. Sie fordern daher klare ethische Standards und Prüfverfahren.
Eine neue Studie zeigt: Sprachmodelle wie ChatGPT empfehlen Frauen, niedrigere Gehälter als Männer zu verlangen - trotz gleicher Qualifikation. Das kann Auswirkungen auf die Lebensrealität der Nutzerinnen haben, mahnen Experten. Sie fordern daher klare ethische Standards und Prüfverfahren.
 Seit 20 Jahren hilft das Mammografie-Screening, die Brustkrebs-Sterblichkeit in Deutschland deutlich zu senken. Laut einer neuen Studie reduziert es Todesfälle um bis zu 30 Prozent. Doch Experten fordern Verbesserungen, um auch Frauen mit dichtem Brustgewebe besser zu schützen.
Seit 20 Jahren hilft das Mammografie-Screening, die Brustkrebs-Sterblichkeit in Deutschland deutlich zu senken. Laut einer neuen Studie reduziert es Todesfälle um bis zu 30 Prozent. Doch Experten fordern Verbesserungen, um auch Frauen mit dichtem Brustgewebe besser zu schützen.
 Keiner ist davor gefeit: Das Risiko, an Krebs zu erkranken, besteht für jeden. Eine frühe Diagnose kann jedoch entscheidend sein. Forschern gewinnen nun eine neue Erkenntnis, die wegweisend sein könnte.
Keiner ist davor gefeit: Das Risiko, an Krebs zu erkranken, besteht für jeden. Eine frühe Diagnose kann jedoch entscheidend sein. Forschern gewinnen nun eine neue Erkenntnis, die wegweisend sein könnte.
 In Nordfrankreich ist ein Mensch am Chikungunya-Fieber erkrankt. Anders als in früheren Fällen wurde die Person offenbar vor Ort von einer Mücke gestochen. Die Behörden schließen Fälle in Deutschland nicht mehr aus.
In Nordfrankreich ist ein Mensch am Chikungunya-Fieber erkrankt. Anders als in früheren Fällen wurde die Person offenbar vor Ort von einer Mücke gestochen. Die Behörden schließen Fälle in Deutschland nicht mehr aus.
 Samsung stellt bereits die siebte Generation seiner Smartphones mit flexiblen Displays vor. Vor allem das Galaxy Z Fold zeigt sich stark verbessert, aber auch beim Z Flip hat sich einiges getan. Außerdem gibt es erstmals einen Falter für knapp unter 1000 Euro und eine neue Galaxy Watch.
Samsung stellt bereits die siebte Generation seiner Smartphones mit flexiblen Displays vor. Vor allem das Galaxy Z Fold zeigt sich stark verbessert, aber auch beim Z Flip hat sich einiges getan. Außerdem gibt es erstmals einen Falter für knapp unter 1000 Euro und eine neue Galaxy Watch.
 Elon Musk will mit Grok im KI-Wettrennen aufholen. Doch in den letzten Tagen machte der Bot so viele Fehler, dass das Unternehmen ihn aus dem Verkehr ziehen musste. Für den Milliardär kommen die Probleme zur Unzeit.
Elon Musk will mit Grok im KI-Wettrennen aufholen. Doch in den letzten Tagen machte der Bot so viele Fehler, dass das Unternehmen ihn aus dem Verkehr ziehen musste. Für den Milliardär kommen die Probleme zur Unzeit.
 Welcher Mathematiker schon in den Fünfzigerjahren über denkende Maschinen nachdachte und wie ChatGPT das Lesen lernte: die wichtigsten Fakten über künstliche Intelligenz.
Welcher Mathematiker schon in den Fünfzigerjahren über denkende Maschinen nachdachte und wie ChatGPT das Lesen lernte: die wichtigsten Fakten über künstliche Intelligenz.
 Hitzewellen sind besonders für ältere Menschen lebensgefährlich. Studien zufolge sterben in den vergangenen Jahren Zehntausende aus der Gruppe ab 65 Jahren. In Europa steigt die Wärme am stärksten an. Nun zeigt auch ein Bericht des UN-Umweltprogramms die Risiken auf - und macht Lösungsvorschläge.
Hitzewellen sind besonders für ältere Menschen lebensgefährlich. Studien zufolge sterben in den vergangenen Jahren Zehntausende aus der Gruppe ab 65 Jahren. In Europa steigt die Wärme am stärksten an. Nun zeigt auch ein Bericht des UN-Umweltprogramms die Risiken auf - und macht Lösungsvorschläge.
 Flugzeuge verursachen massive Klimaschäden, nicht nur durch ihren CO2-Ausstoß. Die EU verlangt nun detaillierte Berichte über diese Effekte, doch die Luftfahrtbranche wehrt sich gegen zusätzliche Auflagen.
Flugzeuge verursachen massive Klimaschäden, nicht nur durch ihren CO2-Ausstoß. Die EU verlangt nun detaillierte Berichte über diese Effekte, doch die Luftfahrtbranche wehrt sich gegen zusätzliche Auflagen.
 Koalas verbringen fast ihr ganzes Leben auf Bäumen. Am Boden sind sie extrem selten. Doch wenn sie es müssen, endet das für sie oft tödlich. Das hat einer Studie zufolge vor allem zwei Gründe.
Koalas verbringen fast ihr ganzes Leben auf Bäumen. Am Boden sind sie extrem selten. Doch wenn sie es müssen, endet das für sie oft tödlich. Das hat einer Studie zufolge vor allem zwei Gründe.
 Im Kampf gegen islamistische Propaganda hat die Kommission für Jugendmedienschutz (KJM) eine Sperrverfügung für kalifat.com ausgesprochen. Demnach stelle das Angebot eine »konkrete Gefahr für den Frieden dar.«
Im Kampf gegen islamistische Propaganda hat die Kommission für Jugendmedienschutz (KJM) eine Sperrverfügung für kalifat.com ausgesprochen. Demnach stelle das Angebot eine »konkrete Gefahr für den Frieden dar.«
 Ein KI-gesteuerter Roboter führt erstmals autonom eine Operation durch. Die Gallenblasenentfernung an einem Schwein zeigt Präzision und Anpassungsfähigkeit. Forscher sehen darin einen Meilenstein für die autonome Chirurgie der Zukunft.
Ein KI-gesteuerter Roboter führt erstmals autonom eine Operation durch. Die Gallenblasenentfernung an einem Schwein zeigt Präzision und Anpassungsfähigkeit. Forscher sehen darin einen Meilenstein für die autonome Chirurgie der Zukunft.
 KI-Browser sind die Zukunft der Internet-Suche. Perplexity Comet ist seit heute eingeschränkt am Markt, OpenAI ist kurz davor und unterstützt weitere Konkurrenten. Auch Underdogs wie Brave oder Opera Neon suchen ihre KI-Chance. Dies könnte die Dominanz von Google Chrome gefährden, doch der Browser-König ist auf den Angriff vorbereitet.
KI-Browser sind die Zukunft der Internet-Suche. Perplexity Comet ist seit heute eingeschränkt am Markt, OpenAI ist kurz davor und unterstützt weitere Konkurrenten. Auch Underdogs wie Brave oder Opera Neon suchen ihre KI-Chance. Dies könnte die Dominanz von Google Chrome gefährden, doch der Browser-König ist auf den Angriff vorbereitet.
 Die Weltmeere sind von Plastikmüll durchsetzt. Laut einer neuen Analyse könnte es noch mehr sein als gedacht - das fanden Forscher bei der Analyse von Nanopartikeln im Nordatlantik heraus. Das Erschreckende: Diese machen womöglich den Großteil des Plastiks in den Ozeanen aus.
Die Weltmeere sind von Plastikmüll durchsetzt. Laut einer neuen Analyse könnte es noch mehr sein als gedacht - das fanden Forscher bei der Analyse von Nanopartikeln im Nordatlantik heraus. Das Erschreckende: Diese machen womöglich den Großteil des Plastiks in den Ozeanen aus.
 Die Interims-Chefin wurde gefeuert, viele andere gehen freiwillig: Mehr als 2000 Weltraumfachleute haben das Angebot angenommen, die Nasa zu verlassen. Experten warnen vor einem »Ende des Weltraumprogramms, wie wir es kennen«.
Die Interims-Chefin wurde gefeuert, viele andere gehen freiwillig: Mehr als 2000 Weltraumfachleute haben das Angebot angenommen, die Nasa zu verlassen. Experten warnen vor einem »Ende des Weltraumprogramms, wie wir es kennen«.
 Viele Infektionen mit Humanen Papillomviren klingen ohne negative Folgen wieder ab. Bestimmte Varianten der Viren können jedoch Gebärmutterhalskrebs auslösen. Seit Jahren empfehlen Experten daher die HPV-Impfung. Eine Studie aus Dänemark zeigt jetzt, dass diese wirksam ist.
Viele Infektionen mit Humanen Papillomviren klingen ohne negative Folgen wieder ab. Bestimmte Varianten der Viren können jedoch Gebärmutterhalskrebs auslösen. Seit Jahren empfehlen Experten daher die HPV-Impfung. Eine Studie aus Dänemark zeigt jetzt, dass diese wirksam ist.
 Ein Komet aus einer fremden Region der Milchstraße könnte der älteste bisher entdeckte sein. Forschende schätzen sein Alter auf über sieben Milliarden Jahre. Während der kilometergroße Brocken in Richtung Sonne rast, gibt ein ESA-Experte Entwarnung für die Erde.
Ein Komet aus einer fremden Region der Milchstraße könnte der älteste bisher entdeckte sein. Forschende schätzen sein Alter auf über sieben Milliarden Jahre. Während der kilometergroße Brocken in Richtung Sonne rast, gibt ein ESA-Experte Entwarnung für die Erde.
 Der Himmelskörper 31/ATLAS wurde Anfang der Monats mit einem speziellen Teleskop entdeckt. Nun sind sich Forschende sicher: Das Objekt ist nicht nur extrem alt, sondern auch aus einem fremden Teil der Galaxie.
Der Himmelskörper 31/ATLAS wurde Anfang der Monats mit einem speziellen Teleskop entdeckt. Nun sind sich Forschende sicher: Das Objekt ist nicht nur extrem alt, sondern auch aus einem fremden Teil der Galaxie.
 Der Himmelskörper 3I/ATLAS wurde Anfang der Monats mit einem speziellen Teleskop entdeckt. Nun sind sich Forschende sicher: Das Objekt ist nicht nur extrem alt, sondern auch aus einem fremden Teil der Galaxie.
Der Himmelskörper 3I/ATLAS wurde Anfang der Monats mit einem speziellen Teleskop entdeckt. Nun sind sich Forschende sicher: Das Objekt ist nicht nur extrem alt, sondern auch aus einem fremden Teil der Galaxie.
 Es sind die Relikte eines antiken Weltwunders: Archäologen haben 22 Fundamentblöcke des Leuchtturms von Alexandria aus dem Meer befördert. Mit den gigantischen Puzzleteilen haben sie große Pläne.
Es sind die Relikte eines antiken Weltwunders: Archäologen haben 22 Fundamentblöcke des Leuchtturms von Alexandria aus dem Meer befördert. Mit den gigantischen Puzzleteilen haben sie große Pläne.
 Zur Jahreshälfte zählen Experten auf Kreuzfahrtschiffen fast so viele Norovirus-Ausbrüche wie im Vorjahr insgesamt. Das kann an einer neuen Variante liegen, die Passagiere ungeschützt trifft. Zugleich bietet diese Art des Reisens dem Magen-Darm-Erreger die allerbesten Bedingungen.
Zur Jahreshälfte zählen Experten auf Kreuzfahrtschiffen fast so viele Norovirus-Ausbrüche wie im Vorjahr insgesamt. Das kann an einer neuen Variante liegen, die Passagiere ungeschützt trifft. Zugleich bietet diese Art des Reisens dem Magen-Darm-Erreger die allerbesten Bedingungen.
 Anja Thiedke hat 30 Kilogramm abgenommen, seit sie sich jede Woche Wegovy spritzt. Was sind ihre Erfahrungen? Und was weiß die Forschung zwei Jahre nach der Zulassung des Medikaments? Eine Bilanz.
Anja Thiedke hat 30 Kilogramm abgenommen, seit sie sich jede Woche Wegovy spritzt. Was sind ihre Erfahrungen? Und was weiß die Forschung zwei Jahre nach der Zulassung des Medikaments? Eine Bilanz.
 Die Merz-Regierung will wieder mehr deutsches Erdgas fördern. Doch wo gibt es das überhaupt noch? Und kommt man da so einfach ran? Die SPIEGEL-Analyse in Grafiken.
Die Merz-Regierung will wieder mehr deutsches Erdgas fördern. Doch wo gibt es das überhaupt noch? Und kommt man da so einfach ran? Die SPIEGEL-Analyse in Grafiken.
 Wie lange sollte man verreisen, um wirklich zu entspannen? Und wie lässt sich das Feriengefühl in den Alltag retten? Neurowissenschaftler und Psychologinnen haben herausgefunden: Weniger ist mehr. Die SPIEGEL-Titelstory.
Wie lange sollte man verreisen, um wirklich zu entspannen? Und wie lässt sich das Feriengefühl in den Alltag retten? Neurowissenschaftler und Psychologinnen haben herausgefunden: Weniger ist mehr. Die SPIEGEL-Titelstory.
 Das Abschalten der Triebwerke führte laut dem vorläufigen Untersuchungsbericht zum Absturz der Air-India-Maschine. Luftfahrtexperte Heinrich Großbongardt ist überzeugt: Einer der beiden Piloten hat vorsätzlich gehandelt.
Das Abschalten der Triebwerke führte laut dem vorläufigen Untersuchungsbericht zum Absturz der Air-India-Maschine. Luftfahrtexperte Heinrich Großbongardt ist überzeugt: Einer der beiden Piloten hat vorsätzlich gehandelt.
 Die US-Regierung nutzt Mängel in Studien, um die Autonomie der Wissenschaft immer stärker einzuschränken. Hier spricht der Nobelpreisträger Thomas Südhof über eigene Fehler und die Rolle von Joe Biden bei Trumps Aufstieg.
Die US-Regierung nutzt Mängel in Studien, um die Autonomie der Wissenschaft immer stärker einzuschränken. Hier spricht der Nobelpreisträger Thomas Südhof über eigene Fehler und die Rolle von Joe Biden bei Trumps Aufstieg.
 Lucy Guo gründete mit 21 das Start-up Scale AI, mit 30 machte sie das Unternehmen zur Milliardärin. Hier sagt sie, was ihr der Reichtum bedeutet und wie es um den Feminismus im Silicon Valley steht.
Lucy Guo gründete mit 21 das Start-up Scale AI, mit 30 machte sie das Unternehmen zur Milliardärin. Hier sagt sie, was ihr der Reichtum bedeutet und wie es um den Feminismus im Silicon Valley steht.
 150.000 Menschen haben mitgemacht – nun liegen Zahlen vor: Die Bundesnetzagentur hat die Mobilfunkqualität in Deutschland untersucht. Probleme gibt es demnach unter anderem im Südwesten.
150.000 Menschen haben mitgemacht – nun liegen Zahlen vor: Die Bundesnetzagentur hat die Mobilfunkqualität in Deutschland untersucht. Probleme gibt es demnach unter anderem im Südwesten.
 China, größter CO2-Emittent der Welt, verzeichnet laut einer Analyse erstmals einen Rückgang seines Ausstoßes. Der massive Ausbau Erneuerbarer Energien und eine zunehmende Elektrifizierung sollen dafür verantwortlich sein. Doch der Trend bleibt fragil.
China, größter CO2-Emittent der Welt, verzeichnet laut einer Analyse erstmals einen Rückgang seines Ausstoßes. Der massive Ausbau Erneuerbarer Energien und eine zunehmende Elektrifizierung sollen dafür verantwortlich sein. Doch der Trend bleibt fragil.
 Erst wurde das badische Kehl von Drüsenameisen geplagt, nun sorgt in der Region eine weitere invasive Art für Schlagzeilen. Sie wurde aktuell in Karlsruhe nachgewiesen und nervt die Anwohner gehörig.
Erst wurde das badische Kehl von Drüsenameisen geplagt, nun sorgt in der Region eine weitere invasive Art für Schlagzeilen. Sie wurde aktuell in Karlsruhe nachgewiesen und nervt die Anwohner gehörig.
 Auf der Suche nach Nahrung verwüsten die rosafarbenen Vögel Anbauflächen für Risottoreis. Die Bauern wollen sie mit Lärm vertreiben. Ein Ornithologe schlägt eine andere Methode vor.
Auf der Suche nach Nahrung verwüsten die rosafarbenen Vögel Anbauflächen für Risottoreis. Die Bauern wollen sie mit Lärm vertreiben. Ein Ornithologe schlägt eine andere Methode vor.
 Sie heißen Wegovy oder Mounjaro: Abnehmspritzen können Übergewicht bekämpfen. Der Mediziner Hans Hauner sagt, für wen die Mittel geeignet sind, und warum er findet, dass Krankenkassen zahlen sollten.
Sie heißen Wegovy oder Mounjaro: Abnehmspritzen können Übergewicht bekämpfen. Der Mediziner Hans Hauner sagt, für wen die Mittel geeignet sind, und warum er findet, dass Krankenkassen zahlen sollten.
 Das Nothing Phone (3) ist das erste Nothing-Smartphone, das ganz oben mitspielen, aber trotzdem anders als die anderen sein soll. Der Praxistest zeigt, dass das Konzept technisch weitgehend aufgeht. Die große Frage ist, ob Nutzerinnen und Nutzer bereit sind, den Preis dafür zu bezahlen und das neue Design mögen.
Das Nothing Phone (3) ist das erste Nothing-Smartphone, das ganz oben mitspielen, aber trotzdem anders als die anderen sein soll. Der Praxistest zeigt, dass das Konzept technisch weitgehend aufgeht. Die große Frage ist, ob Nutzerinnen und Nutzer bereit sind, den Preis dafür zu bezahlen und das neue Design mögen.
 Viele Länder haben schon Maßnahmen gegen die KI-Anwendung DeepSeek ergriffen, nun kommen auch aus Berlin klare Worte: Der Chatbot verstoße gegen europäisches Recht, so die Datenschutzbeauftragte.
Viele Länder haben schon Maßnahmen gegen die KI-Anwendung DeepSeek ergriffen, nun kommen auch aus Berlin klare Worte: Der Chatbot verstoße gegen europäisches Recht, so die Datenschutzbeauftragte.
 Der X-Account von Elmo ist am Sonntag von Unbekannten gekapert worden. Im Namen der populären »Sesamstraße«-Puppe wurde Judenhass verbreitet und verbal gegen US-Präsident Trump geschossen.
Der X-Account von Elmo ist am Sonntag von Unbekannten gekapert worden. Im Namen der populären »Sesamstraße«-Puppe wurde Judenhass verbreitet und verbal gegen US-Präsident Trump geschossen.
 Vor der Küste Grönlands treibt ein Koloss von Eisberg bedrohlich nahe am Hafen einer kleinen Siedlung. Behörden warnen vor einer möglichen Flutwelle und mahnen zur Vorsicht. Es ist nicht das erste Mal, dass die Siedlung sich einem eisigen Riesen gegenübersieht.
Vor der Küste Grönlands treibt ein Koloss von Eisberg bedrohlich nahe am Hafen einer kleinen Siedlung. Behörden warnen vor einer möglichen Flutwelle und mahnen zur Vorsicht. Es ist nicht das erste Mal, dass die Siedlung sich einem eisigen Riesen gegenübersieht.
 Absicht oder Defekt? In der Diskussion um abgeschaltete Treibstoffregler in der abgestürzten Air-India-Boeing kommen Experten zu unterschiedlichen Einschätzungen. Der Chef der Airline warnt vor voreiligen Schlüssen.
Absicht oder Defekt? In der Diskussion um abgeschaltete Treibstoffregler in der abgestürzten Air-India-Boeing kommen Experten zu unterschiedlichen Einschätzungen. Der Chef der Airline warnt vor voreiligen Schlüssen.
 Astronomen sind auf ein rekordverdächtiges Ereignis im All gestoßen: die Entstehung eines schwarzen Lochs mit der 225-fachen Masse unserer Sonne. Es stellt gängige wissenschaftliche Annahmen infrage.
Astronomen sind auf ein rekordverdächtiges Ereignis im All gestoßen: die Entstehung eines schwarzen Lochs mit der 225-fachen Masse unserer Sonne. Es stellt gängige wissenschaftliche Annahmen infrage.
 Sie heißen Wegovy oder Mounjaro: Abnehmspritzen können Übergewicht bekämpfen. Der Mediziner Hans Hauner sagt, für wen die Mittel geeignet sind und warum er findet, dass Krankenkassen zahlen sollten.
Sie heißen Wegovy oder Mounjaro: Abnehmspritzen können Übergewicht bekämpfen. Der Mediziner Hans Hauner sagt, für wen die Mittel geeignet sind und warum er findet, dass Krankenkassen zahlen sollten.
 Absicht oder Defekt? In der Diskussion über abgeschaltete Treibstoffregler in der abgestürzten Air-India-Boeing kommen Experten zu unterschiedlichen Einschätzungen. Der Chef der Airline warnt vor voreiligen Schlüssen.
Absicht oder Defekt? In der Diskussion über abgeschaltete Treibstoffregler in der abgestürzten Air-India-Boeing kommen Experten zu unterschiedlichen Einschätzungen. Der Chef der Airline warnt vor voreiligen Schlüssen.
 Eine aktuelle US-Studie zeigt, wie die persönliche Weltsicht die Bewertung von Führungspersonen beeinflusst. Während manche laute, empathielose Chefs bewundern, empfinden andere sie als unqualifiziert. Die Ergebnisse werfen ein neues Licht auf die Psychologie von Macht und Führung.
Eine aktuelle US-Studie zeigt, wie die persönliche Weltsicht die Bewertung von Führungspersonen beeinflusst. Während manche laute, empathielose Chefs bewundern, empfinden andere sie als unqualifiziert. Die Ergebnisse werfen ein neues Licht auf die Psychologie von Macht und Führung.
 Jurassic Park in echt? Davon träumt offenbar "Herr der Ringe"-Regisseur Peter Jackson und investiert Millionen in die Wiederbelebung eines ausgestorbenen Riesenvogels. Kritiker sprechen derweil von Designer-Tieren und warnen vor ethischen und ökologischen Problemen.
Jurassic Park in echt? Davon träumt offenbar "Herr der Ringe"-Regisseur Peter Jackson und investiert Millionen in die Wiederbelebung eines ausgestorbenen Riesenvogels. Kritiker sprechen derweil von Designer-Tieren und warnen vor ethischen und ökologischen Problemen.
 Die traditionellen Schlittenhunde könnten früher als gedacht mit den Inuit nach Grönland gelangt sein. Strenge Gesetze sollen die Tiere schützen, doch der Klimawandel und veränderte Lebensweisen bedrohen ihr Erbe.
Die traditionellen Schlittenhunde könnten früher als gedacht mit den Inuit nach Grönland gelangt sein. Strenge Gesetze sollen die Tiere schützen, doch der Klimawandel und veränderte Lebensweisen bedrohen ihr Erbe.
 Eine neue Studie zeigt, dass Radarsysteme von Flughäfen wie Frankfurt einer hypothetischen außerirdischen Zivilisation einen Hinweis auf intelligentes Leben auf der Erde geben könnten. Menschliche Signale sollen sogar über 200 Lichtjahre entfernt sichtbar sein.
Eine neue Studie zeigt, dass Radarsysteme von Flughäfen wie Frankfurt einer hypothetischen außerirdischen Zivilisation einen Hinweis auf intelligentes Leben auf der Erde geben könnten. Menschliche Signale sollen sogar über 200 Lichtjahre entfernt sichtbar sein.
 Emily Pellegrini zeigt sich ihren 350.000 Followern häufig im Bikini. Dem Mann, der sie mittels KI erschaffen hat, bringt sie viel Geld ein. SPIEGEL-Redakteurin Angela Gruber berichtet über den Aufstieg eines Geschäftsmodells.
Emily Pellegrini zeigt sich ihren 350.000 Followern häufig im Bikini. Dem Mann, der sie mittels KI erschaffen hat, bringt sie viel Geld ein. SPIEGEL-Redakteurin Angela Gruber berichtet über den Aufstieg eines Geschäftsmodells.
 Jahrzehntelang wurde schwach-radioaktiver Müll in der Tiefsee versenkt. Forschende haben in einem der Gebiete überraschende Funde gemacht: Die Fässer könnten Teil eines neuen Ökosystems geworden sein.
Jahrzehntelang wurde schwach-radioaktiver Müll in der Tiefsee versenkt. Forschende haben in einem der Gebiete überraschende Funde gemacht: Die Fässer könnten Teil eines neuen Ökosystems geworden sein.
 Durch den Bau von Tausenden Staudämmen weltweit hat die Menschheit die Rotationsachse der Erde bewegt. Die künstlichen Gewässer beeinflussen außerdem den Meeresspiegel.
Durch den Bau von Tausenden Staudämmen weltweit hat die Menschheit die Rotationsachse der Erde bewegt. Die künstlichen Gewässer beeinflussen außerdem den Meeresspiegel.
 Welcher Mathematiker schon in den Fünfzigerjahren über denkende Maschinen nachdachte und wie ChatGPT das Lesen lernte: die wichtigsten Fakten über künstliche Intelligenz.
Welcher Mathematiker schon in den Fünfzigerjahren über denkende Maschinen nachdachte und wie ChatGPT das Lesen lernte: die wichtigsten Fakten über künstliche Intelligenz.
 Jahrelang erforschte Mark McCaughrean das Weltall. Nun beschreibt er in einem Reiseführer die faszinierendsten Orte. Hier spricht er über Douglas Adams, Elon Musks Marsprojekt und außerirdisches Leben.
Jahrelang erforschte Mark McCaughrean das Weltall. Nun beschreibt er in einem Reiseführer die faszinierendsten Orte. Hier spricht er über Douglas Adams, Elon Musks Marsprojekt und außerirdisches Leben.
 Schwarze Löcher besitzen eine extrem hohe Schwerkraft. Nun gibt es Hinweise, die auf eine Verschmelzung zweier dieser astronomischen Objekte schließen lassen. Das mit Gravitationswellen entdeckte Ereignis bringt jedoch bisherige Theorien ins Wanken.
Schwarze Löcher besitzen eine extrem hohe Schwerkraft. Nun gibt es Hinweise, die auf eine Verschmelzung zweier dieser astronomischen Objekte schließen lassen. Das mit Gravitationswellen entdeckte Ereignis bringt jedoch bisherige Theorien ins Wanken.
 Köln wird im August wieder Zentrum für Gaming-Fans aus der ganzen Welt. Die Veranstalter rechnen mit der "größten Gamescom aller Zeiten". Es dürfte einen neuen Rekord an Ausstellern geben - und vielleicht auch bei den Besuchern.
Köln wird im August wieder Zentrum für Gaming-Fans aus der ganzen Welt. Die Veranstalter rechnen mit der "größten Gamescom aller Zeiten". Es dürfte einen neuen Rekord an Ausstellern geben - und vielleicht auch bei den Besuchern.
 In Florida hilft eine Hauskatze bei der wissenschaftlichen Arbeit ihres Besitzers. Bereits zum zweiten Mal ist sie an der Entdeckung eines neuen Virusstamms beteiligt. Der Fund wirft gleichzeitig auch ein Schlaglicht auf die Risiken von Freigängerkatzen.
In Florida hilft eine Hauskatze bei der wissenschaftlichen Arbeit ihres Besitzers. Bereits zum zweiten Mal ist sie an der Entdeckung eines neuen Virusstamms beteiligt. Der Fund wirft gleichzeitig auch ein Schlaglicht auf die Risiken von Freigängerkatzen.
 »Nius« ist am Wochenende Ziel einer Hackerattacke geworden. Im Zuge der Attacke wurde ein Link zu einem Dokument gestreut, das Kundendaten des rechtspopulistischen Portals enthält.
»Nius« ist am Wochenende Ziel einer Hackerattacke geworden. Im Zuge der Attacke wurde ein Link zu einem Dokument gestreut, das Kundendaten des rechtspopulistischen Portals enthält.
 Die Ursache der Flugzeugkatastrophe im indischen Ahmedabad ist geklärt, die Treibstoffzufuhr wurde unterbrochen. Wie es dazu kam, ist aber weiterhin unklar. Nun wird diskutiert, ob im Cockpit gefilmt werden muss, und wenn ja, wie.
Die Ursache der Flugzeugkatastrophe im indischen Ahmedabad ist geklärt, die Treibstoffzufuhr wurde unterbrochen. Wie es dazu kam, ist aber weiterhin unklar. Nun wird diskutiert, ob im Cockpit gefilmt werden muss, und wenn ja, wie.
 Der digitale Bilderrahmen Aura Aspen ist ideal, um Smartphone-Fotos im Quer- oder Hochformat zu präsentieren. Man kann ihn von überall auf der Welt bestücken und bedienen, sein zwölf Zoll großes Display ist ausgezeichnet und man hat unbegrenzten Cloud-Speicher.
Der digitale Bilderrahmen Aura Aspen ist ideal, um Smartphone-Fotos im Quer- oder Hochformat zu präsentieren. Man kann ihn von überall auf der Welt bestücken und bedienen, sein zwölf Zoll großes Display ist ausgezeichnet und man hat unbegrenzten Cloud-Speicher.
 Der einzige Kampfeinsatz der »Admiral Kusnezow« erwies sich als Fehlschlag. Selbst in der Werft kam es zu spektakulären Pannen auf dem Flugzeugträger. Jetzt sieht es so aus, als ob er nie wieder in See stechen wird.
Der einzige Kampfeinsatz der »Admiral Kusnezow« erwies sich als Fehlschlag. Selbst in der Werft kam es zu spektakulären Pannen auf dem Flugzeugträger. Jetzt sieht es so aus, als ob er nie wieder in See stechen wird.
 Einnahmen von zehntausend Euro im Monat, aber nicht einmal eine Steuernummer: Fahnder in Nordrhein-Westfalen gehen gegen Influencer vor, die "mit hoher krimineller Energie" ihr Geld am Staat vorbeischleusen.
Einnahmen von zehntausend Euro im Monat, aber nicht einmal eine Steuernummer: Fahnder in Nordrhein-Westfalen gehen gegen Influencer vor, die "mit hoher krimineller Energie" ihr Geld am Staat vorbeischleusen.
 Im Sommer mit dem Motorboot über den See flitzen - für viele Menschen ist das der ultimative Freizeitspaß. Doch Wellen und Liegeplätze schädigen Tiere, Pflanzen und Sedimente. Forscher fordern daher strengere Regeln, um empfindliche Ökosysteme zu schützen.
Im Sommer mit dem Motorboot über den See flitzen - für viele Menschen ist das der ultimative Freizeitspaß. Doch Wellen und Liegeplätze schädigen Tiere, Pflanzen und Sedimente. Forscher fordern daher strengere Regeln, um empfindliche Ökosysteme zu schützen.
 Einnahmen von zehntausend Euro im Monat, aber nicht einmal eine Steuernummer: Fahnder in Nordrhein-Westfalen gehen gegen Influencer vor, die »mit hoher krimineller Energie« ihr Geld am Staat vorbeischleusen.
Einnahmen von zehntausend Euro im Monat, aber nicht einmal eine Steuernummer: Fahnder in Nordrhein-Westfalen gehen gegen Influencer vor, die »mit hoher krimineller Energie« ihr Geld am Staat vorbeischleusen.
 Smartphone, Fernseher, Konsole: Wenn Kinder mit digitalen Geräten beschäftigt sind, entlastet das oft den Alltag der Eltern – aber nicht ihr Gewissen. Eine Umfrage zeigt, wie Familien mit der Mediennutzung umgehen.
Smartphone, Fernseher, Konsole: Wenn Kinder mit digitalen Geräten beschäftigt sind, entlastet das oft den Alltag der Eltern – aber nicht ihr Gewissen. Eine Umfrage zeigt, wie Familien mit der Mediennutzung umgehen.
 Mehrere Strafverfolgungsbehörden sind in einer international abgestimmten Aktion gegen die Hackergruppe »NoName057(16)« vorgegangen. Laut BKA konnte das Botnetz heruntergenommen werden.
Mehrere Strafverfolgungsbehörden sind in einer international abgestimmten Aktion gegen die Hackergruppe »NoName057(16)« vorgegangen. Laut BKA konnte das Botnetz heruntergenommen werden.
 Nach einem halben Jahrhundert wird ein seltener Zwergkiwi wieder auf Neuseelands Festland entdeckt. Die Art galt auf den beiden Hauptinseln eigentlich als ausgerottet. Nach einer ersten Sichtung sorgte ein Ranger für Gewissheit. Experten sprechen von einem Wunder.
Nach einem halben Jahrhundert wird ein seltener Zwergkiwi wieder auf Neuseelands Festland entdeckt. Die Art galt auf den beiden Hauptinseln eigentlich als ausgerottet. Nach einer ersten Sichtung sorgte ein Ranger für Gewissheit. Experten sprechen von einem Wunder.
 Das Objekt 3I/ATLAS kommt aus den Tiefen des Weltraums und bewegt sich rasend schnell durch unser Sonnensystem. Neue Aufnahmen zeigen nun die sogenannte Koma des Flugkörpers.
Das Objekt 3I/ATLAS kommt aus den Tiefen des Weltraums und bewegt sich rasend schnell durch unser Sonnensystem. Neue Aufnahmen zeigen nun die sogenannte Koma des Flugkörpers.
 Ein Wiener Forschungsteam entwickelt einen Bluttest, der das Risiko für Multiple Sklerose vor Symptombeginn erkennt - sogar bis zu zwölf Jahre vor den ersten Anzeichen. Antikörper gegen das Epstein-Barr-Virus dienen dabei als Schlüsselindikator.
Ein Wiener Forschungsteam entwickelt einen Bluttest, der das Risiko für Multiple Sklerose vor Symptombeginn erkennt - sogar bis zu zwölf Jahre vor den ersten Anzeichen. Antikörper gegen das Epstein-Barr-Virus dienen dabei als Schlüsselindikator.
 Stiftung Warentest prüft 14 Smart-Home-Systeme, nur 4 von ihnen sind gut. Die meisten großen Anbieter können nicht überzeugen, der beliebteste Router-Anbieter gehört zu den Verlierern.
Stiftung Warentest prüft 14 Smart-Home-Systeme, nur 4 von ihnen sind gut. Die meisten großen Anbieter können nicht überzeugen, der beliebteste Router-Anbieter gehört zu den Verlierern.
 Allein in NRW sollen Netzstars rund 300 Millionen Euro Steuern hinterzogen haben. Schätzen jedenfalls Steuerfahnder. Kann das sein? Und was könnten Influencer tun, die sich ertappt fühlen?
Allein in NRW sollen Netzstars rund 300 Millionen Euro Steuern hinterzogen haben. Schätzen jedenfalls Steuerfahnder. Kann das sein? Und was könnten Influencer tun, die sich ertappt fühlen?
 Eine neue Studie zeigt, dass der Bau tausender Staudämme in den vergangenen 200 Jahren die geografischen Pole der Erde verschoben hat. Laut dem Forscherteam droht deshalb zwar keine neue Eiszeit - allerdings könnte es Folgen für den Anstieg des Meeresspiegels haben.
Eine neue Studie zeigt, dass der Bau tausender Staudämme in den vergangenen 200 Jahren die geografischen Pole der Erde verschoben hat. Laut dem Forscherteam droht deshalb zwar keine neue Eiszeit - allerdings könnte es Folgen für den Anstieg des Meeresspiegels haben.
 Die Bundeswehr hat keine weitreichenden Waffen im Arsenal. Auf der Wunschliste: das US-System Typhon. Damit könnte Deutschland bis tief in russisches Territorium zielen.
Die Bundeswehr hat keine weitreichenden Waffen im Arsenal. Auf der Wunschliste: das US-System Typhon. Damit könnte Deutschland bis tief in russisches Territorium zielen.
 Die Zahl der geborenen Kinder in Deutschland sinkt weiter. Besonders unter Frauen mit deutscher Staatsangehörigkeit und in Metropolen wie Berlin ist die Lust am Mutterwerden besonders niedrig.
Die Zahl der geborenen Kinder in Deutschland sinkt weiter. Besonders unter Frauen mit deutscher Staatsangehörigkeit und in Metropolen wie Berlin ist die Lust am Mutterwerden besonders niedrig.
 Ein Unbekannter gibt sich als Anwalt aus und erklärt einem Mann, seine Tochter habe einen Unfall verursacht und könne für eine hohe Summe freigekauft werden. Der Senior glaubte dem Anrufer.
Ein Unbekannter gibt sich als Anwalt aus und erklärt einem Mann, seine Tochter habe einen Unfall verursacht und könne für eine hohe Summe freigekauft werden. Der Senior glaubte dem Anrufer.
 Ein Unbekannter gibt sich als Anwalt aus und erklärt einem Mann, seine Tochter habe einen Unfall verursacht und könne für eine hohe Summe freigekauft werden. Der Senior glaubt dem Anrufer.
Ein Unbekannter gibt sich als Anwalt aus und erklärt einem Mann, seine Tochter habe einen Unfall verursacht und könne für eine hohe Summe freigekauft werden. Der Senior glaubt dem Anrufer.
 Ein Blitzschlag, dann facht starker Wind das Feuer an: Seit fast zwei Wochen wüten verheerende Waldbrände im Nationalpark Grand Canyon in Arizona. Von der Südseite des Parks können Besucher das Drama sehen.
Ein Blitzschlag, dann facht starker Wind das Feuer an: Seit fast zwei Wochen wüten verheerende Waldbrände im Nationalpark Grand Canyon in Arizona. Von der Südseite des Parks können Besucher das Drama sehen.
 Junge Sterne sind von Gas- und Staubringen umgeben. In diesen sammeln sich Mineralien, die im Laufe der Zeit zu neuen Planeten zusammenwachsen können. Astronomen beobachten jetzt erstmals den Beginn dieses Prozesses. Die Entdeckung könnte wertvolle Einblicke geben.
Junge Sterne sind von Gas- und Staubringen umgeben. In diesen sammeln sich Mineralien, die im Laufe der Zeit zu neuen Planeten zusammenwachsen können. Astronomen beobachten jetzt erstmals den Beginn dieses Prozesses. Die Entdeckung könnte wertvolle Einblicke geben.
 Eltern wollen, dass ihre Kinder gesund sind. Doch was, wenn die Gefahr besteht, mit den Genen auch unheilbare Krankheiten zu übertragen? Fachleute in Großbritannien berichten von einem bahnbrechenden Ausweg.
Eltern wollen, dass ihre Kinder gesund sind. Doch was, wenn die Gefahr besteht, mit den Genen auch unheilbare Krankheiten zu übertragen? Fachleute in Großbritannien berichten von einem bahnbrechenden Ausweg.
 Es ist kein völlig neues Gerät, aber die siebte Generation des Samsung Galaxy Z Fold ist schon etwas Besonderes. Erstaunlich ist vor allem, dass es Samsung gelungen ist, beide Bildschirme zu vergrößern und das Falt-Smartphone gleichzeitig nochmals deutlich dünner zu machen.
Es ist kein völlig neues Gerät, aber die siebte Generation des Samsung Galaxy Z Fold ist schon etwas Besonderes. Erstaunlich ist vor allem, dass es Samsung gelungen ist, beide Bildschirme zu vergrößern und das Falt-Smartphone gleichzeitig nochmals deutlich dünner zu machen.
 Meta will die erste Superintelligenz schaffen. Doch beim Bau der nötigen Rechenzentren ging es Firmenchef Mark Zuckerberg zu langsam voran. Nun setzt er auf eine ungewöhnliche Lösung.
Meta will die erste Superintelligenz schaffen. Doch beim Bau der nötigen Rechenzentren ging es Firmenchef Mark Zuckerberg zu langsam voran. Nun setzt er auf eine ungewöhnliche Lösung.
 Der KI-Chatbot Grok war wegen antisemitischer und kontroverser Aussagen kritisiert worden. Musk hatte die Fehlerserie auf X erst gerechtfertigt, jetzt postete sein Unternehmen doch noch eine Entschuldigung.
Der KI-Chatbot Grok war wegen antisemitischer und kontroverser Aussagen kritisiert worden. Musk hatte die Fehlerserie auf X erst gerechtfertigt, jetzt postete sein Unternehmen doch noch eine Entschuldigung.
 Der frühere Trigema-Chef Wolfgang Grupp geht ungewöhnliche Wege und macht seine Altersdepression öffentlich. Auf diese Weise rückt die lebensgefährliche Erkrankung, unter der viele Menschen leiden, ins gesellschaftliche Bewusstsein. Aber was verbirgt sich dahinter?
Der frühere Trigema-Chef Wolfgang Grupp geht ungewöhnliche Wege und macht seine Altersdepression öffentlich. Auf diese Weise rückt die lebensgefährliche Erkrankung, unter der viele Menschen leiden, ins gesellschaftliche Bewusstsein. Aber was verbirgt sich dahinter?
 Durch die Sparpläne der Trump-Regierung könnte das Geld für die Forschungsstation Mauna Loa bereits ab 2026 fehlen. Jahrzehntelange Datensammlungen könnten unterbrochen werden.
Durch die Sparpläne der Trump-Regierung könnte das Geld für die Forschungsstation Mauna Loa bereits ab 2026 fehlen. Jahrzehntelange Datensammlungen könnten unterbrochen werden.
 Apple verklagt den bekannten Youtuber Jon Prosser, weil er zusammen mit einem Komplizen Infos zu iOS 26 vom iPhone eines Entwicklers gestohlen haben soll. Die in der Klageschrift genannten Details sind teilweise filmreif. Der Beschuldigte wehrt sich.
Apple verklagt den bekannten Youtuber Jon Prosser, weil er zusammen mit einem Komplizen Infos zu iOS 26 vom iPhone eines Entwicklers gestohlen haben soll. Die in der Klageschrift genannten Details sind teilweise filmreif. Der Beschuldigte wehrt sich.
 Hunde nehmen TV-Bilder nicht nur wahr, sondern reagieren aktiv darauf. Besonders Tiergeräusche und Bewegungen fesseln sie vor dem Bildschirm, findet ein Forschungsteam heraus. Eine bestimmte Art von Programm scheint die Vierbeiner besonders zu begeistern.
Hunde nehmen TV-Bilder nicht nur wahr, sondern reagieren aktiv darauf. Besonders Tiergeräusche und Bewegungen fesseln sie vor dem Bildschirm, findet ein Forschungsteam heraus. Eine bestimmte Art von Programm scheint die Vierbeiner besonders zu begeistern.
 Dass Antibiotika die Darmflora negativ beeinflussen, ist bekannt. Dass jedoch auch andere, weitverbreitete Medikamente das Mikrobiom aus dem Gleichgewicht bringen, findet ein Forschungsteam jetzt heraus - und rät zu neuen Wegen in der Arzneimittelforschung.
Dass Antibiotika die Darmflora negativ beeinflussen, ist bekannt. Dass jedoch auch andere, weitverbreitete Medikamente das Mikrobiom aus dem Gleichgewicht bringen, findet ein Forschungsteam jetzt heraus - und rät zu neuen Wegen in der Arzneimittelforschung.
 AVM verteilt ab sofort FritzOS 8.20, das insgesamt mehr als 40 Neuerungen und Verbesserungen bringt. Zunächst bekommt ein älteres Router-Flaggschiff des Herstellers das Firmware-Update, weitere Fritzboxen folgen in den kommenden Wochen und Monaten.
AVM verteilt ab sofort FritzOS 8.20, das insgesamt mehr als 40 Neuerungen und Verbesserungen bringt. Zunächst bekommt ein älteres Router-Flaggschiff des Herstellers das Firmware-Update, weitere Fritzboxen folgen in den kommenden Wochen und Monaten.
 Zehn Jahre nach dem Pariser Klimaabkommen ist die Bilanz ernüchternd: 2024 wurde so viel Kohle verbrannt wie nie zuvor. Und der Trend für den mit Abstand klimaschädlichsten fossilen Brennstoff ist ungebrochen.
Zehn Jahre nach dem Pariser Klimaabkommen ist die Bilanz ernüchternd: 2024 wurde so viel Kohle verbrannt wie nie zuvor. Und der Trend für den mit Abstand klimaschädlichsten fossilen Brennstoff ist ungebrochen.
 Hafer-, Soja- oder Mandeldrinks gelten als klimafreundliche Alternativen zu Kuhmilch. Ein Blick auf die Ökobilanzen zeigt: Nicht jedes Getränk ist so nachhaltig wie sein Image. Der Vergleich.
Hafer-, Soja- oder Mandeldrinks gelten als klimafreundliche Alternativen zu Kuhmilch. Ein Blick auf die Ökobilanzen zeigt: Nicht jedes Getränk ist so nachhaltig wie sein Image. Der Vergleich.
 Jede Frau weiß, dass es in den Phasen ihres Zyklus verschiedene Bedürfnisse gibt. Die speziellen Qualitäten machen sich auch Leistungssportlerinnen zunutze. Was das sogenannte Cycle Syncing tatsächlich bringen kann, erklärt eine Expertin.
Jede Frau weiß, dass es in den Phasen ihres Zyklus verschiedene Bedürfnisse gibt. Die speziellen Qualitäten machen sich auch Leistungssportlerinnen zunutze. Was das sogenannte Cycle Syncing tatsächlich bringen kann, erklärt eine Expertin.
 Touristen in Asien wollen oftmals auch Elefanten sehen. Die Tiere, die sie fälschlicherweise als gutmütige Dickhäuter wahrnehmen, werden oftmals mit Futter angelockt. Doch das kann lebensgefährlich werden, sowohl für die Menschen als auch für die Tiere.
Touristen in Asien wollen oftmals auch Elefanten sehen. Die Tiere, die sie fälschlicherweise als gutmütige Dickhäuter wahrnehmen, werden oftmals mit Futter angelockt. Doch das kann lebensgefährlich werden, sowohl für die Menschen als auch für die Tiere.
 Viele Eltern, die sich mehrere Kinder wünschen, sind froh, wenn sie nicht nur Mädchen oder nicht nur Jungen bekommen. Doch das Geschlecht der Kinder hängt offenbar viel mehr mit den Eigenschaften der Mütter zusammen als bisher angenommen.
Viele Eltern, die sich mehrere Kinder wünschen, sind froh, wenn sie nicht nur Mädchen oder nicht nur Jungen bekommen. Doch das Geschlecht der Kinder hängt offenbar viel mehr mit den Eigenschaften der Mütter zusammen als bisher angenommen.
 Emily Pellegrini zeigt sich ihren 350.000 Followern häufig im Bikini. Dem Mann, der sie mittels KI erschaffen hat, bringt sie viel Geld ein. SPIEGEL-Redakteurin Angela Gruber berichtet über den Aufstieg eines Geschäftsmodells.
Emily Pellegrini zeigt sich ihren 350.000 Followern häufig im Bikini. Dem Mann, der sie mittels KI erschaffen hat, bringt sie viel Geld ein. SPIEGEL-Redakteurin Angela Gruber berichtet über den Aufstieg eines Geschäftsmodells.
 Der X-Account von Elmo ist am Sonntag von Unbekannten gekapert worden. Im Namen der populären »Sesamstraße«-Puppe wurde Judenhass verbreitet und verbal gegen US-Präsident Trump geschossen.
Der X-Account von Elmo ist am Sonntag von Unbekannten gekapert worden. Im Namen der populären »Sesamstraße«-Puppe wurde Judenhass verbreitet und verbal gegen US-Präsident Trump geschossen.
 Viele Länder haben schon Maßnahmen gegen die KI-Anwendung DeepSeek ergriffen, nun kommen auch aus Berlin klare Worte: Der Chatbot verstoße gegen europäisches Recht, so die Datenschutzbeauftragte.
Viele Länder haben schon Maßnahmen gegen die KI-Anwendung DeepSeek ergriffen, nun kommen auch aus Berlin klare Worte: Der Chatbot verstoße gegen europäisches Recht, so die Datenschutzbeauftragte.
 Vor der Küste Grönlands treibt ein Koloss von Eisberg bedrohlich nahe am Hafen einer kleinen Siedlung. Behörden warnen vor einer möglichen Flutwelle und mahnen zur Vorsicht. Es ist nicht das erste Mal, dass die Siedlung sich einem eisigen Riesen gegenübersieht.
Vor der Küste Grönlands treibt ein Koloss von Eisberg bedrohlich nahe am Hafen einer kleinen Siedlung. Behörden warnen vor einer möglichen Flutwelle und mahnen zur Vorsicht. Es ist nicht das erste Mal, dass die Siedlung sich einem eisigen Riesen gegenübersieht.
 Der Chatbot von Elon Musk sorgte für Skandale. Jetzt hat der Unternehmer eine kinderfreundliche Variante des KI-Tools angekündigt – doch was Musk darunter versteht, ist offen.
Der Chatbot von Elon Musk sorgte für Skandale. Jetzt hat der Unternehmer eine kinderfreundliche Variante des KI-Tools angekündigt – doch was Musk darunter versteht, ist offen.
 Vor 8000 Jahren errichteten Menschen in Albanien Häuser auf Stelzen, fischten und betrieben Ackerbau. Jetzt haben Forscher die Überreste der Siedlungen gefunden – es sind die ältesten Europas.
Vor 8000 Jahren errichteten Menschen in Albanien Häuser auf Stelzen, fischten und betrieben Ackerbau. Jetzt haben Forscher die Überreste der Siedlungen gefunden – es sind die ältesten Europas.
 Mit den sommerlichen Temperaturen kommen auch die Bakterien: Vibrionen können beim Baden in den Körper eindringen und zu schweren Infektionen führen. Wer betroffen ist - und wie man sich schützt.
Mit den sommerlichen Temperaturen kommen auch die Bakterien: Vibrionen können beim Baden in den Körper eindringen und zu schweren Infektionen führen. Wer betroffen ist - und wie man sich schützt.
 In der italienischen Region Latium haben sich sieben Menschen mit dem West-Nil-Fieber angesteckt. Eine Frau ist im Krankenhaus verstorben. Die Behörden richteten eine Taskforce ein.
In der italienischen Region Latium haben sich sieben Menschen mit dem West-Nil-Fieber angesteckt. Eine Frau ist im Krankenhaus verstorben. Die Behörden richteten eine Taskforce ein.
 Die Ursache der Flugzeugkatastrophe im indischen Ahmedabad ist geklärt, die Treibstoffzufuhr wurde unterbrochen. Wie es dazu kam, ist aber weiterhin unklar. Nun wird diskutiert, ob im Cockpit gefilmt werden muss, und wenn ja, wie.
Die Ursache der Flugzeugkatastrophe im indischen Ahmedabad ist geklärt, die Treibstoffzufuhr wurde unterbrochen. Wie es dazu kam, ist aber weiterhin unklar. Nun wird diskutiert, ob im Cockpit gefilmt werden muss, und wenn ja, wie.
 Parkinson, auch Schüttellähmung genannt, ist eine nervlich bedingte Bewegungsstörung, die vor allem Ältere trifft und ähnlich häufig auftritt wie Alzheimer. Dabei sterben bestimmte Nervenzellen im Gehirn ab. Eine Studie zeigt nun: Trainierte Hunde können die Krankheit auch erschnüffeln.
Parkinson, auch Schüttellähmung genannt, ist eine nervlich bedingte Bewegungsstörung, die vor allem Ältere trifft und ähnlich häufig auftritt wie Alzheimer. Dabei sterben bestimmte Nervenzellen im Gehirn ab. Eine Studie zeigt nun: Trainierte Hunde können die Krankheit auch erschnüffeln.
 Warum ist Flug 2216 von Jeju Air abgestürzt? Die offizielle Untersuchung hat den Fall wohl geklärt - doch die Hinterbliebenen der 179 Toten wollen die Wahrheit nicht hinnehmen.
Warum ist Flug 2216 von Jeju Air abgestürzt? Die offizielle Untersuchung hat den Fall wohl geklärt - doch die Hinterbliebenen der 179 Toten wollen die Wahrheit nicht hinnehmen.
 Samsung vergrößert beide Bildschirme des Galaxy Z Fold. Und weil sie nahezu keine Schwächen, aber erstaunliche Stärken zeigt, ist die siebte Generation ein fast perfektes Klapp-Smartphone.
Samsung vergrößert beide Bildschirme des Galaxy Z Fold. Und weil sie nahezu keine Schwächen, aber erstaunliche Stärken zeigt, ist die siebte Generation ein fast perfektes Klapp-Smartphone.
 Bei Sanierungsarbeiten in einer Kirche haben Archäologen offenbar das Grab von Julie von Voß entdeckt. Die letzte Ruhestätte der zweiten Ehefrau des preußischen Königs Friedrich Wilhelm II. galt bislang als unbekannt.
Bei Sanierungsarbeiten in einer Kirche haben Archäologen offenbar das Grab von Julie von Voß entdeckt. Die letzte Ruhestätte der zweiten Ehefrau des preußischen Königs Friedrich Wilhelm II. galt bislang als unbekannt.
 Vor 100 Jahren wagte der britische Ingenieur Archibald Low visionäre Prognosen über die Zukunft. Mit erstaunlicher Präzision trifft er etwa bei Mobiltelefonen, Streaming und modernen Kriegen ins Schwarze. Doch einige Ideen waren viel zu kühn – oder skurril.
Vor 100 Jahren wagte der britische Ingenieur Archibald Low visionäre Prognosen über die Zukunft. Mit erstaunlicher Präzision trifft er etwa bei Mobiltelefonen, Streaming und modernen Kriegen ins Schwarze. Doch einige Ideen waren viel zu kühn – oder skurril.
 Hygiene ist wichtig, besonders in einem Krankenhaus. Eine Studie in Dänemark stellt jedoch fest, dass viele Menschen sich nach dem Toilettengang nicht mal die Hände waschen. Einen Lerneffekt hat es während der Corona-Pandemie demnach wohl nicht gegeben.
Hygiene ist wichtig, besonders in einem Krankenhaus. Eine Studie in Dänemark stellt jedoch fest, dass viele Menschen sich nach dem Toilettengang nicht mal die Hände waschen. Einen Lerneffekt hat es während der Corona-Pandemie demnach wohl nicht gegeben.
 Samsung vergrößert beide Bildschirme des Galaxy Z Flip Und weil sie nahezu keine Schwächen, aber erstaunliche Stärken zeigt, ist die siebte Generation ein fast perfektes Klapp-Smartphone.
Samsung vergrößert beide Bildschirme des Galaxy Z Flip Und weil sie nahezu keine Schwächen, aber erstaunliche Stärken zeigt, ist die siebte Generation ein fast perfektes Klapp-Smartphone.
 Die südkoreanische Raumfahrtbehörde hat ehrgeizige Ziele: Spätestens in 20 Jahren soll eine Basis für »wirtschaftliche Aktivitäten« auf der Mondoberfläche stehen.
Die südkoreanische Raumfahrtbehörde hat ehrgeizige Ziele: Spätestens in 20 Jahren soll eine Basis für »wirtschaftliche Aktivitäten« auf der Mondoberfläche stehen.
 Zuckerersatz soll das süße Leben leichter machen. Doch die Stoffe bringen auch ungewollte Effekte mit sich. Einen bisher als unbedenklich geltenden Süßstoff nehmen Forschende im Labor genauer unter die Lupe - und entdecken bedenkliche Kettenreaktionen.
Zuckerersatz soll das süße Leben leichter machen. Doch die Stoffe bringen auch ungewollte Effekte mit sich. Einen bisher als unbedenklich geltenden Süßstoff nehmen Forschende im Labor genauer unter die Lupe - und entdecken bedenkliche Kettenreaktionen.
 Die eigene Datenschutzbehörde wollte der Bundesregierung untersagen, mit sogenannten Fanpages auf Facebook präsent zu sein. Das Verwaltungsgericht Köln erteilt nun eine Freigabe.
Die eigene Datenschutzbehörde wollte der Bundesregierung untersagen, mit sogenannten Fanpages auf Facebook präsent zu sein. Das Verwaltungsgericht Köln erteilt nun eine Freigabe.
 Der JBL Tour One M3 kostet in der einfachen Ausführung 300 Euro, womit klar ist, dass er in der Oberklasse mitspielen soll. Entsprechende Möglichkeiten hat er, ob der Bluetooth-Kopfhörer damit auch spitze ist, zeigt der Praxistest.
Der JBL Tour One M3 kostet in der einfachen Ausführung 300 Euro, womit klar ist, dass er in der Oberklasse mitspielen soll. Entsprechende Möglichkeiten hat er, ob der Bluetooth-Kopfhörer damit auch spitze ist, zeigt der Praxistest.
 Auf Hawaii messen Wissenschaftler seit 1958 den CO₂-Gehalt der Atmosphäre. Der US-Präsident will die Station dichtmachen, Forschungsleiter Ralph Keeling versucht, das noch zu verhindern.
Auf Hawaii messen Wissenschaftler seit 1958 den CO₂-Gehalt der Atmosphäre. Der US-Präsident will die Station dichtmachen, Forschungsleiter Ralph Keeling versucht, das noch zu verhindern.
 Die Universität Würzburg sammelt Pilotenberichte über unerklärliche Objekte in der Luft. Manche davon, glaubt Raumfahrttechniker Hakan Kayal, könnten »intelligenten nichtmenschlichen Ursprungs« sein.
Die Universität Würzburg sammelt Pilotenberichte über unerklärliche Objekte in der Luft. Manche davon, glaubt Raumfahrttechniker Hakan Kayal, könnten »intelligenten nichtmenschlichen Ursprungs« sein.
 Die Erdbevölkerung beansprucht zu viel Ackerland, Fischgründe und Wälder. Die rechnerisch in diesem Jahr zur Verfügung stehenden Ressourcen sind schon am Ende. Umweltorganisationen haben Lösungsvorschläge.
Die Erdbevölkerung beansprucht zu viel Ackerland, Fischgründe und Wälder. Die rechnerisch in diesem Jahr zur Verfügung stehenden Ressourcen sind schon am Ende. Umweltorganisationen haben Lösungsvorschläge.
 Die Junocam ist bekannt für ihre spektakulären Bilder. Doch als sie beschädigt wird, müssen Nasa-Fachleute improvisieren – ein ungewöhnliches Vorgehen für die US-Weltraumbehörde.
Die Junocam ist bekannt für ihre spektakulären Bilder. Doch als sie beschädigt wird, müssen Nasa-Fachleute improvisieren – ein ungewöhnliches Vorgehen für die US-Weltraumbehörde.
 Der Mirasaura grauvogeli zählt zu den bizarrsten Wesen der Urzeit. Ein Fossil liefert neue Erkenntnisse zur Evolution von Haaren und Federn.
Der Mirasaura grauvogeli zählt zu den bizarrsten Wesen der Urzeit. Ein Fossil liefert neue Erkenntnisse zur Evolution von Haaren und Federn.
 Der Internationale Gerichtshof in Den Haag hat ein mit Spannung erwartetes Gutachten veröffentlicht. Darin verpflichtet er Länder zu Klimamaßnahmen.
Der Internationale Gerichtshof in Den Haag hat ein mit Spannung erwartetes Gutachten veröffentlicht. Darin verpflichtet er Länder zu Klimamaßnahmen.
 Ein Berliner Gericht spricht Sebastian Hotz im Fall seiner umstrittenen Donald-Trump-Tweets frei. Der Satiriker genießt das Urteil und nutzt es zur Eigen-PR.
Ein Berliner Gericht spricht Sebastian Hotz im Fall seiner umstrittenen Donald-Trump-Tweets frei. Der Satiriker genießt das Urteil und nutzt es zur Eigen-PR.
 Ein internationales Forscherteam identifiziert ein 247 Millionen Jahre altes Reptil mit einzigartigen Hautauswüchsen. Mirasaura grauvogeli liefert den frühesten Beweis für komplexe Strukturen vor den Dinosauriern. Die Entdeckung wirft auch ein neues Licht auf die Evolution.
Ein internationales Forscherteam identifiziert ein 247 Millionen Jahre altes Reptil mit einzigartigen Hautauswüchsen. Mirasaura grauvogeli liefert den frühesten Beweis für komplexe Strukturen vor den Dinosauriern. Die Entdeckung wirft auch ein neues Licht auf die Evolution.
 Mit seinem ersten Luftreiniger AirPursue PM10 gelingt Dreame ein beeindruckendes Debüt. Das Gerät erweist sich im Praxistest als leistungsstark, aber leise und überzeugt mit durchdachten Funktionen und einem effektiven Verfolgungsmodus. Leider muss man dafür einen hohen Preis bezahlen.
Mit seinem ersten Luftreiniger AirPursue PM10 gelingt Dreame ein beeindruckendes Debüt. Das Gerät erweist sich im Praxistest als leistungsstark, aber leise und überzeugt mit durchdachten Funktionen und einem effektiven Verfolgungsmodus. Leider muss man dafür einen hohen Preis bezahlen.
 Meta möchte seine jüngsten Nutzerinnen und Nutzer besser schützen. Der Konzern löscht Tausende Accounts, die Jugendliche sexualisiert haben. Mit neuen Funktionen sollen sich die Teenager auch selbst wehren können.
Meta möchte seine jüngsten Nutzerinnen und Nutzer besser schützen. Der Konzern löscht Tausende Accounts, die Jugendliche sexualisiert haben. Mit neuen Funktionen sollen sich die Teenager auch selbst wehren können.
 Die Menschheit verbraucht 2025 schon jetzt mehr Ressourcen als die Erde regenerieren kann. Besonders Industriestaaten wie Deutschland leben weit über ihre Verhältnisse. Der BUND warnt vor katastrophalen Folgen und fordert dringend Maßnahmen.
Die Menschheit verbraucht 2025 schon jetzt mehr Ressourcen als die Erde regenerieren kann. Besonders Industriestaaten wie Deutschland leben weit über ihre Verhältnisse. Der BUND warnt vor katastrophalen Folgen und fordert dringend Maßnahmen.
 Mit einer neuartigen Therapie haben Forschende den Tod von Mäusen erheblich hinausgezögert. Die Nager waren im hohen Alter obendrein gesünder. Funktioniert das auch bei Menschen?
Mit einer neuartigen Therapie haben Forschende den Tod von Mäusen erheblich hinausgezögert. Die Nager waren im hohen Alter obendrein gesünder. Funktioniert das auch bei Menschen?
 Auf die Balearen eingeschleppte Hufeisennattern breiten sich rasant aus. Experte Mark-Oliver Rödel erklärt, warum es fast unmöglich sein wird, die bis zu 1,85 Meter langen Tiere wieder loszuwerden.
Auf die Balearen eingeschleppte Hufeisennattern breiten sich rasant aus. Experte Mark-Oliver Rödel erklärt, warum es fast unmöglich sein wird, die bis zu 1,85 Meter langen Tiere wieder loszuwerden.
 Weniger regulieren, mehr ausprobieren: US-Präsident Donald Trump will die Vorgaben für künstliche Intelligenz lockern, um die KI-Branche anzukurbeln. Allerdings stellt er dafür auch Bedingungen.
Weniger regulieren, mehr ausprobieren: US-Präsident Donald Trump will die Vorgaben für künstliche Intelligenz lockern, um die KI-Branche anzukurbeln. Allerdings stellt er dafür auch Bedingungen.
 Ob man sich am Anfang eines Tages vorstellt oder eher zur Mittagszeit hat maßgeblich Einfluss, wie man von Arbeitgebern eingeschätzt wird. Auch die Prüfungsergebnisse variieren nach Tageszeit, wie eine aktuelle Untersuchung zeigt.
Ob man sich am Anfang eines Tages vorstellt oder eher zur Mittagszeit hat maßgeblich Einfluss, wie man von Arbeitgebern eingeschätzt wird. Auch die Prüfungsergebnisse variieren nach Tageszeit, wie eine aktuelle Untersuchung zeigt.
 Für viele Menschen gehört der tägliche Blick auf den Schrittzähler dazu. 10.000 Schritte sollen laut diverser Apps sein. Wer das Ziel erreicht, fühlt sich zufrieden - und wer noch deutlich mehr schafft, auch. Doch laut einer Studie ist das gar nicht unbedingt nötig, um die Gesundheit zu fördern.
Für viele Menschen gehört der tägliche Blick auf den Schrittzähler dazu. 10.000 Schritte sollen laut diverser Apps sein. Wer das Ziel erreicht, fühlt sich zufrieden - und wer noch deutlich mehr schafft, auch. Doch laut einer Studie ist das gar nicht unbedingt nötig, um die Gesundheit zu fördern.
 In der britischen Öffentlichkeit ist Richard III. auch wegen William Shakespeare als Prinzenmörder bekannt. Hat er 1483 seine Neffen getötet, um den Thron besteigen zu können? Eine hartnäckige Amateur-Historikerin weckt mit neuen Dokumenten Zweifel.
In der britischen Öffentlichkeit ist Richard III. auch wegen William Shakespeare als Prinzenmörder bekannt. Hat er 1483 seine Neffen getötet, um den Thron besteigen zu können? Eine hartnäckige Amateur-Historikerin weckt mit neuen Dokumenten Zweifel.
 Bislang wussten Fachleute nicht, wieso die Helligkeit des Himmelskörpers mit dem Namen Beteigeuze so sehr schwankt. Ein Begleitstern könnte das Phänomen erklären. Seine Existenz muss jedoch erst noch bestätigt werden.
Bislang wussten Fachleute nicht, wieso die Helligkeit des Himmelskörpers mit dem Namen Beteigeuze so sehr schwankt. Ein Begleitstern könnte das Phänomen erklären. Seine Existenz muss jedoch erst noch bestätigt werden.
 »Die Lage ist ernst«: Irans Präsident denkt öffentlich über eine Verlegung der Hauptstadt Teheran nach – weil ihr das Wasser ausgeht. Schon jetzt sind Behörden und Produktionskapazitäten von der Knappheit betroffen.
»Die Lage ist ernst«: Irans Präsident denkt öffentlich über eine Verlegung der Hauptstadt Teheran nach – weil ihr das Wasser ausgeht. Schon jetzt sind Behörden und Produktionskapazitäten von der Knappheit betroffen.
 Eine neue US-Studie zeigt, dass ein spezielles Gen den Erfolg von Abnehmspritzen maßgeblich beeinflusst. Bei etwa einem Drittel der adipösen Patienten bleibt der gewünschte Effekt aus. Eine genetische Analyse könnte künftig teure Fehlbehandlungen vermeiden, sagen die Forschenden.
Eine neue US-Studie zeigt, dass ein spezielles Gen den Erfolg von Abnehmspritzen maßgeblich beeinflusst. Bei etwa einem Drittel der adipösen Patienten bleibt der gewünschte Effekt aus. Eine genetische Analyse könnte künftig teure Fehlbehandlungen vermeiden, sagen die Forschenden.
 Das Leben, wie es auf der Erde existiert, basiert auf komplexen organischen Molekülen. In einem weit entfernten Sternensystem entdecken Forscher nun Substanzen, die als Vorstufe dieser Verbindungen gelten. Die Forscher vermuten einen Prozess, der im Universum weit verbreitet ist.
Das Leben, wie es auf der Erde existiert, basiert auf komplexen organischen Molekülen. In einem weit entfernten Sternensystem entdecken Forscher nun Substanzen, die als Vorstufe dieser Verbindungen gelten. Die Forscher vermuten einen Prozess, der im Universum weit verbreitet ist.
 Apple stellt die erste öffentliche Beta von iOS 26 bereit. Jeder, der ein kompatibles iPhone hat, kann sie installieren. Die Software gibt erste Eindrücke in das Liquid-Glass-Design, bringt aber auch neue Funktionen auf die Geräte. ntv.de zeigt, wie man die Version installiert und was sie aktuell zu bieten hat.
Apple stellt die erste öffentliche Beta von iOS 26 bereit. Jeder, der ein kompatibles iPhone hat, kann sie installieren. Die Software gibt erste Eindrücke in das Liquid-Glass-Design, bringt aber auch neue Funktionen auf die Geräte. ntv.de zeigt, wie man die Version installiert und was sie aktuell zu bieten hat.
 Durch ihren fragwürdigen Deal mit der Regierung setzen die Funktionäre der New Yorker Eliteuniversität andere Hochschulen unter Druck, ebenfalls klein beizugeben. Und Trump kann das Land weiter zur Autokratie umbauen.
Durch ihren fragwürdigen Deal mit der Regierung setzen die Funktionäre der New Yorker Eliteuniversität andere Hochschulen unter Druck, ebenfalls klein beizugeben. Und Trump kann das Land weiter zur Autokratie umbauen.
 Viele wollen den Partner oder die Partnerin fürs Leben über das Internet kennenlernen. So boomen auch die Zugriffe auf Dating-Apps. Wie sich Menschen bei der Online-Suche verhalten und wieso, erklärt ein Forscherduo.
Viele wollen den Partner oder die Partnerin fürs Leben über das Internet kennenlernen. So boomen auch die Zugriffe auf Dating-Apps. Wie sich Menschen bei der Online-Suche verhalten und wieso, erklärt ein Forscherduo.
 Kichererbsen in Deutschland, Lavendel in Frankreich: Der Wanderfalter Baumwoll-Kapseleule ist in Europa auf dem Vormarsch. Der Schädling kann mehr als 100 Wirtspflanzen befallen und 1000 Kilometer weit fliegen.
Kichererbsen in Deutschland, Lavendel in Frankreich: Der Wanderfalter Baumwoll-Kapseleule ist in Europa auf dem Vormarsch. Der Schädling kann mehr als 100 Wirtspflanzen befallen und 1000 Kilometer weit fliegen.
 Sie ist nur zehn Zentimeter lang und kaum dicker als Spaghetti: Die Barbados-Fadenschlange galt als für die Wissenschaft verloren, jetzt wurde sie auf der Karibik-Insel wiederentdeckt.
Sie ist nur zehn Zentimeter lang und kaum dicker als Spaghetti: Die Barbados-Fadenschlange galt als für die Wissenschaft verloren, jetzt wurde sie auf der Karibik-Insel wiederentdeckt.
 Personen, die bereits unter einem erhöhten Blutzuckerspiegel leiden, sollten abends lieber zu Pistazien statt zu kohlenhydrathaltigen Snacks greifen. Denn dies könnte langfristig die Entwicklung von Diabetes Typ 2 verzögern. Weitere Forschungen sollen die Effekte bestätigen.
Personen, die bereits unter einem erhöhten Blutzuckerspiegel leiden, sollten abends lieber zu Pistazien statt zu kohlenhydrathaltigen Snacks greifen. Denn dies könnte langfristig die Entwicklung von Diabetes Typ 2 verzögern. Weitere Forschungen sollen die Effekte bestätigen.
 Scapade bietet drei Reise-Gadgets mit integrierten Trackern an, die über Apples "Wo ist?"-Netzwerk geortet werden können: einen Kartenhalter, eine Passhülle und ein TSA-Kofferschloss. ntv.de hat ausprobiert, ob sie ihr Geld wert sind.
Scapade bietet drei Reise-Gadgets mit integrierten Trackern an, die über Apples "Wo ist?"-Netzwerk geortet werden können: einen Kartenhalter, eine Passhülle und ein TSA-Kofferschloss. ntv.de hat ausprobiert, ob sie ihr Geld wert sind.
 In den USA, Japan, China und Großbritannien ist es schon auf dem Markt, Europa könnte folgen: Mit Donanemab, auch bekannt unter dem Namen Kisunla, steht die Zulassung eines weiteren Medikaments für die Frühphase der Volkskrankheit Alzheimer kurz bevor.
In den USA, Japan, China und Großbritannien ist es schon auf dem Markt, Europa könnte folgen: Mit Donanemab, auch bekannt unter dem Namen Kisunla, steht die Zulassung eines weiteren Medikaments für die Frühphase der Volkskrankheit Alzheimer kurz bevor.
 Regen in Dresden, Regen in Berlin, Regen an der Nordsee, dafür Sonne in Nizza, Madrid und sogar in Helsinki: Der Sommer in Deutschland fällt offenbar aus. Dabei ist es auch hier zu warm und zu trocken, wie Daten zeigen.
Regen in Dresden, Regen in Berlin, Regen an der Nordsee, dafür Sonne in Nizza, Madrid und sogar in Helsinki: Der Sommer in Deutschland fällt offenbar aus. Dabei ist es auch hier zu warm und zu trocken, wie Daten zeigen.
 Abschweifen kann zum Tagträumen werden. Diese Art des Kopfkinos kann den Alltag bereichern und sogar der Kreativität Schwung verleihen - aber tatsächlich auch gefährlich werden.
Abschweifen kann zum Tagträumen werden. Diese Art des Kopfkinos kann den Alltag bereichern und sogar der Kreativität Schwung verleihen - aber tatsächlich auch gefährlich werden.
 Im ersten Halbjahr 2025 wurden weltweit fast sechs Millionen reine Elektroautos zugelassen. Weit vorn liegen die Verkäufe in China und Europa. Doch die europäischen Autohersteller geraten weiter unter Druck.
Im ersten Halbjahr 2025 wurden weltweit fast sechs Millionen reine Elektroautos zugelassen. Weit vorn liegen die Verkäufe in China und Europa. Doch die europäischen Autohersteller geraten weiter unter Druck.
 Berliner Forscher wollen eine Technik entwickeln, die den Bau von Straßen und Gebäuden auf dem Mond möglich macht, ohne dass man schweres Baumaterial hintransportieren muss. Einen Test machen sie in der Schwerelosigkeit an Bord einer alten Regierungsmaschine.
Berliner Forscher wollen eine Technik entwickeln, die den Bau von Straßen und Gebäuden auf dem Mond möglich macht, ohne dass man schweres Baumaterial hintransportieren muss. Einen Test machen sie in der Schwerelosigkeit an Bord einer alten Regierungsmaschine.
 Donald Trumps Kahlschlag in Behörden und Wissenschaftseinrichtungen trifft auch die US-Raumfahrtbehörde. Einer Sprecherin zufolge verliert die Nasa rund 3900 Mitarbeiterinnen und Mitarbeiter.
Donald Trumps Kahlschlag in Behörden und Wissenschaftseinrichtungen trifft auch die US-Raumfahrtbehörde. Einer Sprecherin zufolge verliert die Nasa rund 3900 Mitarbeiterinnen und Mitarbeiter.
 Mysophobie ist der Fachbegriff für die krankhafte Angst vor Keimen. Doch was versteckt sich dahinter - und wie kann man der krankhaften Entwicklung entgegentreten? Ein Fachmann gibt Antworten.
Mysophobie ist der Fachbegriff für die krankhafte Angst vor Keimen. Doch was versteckt sich dahinter - und wie kann man der krankhaften Entwicklung entgegentreten? Ein Fachmann gibt Antworten.
 Massen einer aggressiven invasiven Algenart aus Südostasien sind an den Stränden der Straße von Gibraltar und Südspaniens angeschwemmt worden. Umweltschützer bangen um die Biodiversität der Region.
Massen einer aggressiven invasiven Algenart aus Südostasien sind an den Stränden der Straße von Gibraltar und Südspaniens angeschwemmt worden. Umweltschützer bangen um die Biodiversität der Region.
 Warum hilft eine Immuntherapie bei Erdnussallergie manchen Kindern und anderen nicht? Berliner Wissenschaftler haben im Blut potenzielle Hinweise gefunden, die den Erfolg einer solchen Behandlung vorhersagen könnten.
Warum hilft eine Immuntherapie bei Erdnussallergie manchen Kindern und anderen nicht? Berliner Wissenschaftler haben im Blut potenzielle Hinweise gefunden, die den Erfolg einer solchen Behandlung vorhersagen könnten.
 Zwei Tanker havarieren im Winter vor der russischen Schwarzmeerküste, Öl läuft aus, Tiere verenden. Inzwischen sind die oberen Sandschichten gereinigt. Doch flüssige Fracht ist wohl gefährlicher, als die Behörden zugeben wollen.
Zwei Tanker havarieren im Winter vor der russischen Schwarzmeerküste, Öl läuft aus, Tiere verenden. Inzwischen sind die oberen Sandschichten gereinigt. Doch flüssige Fracht ist wohl gefährlicher, als die Behörden zugeben wollen.
 Im brasilianischen Bundesstaat Amazonas leben Menschen, die Kontakt mit der Außenwelt ablehnen. Missionare wollen sie offenbar dennoch zum Christentum bekehren – mit Tonaufnahmen von Bibelversen.
Im brasilianischen Bundesstaat Amazonas leben Menschen, die Kontakt mit der Außenwelt ablehnen. Missionare wollen sie offenbar dennoch zum Christentum bekehren – mit Tonaufnahmen von Bibelversen.
 Die Bundeswehr muss energieautark werden, sagt der Militärforscher Stefan Bayer. Die Abhängigkeit von Importen mache sie erpressbar. Solaranlagen in Kasernen und elektrisch betriebene Drohnen würden helfen, glaubt er.
Die Bundeswehr muss energieautark werden, sagt der Militärforscher Stefan Bayer. Die Abhängigkeit von Importen mache sie erpressbar. Solaranlagen in Kasernen und elektrisch betriebene Drohnen würden helfen, glaubt er.
 Er überdauerte 4000 Jahre: Archäologen haben auf einer Beigabe für ein Grab die Umrisse einer Hand gefunden. Wahrscheinlich hat ein altägyptischer Handwerker die seltene Spur unbeabsichtigt hinterlassen.
Er überdauerte 4000 Jahre: Archäologen haben auf einer Beigabe für ein Grab die Umrisse einer Hand gefunden. Wahrscheinlich hat ein altägyptischer Handwerker die seltene Spur unbeabsichtigt hinterlassen.
 Die russische Airline Aeroflot hat mehr als 60 Flüge gestrichen. Die Reaktionen von der Ukraine nahestehenden Hackergruppen und des Kreml legen nahe: Die Sache könnte mit einem Cyberangriff zusammenhängen.
Die russische Airline Aeroflot hat mehr als 60 Flüge gestrichen. Die Reaktionen von der Ukraine nahestehenden Hackergruppen und des Kreml legen nahe: Die Sache könnte mit einem Cyberangriff zusammenhängen.
 Der Anblick einer hustenden, schniefenden Person reicht, selbst wenn diese nicht echt ist. Eine Studie zeigt: Wohl schon beim kleinsten Hinweis auf eine drohende Infektion springt die körpereigene Abwehr an.
Der Anblick einer hustenden, schniefenden Person reicht, selbst wenn diese nicht echt ist. Eine Studie zeigt: Wohl schon beim kleinsten Hinweis auf eine drohende Infektion springt die körpereigene Abwehr an.
 Unser Immunsystem soll uns vor Gefahren beschützen: Es reagiert auf Infektionen und bekämpft sie dann - selbst wenn die Gefahr gar nicht real ist. Schon der Anblick krank aussehender Gesichter von Avataren, löst eine Immunreaktion aus, findet ein Forschungsteam heraus.
Unser Immunsystem soll uns vor Gefahren beschützen: Es reagiert auf Infektionen und bekämpft sie dann - selbst wenn die Gefahr gar nicht real ist. Schon der Anblick krank aussehender Gesichter von Avataren, löst eine Immunreaktion aus, findet ein Forschungsteam heraus.
 Die zweite Generation der Bose QuietComfort Ultra Earbuds überzeugt durch eine ausgezeichnete aktive Geräuschunterdrückung, einen tollen Klang und einen hohen Tragekomfort. Außerdem kann man die Bluetooth-Ohrhörer im Gegensatz zu ihren Vorgängern induktiv laden.
Die zweite Generation der Bose QuietComfort Ultra Earbuds überzeugt durch eine ausgezeichnete aktive Geräuschunterdrückung, einen tollen Klang und einen hohen Tragekomfort. Außerdem kann man die Bluetooth-Ohrhörer im Gegensatz zu ihren Vorgängern induktiv laden.
 In Deutschland kommen immer mehr Menschen wegen starken Übergewichts unters Messer. Seit 2010 ist die Zahl der Eingriffe rasant gestiegen. Die Schlauchmagen-OP ist dabei die mit Abstand häufigste Methode.
In Deutschland kommen immer mehr Menschen wegen starken Übergewichts unters Messer. Seit 2010 ist die Zahl der Eingriffe rasant gestiegen. Die Schlauchmagen-OP ist dabei die mit Abstand häufigste Methode.
 Unser Immunsystem soll uns vor Gefahren beschützen: Es reagiert auf Infektionen und bekämpft sie dann - selbst wenn die Gefahr gar nicht real ist. Schon der Anblick krank aussehender Gesichter von Avataren löst eine Immunreaktion aus, findet ein Forschungsteam heraus.
Unser Immunsystem soll uns vor Gefahren beschützen: Es reagiert auf Infektionen und bekämpft sie dann - selbst wenn die Gefahr gar nicht real ist. Schon der Anblick krank aussehender Gesichter von Avataren löst eine Immunreaktion aus, findet ein Forschungsteam heraus.
 In der chinesischen Großstadt Foshan werden mehr als 2600 Fälle des Chikungunya-Virus festgestellt. Die WHO warnt vor einer weltweiten Verbreitung des Virus. Überträger, wie etwa die Asiatische Tigermücke, gibt es weltweit - auch in Deutschland ist sie mittlerweile zu Hause.
In der chinesischen Großstadt Foshan werden mehr als 2600 Fälle des Chikungunya-Virus festgestellt. Die WHO warnt vor einer weltweiten Verbreitung des Virus. Überträger, wie etwa die Asiatische Tigermücke, gibt es weltweit - auch in Deutschland ist sie mittlerweile zu Hause.
 Leberkrebs gehört zu den Krebsarten, die am schwierigsten zu behandeln sind. Zudem sind die Überlebensraten recht gering. Umso dramatischer: Einer Analyse zufolge dürfte die Zahl der Fälle von Leberzellkrebs weltweit drastisch steigen. Dabei ließe sich die Krankheit meist sogar verhindern.
Leberkrebs gehört zu den Krebsarten, die am schwierigsten zu behandeln sind. Zudem sind die Überlebensraten recht gering. Umso dramatischer: Einer Analyse zufolge dürfte die Zahl der Fälle von Leberzellkrebs weltweit drastisch steigen. Dabei ließe sich die Krankheit meist sogar verhindern.
 Die grün-schwarze Koalition in Stuttgart hat sich geeinigt: Trotz bisher fehlender Rechtsgrundlage soll die umstrittene Software von Palantir zum Einsatz kommen. Es geht um einen Millionenbetrag.
Die grün-schwarze Koalition in Stuttgart hat sich geeinigt: Trotz bisher fehlender Rechtsgrundlage soll die umstrittene Software von Palantir zum Einsatz kommen. Es geht um einen Millionenbetrag.
 Der Schütze von Manhattan, der erst vier Menschen und dann sich selbst tötete, hat in seinem Abschiedsbrief von einer Erkrankung seines Gehirns geschrieben, die als CTE bekannt ist. Sport und Kopfverletzungen spielen dabei eine Rolle.
Der Schütze von Manhattan, der erst vier Menschen und dann sich selbst tötete, hat in seinem Abschiedsbrief von einer Erkrankung seines Gehirns geschrieben, die als CTE bekannt ist. Sport und Kopfverletzungen spielen dabei eine Rolle.
 Wie eine riesige Säule, die bis in den Himmel ragt: Am Bodensee hat sich am Dienstag ein Tornado gebildet. Diese entstehen nur bei speziellen Wetterbedingungen.
Wie eine riesige Säule, die bis in den Himmel ragt: Am Bodensee hat sich am Dienstag ein Tornado gebildet. Diese entstehen nur bei speziellen Wetterbedingungen.
 Für viele Gamer sind Mario und Prinzessin Peach eines der romantischsten Liebespaare überhaupt. Jetzt aber lässt der Konzern Nintendo klarstellen: Die beiden sind nur gute Freunde. Wie bitte?!
Für viele Gamer sind Mario und Prinzessin Peach eines der romantischsten Liebespaare überhaupt. Jetzt aber lässt der Konzern Nintendo klarstellen: Die beiden sind nur gute Freunde. Wie bitte?!
 Die Körpergerüche von Frauen verändern sich innerhalb der verschiedenen Zyklusphasen. Ein Forschungsteam in Japan kann nun erklären, wie sich der Geruch der fruchtbaren Tage auf Männer auswirkt.
Die Körpergerüche von Frauen verändern sich innerhalb der verschiedenen Zyklusphasen. Ein Forschungsteam in Japan kann nun erklären, wie sich der Geruch der fruchtbaren Tage auf Männer auswirkt.
 Viele Deutsche halten zu Hause Schlangen, Schildkröten oder auch mal einen Kurzkopfgleitbeutler. Doch ein Blick in Auffangstationen zeigt, wie problematisch die Haltung sein kann. SPIEGEL-Redakteurin Julia Koch berichtet.
Viele Deutsche halten zu Hause Schlangen, Schildkröten oder auch mal einen Kurzkopfgleitbeutler. Doch ein Blick in Auffangstationen zeigt, wie problematisch die Haltung sein kann. SPIEGEL-Redakteurin Julia Koch berichtet.
 Die weltweit größten Korallen sind Hunderte Jahre alt. Forschende spüren sie auf, um herauszufinden, was sie so widerstandsfähig macht. Ein Meeresbiologe erklärt, wie Taucher und Schnorchler bei dem Projekt mitmachen können.
Die weltweit größten Korallen sind Hunderte Jahre alt. Forschende spüren sie auf, um herauszufinden, was sie so widerstandsfähig macht. Ein Meeresbiologe erklärt, wie Taucher und Schnorchler bei dem Projekt mitmachen können.
 Vor der russischen Halbinsel Kamtschatka hat die Erde gebebt, die Stärke wurde mit 8,7 gemessen. Es gibt Tsunamiwarnungen für Teile Russlands, Japans und Hawaii.
Vor der russischen Halbinsel Kamtschatka hat die Erde gebebt, die Stärke wurde mit 8,7 gemessen. Es gibt Tsunamiwarnungen für Teile Russlands, Japans und Hawaii.
 Vor der russischen Halbinsel Kamtschatka hat die Erde gebebt, die Stärke wurde mit 8,8 gemessen. Es gibt Tsunamiwarnungen für Teile Russlands, Japans und Hawaii. Auch die US-Westküste ist betroffen.
Vor der russischen Halbinsel Kamtschatka hat die Erde gebebt, die Stärke wurde mit 8,8 gemessen. Es gibt Tsunamiwarnungen für Teile Russlands, Japans und Hawaii. Auch die US-Westküste ist betroffen.
 Kinder und Jugendliche unter 16 Jahren sollen künftig in Australien kein YouTube-Konto mehr haben dürfen. Mit dem Social-Media-Verbot will die Regierung Kindern eine »Atempause« und Eltern »ein Gefühl der Sicherheit« geben.
Kinder und Jugendliche unter 16 Jahren sollen künftig in Australien kein YouTube-Konto mehr haben dürfen. Mit dem Social-Media-Verbot will die Regierung Kindern eine »Atempause« und Eltern »ein Gefühl der Sicherheit« geben.
 Es gilt als die größte Erschütterung seit der Katastrophe von Fukushima: Vor der Halbinsel Kamtschatka hat der Meeresgrund gebebt. Welche Regionen betroffen sind und womit Experten nun rechnen.
Es gilt als die größte Erschütterung seit der Katastrophe von Fukushima: Vor der Halbinsel Kamtschatka hat der Meeresgrund gebebt. Welche Regionen betroffen sind und womit Experten nun rechnen.
 Die Geburtenrate in Deutschland sinkt und sinkt, dabei wünschen sich Erwachsene sehr wohl Kinder. Wie passt das zusammen? Laut einer Untersuchung schieben viele den Nachwuchs auf.
Die Geburtenrate in Deutschland sinkt und sinkt, dabei wünschen sich Erwachsene sehr wohl Kinder. Wie passt das zusammen? Laut einer Untersuchung schieben viele den Nachwuchs auf.
 In Autohäusern fehlt es oft an Verkaufspersonal, das sich um die Kundschaft kümmert. In diese Lücke kann nun "Mornine" springen - ein Roboter, der Kunden die Autotür öffnet. Besonders bemerkenswert: Diese Fähigkeit wurde nicht direkt programmiert, sondern erlernt.
In Autohäusern fehlt es oft an Verkaufspersonal, das sich um die Kundschaft kümmert. In diese Lücke kann nun "Mornine" springen - ein Roboter, der Kunden die Autotür öffnet. Besonders bemerkenswert: Diese Fähigkeit wurde nicht direkt programmiert, sondern erlernt.
 Auf der Einschätzung, dass Treibhausgase gesundheitsgefährdend sind, basieren alle nationalen Klimaschutzgesetze in den USA. Die Umweltschutzbehörde will das nun zurücknehmen. Welche Folgen das hätte und was jetzt passiert.
Auf der Einschätzung, dass Treibhausgase gesundheitsgefährdend sind, basieren alle nationalen Klimaschutzgesetze in den USA. Die Umweltschutzbehörde will das nun zurücknehmen. Welche Folgen das hätte und was jetzt passiert.
 Naturkatastrophen als Followermagnet: Manche Influencer nutzen die Sensationsgier bei Ereignissen wie den Tsunamiwarnungen für vermeintlich spektakuläre Livestreams. Dahinter stecken auch finanzielle Interessen.
Naturkatastrophen als Followermagnet: Manche Influencer nutzen die Sensationsgier bei Ereignissen wie den Tsunamiwarnungen für vermeintlich spektakuläre Livestreams. Dahinter stecken auch finanzielle Interessen.
 Das Kraftwerk in Fukushima wurde evakuiert, in Russland mussten Ärzte eine Patientin festhalten, damit sie nicht vom OP-Tisch fällt: Beim Erdbeben vor Kamtschatka sind Teile der Welt an einer Katastrophe vorbeigeschrammt.
Das Kraftwerk in Fukushima wurde evakuiert, in Russland mussten Ärzte eine Patientin festhalten, damit sie nicht vom OP-Tisch fällt: Beim Erdbeben vor Kamtschatka sind Teile der Welt an einer Katastrophe vorbeigeschrammt.
 Im Jahr 2014 ereignet sich eine Flutkatastrophe in Grönland. Erst jetzt entdecken Forschende auf Satellitenbildern einen zwei Quadratkilometer großen Krater, der dabei entsteht. Sie können ihren Augen nicht trauen - und halten die Daten zuerst für einen Fehler.
Im Jahr 2014 ereignet sich eine Flutkatastrophe in Grönland. Erst jetzt entdecken Forschende auf Satellitenbildern einen zwei Quadratkilometer großen Krater, der dabei entsteht. Sie können ihren Augen nicht trauen - und halten die Daten zuerst für einen Fehler.
 Die Tiefen des Marianengrabens im Pazifischen Ozean sind nur wenig erforscht. Im vergangenen Jahr begeben sich Wissenschaftler immer wieder in die Tiefseerinne herab. In mehreren Kilometern Tiefe finden sie dabei Spektakuläres vor.
Die Tiefen des Marianengrabens im Pazifischen Ozean sind nur wenig erforscht. Im vergangenen Jahr begeben sich Wissenschaftler immer wieder in die Tiefseerinne herab. In mehreren Kilometern Tiefe finden sie dabei Spektakuläres vor.
 Sie wiegt nur 20 Gramm und sieht aus wie ein Insekt: In England ist die Figur eines Grashüpfers versteigert worden, die aus dem Grab von Tutanchamun stammen soll. Über die lange Reise einer antiken Kostbarkeit.
Sie wiegt nur 20 Gramm und sieht aus wie ein Insekt: In England ist die Figur eines Grashüpfers versteigert worden, die aus dem Grab von Tutanchamun stammen soll. Über die lange Reise einer antiken Kostbarkeit.
 Im Netz breiten sich massenhaft generierte KI-Inhalte rasend schnell aus. Das belegt eine neue Studie. Das Forscherteam warnt vor Gefahren für die Demokratie.
Im Netz breiten sich massenhaft generierte KI-Inhalte rasend schnell aus. Das belegt eine neue Studie. Das Forscherteam warnt vor Gefahren für die Demokratie.
 Menschen atmen mehr Mikroplastik ein als bislang gedacht, wie eine Studie aufzeigt. Besonders stark belastet ist die Luft in Innenräumen und Autos. Die Teilchen könnten Forschern zufolge tief in die Lunge eindringen.
Menschen atmen mehr Mikroplastik ein als bislang gedacht, wie eine Studie aufzeigt. Besonders stark belastet ist die Luft in Innenräumen und Autos. Die Teilchen könnten Forschern zufolge tief in die Lunge eindringen.
 Wer Software zum Schummeln in Games anbietet, verstößt nicht gegen das Urheberrecht, urteilt der Bundesgerichtshof. Ein Streit zwischen Axel Springer und dem Hersteller von Adblock Plus geht weiter.
Wer Software zum Schummeln in Games anbietet, verstößt nicht gegen das Urheberrecht, urteilt der Bundesgerichtshof. Ein Streit zwischen Axel Springer und dem Hersteller von Adblock Plus geht weiter.
 Ein Blitz von unglaublichen 829 Kilometern Länge wird von der Weltwetterorganisation als neuer Weltrekord anerkannt. Die Strecke entspricht fast der Luftlinie quer durch Deutschland. Neue Satellitendaten machen diese Messungen möglich.
Ein Blitz von unglaublichen 829 Kilometern Länge wird von der Weltwetterorganisation als neuer Weltrekord anerkannt. Die Strecke entspricht fast der Luftlinie quer durch Deutschland. Neue Satellitendaten machen diese Messungen möglich.
 Die Knolle der Kartoffelpflanze ist ihre Superkraft - und sichert ihr das Überleben. Doch wie die Knolle entstanden ist, bleibt lange Zeit mysteriös. Forscher wollen das Rätsel nun gelöst haben. Demnach spielt auch die Tomate eine entscheidende Rolle.
Die Knolle der Kartoffelpflanze ist ihre Superkraft - und sichert ihr das Überleben. Doch wie die Knolle entstanden ist, bleibt lange Zeit mysteriös. Forscher wollen das Rätsel nun gelöst haben. Demnach spielt auch die Tomate eine entscheidende Rolle.
 Die Computer von Botschaftsmitarbeitern sollen in Moskau offenbar gezielt ausspioniert werden, warnt Microsoft. Besonders brisant: Die Schadsoftware wird in den Datenstrom russischer Provider eingeschleust.
Die Computer von Botschaftsmitarbeitern sollen in Moskau offenbar gezielt ausspioniert werden, warnt Microsoft. Besonders brisant: Die Schadsoftware wird in den Datenstrom russischer Provider eingeschleust.
 In wenigen Wochen stellt Apple die neuen iPhones vor. Offenbar gibt es in diesem Jahr größere Designänderungen, ein ultradünnes "Air" wird erwartet und die Normalos könnten endlich zeitgemäße Displays erhalten.
In wenigen Wochen stellt Apple die neuen iPhones vor. Offenbar gibt es in diesem Jahr größere Designänderungen, ein ultradünnes "Air" wird erwartet und die Normalos könnten endlich zeitgemäße Displays erhalten.
 Donald Trump scheut nichts, um den USA mit KI die globale Macht über die Information zu sichern. Und die Techkonzerne sind seine willigen Gehilfen. Höchste Zeit, den Kontrollverlust zu stoppen.
Donald Trump scheut nichts, um den USA mit KI die globale Macht über die Information zu sichern. Und die Techkonzerne sind seine willigen Gehilfen. Höchste Zeit, den Kontrollverlust zu stoppen.
 Der August ist ein guter Monat für Sterngucker. Jährlich treten die Perseiden als besonderes Himmelsspektakel auf. Ihren Höhepunkt kann man Mitte des Monats verfolgen - allerdings muss das Wetter mitspielen.
Der August ist ein guter Monat für Sterngucker. Jährlich treten die Perseiden als besonderes Himmelsspektakel auf. Ihren Höhepunkt kann man Mitte des Monats verfolgen - allerdings muss das Wetter mitspielen.
 Microsoft hat die schwerwiegende Schwachstelle in seiner Sharepoint-Software behoben, doch noch immer nehmen Cyber-Attacken darüber zu. Ein großer Teil der infizierten Server bedient in Deutschland tätige Unternehmen und Behörden. Ein zentrales Element der deutschen Wirtschaft gerät besonders ins Visier.
Microsoft hat die schwerwiegende Schwachstelle in seiner Sharepoint-Software behoben, doch noch immer nehmen Cyber-Attacken darüber zu. Ein großer Teil der infizierten Server bedient in Deutschland tätige Unternehmen und Behörden. Ein zentrales Element der deutschen Wirtschaft gerät besonders ins Visier.
 Im US-Reservat Savannah River Site wurde in den 1950er-Jahren Plutonium für die Herstellung von Atombomben gewonnen. Die Anlage ist weiterhin aktiv, auch Atommüll wird dort gelagert. Nun sorgt dort ein radioaktives Wespennest für Aufsehen.
Im US-Reservat Savannah River Site wurde in den 1950er-Jahren Plutonium für die Herstellung von Atombomben gewonnen. Die Anlage ist weiterhin aktiv, auch Atommüll wird dort gelagert. Nun sorgt dort ein radioaktives Wespennest für Aufsehen.
 Zunächst haben Forschende das Ereignis in den Messdaten übersehen. Dann hat die Weltwetterorganisation noch mal genauer hingeschaut: Ein Blitz aus dem Jahr 2017 ist nun offiziell der längste der Welt.
Zunächst haben Forschende das Ereignis in den Messdaten übersehen. Dann hat die Weltwetterorganisation noch mal genauer hingeschaut: Ein Blitz aus dem Jahr 2017 ist nun offiziell der längste der Welt.
 Seit Kurzem verpflichtet der »Online Safety Act« Onlineplattformen in Großbritannien zu strengeren Jugendschutzregeln. User sind genervt, fast eine halbe Million Menschen fordert die Abschaffung.
Seit Kurzem verpflichtet der »Online Safety Act« Onlineplattformen in Großbritannien zu strengeren Jugendschutzregeln. User sind genervt, fast eine halbe Million Menschen fordert die Abschaffung.
 Die biologische Herkunft der Kartoffel war lange ein Rätsel. Nun haben sich Forschende die Gene der Pflanzen genauer angeschaut und herausgefunden, wie die berühmten Knollen entstanden sind.
Die biologische Herkunft der Kartoffel war lange ein Rätsel. Nun haben sich Forschende die Gene der Pflanzen genauer angeschaut und herausgefunden, wie die berühmten Knollen entstanden sind.
 Derzeit sind mehr Meteore zu sehen als gewöhnlich. Mitte August erreicht der Strom der Perseiden seinen Höhepunkt. Wer besonders viele Sternschnuppen sehen möchte, hat in der zweiten Nachthälfte die besten Chancen.
Derzeit sind mehr Meteore zu sehen als gewöhnlich. Mitte August erreicht der Strom der Perseiden seinen Höhepunkt. Wer besonders viele Sternschnuppen sehen möchte, hat in der zweiten Nachthälfte die besten Chancen.
 Wegen eines umstrittenen Tweets zum Attentat auf Donald Trump wurde der Satiriker Sebastian Hotz angeklagt – und freigesprochen. Doch für die Berliner Justiz ist der Fall noch nicht abgeschlossen.
Wegen eines umstrittenen Tweets zum Attentat auf Donald Trump wurde der Satiriker Sebastian Hotz angeklagt – und freigesprochen. Doch für die Berliner Justiz ist der Fall noch nicht abgeschlossen.
 Es ist ein Riesenproblem für die Alpen - und ein Alarmzeichen: Die Gletscherschmelze beginnt immer früher. Mehr noch: Seit mehr als 20 Jahren gibt es in der Schweiz kein Gletscherwachstum mehr.
Es ist ein Riesenproblem für die Alpen - und ein Alarmzeichen: Die Gletscherschmelze beginnt immer früher. Mehr noch: Seit mehr als 20 Jahren gibt es in der Schweiz kein Gletscherwachstum mehr.
 Unter anderem mit Granatapfelkernen an Bord ist die "Crew 11" am Ziel angelangt: Auf der Internationalen Raumstation wollen die vier Raumfahrer aber nicht nur den Einfluss von Schwerelosigkeit aufs Wachstum erforschen. Sie arbeiten auch an der für 2027 geplanten bemannten Mondlandung.
Unter anderem mit Granatapfelkernen an Bord ist die "Crew 11" am Ziel angelangt: Auf der Internationalen Raumstation wollen die vier Raumfahrer aber nicht nur den Einfluss von Schwerelosigkeit aufs Wachstum erforschen. Sie arbeiten auch an der für 2027 geplanten bemannten Mondlandung.
 Die EU verspricht den USA, Öl und Gas für 750 Milliarden Dollar zu kaufen. Experten warnen: Das würde Europas Klimaziele gefährden und die Staatengemeinschaft von Trump abhängig machen.
Die EU verspricht den USA, Öl und Gas für 750 Milliarden Dollar zu kaufen. Experten warnen: Das würde Europas Klimaziele gefährden und die Staatengemeinschaft von Trump abhängig machen.
 Ein Schönling mit kurzem Rock, Schwert und Schnauzbart: Das Hermannsdenkmal bei Detmold ist eines der beliebtesten Ausflugsziele Deutschlands. Zu ihrem Jubiläum muss die Statue für allerlei Klamauk herhalten.
Ein Schönling mit kurzem Rock, Schwert und Schnauzbart: Das Hermannsdenkmal bei Detmold ist eines der beliebtesten Ausflugsziele Deutschlands. Zu ihrem Jubiläum muss die Statue für allerlei Klamauk herhalten.
 Mit leichter Verzögerung sind vier Astronauten an der Internationalen Raumstation eingetroffen. Sie werden in den kommenden Monaten Experimente im All durchführen, unter anderem für die Nasa-Mondmission.
Mit leichter Verzögerung sind vier Astronauten an der Internationalen Raumstation eingetroffen. Sie werden in den kommenden Monaten Experimente im All durchführen, unter anderem für die Nasa-Mondmission.
 Um das Jahr 1550 herum oder noch früher soll der Vulkan Krascheninnikow zuletzt aktiv gewesen sein. Hat ihn das Beben vor Kamtschatka nun aufgeweckt?
Um das Jahr 1550 herum oder noch früher soll der Vulkan Krascheninnikow zuletzt aktiv gewesen sein. Hat ihn das Beben vor Kamtschatka nun aufgeweckt?
 Ein Team an der Universität Gießen stellt erstmals ein Molekül her, das aus sechs Stickstoffatomen besteht. Es ist die energiereichste Substanz der Welt. Wie das gelang und wie der N6 genannte Stoff die Raumfahrt revolutionieren könnte, verriet Chemiker Peter Schreiner im Gespräch mit ntv.de.
Ein Team an der Universität Gießen stellt erstmals ein Molekül her, das aus sechs Stickstoffatomen besteht. Es ist die energiereichste Substanz der Welt. Wie das gelang und wie der N6 genannte Stoff die Raumfahrt revolutionieren könnte, verriet Chemiker Peter Schreiner im Gespräch mit ntv.de.
 Um die Körpersprache von Katzen besser zu verstehen, haben Neurowissenschaftler dazu aufgerufen, Handyvideos einzuschicken. Ein Grund? Anders als Hunde seien Katzen eher nicht für kontrollierte Laborbedingungen geeignet.
Um die Körpersprache von Katzen besser zu verstehen, haben Neurowissenschaftler dazu aufgerufen, Handyvideos einzuschicken. Ein Grund? Anders als Hunde seien Katzen eher nicht für kontrollierte Laborbedingungen geeignet.
 Kettensägen-Killer, Tiere mit Atomwaffen, mordende Witwen und die neun Kreise der Hölle: Wer Böses auf den Tisch bringen will, kommt hier auf seine Kosten. Fünf Tipps für Unerschrockene.
Kettensägen-Killer, Tiere mit Atomwaffen, mordende Witwen und die neun Kreise der Hölle: Wer Böses auf den Tisch bringen will, kommt hier auf seine Kosten. Fünf Tipps für Unerschrockene.
 Der viele Regen der letzten Tage ist gut für Pollenallergiker, denn er wäscht die Pollen aus der Luft - so zumindest die weit verbreitete Annahme. Doch das ist gar nicht unbedingt so, stellt ein Allergieforscher richtig.
Der viele Regen der letzten Tage ist gut für Pollenallergiker, denn er wäscht die Pollen aus der Luft - so zumindest die weit verbreitete Annahme. Doch das ist gar nicht unbedingt so, stellt ein Allergieforscher richtig.
 Der viele Regen der letzten Tage ist gut für Pollenallergiker, denn er wäscht die Pollen aus der Luft - so zumindest die weitverbreitete Annahme. Doch das ist gar nicht unbedingt so, stellt ein Allergieforscher richtig.
Der viele Regen der letzten Tage ist gut für Pollenallergiker, denn er wäscht die Pollen aus der Luft - so zumindest die weitverbreitete Annahme. Doch das ist gar nicht unbedingt so, stellt ein Allergieforscher richtig.
 Rheuma ist eine vielschichtige und oftmals schmerzhafte Erkrankung. Nicht allen Betroffenen kann mit Medikamenten geholfen werden. Ein Implantat, das einen bestimmten Nerv stimuliert, überzeugt - auch die Zulassungsbehörde in den USA.
Rheuma ist eine vielschichtige und oftmals schmerzhafte Erkrankung. Nicht allen Betroffenen kann mit Medikamenten geholfen werden. Ein Implantat, das einen bestimmten Nerv stimuliert, überzeugt - auch die Zulassungsbehörde in den USA.
 Viele Politiker und Eltern fordern, Jugendliche von Social-Media-Plattformen auszuschließen. Doch so einfach ist das gar nicht. Details werden entscheiden, ob die Maßnahmen verpuffen.
Viele Politiker und Eltern fordern, Jugendliche von Social-Media-Plattformen auszuschließen. Doch so einfach ist das gar nicht. Details werden entscheiden, ob die Maßnahmen verpuffen.
 In den USA wurden vier radioaktiv verseuchte Wespennester auf einer alten Nuklearanlage gefunden, die im Kalten Krieg gebaut worden war, um Materialien für Atomwaffen zu produzieren. Anwohner sind besorgt. Das ist über den Fall bekannt.
In den USA wurden vier radioaktiv verseuchte Wespennester auf einer alten Nuklearanlage gefunden, die im Kalten Krieg gebaut worden war, um Materialien für Atomwaffen zu produzieren. Anwohner sind besorgt. Das ist über den Fall bekannt.
 Die Nasa will laut der US-Nachrichtenseite »Politico« Vorschläge aus der Industrie für einen Reaktor auf dem Mond einholen. Er soll bis 2030 in Betrieb gehen. Der straffe Zeitplan hat auch mit der Sorge vor Konkurrenz zu tun.
Die Nasa will laut der US-Nachrichtenseite »Politico« Vorschläge aus der Industrie für einen Reaktor auf dem Mond einholen. Er soll bis 2030 in Betrieb gehen. Der straffe Zeitplan hat auch mit der Sorge vor Konkurrenz zu tun.
 Dürren, Waldbrände und bedrohte Ernten: Im Mittelmeerraum verzeichnen viele Länder in diesem Monat extreme Trockenheit. Besonders auffällig ist der Wert im Vergleich mit dem Beginn der Messungen.
Dürren, Waldbrände und bedrohte Ernten: Im Mittelmeerraum verzeichnen viele Länder in diesem Monat extreme Trockenheit. Besonders auffällig ist der Wert im Vergleich mit dem Beginn der Messungen.
 Immer wieder richten Tsunamis verheerende Schäden an. Besonders die Nuklear-Katastrophe von Fukushima ist weltbekannt. Doch wie entstehen sie und was macht einen Tsunami eigentlich aus?
Immer wieder richten Tsunamis verheerende Schäden an. Besonders die Nuklear-Katastrophe von Fukushima ist weltbekannt. Doch wie entstehen sie und was macht einen Tsunami eigentlich aus?
 Gäbe es in Deutschland keine Zuwanderung, würde die Bevölkerungszahl schrumpfen. Grund: die sinkende Geburtenrate. Die gibt in den vergangenen Jahren erneut nach. Einer Studie zufolge wollen Männer und Frauen hierzulande aber mehr Kinder haben. Zahlreiche Krisen sorgen jedoch für große Unsicherheit.
Gäbe es in Deutschland keine Zuwanderung, würde die Bevölkerungszahl schrumpfen. Grund: die sinkende Geburtenrate. Die gibt in den vergangenen Jahren erneut nach. Einer Studie zufolge wollen Männer und Frauen hierzulande aber mehr Kinder haben. Zahlreiche Krisen sorgen jedoch für große Unsicherheit.
 Leber, Herz, Gehirn: Mikroplastik reichert sich auch im menschlichen Körper an. Welche genauen Auswirkungen das hat, ist unklar. Forscher dringen dennoch auf Maßnahmen. Ob es auf der heute beginnenden Konferenz der Vereinten Nationen in Genf eine Lösung gibt, ist aber ungewiss.
Leber, Herz, Gehirn: Mikroplastik reichert sich auch im menschlichen Körper an. Welche genauen Auswirkungen das hat, ist unklar. Forscher dringen dennoch auf Maßnahmen. Ob es auf der heute beginnenden Konferenz der Vereinten Nationen in Genf eine Lösung gibt, ist aber ungewiss.
 Als Vorsichtsmaßnahme gegen Stromausfälle haben zwei Netzbetreiber Abkommen mit Google getroffen: Wenn der Energiebedarf steigt, müssen die Rechenzentren zurückstecken.
Als Vorsichtsmaßnahme gegen Stromausfälle haben zwei Netzbetreiber Abkommen mit Google getroffen: Wenn der Energiebedarf steigt, müssen die Rechenzentren zurückstecken.
 Der Westen der USA hat ein Wolfsproblem: Immer mehr Weidetiere werden von gerissen. Um das zu verhindern, setzt das Landwirtschaftsministerium Drohnen ein – und Scarlett Johanssons Stimme.
Der Westen der USA hat ein Wolfsproblem: Immer mehr Weidetiere werden von gerissen. Um das zu verhindern, setzt das Landwirtschaftsministerium Drohnen ein – und Scarlett Johanssons Stimme.
 Auf der australischen Insel Heard Island schmelzen die Gletscher dramatisch schnell. Wissenschaftler warnen vor verheerenden Folgen für die Artenvielfalt und sprechen von einem »besorgniserregenden Bild«.
Auf der australischen Insel Heard Island schmelzen die Gletscher dramatisch schnell. Wissenschaftler warnen vor verheerenden Folgen für die Artenvielfalt und sprechen von einem »besorgniserregenden Bild«.
 Der Mond bleibt bei den Raumfahrtnationen ein Sehnsuchtsziel. Um auch auf dem Erdtrabanten Energie nutzen zu können, erwägt die Nasa den Bau eines Atomreaktors. Doch die Idee ist nicht neu, wie Pläne von Russland und China beweisen.
Der Mond bleibt bei den Raumfahrtnationen ein Sehnsuchtsziel. Um auch auf dem Erdtrabanten Energie nutzen zu können, erwägt die Nasa den Bau eines Atomreaktors. Doch die Idee ist nicht neu, wie Pläne von Russland und China beweisen.
 Nach wochenlangem Dauerregen kündigen sich die ersten heißen Tage an. Marco Manitta vom Deutschen Wetterdienst erklärt, warum das so lange gedauert hat – und wo nun das schlechte Wetter bevorsteht.
Nach wochenlangem Dauerregen kündigen sich die ersten heißen Tage an. Marco Manitta vom Deutschen Wetterdienst erklärt, warum das so lange gedauert hat – und wo nun das schlechte Wetter bevorsteht.
 In der Kabine drückt es häufiger im Bauch als am Boden. Mediziner erklären das Phänomen mit dem Luftdruck in großer Höhe. Eine dänische Forschergruppe hat dem Problem nachgespürt - und gibt eine ungewöhnliche Empfehlung ab.
In der Kabine drückt es häufiger im Bauch als am Boden. Mediziner erklären das Phänomen mit dem Luftdruck in großer Höhe. Eine dänische Forschergruppe hat dem Problem nachgespürt - und gibt eine ungewöhnliche Empfehlung ab.
 Das Great Barrier Reef vor Australien ist das größte Korallenriff der Welt. Durch hohe Wassertemperaturen sind die Korallen jetzt bedroht wie noch nie. Hauptursache sei der Klimawandel, so die Autoren einer neuen Studie.
Das Great Barrier Reef vor Australien ist das größte Korallenriff der Welt. Durch hohe Wassertemperaturen sind die Korallen jetzt bedroht wie noch nie. Hauptursache sei der Klimawandel, so die Autoren einer neuen Studie.
 Baseus bringt drei neue Ladegeräte für unterwegs auf den Markt, die leistungsfähig und praktisch, aber durch Einsparungen beim Funktionsumfang vergleichsweise günstig sind. Im Praxistest hinterlassen sie grundsätzlich einen guten Eindruck, obwohl die Beschreibung nicht immer korrekt ist.
Baseus bringt drei neue Ladegeräte für unterwegs auf den Markt, die leistungsfähig und praktisch, aber durch Einsparungen beim Funktionsumfang vergleichsweise günstig sind. Im Praxistest hinterlassen sie grundsätzlich einen guten Eindruck, obwohl die Beschreibung nicht immer korrekt ist.
 460 Millionen Tonnen Plastik produziert die Menschheit jedes Jahr, viele davon landen in der Natur. Mit einem Abkommen wollen die Vereinten Nationen die Lage verbessern. Es wäre wichtig – auch für unsere Gesundheit.
460 Millionen Tonnen Plastik produziert die Menschheit jedes Jahr, viele davon landen in der Natur. Mit einem Abkommen wollen die Vereinten Nationen die Lage verbessern. Es wäre wichtig – auch für unsere Gesundheit.
 Robert F. Kennedy Jr. hält mRNA-Impfstoffe bei Infektionen der oberen Atemwege für nicht wirksam. Jetzt kündigte der US-Gesundheitsminister Konsequenzen an.
Robert F. Kennedy Jr. hält mRNA-Impfstoffe bei Infektionen der oberen Atemwege für nicht wirksam. Jetzt kündigte der US-Gesundheitsminister Konsequenzen an.
 Donald Trump scheut nichts, um den USA mit KI die globale Macht über die Information zu sichern. Und die Techkonzerne sind seine willigen Gehilfen. Höchste Zeit, den Kontrollverlust zu stoppen.
Donald Trump scheut nichts, um den USA mit KI die globale Macht über die Information zu sichern. Und die Techkonzerne sind seine willigen Gehilfen. Höchste Zeit, den Kontrollverlust zu stoppen.
 200 Millionen Views in wenigen Tagen: Ein vermeintliches Überwachungsvideo trampolinspringender Kaninchen geht auf TikTok viral. Der Clip ist KI-generiert – und stürzt manche Nutzer in eine Vertrauenskrise.
200 Millionen Views in wenigen Tagen: Ein vermeintliches Überwachungsvideo trampolinspringender Kaninchen geht auf TikTok viral. Der Clip ist KI-generiert – und stürzt manche Nutzer in eine Vertrauenskrise.
 200 Millionen Views in wenigen Tagen: Ein vermeintliches Überwachungsvideo trampolinspringender Kaninchen geht auf TikTok viral. Der Clip ist KI-generiert – und stürzt manche Nutzer in eine Vertrauenskrise.
200 Millionen Views in wenigen Tagen: Ein vermeintliches Überwachungsvideo trampolinspringender Kaninchen geht auf TikTok viral. Der Clip ist KI-generiert – und stürzt manche Nutzer in eine Vertrauenskrise.
 Vodafone alarmiert seit Ende April Kunden bei potenziellen Betrugsanrufen. Die Zahl der Warnungen ist beträchtlich.
Vodafone alarmiert seit Ende April Kunden bei potenziellen Betrugsanrufen. Die Zahl der Warnungen ist beträchtlich.
 Mit dem durch Mücken übertragenen Chikungunya-Virus haben sich in China inzwischen fast 8000 Menschen infiziert. Um den Ausbruch einzudämmen, werden zum Teil strikte Maßnahmen ergriffen, die an die Corona-Pandemie erinnern. Aber auch die Mücken werden bekämpft - mit anderen Mücken.
Mit dem durch Mücken übertragenen Chikungunya-Virus haben sich in China inzwischen fast 8000 Menschen infiziert. Um den Ausbruch einzudämmen, werden zum Teil strikte Maßnahmen ergriffen, die an die Corona-Pandemie erinnern. Aber auch die Mücken werden bekämpft - mit anderen Mücken.
 Bislang ist ungewiss, ob die USA an der Klimakonferenz COP30 teilnehmen. Luiz Inácio Lula da Silva, der Präsident des Gastgeberlandes Brasilien, will am Telefon Überzeugungsarbeit bei Donald Trump leisten.
Bislang ist ungewiss, ob die USA an der Klimakonferenz COP30 teilnehmen. Luiz Inácio Lula da Silva, der Präsident des Gastgeberlandes Brasilien, will am Telefon Überzeugungsarbeit bei Donald Trump leisten.
 Das Great Barrier Reef steht unter massivem Stress - schon länger, aber in den letzten Monaten besonders: Wirbelstürme, hohe Temperaturen und gefräßige Seesterne setzen dem Riff zu. Das führt zum schwersten Verlust an Korallen seit Beginn der Messungen.
Das Great Barrier Reef steht unter massivem Stress - schon länger, aber in den letzten Monaten besonders: Wirbelstürme, hohe Temperaturen und gefräßige Seesterne setzen dem Riff zu. Das führt zum schwersten Verlust an Korallen seit Beginn der Messungen.
 Das Great Barrier Reef steht unter massivem Stress - schon länger, aber in den letzten Monaten besonders: Wirbelstürme, hohe Temperaturen und gefräßige Seesterne setzen dem Riff zu. Das führt zum schwersten Verlust an Korallen seit Beginn der Messungen vor fast 40 Jahren.
Das Great Barrier Reef steht unter massivem Stress - schon länger, aber in den letzten Monaten besonders: Wirbelstürme, hohe Temperaturen und gefräßige Seesterne setzen dem Riff zu. Das führt zum schwersten Verlust an Korallen seit Beginn der Messungen vor fast 40 Jahren.
 Die KI von Elon Musk kann nun auch kurze Videos erstellen. Doch weil der Chef einen »Spicy«-Modus einbauen ließ, werden auch problematische Fake-Nacktvideos generiert. Prominentes Beispiel: Taylor Swift.
Die KI von Elon Musk kann nun auch kurze Videos erstellen. Doch weil der Chef einen »Spicy«-Modus einbauen ließ, werden auch problematische Fake-Nacktvideos generiert. Prominentes Beispiel: Taylor Swift.
 Wer sein Englisch trainieren will, kann dafür Kino und Fernsehen nutzen. Länder, die Filme und Serien im englischen Originalton und mit Untertiteln zeigen, verbessern so das Sprachniveau der Einwohnerinnen und Einwohner.
Wer sein Englisch trainieren will, kann dafür Kino und Fernsehen nutzen. Länder, die Filme und Serien im englischen Originalton und mit Untertiteln zeigen, verbessern so das Sprachniveau der Einwohnerinnen und Einwohner.
 Je mehr internetfähige Geräte in einem Haushalt stehen, desto wichtiger ist ein schnelles und stabiles WLAN, doch die Realität sieht oft anders aus: Verbindungen kommen nicht zustande, brechen ab oder die Datenraten sind langsam. Einen Fachmann muss man deshalb aber nicht gleich rufen.
Je mehr internetfähige Geräte in einem Haushalt stehen, desto wichtiger ist ein schnelles und stabiles WLAN, doch die Realität sieht oft anders aus: Verbindungen kommen nicht zustande, brechen ab oder die Datenraten sind langsam. Einen Fachmann muss man deshalb aber nicht gleich rufen.
 In der Coronapandemie haben mRNA-Impfungen Millionen Menschen das Leben gerettet. Nun streicht der US-Gesundheitsminister im großen Stil Forschungsgelder für diese Technologie. Experten sind entsetzt.
In der Coronapandemie haben mRNA-Impfungen Millionen Menschen das Leben gerettet. Nun streicht der US-Gesundheitsminister im großen Stil Forschungsgelder für diese Technologie. Experten sind entsetzt.
 Die "Ähnlichkeiten mit dem menschlichen Tanzen" erstaunen australische Forscher: Sie beobachten bei Kakadus eine überraschend große Zahl rhythmischer Bewegungen. Was steckt dahinter? Hat das Tanzen einen bestimmten Zweck oder macht es den Papageien einfach nur Spaß?
Die "Ähnlichkeiten mit dem menschlichen Tanzen" erstaunen australische Forscher: Sie beobachten bei Kakadus eine überraschend große Zahl rhythmischer Bewegungen. Was steckt dahinter? Hat das Tanzen einen bestimmten Zweck oder macht es den Papageien einfach nur Spaß?
 Seit 2017 könnten Beamte beim Verdacht auf schwere Straftaten heimlich Trojaner auf Computer und Handys schicken. Der Verein Digitalcourage hat dagegen geklagt – nun hat Karlsruhe in der Sache entschieden.
Seit 2017 könnten Beamte beim Verdacht auf schwere Straftaten heimlich Trojaner auf Computer und Handys schicken. Der Verein Digitalcourage hat dagegen geklagt – nun hat Karlsruhe in der Sache entschieden.
 Sie sind einfach so praktisch, die Tiefkühlessen oder Müsliriegel. Doch ob fertig oder hausgemacht, das macht bei vielen Gerichten einen großen Unterschied - einer Studie zufolge sogar in Bezug aufs Abnehmen. Das gilt auch, wenn die Fertigprodukte von den Nährwerten her ausgewogen sind.
Sie sind einfach so praktisch, die Tiefkühlessen oder Müsliriegel. Doch ob fertig oder hausgemacht, das macht bei vielen Gerichten einen großen Unterschied - einer Studie zufolge sogar in Bezug aufs Abnehmen. Das gilt auch, wenn die Fertigprodukte von den Nährwerten her ausgewogen sind.
 OpenAI will mit dem »Lernmodus« weiter in den Alltag von Schülern und Studenten vordringen. Macht die neue Funktion das Bildungssystem besser oder wird OpenAIs wachsender Einfluss an Unis und Schulen zum Problem?
OpenAI will mit dem »Lernmodus« weiter in den Alltag von Schülern und Studenten vordringen. Macht die neue Funktion das Bildungssystem besser oder wird OpenAIs wachsender Einfluss an Unis und Schulen zum Problem?
 Zwei Nasa-Missionen beobachten, wie und wo auf der Erde Kohlendioxid ausgestoßen und absorbiert wird. Die Beobachtungen liefert wichtige Daten zur Klimakrise. US-Präsident Trump will die Forschung nun torpedieren.
Zwei Nasa-Missionen beobachten, wie und wo auf der Erde Kohlendioxid ausgestoßen und absorbiert wird. Die Beobachtungen liefert wichtige Daten zur Klimakrise. US-Präsident Trump will die Forschung nun torpedieren.
 Ein kleiner Tümpel im Westen Indiens entpuppt sich als Hotspot für Artenvielfalt: Neben Wasserpflanzen, Armfüßlern und Kaulquappen lebt dort auch eine völlig neue Krebsart, die Forscher nun entdecken. Die kleinen Tierchen könnten dabei nicht die einzigen bislang unbekannten Wesen dort sein.
Ein kleiner Tümpel im Westen Indiens entpuppt sich als Hotspot für Artenvielfalt: Neben Wasserpflanzen, Armfüßlern und Kaulquappen lebt dort auch eine völlig neue Krebsart, die Forscher nun entdecken. Die kleinen Tierchen könnten dabei nicht die einzigen bislang unbekannten Wesen dort sein.
 Chiasamen, Goji-Beeren oder Açai-Pulver: Der Markt für sogenanntes Superfood boomt. Dabei gibt es eine Reihe einheimischer Früchte, die die Gesundheit genauso fördern können. Ein Experte macht sich für Trauben stark.
Chiasamen, Goji-Beeren oder Açai-Pulver: Der Markt für sogenanntes Superfood boomt. Dabei gibt es eine Reihe einheimischer Früchte, die die Gesundheit genauso fördern können. Ein Experte macht sich für Trauben stark.
 Schleimpilze bilden riesige Netzwerke und lösen komplexe Probleme, obwohl sie weder Tier noch Pflanze sind. Manche haben sogar Spitznamen. Warum sie sich auch gut als Haustiere eignen, erklärt ein Zellbiologe.
Schleimpilze bilden riesige Netzwerke und lösen komplexe Probleme, obwohl sie weder Tier noch Pflanze sind. Manche haben sogar Spitznamen. Warum sie sich auch gut als Haustiere eignen, erklärt ein Zellbiologe.
 Zwei Nasa-Missionen beobachten, wie und wo auf der Erde Kohlendioxid ausgestoßen und absorbiert wird. Die Beobachtungen liefern wichtige Daten zur Klimakrise. US-Präsident Trump will die Forschung nun torpedieren.
Zwei Nasa-Missionen beobachten, wie und wo auf der Erde Kohlendioxid ausgestoßen und absorbiert wird. Die Beobachtungen liefern wichtige Daten zur Klimakrise. US-Präsident Trump will die Forschung nun torpedieren.
 Seit 2017 können Ermittler beim Verdacht auf schwere Straftaten heimlich Trojaner auf Computer und Handys schicken. Diese Praxis hat das Bundesverfassungsgericht im Wesentlichen nun bestätigt, der Gesetzgeber muss aber nachbessern.
Seit 2017 können Ermittler beim Verdacht auf schwere Straftaten heimlich Trojaner auf Computer und Handys schicken. Diese Praxis hat das Bundesverfassungsgericht im Wesentlichen nun bestätigt, der Gesetzgeber muss aber nachbessern.
 Kartoffeln auf die eins? Das kommt auf die Art der Zubereitung an, meinen Forscher, zumindest, wenn es um das Diabetesrisiko geht. Hohen Pommeskonsum sehen sie kritisch.
Kartoffeln auf die eins? Das kommt auf die Art der Zubereitung an, meinen Forscher, zumindest, wenn es um das Diabetesrisiko geht. Hohen Pommeskonsum sehen sie kritisch.
 Fotograf Dominik Reigl zog mal wieder auf Erkundungstour durch die Natur, ohne Erfolg. Dann tauchte plötzlich ein seltener Fuchs vor seiner Linse auf. Und nein, das ist kein Albino.
Fotograf Dominik Reigl zog mal wieder auf Erkundungstour durch die Natur, ohne Erfolg. Dann tauchte plötzlich ein seltener Fuchs vor seiner Linse auf. Und nein, das ist kein Albino.
 Die italienische Polizei hatte im Mai einen Mann festgenommen, der Wohnungssuchende in München abgezockt haben soll. Als deutsche Beamte ihn übernehmen wollten, erlebten sie eine Überraschung.
Die italienische Polizei hatte im Mai einen Mann festgenommen, der Wohnungssuchende in München abgezockt haben soll. Als deutsche Beamte ihn übernehmen wollten, erlebten sie eine Überraschung.
 In Südfrankreich wütet das verheerendste Feuer seit mehr als siebzig Jahren. Nun droht eine Hitzewelle mit trockenen, heißen Winden. Was das für die Region bedeutet.
In Südfrankreich wütet das verheerendste Feuer seit mehr als siebzig Jahren. Nun droht eine Hitzewelle mit trockenen, heißen Winden. Was das für die Region bedeutet.
 Die Ecoflow Rapid Pro ist eine Powerbank, die nahezu alles bietet, was man sich aktuell von einer reisetauglichen Stromtankstelle wünschen kann. Mit bis zu 300 W kann sie notfalls drei Laptops gleichzeitig aufladen, mit dem passenden Sockel ist sie selbst mit bis zu 320 W blitzschnell aufgetankt.
Die Ecoflow Rapid Pro ist eine Powerbank, die nahezu alles bietet, was man sich aktuell von einer reisetauglichen Stromtankstelle wünschen kann. Mit bis zu 300 W kann sie notfalls drei Laptops gleichzeitig aufladen, mit dem passenden Sockel ist sie selbst mit bis zu 320 W blitzschnell aufgetankt.
 700 Millionen Menschen nutzen laut OpenAI regelmäßig ChatGPT. Mit der neuen Version sollen sie einen kompetenteren Begleiter an ihrer Seite haben als bisher, so Firmenchef Altman.
700 Millionen Menschen nutzen laut OpenAI regelmäßig ChatGPT. Mit der neuen Version sollen sie einen kompetenteren Begleiter an ihrer Seite haben als bisher, so Firmenchef Altman.
 Kochen ist ein Spiel mit Hitze. Die richtige Temperatur setzt eine chemische Wandlung in Gang, die Speisen ihren einzigartigen Geschmack gibt: Was ist das Geheimnis dieser Maillard-Reaktion?
Kochen ist ein Spiel mit Hitze. Die richtige Temperatur setzt eine chemische Wandlung in Gang, die Speisen ihren einzigartigen Geschmack gibt: Was ist das Geheimnis dieser Maillard-Reaktion?
 US-Präsident Trump versucht, den Klimawandel mit aller Macht zu ignorieren. Dafür lässt seine Regierung nun wohl sogar einen Nasa-Satelliten zerstören. Ein deutsches Projekt will wichtige Daten retten.
US-Präsident Trump versucht, den Klimawandel mit aller Macht zu ignorieren. Dafür lässt seine Regierung nun wohl sogar einen Nasa-Satelliten zerstören. Ein deutsches Projekt will wichtige Daten retten.
 Mit ambitionierten Plänen überrascht die Nasa in dieser Woche. Die US-Raumfahrtbehörde will auf der Mondoberfläche einen Atomreaktor errichten - und das bereits bis 2030. Ist das überhaupt machbar?
Mit ambitionierten Plänen überrascht die Nasa in dieser Woche. Die US-Raumfahrtbehörde will auf der Mondoberfläche einen Atomreaktor errichten - und das bereits bis 2030. Ist das überhaupt machbar?
 Ein seltener Ausbruch der bakteriellen Krankheit Hib fordert in Hamburg drei Todesopfer. Für gesunde Menschen besteht laut Experten zwar kein größerer Grund zur Sorge. Bei geschwächten Personen kann ein Verlauf allerdings innerhalb weniger Stunden lebensbedrohlich werden.
Ein seltener Ausbruch der bakteriellen Krankheit Hib fordert in Hamburg drei Todesopfer. Für gesunde Menschen besteht laut Experten zwar kein größerer Grund zur Sorge. Bei geschwächten Personen kann ein Verlauf allerdings innerhalb weniger Stunden lebensbedrohlich werden.
 Kakadus haben Rhythmus im Blut, das beweisen zahlreiche Videos auf YouTube und TikTok. Wie vielfältig die Bewegungen der Tiere dabei sind, haben australische Forscher dokumentiert.
Kakadus haben Rhythmus im Blut, das beweisen zahlreiche Videos auf YouTube und TikTok. Wie vielfältig die Bewegungen der Tiere dabei sind, haben australische Forscher dokumentiert.
 Besucher des Dinosaurierparks Teufelsschlucht haben die Zähne eines Flugsauriers entdeckt. Dieser lebte vor über 200 Millionen Jahren. Die ersten Fossilien dieser Art werden nun ausgestellt.
Besucher des Dinosaurierparks Teufelsschlucht haben die Zähne eines Flugsauriers entdeckt. Dieser lebte vor über 200 Millionen Jahren. Die ersten Fossilien dieser Art werden nun ausgestellt.
 Die Plastiklobby schüchtert Forscher ein, beleidigt sie und verbreitet PR-Märchen. Bislang mit Erfolg. Bei der Uno-Konferenz gegen Plastikvermüllung in Genf muss eine Staatenmehrheit endlich für die Kehrtwende sorgen.
Die Plastiklobby schüchtert Forscher ein, beleidigt sie und verbreitet PR-Märchen. Bislang mit Erfolg. Bei der Uno-Konferenz gegen Plastikvermüllung in Genf muss eine Staatenmehrheit endlich für die Kehrtwende sorgen.
 Mit mehr als 200.000 pro Stunde rauscht der Komet 3I/Atlas an der Erde vorbei. Dank »Hubble« existiert jetzt ein deutlicheres Bild des interstellaren Objektes. Aber sein Ursprung gibt Forschern Rätsel auf.
Mit mehr als 200.000 pro Stunde rauscht der Komet 3I/Atlas an der Erde vorbei. Dank »Hubble« existiert jetzt ein deutlicheres Bild des interstellaren Objektes. Aber sein Ursprung gibt Forschern Rätsel auf.
 Der Forscher Reese Richardson hat Betrug in der Wissenschaft untersucht. Er sagt: Nicht einzelne Forscher seien das Problem, sondern das System an sich.
Der Forscher Reese Richardson hat Betrug in der Wissenschaft untersucht. Er sagt: Nicht einzelne Forscher seien das Problem, sondern das System an sich.
 Google stellt am 20. August die neuen Pixel-10-Smartphones vor, doch viele mögliche Eigenschaften der Geräte sind schon jetzt bekannt. Dabei handelt es sich größtenteils um Gerüchte und Leaks, aber auch der Hersteller selbst verrät Details - und spottet über Apple.
Google stellt am 20. August die neuen Pixel-10-Smartphones vor, doch viele mögliche Eigenschaften der Geräte sind schon jetzt bekannt. Dabei handelt es sich größtenteils um Gerüchte und Leaks, aber auch der Hersteller selbst verrät Details - und spottet über Apple.
 Kettensägen-Killer, Tiere mit Atomwaffen, mordende Witwen und die neun Kreise der Hölle: Wer Böses auf den Tisch bringen will, kommt hier auf seine Kosten. Fünf Tipps für Unerschrockene.
Kettensägen-Killer, Tiere mit Atomwaffen, mordende Witwen und die neun Kreise der Hölle: Wer Böses auf den Tisch bringen will, kommt hier auf seine Kosten. Fünf Tipps für Unerschrockene.
 Mit mehr als 200.000 Kilometern pro Stunde rauscht der Komet 3I/Atlas an der Erde vorbei. Dank »Hubble« existiert jetzt ein deutlicheres Bild des interstellaren Objektes. Aber sein Ursprung gibt Forschern Rätsel auf.
Mit mehr als 200.000 Kilometern pro Stunde rauscht der Komet 3I/Atlas an der Erde vorbei. Dank »Hubble« existiert jetzt ein deutlicheres Bild des interstellaren Objektes. Aber sein Ursprung gibt Forschern Rätsel auf.
 Sobald der erste Quantencomputer bereitsteht, sind womöglich alle derzeit üblichen Verschlüsselungssysteme wertlos. Und dann?
Sobald der erste Quantencomputer bereitsteht, sind womöglich alle derzeit üblichen Verschlüsselungssysteme wertlos. Und dann?
 Die Rückreise dauerte fast 18 Stunden: Vier Astronauten sind nach einem monatelangen Aufenthalt in der Internationalen Raumstation wieder auf der Erde gelandet.
Die Rückreise dauerte fast 18 Stunden: Vier Astronauten sind nach einem monatelangen Aufenthalt in der Internationalen Raumstation wieder auf der Erde gelandet.
 Wildschweine erobern die Stadt: Sie durchpflügen Parks, plündern Gärten und greifen sogar Passanten an. Mit neuen Jagdmethoden sollen die gefährlichen Tiere bekämpft werden.
Wildschweine erobern die Stadt: Sie durchpflügen Parks, plündern Gärten und greifen sogar Passanten an. Mit neuen Jagdmethoden sollen die gefährlichen Tiere bekämpft werden.
 Bundestagspräsidentin Julia Klöckner hat offenbar das Potenzial von TikTok erkannt: »An dieser digitalen Theke sind Menschen, die sich nirgendwo anders informieren.«
Bundestagspräsidentin Julia Klöckner hat offenbar das Potenzial von TikTok erkannt: »An dieser digitalen Theke sind Menschen, die sich nirgendwo anders informieren.«
 Der Sommer ist die Zeit der Perseiden, Mitte August sind besonders viele der Sternschnuppen am Himmel zu sehen. Doch in diesem Jahr dürfte es schwierig werden, das Spektakel zu verfolgen.
Der Sommer ist die Zeit der Perseiden, Mitte August sind besonders viele der Sternschnuppen am Himmel zu sehen. Doch in diesem Jahr dürfte es schwierig werden, das Spektakel zu verfolgen.
 Ob Thüringer oder Nürnberger: Bratwürste gehören in Deutschland zu jedem Volksfest dazu. Doch wo gingen die Würste erstmals über den Tresen? Ein zufällig entdecktes Schriftstück könnte die Antwort liefern.
Ob Thüringer oder Nürnberger: Bratwürste gehören in Deutschland zu jedem Volksfest dazu. Doch wo gingen die Würste erstmals über den Tresen? Ein zufällig entdecktes Schriftstück könnte die Antwort liefern.
 Schluss mit Brumm, Pfeif, Tüüt. Nach 34 Jahren streicht der Onlinedienst AOL die Möglichkeit, sich per Modem ins Internet einzuwählen. Erstaunlicher als die Ankündigung ist, dass es diese Option überhaupt noch gab.
Schluss mit Brumm, Pfeif, Tüüt. Nach 34 Jahren streicht der Onlinedienst AOL die Möglichkeit, sich per Modem ins Internet einzuwählen. Erstaunlicher als die Ankündigung ist, dass es diese Option überhaupt noch gab.
 Mit einem neu entwickelten Rechner lässt sich das Alter des Herzens bestimmen. Die Ergebnisse sollen Betroffenen bei der Prävention helfen und Herztote verhindern.
Mit einem neu entwickelten Rechner lässt sich das Alter des Herzens bestimmen. Die Ergebnisse sollen Betroffenen bei der Prävention helfen und Herztote verhindern.
 Eigentlich sollte der ICE L längst deutsche Schienen befahren. Dann kamen Lieferschwierigkeiten und Testverzögerungen. Nun teilt die Bahn mit: Der erste Einsatz für den Zug mit dem stufenlosen Einstieg naht.
Eigentlich sollte der ICE L längst deutsche Schienen befahren. Dann kamen Lieferschwierigkeiten und Testverzögerungen. Nun teilt die Bahn mit: Der erste Einsatz für den Zug mit dem stufenlosen Einstieg naht.
 Der Schiffsverkehr zwischen den Kanarischen Inseln gefährdet die dort lebenden Wale. Zwar sinkt die Zahl der Todesfälle, doch laut Experten liegt das an der mittlerweile geringen Zahl noch lebender Tiere.
Der Schiffsverkehr zwischen den Kanarischen Inseln gefährdet die dort lebenden Wale. Zwar sinkt die Zahl der Todesfälle, doch laut Experten liegt das an der mittlerweile geringen Zahl noch lebender Tiere.
 Sternschnuppen sind beliebte Himmelsphänomene. In Sommernächten sind besonders viele zu sehen. Doch in diesem Jahr könnte der Mond den Himmelsguckern einen Strich durch die Rechnung machen.
Sternschnuppen sind beliebte Himmelsphänomene. In Sommernächten sind besonders viele zu sehen. Doch in diesem Jahr könnte der Mond den Himmelsguckern einen Strich durch die Rechnung machen.
 Eigentlich ist es nur eine Randnotiz, dass AOL ab Ende September keine Internetverbindungen mehr über das analoge Telefonnetz per Modem und ISDN zur Verfügung stellt. Viele erinnern sich aber noch an die legendären Geräusche bei der Einwahl, andere möchten vielleicht wissen, was das überhaupt war.
Eigentlich ist es nur eine Randnotiz, dass AOL ab Ende September keine Internetverbindungen mehr über das analoge Telefonnetz per Modem und ISDN zur Verfügung stellt. Viele erinnern sich aber noch an die legendären Geräusche bei der Einwahl, andere möchten vielleicht wissen, was das überhaupt war.
 Ein schmelzender Gletscher sorgt für eine Sensation in der Polarforschung: Ein polnisches Team entdeckt in der Antarktis menschliche Knochen. Ein DNA-Test zeigt: Es sind die Überreste eines schon lange verschwundenen britischen Forschers. Seine Familie ist begeistert.
Ein schmelzender Gletscher sorgt für eine Sensation in der Polarforschung: Ein polnisches Team entdeckt in der Antarktis menschliche Knochen. Ein DNA-Test zeigt: Es sind die Überreste eines schon lange verschwundenen britischen Forschers. Seine Familie ist begeistert.
 Eine Studie enthüllt regelmäßige Begegnungen im Ozean zwischen Walen und Delfinen. Zwei der faszinierendsten Meeresbewohner spielen sogar miteinander. Doch die Aufeinandertreffen sind nicht immer harmonisch.
Eine Studie enthüllt regelmäßige Begegnungen im Ozean zwischen Walen und Delfinen. Zwei der faszinierendsten Meeresbewohner spielen sogar miteinander. Doch die Aufeinandertreffen sind nicht immer harmonisch.
 Gaming ist mehr als nur ein Hobby. Fast die Hälfte der deutschen Gamer kann sich ein Leben ohne Zocken nicht mehr vorstellen. Jeder Fünfte hat sogar schon von Games geträumt.
Gaming ist mehr als nur ein Hobby. Fast die Hälfte der deutschen Gamer kann sich ein Leben ohne Zocken nicht mehr vorstellen. Jeder Fünfte hat sogar schon von Games geträumt.
 An heißen Tagen sorgen sie für Wohlfühltemperaturen - doch schlecht gewartete Klimaanlagen können der Gesundheit schaden. Experten warnen vor Bakterien, Pilzen und Viren, die schwere Krankheiten auslösen können. Besonders gefährdet sind Büroangestellte und immungeschwächte Personen.
An heißen Tagen sorgen sie für Wohlfühltemperaturen - doch schlecht gewartete Klimaanlagen können der Gesundheit schaden. Experten warnen vor Bakterien, Pilzen und Viren, die schwere Krankheiten auslösen können. Besonders gefährdet sind Büroangestellte und immungeschwächte Personen.
 Wie groß ist das Risiko, dass ein Asteroid die Erde trifft? Um das zu veranschaulichen, haben Forscher Autounfälle oder Wildtierangriffe zum Vergleich herangezogen. Manches Ergebnis überrascht.
Wie groß ist das Risiko, dass ein Asteroid die Erde trifft? Um das zu veranschaulichen, haben Forscher Autounfälle oder Wildtierangriffe zum Vergleich herangezogen. Manches Ergebnis überrascht.
 Um ein Viertel bis ein Drittel sind die Bestände tropischer Vögel seit Mitte des vergangenen Jahrhunderts zurückgegangen. Forscher warnen, dass der Schutz der Lebensräume allein nicht ausreicht.
Um ein Viertel bis ein Drittel sind die Bestände tropischer Vögel seit Mitte des vergangenen Jahrhunderts zurückgegangen. Forscher warnen, dass der Schutz der Lebensräume allein nicht ausreicht.
 Morgens sind derzeit zwei Lichter am Himmel zu sehen. Dies führt zu vielen aufgeregten Nachfragen bei einer Meldestelle. Einige Theorien, um was es sich bei der Erscheinung handeln könnte, kommen auf. Doch die Erklärung ist einfach.
Morgens sind derzeit zwei Lichter am Himmel zu sehen. Dies führt zu vielen aufgeregten Nachfragen bei einer Meldestelle. Einige Theorien, um was es sich bei der Erscheinung handeln könnte, kommen auf. Doch die Erklärung ist einfach.
 An der deutsch-tschechischen Grenze kommt es immer wieder zu Serien von Mikrobeben. Noch haben Fachleute nur eine Vermutung, was die Erschütterungen auslöst. Aufwendige Messungen sollen Klarheit bringen.
An der deutsch-tschechischen Grenze kommt es immer wieder zu Serien von Mikrobeben. Noch haben Fachleute nur eine Vermutung, was die Erschütterungen auslöst. Aufwendige Messungen sollen Klarheit bringen.
 Forscher des Bonner Max-Planck-Instituts haben den Plasmastrahl eines weit entfernten Galaxienkerns in bislang beispielloser Schärfe aufgenommen. Das Bild erinnert die Wissenschaftler an die finstere Macht aus "Der Herr der Ringe".
Forscher des Bonner Max-Planck-Instituts haben den Plasmastrahl eines weit entfernten Galaxienkerns in bislang beispielloser Schärfe aufgenommen. Das Bild erinnert die Wissenschaftler an die finstere Macht aus "Der Herr der Ringe".
 Astronomen haben das Bild eines direkt auf die Erde gerichteten kosmischen Jets aufgenommen – und darin das »Auge von Sauron« erkannt. Der unwissenschaftliche Begriff setzte sich auch im entsprechenden Fachartikel durch.
Astronomen haben das Bild eines direkt auf die Erde gerichteten kosmischen Jets aufgenommen – und darin das »Auge von Sauron« erkannt. Der unwissenschaftliche Begriff setzte sich auch im entsprechenden Fachartikel durch.
 Die italienische Polizei hatte im Mai einen Mann festgenommen, der Wohnungssuchende in München abgezockt haben soll. Als deutsche Beamte ihn übernehmen wollten, erlebten sie eine Überraschung.
Die italienische Polizei hatte im Mai einen Mann festgenommen, der Wohnungssuchende in München abgezockt haben soll. Als deutsche Beamte ihn übernehmen wollten, erlebten sie eine Überraschung.
 Was passiert, falls die USA wichtige medizinische Tools für Forscher und Ärzte abschalten sollten? »Für den Fall der Fälle« haben Fachleute in Deutschland nun Alternativen zusammengestellt.
Was passiert, falls die USA wichtige medizinische Tools für Forscher und Ärzte abschalten sollten? »Für den Fall der Fälle« haben Fachleute in Deutschland nun Alternativen zusammengestellt.
 Die Welt ist für Rechtshänder ausgerichtet. Dabei sind etwas mehr als zehn Prozent der Menschen Linkshänder. Für diese gibt es eine Vielzahl von Zuweisungen. Sie reichen von ungeschickt, über sportlicher bis zu kreativer. Welche davon stimmen, zeigt ntv.de.
Die Welt ist für Rechtshänder ausgerichtet. Dabei sind etwas mehr als zehn Prozent der Menschen Linkshänder. Für diese gibt es eine Vielzahl von Zuweisungen. Sie reichen von ungeschickt, über sportlicher bis zu kreativer. Welche davon stimmen, zeigt ntv.de.
 GPT-5 kann keine Deutschlandkarte erstellen. Ist das globale Feuerwerk der KI-Lostheit ein Versagen oder der kluge Weg, die neue ChatGPT-Version besser zu machen?
GPT-5 kann keine Deutschlandkarte erstellen. Ist das globale Feuerwerk der KI-Lostheit ein Versagen oder der kluge Weg, die neue ChatGPT-Version besser zu machen?
 Absurde Steuerklassen, fehlende Kitaplätze und viel Bürokratie: Der deutsche Arbeitsmarkt ist ein Flickenteppich aus veralteten Strukturen. Einziger Lichtblick: Als Homeofficeland steht Deutschland gut da.
Absurde Steuerklassen, fehlende Kitaplätze und viel Bürokratie: Der deutsche Arbeitsmarkt ist ein Flickenteppich aus veralteten Strukturen. Einziger Lichtblick: Als Homeofficeland steht Deutschland gut da.
 Ein Moment der Unachtsamkeit, der ein Leben kostet. Immer wieder sterben Kinder, die im Auto vergessen werden. Aber warum passiert das überhaupt? Die Forschung gibt Antworten.
Ein Moment der Unachtsamkeit, der ein Leben kostet. Immer wieder sterben Kinder, die im Auto vergessen werden. Aber warum passiert das überhaupt? Die Forschung gibt Antworten.
 Seit 1985 verschwanden im Amazonas Naturflächen, die größer als Spanien sind. Eine neue Analyse zeigt: Auch landesweit hat Brasilien massive Verluste zu verzeichnen.
Seit 1985 verschwanden im Amazonas Naturflächen, die größer als Spanien sind. Eine neue Analyse zeigt: Auch landesweit hat Brasilien massive Verluste zu verzeichnen.
 Schon jetzt macht der Klimawandel Rentieren weltweit zu schaffen. Forschende warnen nun in einer Studie vor noch gravierenderen Folgen für den Rentierbestand auf der ganzen Welt.
Schon jetzt macht der Klimawandel Rentieren weltweit zu schaffen. Forschende warnen nun in einer Studie vor noch gravierenderen Folgen für den Rentierbestand auf der ganzen Welt.
 Milliarden Tonnen Plastik verschmutzen unseren Planeten. Mit einem Abkommen wollen die Vereinten Nationen die Lage verbessern. Doch kurz vor Ende der Verhandlungen drohen angestrebte Ziele gestrichen zu werden.
Milliarden Tonnen Plastik verschmutzen unseren Planeten. Mit einem Abkommen wollen die Vereinten Nationen die Lage verbessern. Doch kurz vor Ende der Verhandlungen drohen angestrebte Ziele gestrichen zu werden.
 Helgoland war einst ein britischer Militärstützpunkt. In den Gewässern der Nordsee finden sich Tonnen an Munition und Militärgerät. Nun entdecken Taucher historische Kanonen - von der vor der Insel gesunkenen "HMS Explosion" stammen sie aber nicht.
Helgoland war einst ein britischer Militärstützpunkt. In den Gewässern der Nordsee finden sich Tonnen an Munition und Militärgerät. Nun entdecken Taucher historische Kanonen - von der vor der Insel gesunkenen "HMS Explosion" stammen sie aber nicht.
 KI-Agenten sollen die App-Nutzung bei den Smartphones vereinfachen. Auch Samsung und Apple setzen auf die Technik. Der deutsche Kommunikationsriese Telekom bringt nach der Vorstellung im März nun ein KI-Phone ohne sichtbare Apps in die Läden. Und das deutlich günstiger als die Konkurrenz.
KI-Agenten sollen die App-Nutzung bei den Smartphones vereinfachen. Auch Samsung und Apple setzen auf die Technik. Der deutsche Kommunikationsriese Telekom bringt nach der Vorstellung im März nun ein KI-Phone ohne sichtbare Apps in die Läden. Und das deutlich günstiger als die Konkurrenz.
 Die Struktur einer Stadt hängt direkt mit der Anzahl der Schritte zusammen, die ihre Bewohner und Bewohnerinnen machen. Das haben Forschende jetzt herausgefunden. Sie verraten auch gleich noch den Namen der "gehfreundlichsten Stadt" in den USA.
Die Struktur einer Stadt hängt direkt mit der Anzahl der Schritte zusammen, die ihre Bewohner und Bewohnerinnen machen. Das haben Forschende jetzt herausgefunden. Sie verraten auch gleich noch den Namen der "gehfreundlichsten Stadt" in den USA.
 Die DNA ist weiblich, die Fortpflanzungsorgane männlich: Bei einer ganzen Reihe von Vögeln sind genetisches und physisches Geschlecht nicht gleich. Forschende stehen vor einem Rätsel.
Die DNA ist weiblich, die Fortpflanzungsorgane männlich: Bei einer ganzen Reihe von Vögeln sind genetisches und physisches Geschlecht nicht gleich. Forschende stehen vor einem Rätsel.
 Die Sorgen hinsichtlich der Wirkmacht von künstlicher Intelligenz sind ohnehin vorhanden. Ein Bericht zum Handbuch für den KI-Chatbot von Meta dürfte sie befeuern. Demnach durfte er Kindern Komplimente zu ihrem Körper machen. Auch Gewalt und Fakenews waren in Ordnung.
Die Sorgen hinsichtlich der Wirkmacht von künstlicher Intelligenz sind ohnehin vorhanden. Ein Bericht zum Handbuch für den KI-Chatbot von Meta dürfte sie befeuern. Demnach durfte er Kindern Komplimente zu ihrem Körper machen. Auch Gewalt und Fakenews waren in Ordnung.
 Im mexikanischen Yucatán wachsen in Höhlen uralte Tropfsteingebilde. Einige davon werden genauer unter die wissenschaftliche Lupe genommen. Aus den Ergebnissen lassen sich die Gründe für den Untergang der Maya ablesen.
Im mexikanischen Yucatán wachsen in Höhlen uralte Tropfsteingebilde. Einige davon werden genauer unter die wissenschaftliche Lupe genommen. Aus den Ergebnissen lassen sich die Gründe für den Untergang der Maya ablesen.
 Welche Auswirkungen die voranschreitende Erderwärmung auf den Bestand der Rentiere hat, berechnet ein Forschungsteam - und gibt eine klare und erschreckende Prognose ab.
Welche Auswirkungen die voranschreitende Erderwärmung auf den Bestand der Rentiere hat, berechnet ein Forschungsteam - und gibt eine klare und erschreckende Prognose ab.
 Plastikabfall vermüllt die Welt. Drei Jahre haben 180 Länder versucht eine Lösung für das Problem zu finden. Selbst ein Vertragsentwurf fast ohne bindende Verpflichtungen wurde von Dutzenden Ländern zurückgewiesen.
Plastikabfall vermüllt die Welt. Drei Jahre haben 180 Länder versucht eine Lösung für das Problem zu finden. Selbst ein Vertragsentwurf fast ohne bindende Verpflichtungen wurde von Dutzenden Ländern zurückgewiesen.
 Kurz vor Wladimir Putins Treffen mit US-Präsident Donald Trump berichten russische Nutzer von Störungen bei WhatsApp und Telegram. Die Meta-Tochter wirft Russland vor, den Zugang zu sicherer Kommunikation zu verwehren.
Kurz vor Wladimir Putins Treffen mit US-Präsident Donald Trump berichten russische Nutzer von Störungen bei WhatsApp und Telegram. Die Meta-Tochter wirft Russland vor, den Zugang zu sicherer Kommunikation zu verwehren.
 Plastikabfall vermüllt die Welt. Drei Jahre haben 180 Länder versucht, eine Lösung für das Problem zu finden. Selbst ein Vertragsentwurf fast ohne bindende Verpflichtungen wurde von Dutzenden Ländern zurückgewiesen.
Plastikabfall vermüllt die Welt. Drei Jahre haben 180 Länder versucht, eine Lösung für das Problem zu finden. Selbst ein Vertragsentwurf fast ohne bindende Verpflichtungen wurde von Dutzenden Ländern zurückgewiesen.
 Seit Jahrzehnten sterben die Gletscher. Wissenschaftler des Alfred-Wegner-Instituts schauen sich diese Vorgänge bei dem 79°N-Gletscher an und erklären, wie die meterlangen Risse im Eis entstehen und was sie anrichten.
Seit Jahrzehnten sterben die Gletscher. Wissenschaftler des Alfred-Wegner-Instituts schauen sich diese Vorgänge bei dem 79°N-Gletscher an und erklären, wie die meterlangen Risse im Eis entstehen und was sie anrichten.
 Mindestens 40 Menschen sind im Sudan binnen einer Woche an Cholera gestorben. Besonders schlimm ist die Situation in der Region Darfur. Viele Geflüchtete müssen mit drei Litern Wasser pro Tag auskommen.
Mindestens 40 Menschen sind im Sudan binnen einer Woche an Cholera gestorben. Besonders schlimm ist die Situation in der Region Darfur. Viele Geflüchtete müssen mit drei Litern Wasser pro Tag auskommen.
 Das Mittelmeer ist in diesem Sommer ungewöhnlich warm. Die Folgen für Pflanzen und Tiere sind dramatisch. Wissenschaftler haben nun zwei wesentliche Faktoren ergründet, die das Wasser aufheizen.
Das Mittelmeer ist in diesem Sommer ungewöhnlich warm. Die Folgen für Pflanzen und Tiere sind dramatisch. Wissenschaftler haben nun zwei wesentliche Faktoren ergründet, die das Wasser aufheizen.
 Nach rund zwei Jahren zieht Spotify erneut die Preise für seine Abos an. Gleichzeitig soll eine neue Sparvariante kommen. Die ist allerdings nur für bestimmte Kunden buchbar.
Nach rund zwei Jahren zieht Spotify erneut die Preise für seine Abos an. Gleichzeitig soll eine neue Sparvariante kommen. Die ist allerdings nur für bestimmte Kunden buchbar.
 Über ein spezielles Implantat konnten US-Wissenschaftler das innere Gespräch von Versuchspersonen teilweise mithören – wenn die zuvor »chitty chitty bang bang« dachten. Noch ist die Fehlerrate allerdings hoch.
Über ein spezielles Implantat konnten US-Wissenschaftler das innere Gespräch von Versuchspersonen teilweise mithören – wenn die zuvor »chitty chitty bang bang« dachten. Noch ist die Fehlerrate allerdings hoch.
 Noch immer wird unter Fachleuten über die Existenz von Kugelblitzen gestritten. Ein Astrophysiker ist seit seiner Kindheit fasziniert von ihnen und versucht, einen wissenschaftlich haltbaren Beleg für das seltene Naturphänomen zu finden.
Noch immer wird unter Fachleuten über die Existenz von Kugelblitzen gestritten. Ein Astrophysiker ist seit seiner Kindheit fasziniert von ihnen und versucht, einen wissenschaftlich haltbaren Beleg für das seltene Naturphänomen zu finden.
 Jeder vierte Deutsche ist tätowiert. Doch die gesundheitlichen Gefahren sind kaum erforscht. Eine neue Studie soll das Krebsrisiko durch die Farben berechnen.
Jeder vierte Deutsche ist tätowiert. Doch die gesundheitlichen Gefahren sind kaum erforscht. Eine neue Studie soll das Krebsrisiko durch die Farben berechnen.
 Endlich ist es mehr als eine gefühlte Wahrheit: Eine Studie der Universitäten Warwick und Bielefeld zeigt, dass koffeinhaltige Getränke die Stimmung heben. Doch ein allgemeiner Glücklichmacher ist Kaffee damit nicht.
Endlich ist es mehr als eine gefühlte Wahrheit: Eine Studie der Universitäten Warwick und Bielefeld zeigt, dass koffeinhaltige Getränke die Stimmung heben. Doch ein allgemeiner Glücklichmacher ist Kaffee damit nicht.
 Schluss mit Brumm, Pfeif, Tüüt. Nach 34 Jahren streicht der Onlinedienst AOL die Möglichkeit, sich per Modem ins Internet einzuwählen. Erstaunlicher als die Ankündigung ist, dass es diese Option überhaupt noch gab.
Schluss mit Brumm, Pfeif, Tüüt. Nach 34 Jahren streicht der Onlinedienst AOL die Möglichkeit, sich per Modem ins Internet einzuwählen. Erstaunlicher als die Ankündigung ist, dass es diese Option überhaupt noch gab.
 Ob Thüringer oder Nürnberger: Bratwürste gehören in Deutschland zu jedem Volksfest dazu. Doch wo gingen die Würste erstmals über den Tresen? Ein zufällig entdecktes Schriftstück könnte die Antwort liefern.
Ob Thüringer oder Nürnberger: Bratwürste gehören in Deutschland zu jedem Volksfest dazu. Doch wo gingen die Würste erstmals über den Tresen? Ein zufällig entdecktes Schriftstück könnte die Antwort liefern.
 Unter dem Sammelbegriff "Sleepmaxxing" (in etwa: den Schlaf optimieren) schüren Influencer die Hoffnung auf erholsamere Nächte. Die vermeintlichen Wundermittel, die auf Tiktok die Runde machen, bergen Risiken.
Unter dem Sammelbegriff "Sleepmaxxing" (in etwa: den Schlaf optimieren) schüren Influencer die Hoffnung auf erholsamere Nächte. Die vermeintlichen Wundermittel, die auf Tiktok die Runde machen, bergen Risiken.
 Leben entsteht aus Wasser. Doch jetzt finden Forschende bei Experimenten im Labor eine Alternative. Worum es dabei geht und welche Himmelskörper die passenden Voraussetzungen außerhalb der Erde mitbringen, zählt ein Forschungsteam auf.
Leben entsteht aus Wasser. Doch jetzt finden Forschende bei Experimenten im Labor eine Alternative. Worum es dabei geht und welche Himmelskörper die passenden Voraussetzungen außerhalb der Erde mitbringen, zählt ein Forschungsteam auf.
 Für kleines Geld kaufte der US-Amerikaner Justus Reid eine Bruchbude im Wald. Nun helfen ihm Wildfremde beim Renovieren. Hier spricht er über seinen Internetruhm und das Geheimnis um den Standort.
Für kleines Geld kaufte der US-Amerikaner Justus Reid eine Bruchbude im Wald. Nun helfen ihm Wildfremde beim Renovieren. Hier spricht er über seinen Internetruhm und das Geheimnis um den Standort.
 Thorsten Müller hat einen KI-Sprachassistenten mit seiner eigenen Stimme gebaut. Er will den Angeboten großer Techkonzerne etwas entgegensetzen. Doch sein Projekt hat Risiken und gegen die Nebenwirkungen kann er wenig tun.
Thorsten Müller hat einen KI-Sprachassistenten mit seiner eigenen Stimme gebaut. Er will den Angeboten großer Techkonzerne etwas entgegensetzen. Doch sein Projekt hat Risiken und gegen die Nebenwirkungen kann er wenig tun.
 Die private Haltung von Honigbienen boomt in Deutschland. Doch ist das auch ein Beitrag zum Naturschutz, wie so mancher denkt? Der Naturschutzbund Nabu warnt, der Deutsche Imkerbund sieht das etwas anders.
Die private Haltung von Honigbienen boomt in Deutschland. Doch ist das auch ein Beitrag zum Naturschutz, wie so mancher denkt? Der Naturschutzbund Nabu warnt, der Deutsche Imkerbund sieht das etwas anders.
 Auch wenn vegane Produkte den Markt erobern: Tatsächlich vegan ernähren sich nur wenige Deutsche, wie eine Studie zeigt. Und der Großteil der Befragten missachtet einen wichtigen Ernährungstipp.
Auch wenn vegane Produkte den Markt erobern: Tatsächlich vegan ernähren sich nur wenige Deutsche, wie eine Studie zeigt. Und der Großteil der Befragten missachtet einen wichtigen Ernährungstipp.
 Turbulenzen können Flugpassagiere in Angst und Schrecken versetzen. Der SPIEGEL zeigt, wo das Risiko am größten ist und wie Sie die Achterbahnfahrt in der Luft unbeschadet überstehen.
Turbulenzen können Flugpassagiere in Angst und Schrecken versetzen. Der SPIEGEL zeigt, wo das Risiko am größten ist und wie Sie die Achterbahnfahrt in der Luft unbeschadet überstehen.
 Sobald es heiß wird, mehren sich Berichte über Gewalt in Parks und Schwimmbädern. Macht Hitze aggressiv? Wie sich hohe Temperaturen auf die Psyche auswirken und wie wir damit umgehen sollten, erklärt ein Experte ntv.de.
Sobald es heiß wird, mehren sich Berichte über Gewalt in Parks und Schwimmbädern. Macht Hitze aggressiv? Wie sich hohe Temperaturen auf die Psyche auswirken und wie wir damit umgehen sollten, erklärt ein Experte ntv.de.
 Gaming ist mehr als nur ein Hobby. Fast die Hälfte der deutschen Gamer kann sich ein Leben ohne Zocken nicht mehr vorstellen. Jeder Fünfte hat sogar schon von Games geträumt.
Gaming ist mehr als nur ein Hobby. Fast die Hälfte der deutschen Gamer kann sich ein Leben ohne Zocken nicht mehr vorstellen. Jeder Fünfte hat sogar schon von Games geträumt.
 Die Zahl der Fruchtbarkeitsbehandlungen in Deutschland steigt, während die Spermienqualität sinkt. Eine Urologie-Professorin erklärt, für wen »Social Freezing« – das Einfrieren von Spermien – eine Lösung sein könnte.
Die Zahl der Fruchtbarkeitsbehandlungen in Deutschland steigt, während die Spermienqualität sinkt. Eine Urologie-Professorin erklärt, für wen »Social Freezing« – das Einfrieren von Spermien – eine Lösung sein könnte.
 1943 stürzt ein britisches Kampfflugzeug des Typs "Short Stirling" in Nordrhein-Westfalen ab. Vier Besatzungsmitglieder werden noch immer vermisst. In der Nähe des Braunkohletagebaus Hambach stoßen Archäologen nun auf Maschinenteile und menschliche Überreste.
1943 stürzt ein britisches Kampfflugzeug des Typs "Short Stirling" in Nordrhein-Westfalen ab. Vier Besatzungsmitglieder werden noch immer vermisst. In der Nähe des Braunkohletagebaus Hambach stoßen Archäologen nun auf Maschinenteile und menschliche Überreste.
 Gletscher schmelzen, Wälder leiden unter Schädlingen und Flüsse trocknen aus: Die Klimakrise hinterlässt in vielen Teilen Deutschlands ihre Spuren. Fotos aus den vergangenen Jahren zeigen das Ausmaß der Zerstörung.
Gletscher schmelzen, Wälder leiden unter Schädlingen und Flüsse trocknen aus: Die Klimakrise hinterlässt in vielen Teilen Deutschlands ihre Spuren. Fotos aus den vergangenen Jahren zeigen das Ausmaß der Zerstörung.
 Ein internationales Team rekonstruiert die Entstehung des Mittelmeers: Die Öffnung der Straße von Gibraltar löst vor 5,3 Millionen Jahren die abrupteste Überflutung der Erdgeschichte aus. Die neuen Analysen offenbaren die gewaltigen Dimensionen dieser Urflut.
Ein internationales Team rekonstruiert die Entstehung des Mittelmeers: Die Öffnung der Straße von Gibraltar löst vor 5,3 Millionen Jahren die abrupteste Überflutung der Erdgeschichte aus. Die neuen Analysen offenbaren die gewaltigen Dimensionen dieser Urflut.
 Auf die US-Lebensversicherungstochter der Allianz war im Juli ein schwerer Hackerangriff verübt worden. Einem Medienbericht zufolge könnten Daten eines Großteils der rund 1,4 Millionen Kunden der Firma erbeutet worden sein.
Auf die US-Lebensversicherungstochter der Allianz war im Juli ein schwerer Hackerangriff verübt worden. Einem Medienbericht zufolge könnten Daten eines Großteils der rund 1,4 Millionen Kunden der Firma erbeutet worden sein.
 Gletscher schmelzen nicht nur in den Alpen, auch im entfernten Norden verlieren sie Eis - 2024 in Rekordhöhe. In Spitzbergen gehen dem Gletscher Wissenschaftlern zufolge mehr als 60 Gigatonnen verloren. Die Auswirkungen auf den Meeresspiegel sind immens.
Gletscher schmelzen nicht nur in den Alpen, auch im entfernten Norden verlieren sie Eis - 2024 in Rekordhöhe. In Spitzbergen gehen dem Gletscher Wissenschaftlern zufolge mehr als 60 Gigatonnen verloren. Die Auswirkungen auf den Meeresspiegel sind immens.
 Infektionen mit Vibrionen sind zwar selten, aber aggressiv. Klimawandel und Überdüngung befördern das explosive Wachstum der gefährlichen Keime.
Infektionen mit Vibrionen sind zwar selten, aber aggressiv. Klimawandel und Überdüngung befördern das explosive Wachstum der gefährlichen Keime.
 Eigentlich wollen japanische Wissenschaftler herausfinden, wie bestimmte Seevögel von der Wasseroberfläche abheben. Dafür bringen sie Mini-Kameras an den Tieren an. Doch nach der Auswertung der Bilder schwenken sie thematisch zu einem spannenderen Thema um.
Eigentlich wollen japanische Wissenschaftler herausfinden, wie bestimmte Seevögel von der Wasseroberfläche abheben. Dafür bringen sie Mini-Kameras an den Tieren an. Doch nach der Auswertung der Bilder schwenken sie thematisch zu einem spannenderen Thema um.
 Forschende der Universität Oslo haben den Eis-Verlust der Gletscher in Spitzbergen nördlich von Norwegen berechnet. Der übertrifft laut den Wissenschaftlern alle bisherigen Befürchtungen. Und wird Folgen haben.
Forschende der Universität Oslo haben den Eis-Verlust der Gletscher in Spitzbergen nördlich von Norwegen berechnet. Der übertrifft laut den Wissenschaftlern alle bisherigen Befürchtungen. Und wird Folgen haben.
 Große Sprengkraft, hohe Reichweite: Der Marschflugkörper »Flamingo« geht offenbar in Serie. Experten spekulieren bereits, wo ihn die Ukraine im Abwehrkampf gegen Russland einsetzen könnte.
Große Sprengkraft, hohe Reichweite: Der Marschflugkörper »Flamingo« geht offenbar in Serie. Experten spekulieren bereits, wo ihn die Ukraine im Abwehrkampf gegen Russland einsetzen könnte.
 Forschende der Universität Oslo haben den Eisverlust der Gletscher in Spitzbergen nördlich von Norwegen berechnet. Der übertrifft laut den Wissenschaftlern alle bisherigen Befürchtungen. Und wird Folgen haben.
Forschende der Universität Oslo haben den Eisverlust der Gletscher in Spitzbergen nördlich von Norwegen berechnet. Der übertrifft laut den Wissenschaftlern alle bisherigen Befürchtungen. Und wird Folgen haben.
 Ob Knie-Spritzen oder Stoßwellentherapie – viele Selbstzahlerleistungen halten nicht, was sie versprechen. Statt Linderung drohen Schäden, wie der Medizinische Dienst Bund betont. Von 60 geprüften Angeboten fallen die meisten durch.
Ob Knie-Spritzen oder Stoßwellentherapie – viele Selbstzahlerleistungen halten nicht, was sie versprechen. Statt Linderung drohen Schäden, wie der Medizinische Dienst Bund betont. Von 60 geprüften Angeboten fallen die meisten durch.
 Zu einem Preis wie beim Discounter will ein Krimineller Zugangsdaten zu 15,8 Millionen PayPal-Konten verkaufen. Ob die Daten echt sind, ist unklar. Dennoch sollten sich PayPal-User schützen. Wir sagen, wie.
Zu einem Preis wie beim Discounter will ein Krimineller Zugangsdaten zu 15,8 Millionen PayPal-Konten verkaufen. Ob die Daten echt sind, ist unklar. Dennoch sollten sich PayPal-User schützen. Wir sagen, wie.
 In Köln startet diesen Mittwoch die weltgrößte Spielemesse. Präsentiert werden Hunderte neue Games, doch die glitzernde Fassade täuscht: Viele Spielestudios stehen massiv unter Druck.
In Köln startet diesen Mittwoch die weltgrößte Spielemesse. Präsentiert werden Hunderte neue Games, doch die glitzernde Fassade täuscht: Viele Spielestudios stehen massiv unter Druck.
 Zahnschmelz ist die härteste Substanz im menschlichen Körper. Ist er erst einmal abgenutzt oder schadhaft, bleibt der Zahn schutzlos. Doch eine Neuentdeckung könnte das ändern.
Zahnschmelz ist die härteste Substanz im menschlichen Körper. Ist er erst einmal abgenutzt oder schadhaft, bleibt der Zahn schutzlos. Doch eine Neuentdeckung könnte das ändern.
 In welcher Beziehung manche Vor- und Frühmenschenarten zueinander standen, ist nicht vollständig geklärt. Forschungen zeigen nun, dass die Gattungen Homo und Australopithecus möglicherweise koexistierten.
In welcher Beziehung manche Vor- und Frühmenschenarten zueinander standen, ist nicht vollständig geklärt. Forschungen zeigen nun, dass die Gattungen Homo und Australopithecus möglicherweise koexistierten.
 Helgoland war einst ein britischer Militärstützpunkt. In den Gewässern der Nordsee finden sich Tonnen an Munition und Militärgerät. Nun entdecken Taucher historische Kanonen - von der vor der Insel gesunkenen "HMS Explosion" stammen sie aber nicht.
Helgoland war einst ein britischer Militärstützpunkt. In den Gewässern der Nordsee finden sich Tonnen an Munition und Militärgerät. Nun entdecken Taucher historische Kanonen - von der vor der Insel gesunkenen "HMS Explosion" stammen sie aber nicht.
 Donald Trump hat wiederholt mit dem Ende von TikTok in den USA gedroht. Dann räumte er dem chinesischen Mutterkonzern Bytedance eine Gnadenfrist ein, die er mehrfach verlängerte. Jetzt hat seine Regierungszentrale einen eigenen Account.
Donald Trump hat wiederholt mit dem Ende von TikTok in den USA gedroht. Dann räumte er dem chinesischen Mutterkonzern Bytedance eine Gnadenfrist ein, die er mehrfach verlängerte. Jetzt hat seine Regierungszentrale einen eigenen Account.
 Der Stromanbieter Tepco bereitet die Bergung verstrahlter Trümmer aus den Reaktoren des Atomkraftwerks vor. 880 Tonnen Atommüll lagern dort noch. Doch das Vorhaben wird noch viele Jahre in Anspruch nehmen.
Der Stromanbieter Tepco bereitet die Bergung verstrahlter Trümmer aus den Reaktoren des Atomkraftwerks vor. 880 Tonnen Atommüll lagern dort noch. Doch das Vorhaben wird noch viele Jahre in Anspruch nehmen.
 Der Planet Uranus hat sehr viele Monde - bisher kannte man 28. Nun wird noch einer bei dem Eisriesen erspäht. Der blieb aus einem bestimmten Grund bisher verborgen. Und er ist zwar ein Mini-Mond, aber bedeutend, seine Entdeckung "erweitert unsere Sicht auf Uranus und sein rätselhaftes Mondsystem".
Der Planet Uranus hat sehr viele Monde - bisher kannte man 28. Nun wird noch einer bei dem Eisriesen erspäht. Der blieb aus einem bestimmten Grund bisher verborgen. Und er ist zwar ein Mini-Mond, aber bedeutend, seine Entdeckung "erweitert unsere Sicht auf Uranus und sein rätselhaftes Mondsystem".
 Die Ukraine will in Zukunft sicher vor russischen Angriffen sein. Eine Nato-Mitgliedschaft scheint ungewiss. Könnte das Land eine eigene Atombombe bauen? Ein Experte hat in einer Analyse durchgespielt, ob das machbar wäre - und welche Folgen es hätte.
Die Ukraine will in Zukunft sicher vor russischen Angriffen sein. Eine Nato-Mitgliedschaft scheint ungewiss. Könnte das Land eine eigene Atombombe bauen? Ein Experte hat in einer Analyse durchgespielt, ob das machbar wäre - und welche Folgen es hätte.
 Wissenschaftler haben eine Fledermausfamilie in Costa Rica per Videokamera beobachtet. Die Tiere wiesen ein reges Sozialverhalten auf, inklusive Begrüßungsritual.
Wissenschaftler haben eine Fledermausfamilie in Costa Rica per Videokamera beobachtet. Die Tiere wiesen ein reges Sozialverhalten auf, inklusive Begrüßungsritual.
 Ein neues Computerspiel soll Jugendliche für die Gefahren des Islamismus sensibilisieren. Es zeigt, wie sich ein Jugendlicher radikalisiert und wie man reagieren kann. Auch der Verfassungsschutz ist an dem Projekt beteiligt.
Ein neues Computerspiel soll Jugendliche für die Gefahren des Islamismus sensibilisieren. Es zeigt, wie sich ein Jugendlicher radikalisiert und wie man reagieren kann. Auch der Verfassungsschutz ist an dem Projekt beteiligt.
 Bienen ernähren sich von Pollen, die in der Natur immer seltener vorkommen. Nun ist es Forschenden gelungen, ein angereichertes Nahrungsergänzungsmittel herzustellen, das künftig als Ersatz dienen könnte.
Bienen ernähren sich von Pollen, die in der Natur immer seltener vorkommen. Nun ist es Forschenden gelungen, ein angereichertes Nahrungsergänzungsmittel herzustellen, das künftig als Ersatz dienen könnte.
 Die Kritik an künstlicher Intelligenz folgt einem Tausende Jahre alten Muster. Wie man sie durchschaut und was es über die Zukunftsfähigkeit unserer Gesellschaft aussagt.
Die Kritik an künstlicher Intelligenz folgt einem Tausende Jahre alten Muster. Wie man sie durchschaut und was es über die Zukunftsfähigkeit unserer Gesellschaft aussagt.
 Die neuen Pixel-Smartphones haben mehr Leistung und mehr KI, vor allem aber ein paar nützliche Magnete. Das Display der neuen Smartwatch verbiegt sich, und die neuen Pixelbuds sollen die Ohren schützen.
Die neuen Pixel-Smartphones haben mehr Leistung und mehr KI, vor allem aber ein paar nützliche Magnete. Das Display der neuen Smartwatch verbiegt sich, und die neuen Pixelbuds sollen die Ohren schützen.
 Der französische Streamer Raphaël Graven wurde mit Gewaltvideos im Netz bekannt. Am Montag starb er während eines Livestreams. Die Staatsanwaltschaft untersucht den Fall.
Der französische Streamer Raphaël Graven wurde mit Gewaltvideos im Netz bekannt. Am Montag starb er während eines Livestreams. Die Staatsanwaltschaft untersucht den Fall.
 Musik löst mitunter starke Emotionen aus - und kann Erinnerungen wecken. Eine Studie findet heraus, welche Art von Songs man hören muss, um Erinnerungen voller Freude, Aufregung und Vergnügen hervorzurufen. Die Erkenntnis könnte bei der Alzheimer-Therapie nützlich sein.
Musik löst mitunter starke Emotionen aus - und kann Erinnerungen wecken. Eine Studie findet heraus, welche Art von Songs man hören muss, um Erinnerungen voller Freude, Aufregung und Vergnügen hervorzurufen. Die Erkenntnis könnte bei der Alzheimer-Therapie nützlich sein.
 Von "beunruhigenden Anzeichen für Veränderungen in Bezug auf das Eis, den Ozean und die Ökosysteme" schreiben Forscher in einer Studie über die Antarktis. Einige davon seien schwer aufzuhalten - und könnten verheerende Folgen weltweit haben.
Von "beunruhigenden Anzeichen für Veränderungen in Bezug auf das Eis, den Ozean und die Ökosysteme" schreiben Forscher in einer Studie über die Antarktis. Einige davon seien schwer aufzuhalten - und könnten verheerende Folgen weltweit haben.
 Über ein spezielles Implantat konnten US-Wissenschaftler das innere Gespräch von Versuchspersonen teilweise mithören – wenn die zuvor »chitty chitty bang bang« dachten. Noch ist die Fehlerrate allerdings hoch.
Über ein spezielles Implantat konnten US-Wissenschaftler das innere Gespräch von Versuchspersonen teilweise mithören – wenn die zuvor »chitty chitty bang bang« dachten. Noch ist die Fehlerrate allerdings hoch.
 Das Mittelmeer ist in diesem Sommer ungewöhnlich warm. Die Folgen für Pflanzen und Tiere sind dramatisch. Wissenschaftler haben nun zwei wesentliche Faktoren ergründet, die das Wasser aufheizen.
Das Mittelmeer ist in diesem Sommer ungewöhnlich warm. Die Folgen für Pflanzen und Tiere sind dramatisch. Wissenschaftler haben nun zwei wesentliche Faktoren ergründet, die das Wasser aufheizen.
 Rund 180 Länder konnten sich in Genf nicht auf ein Plastikabkommen einigen. Was bleibt, sind Wut und Enttäuschung. Doch daraus kann jetzt etwas Neues entstehen.
Rund 180 Länder konnten sich in Genf nicht auf ein Plastikabkommen einigen. Was bleibt, sind Wut und Enttäuschung. Doch daraus kann jetzt etwas Neues entstehen.
 Nach rund zwei Jahren zieht Spotify erneut die Preise für seine Abos an. Gleichzeitig soll eine neue Sparvariante kommen. Die ist allerdings nur für bestimmte Kunden buchbar.
Nach rund zwei Jahren zieht Spotify erneut die Preise für seine Abos an. Gleichzeitig soll eine neue Sparvariante kommen. Die ist allerdings nur für bestimmte Kunden buchbar.
 Kurz vor Wladimir Putins Treffen mit US-Präsident Donald Trump berichten russische Nutzer von Störungen bei WhatsApp und Telegram. Die Meta-Tochter wirft Russland vor, den Zugang zu sicherer Kommunikation zu verwehren.
Kurz vor Wladimir Putins Treffen mit US-Präsident Donald Trump berichten russische Nutzer von Störungen bei WhatsApp und Telegram. Die Meta-Tochter wirft Russland vor, den Zugang zu sicherer Kommunikation zu verwehren.
 Musik löst mitunter starke Emotionen aus - und sie kann auch Erinnerungen wecken. Eine Studie findet heraus, welche Art von Songs man hören muss, um Erinnerungen voller Freude, Aufregung und Vergnügen hervorzurufen. Die Erkenntnis könnte bei der Alzheimer-Therapie nützlich sein.
Musik löst mitunter starke Emotionen aus - und sie kann auch Erinnerungen wecken. Eine Studie findet heraus, welche Art von Songs man hören muss, um Erinnerungen voller Freude, Aufregung und Vergnügen hervorzurufen. Die Erkenntnis könnte bei der Alzheimer-Therapie nützlich sein.
 Bei der Pest denken die meisten Menschen an dunkle, aber längst vergangene Zeiten. Doch die Seuche des Mittelalters gibt es immer noch - auch in den USA. Eine Frau infiziert sich dort auf einem Campingausflug. Könnte das auch in Deutschland passieren?
Bei der Pest denken die meisten Menschen an dunkle, aber längst vergangene Zeiten. Doch die Seuche des Mittelalters gibt es immer noch - auch in den USA. Eine Frau infiziert sich dort auf einem Campingausflug. Könnte das auch in Deutschland passieren?
 Die Trump-Regierung feiert Abschiebungen mit Memes über Billigflieger. Die Administration weiß offenbar genau, wie man die aufmerksamkeitsheischenden Mechanismen der Plattformen bedient – und bespielt damit nun auch TikTok.
Die Trump-Regierung feiert Abschiebungen mit Memes über Billigflieger. Die Administration weiß offenbar genau, wie man die aufmerksamkeitsheischenden Mechanismen der Plattformen bedient – und bespielt damit nun auch TikTok.
 Immer öfter kommt es zu Temperaturrekorden und Hitzewellen. Besonders in Städten sind die hohen Temperaturen belastend. Ein neuartiger Baustoff könnte helfen.
Immer öfter kommt es zu Temperaturrekorden und Hitzewellen. Besonders in Städten sind die hohen Temperaturen belastend. Ein neuartiger Baustoff könnte helfen.
 Bei der Pest denken die meisten Menschen an dunkle, aber längst vergangene Zeiten. Doch die Seuche des Mittelalters gibt es immer noch - auch in den USA. Eine Person infiziert sich dort auf einem Campingausflug. Könnte das auch in Deutschland passieren?
Bei der Pest denken die meisten Menschen an dunkle, aber längst vergangene Zeiten. Doch die Seuche des Mittelalters gibt es immer noch - auch in den USA. Eine Person infiziert sich dort auf einem Campingausflug. Könnte das auch in Deutschland passieren?
 Wissenschaftler fürchten abrupte Veränderungen in der Antarktis. Ein Überblick zum aktuellen Forschungsstand zeichnet eine düstere Zukunft für Kaiserpinguine und für die Menschheit.
Wissenschaftler fürchten abrupte Veränderungen in der Antarktis. Ein Überblick zum aktuellen Forschungsstand zeichnet eine düstere Zukunft für Kaiserpinguine und für die Menschheit.
 Wie findet man Signale von Außerirdischen im All? US-Wissenschaftler haben dazu neue Erkenntnisse gesammelt, etwa über die beste Planetenkonstellation.
Wie findet man Signale von Außerirdischen im All? US-Wissenschaftler haben dazu neue Erkenntnisse gesammelt, etwa über die beste Planetenkonstellation.
 Künstliche Beleuchtung beeinflusst die Tierwelt, sie macht auch für viele Vögel die Nacht zum Tag. Das haben amerikanische Forscher über verschiedene Arten, Orte und Jahreszeiten hinweg untersucht.
Künstliche Beleuchtung beeinflusst die Tierwelt, sie macht auch für viele Vögel die Nacht zum Tag. Das haben amerikanische Forscher über verschiedene Arten, Orte und Jahreszeiten hinweg untersucht.
 Auf der Gamescom platzt die Bombe: King Art Games aus Bremen entwickeln den neuen Teil der Warhammer-Echtzeitstrategiereihe "Dawn of War". ntv.de hat den Titel in Köln angespielt - und die ersten Eindrücke haben es in sich.
Auf der Gamescom platzt die Bombe: King Art Games aus Bremen entwickeln den neuen Teil der Warhammer-Echtzeitstrategiereihe "Dawn of War". ntv.de hat den Titel in Köln angespielt - und die ersten Eindrücke haben es in sich.
 Auf der Gamescom werden Hunderte Neuheiten präsentiert. Viele davon werden am Markt scheitern, weil die meisten Gamer am liebsten olle Kamellen spielen. Für große Teile der Branche ist das ein existenzbedrohendes Problem.
Auf der Gamescom werden Hunderte Neuheiten präsentiert. Viele davon werden am Markt scheitern, weil die meisten Gamer am liebsten olle Kamellen spielen. Für große Teile der Branche ist das ein existenzbedrohendes Problem.
 Endlich ist es mehr als eine gefühlte Wahrheit: Eine Studie der Universitäten Warwick und Bielefeld zeigt, dass koffeinhaltige Getränke die Stimmung heben. Doch ein allgemeiner Glücklichmacher ist Kaffee damit nicht.
Endlich ist es mehr als eine gefühlte Wahrheit: Eine Studie der Universitäten Warwick und Bielefeld zeigt, dass koffeinhaltige Getränke die Stimmung heben. Doch ein allgemeiner Glücklichmacher ist Kaffee damit nicht.
 KI-Rechenzentren gelten als Stromfresser. Techunternehmen bemühen jetzt Rechenbeispiele, die beweisen sollen, dass eine einzelne Anfrage gar nicht so problematisch ist. Jetzt hat Google eine Berechnung veröffentlicht.
KI-Rechenzentren gelten als Stromfresser. Techunternehmen bemühen jetzt Rechenbeispiele, die beweisen sollen, dass eine einzelne Anfrage gar nicht so problematisch ist. Jetzt hat Google eine Berechnung veröffentlicht.
 Als blutsaugende Flattertiere der Nacht haben Fledermäuse kein gutes Image. Dabei sind die Tiere untereinander überaus fürsorglich, wie aktuelle Beobachtungen einer Fledermausfamilie in Costa Rica beweisen.
Als blutsaugende Flattertiere der Nacht haben Fledermäuse kein gutes Image. Dabei sind die Tiere untereinander überaus fürsorglich, wie aktuelle Beobachtungen einer Fledermausfamilie in Costa Rica beweisen.
 Die Messenger-Dienste WhatsApp und Telegramm sind dem Kreml schon lange nicht mehr geheuer. Besser kontrollieren lässt sich der heimische Konkurrent Max – weshalb er ab September auf allen neuen Gadgets installiert sein muss.
Die Messenger-Dienste WhatsApp und Telegramm sind dem Kreml schon lange nicht mehr geheuer. Besser kontrollieren lässt sich der heimische Konkurrent Max – weshalb er ab September auf allen neuen Gadgets installiert sein muss.
 Giraffen sind beeindruckend. Mit ihren sehr langen Hälsen gehören sie zu den höchsten an Land lebenden Tieren. Ihr sanftes Wesen verzaubert viele Beobachter. Da jede Art besonderen Schutz benötigt, ist die Anerkennung grundlegend.
Giraffen sind beeindruckend. Mit ihren sehr langen Hälsen gehören sie zu den höchsten an Land lebenden Tieren. Ihr sanftes Wesen verzaubert viele Beobachter. Da jede Art besonderen Schutz benötigt, ist die Anerkennung grundlegend.
 Giraffen sind beeindruckend. Mit ihren sehr langen Hälsen gehören sie zu den größten an Land lebenden Tieren. Ihr sanftes Wesen verzaubert viele Beobachter. Da jede Art besonderen Schutz benötigt, ist die Anerkennung grundlegend.
Giraffen sind beeindruckend. Mit ihren sehr langen Hälsen gehören sie zu den größten an Land lebenden Tieren. Ihr sanftes Wesen verzaubert viele Beobachter. Da jede Art besonderen Schutz benötigt, ist die Anerkennung grundlegend.
 Immer mehr Menschen nutzen regelmäßig KI-Chatbots: Die Zahl der Anbieter und Funktionen ist mittlerweile groß und unübersichtlich. Welche Modelle sind die besten - und wie nutzt man KI am besten für sich, privat und im Beruf?
Immer mehr Menschen nutzen regelmäßig KI-Chatbots: Die Zahl der Anbieter und Funktionen ist mittlerweile groß und unübersichtlich. Welche Modelle sind die besten - und wie nutzt man KI am besten für sich, privat und im Beruf?
 Die Messengerdienste WhatsApp und Telegramm sind dem Kreml schon lange nicht mehr geheuer. Besser kontrollieren lässt sich der heimische Konkurrent Max – weshalb er ab September auf allen neuen Gadgets installiert sein muss.
Die Messengerdienste WhatsApp und Telegramm sind dem Kreml schon lange nicht mehr geheuer. Besser kontrollieren lässt sich der heimische Konkurrent Max – weshalb er ab September auf allen neuen Gadgets installiert sein muss.
 Als Teenager stand unser Autor auf der Gamescom stundenlang für die neuesten Games an. Mit 31 feierte er nun sein Comeback in den Schlangen, auf der Suche nach den vielleicht letzten echten Gamern.
Als Teenager stand unser Autor auf der Gamescom stundenlang für die neuesten Games an. Mit 31 feierte er nun sein Comeback in den Schlangen, auf der Suche nach den vielleicht letzten echten Gamern.
 Eigentlich ist der schöne, aber hochgiftige »Blaue Drache« nicht im Mittelmeer zu Hause. Jetzt wurde die Ozeanschnecke an der spanischen Costa Blanca gesichtet. Die Behörden reagierten schnell.
Eigentlich ist der schöne, aber hochgiftige »Blaue Drache« nicht im Mittelmeer zu Hause. Jetzt wurde die Ozeanschnecke an der spanischen Costa Blanca gesichtet. Die Behörden reagierten schnell.
 Die Gamescom ist größer denn je. Der Ausstellerrekord ist eine gute Nachricht für die Organisatoren und die Szene, macht es für Gäste jedoch umso schwerer, sich zu entscheiden, für welche Spiele sich die wertvolle Zeit lohnt. ntv.de hat drei Tipps mitgebracht.
Die Gamescom ist größer denn je. Der Ausstellerrekord ist eine gute Nachricht für die Organisatoren und die Szene, macht es für Gäste jedoch umso schwerer, sich zu entscheiden, für welche Spiele sich die wertvolle Zeit lohnt. ntv.de hat drei Tipps mitgebracht.
 Eine Technik aus der Hirnforschung macht in den sozialen Medien die Runde: Durch "Gedankenmischen" soll das Gehirn beruhigt und das Einschlafen erleichtert werden. Ob und wie das funktioniert, erklärt ntv.de.
Eine Technik aus der Hirnforschung macht in den sozialen Medien die Runde: Durch "Gedankenmischen" soll das Gehirn beruhigt und das Einschlafen erleichtert werden. Ob und wie das funktioniert, erklärt ntv.de.
 Die Wanderung durchs Watt birgt Gefahren, immer wieder müssen Touristen vor der Flut gerettet werden. Durch den Klimawandel könnte das Abenteuer risikoreicher werden.
Die Wanderung durchs Watt birgt Gefahren, immer wieder müssen Touristen vor der Flut gerettet werden. Durch den Klimawandel könnte das Abenteuer risikoreicher werden.
 Eine Echse groß wie ein Bison, mit einem Segel auf dem Rücken. So sah wohl eine Dinosaurier-Art aus, von der ein englisches Team erstmals Knochen gefunden hat. Das Haut-Segel war möglicherweise wichtig, um die Körpertemperatur zu regulieren. Oder aber für die "sexuelle Signalgebung".
Eine Echse groß wie ein Bison, mit einem Segel auf dem Rücken. So sah wohl eine Dinosaurier-Art aus, von der ein englisches Team erstmals Knochen gefunden hat. Das Haut-Segel war möglicherweise wichtig, um die Körpertemperatur zu regulieren. Oder aber für die "sexuelle Signalgebung".
 Die evolutionäre Anpassung der Menschen ist ein anhaltender Prozess. Das belegen abweichende Merkmale von Bewohnern unterschiedlicher Weltregionen. Aber auch die Medizin und moderne Lebensweisen beeinflussen unsere Biologie zunehmend.
Die evolutionäre Anpassung der Menschen ist ein anhaltender Prozess. Das belegen abweichende Merkmale von Bewohnern unterschiedlicher Weltregionen. Aber auch die Medizin und moderne Lebensweisen beeinflussen unsere Biologie zunehmend.
 Die Asiatische Tigermücke gelangt in Europa immer weiter nach Norden. Gefährliche Viren wie Dengue oder Chikungunya könnten laut einer neuen Studie bald auch Deutschland und England erreichen. Der Klimawandel beschleunigt die besorgniserregende Ausbreitung.
Die Asiatische Tigermücke gelangt in Europa immer weiter nach Norden. Gefährliche Viren wie Dengue oder Chikungunya könnten laut einer neuen Studie bald auch Deutschland und England erreichen. Der Klimawandel beschleunigt die besorgniserregende Ausbreitung.
 Die Feuerwehr Wiesmoor hat ein neues Einsatz-Fahrzeug. Es ist: ein Traktor, der ziemlich viel kann. Er löscht, pumpt und ist feuerfest. Und ja, wirklich, Fans im Netz überschlagen sich vor Freude.
Die Feuerwehr Wiesmoor hat ein neues Einsatz-Fahrzeug. Es ist: ein Traktor, der ziemlich viel kann. Er löscht, pumpt und ist feuerfest. Und ja, wirklich, Fans im Netz überschlagen sich vor Freude.
 Der Istiorachis macarthurae lebte vor mehr als 120 Millionen Jahren in Südengland. Er war zwei Meter hoch und ausgestattet mit einem auffälligen Rückensegel. Wozu der Rückenkamm diente? Könnte mit Liebe zu tun haben.
Der Istiorachis macarthurae lebte vor mehr als 120 Millionen Jahren in Südengland. Er war zwei Meter hoch und ausgestattet mit einem auffälligen Rückensegel. Wozu der Rückenkamm diente? Könnte mit Liebe zu tun haben.
 Die Feuerwehr Wiesmoor hat ein neues Einsatzfahrzeug. Es ist: ein Traktor, der ziemlich viel kann. Er löscht, pumpt und ist feuerfest. Und ja, wirklich, Fans im Netz überschlagen sich vor Freude.
Die Feuerwehr Wiesmoor hat ein neues Einsatzfahrzeug. Es ist: ein Traktor, der ziemlich viel kann. Er löscht, pumpt und ist feuerfest. Und ja, wirklich, Fans im Netz überschlagen sich vor Freude.
 Mit der Riesenrakete Starship will Elon Musk irgendwann Menschen auf den Mars bringen. Das Vorhaben gestaltet sich schwierig, die letzten Tests missglücken. Den zehnten Versuch bricht SpaceX jetzt fast in letzter Minute ab.
Mit der Riesenrakete Starship will Elon Musk irgendwann Menschen auf den Mars bringen. Das Vorhaben gestaltet sich schwierig, die letzten Tests missglücken. Den zehnten Versuch bricht SpaceX jetzt fast in letzter Minute ab.
 Der 123-Meter-Koloss wurde bereits betankt, als die schlechte Nachricht kam: Die Starship-Rakete von SpaceX kann nicht wie geplant zum zehnten Test abheben. Nun beginnt die Fehlersuche.
Der 123-Meter-Koloss wurde bereits betankt, als die schlechte Nachricht kam: Die Starship-Rakete von SpaceX kann nicht wie geplant zum zehnten Test abheben. Nun beginnt die Fehlersuche.
 In den USA hat die Arzneimittelbehörde neue Augentropfen mit einem altbekannten Wirkstoff zugelassen. Sie sollen die Sehschärfe in der Nähe verbessern, haben aber einen Nachteil.
In den USA hat die Arzneimittelbehörde neue Augentropfen mit einem altbekannten Wirkstoff zugelassen. Sie sollen die Sehschärfe in der Nähe verbessern, haben aber einen Nachteil.
 Die zweitgrößte Volkswirtschaft der Welt gilt als wichtiger Akteur im Kampf gegen den Klimawandel, löst sich aber nicht von dem klimaschädlichen Energieträger Kohle. Woran das liegen könnte.
Die zweitgrößte Volkswirtschaft der Welt gilt als wichtiger Akteur im Kampf gegen den Klimawandel, löst sich aber nicht von dem klimaschädlichen Energieträger Kohle. Woran das liegen könnte.
 Die Welt versinkt in Kunststoff. Der SPIEGEL zeigt die globalen Plastikströme und ihre lokalen Folgen in Grafiken: die größten Produzenten und Verbraucher, wie wenig recycelt wird und wo der ganze Müll letztlich bleibt.
Die Welt versinkt in Kunststoff. Der SPIEGEL zeigt die globalen Plastikströme und ihre lokalen Folgen in Grafiken: die größten Produzenten und Verbraucher, wie wenig recycelt wird und wo der ganze Müll letztlich bleibt.
 Seit dem 19. Jahrhundert breitet sich Ambrosia in Europa aus. Besonders für Allergiker ist die Pflanze gefährlich, da sie bis zum Absterben Pollen produziert, welche ein fünffaches Allergiepotenzial als Gräser haben. Was gegen die Verbreitung getan werden kann und wie sich Betroffene schützen können.
Seit dem 19. Jahrhundert breitet sich Ambrosia in Europa aus. Besonders für Allergiker ist die Pflanze gefährlich, da sie bis zum Absterben Pollen produziert, welche ein fünffaches Allergiepotenzial als Gräser haben. Was gegen die Verbreitung getan werden kann und wie sich Betroffene schützen können.
 Die Gamescom ist vorbei. Zeit, ein Resümee zu ziehen. ntv.de hat einige der gefragtesten Titel angespielt und kann verraten: Videospiel-Fans können sich auf die Zukunft freuen.
Die Gamescom ist vorbei. Zeit, ein Resümee zu ziehen. ntv.de hat einige der gefragtesten Titel angespielt und kann verraten: Videospiel-Fans können sich auf die Zukunft freuen.
 Da die Zahl menschlicher Organspenden bei Weitem nicht ausreicht, versuchen Mediziner, Organe von Tieren für Transplantationen zu nutzen, etwa von Schweinen. Bei der Lunge ist das besonders schwierig. Chinesischen Ärzten ist ein solcher Eingriff gelungen - allerdings nur für einige Tage.
Da die Zahl menschlicher Organspenden bei Weitem nicht ausreicht, versuchen Mediziner, Organe von Tieren für Transplantationen zu nutzen, etwa von Schweinen. Bei der Lunge ist das besonders schwierig. Chinesischen Ärzten ist ein solcher Eingriff gelungen - allerdings nur für einige Tage.
 Das Organ funktionierte neun Tage lang: Ein Forscherteam aus dem chinesischen Guangzhou meldet einen wichtigen Fortschritt auf dem Weg in eine Zukunft, in der Schwerkranke durch Verpflanzung von Tierorganen gerettet werden könnten.
Das Organ funktionierte neun Tage lang: Ein Forscherteam aus dem chinesischen Guangzhou meldet einen wichtigen Fortschritt auf dem Weg in eine Zukunft, in der Schwerkranke durch Verpflanzung von Tierorganen gerettet werden könnten.
 Ausgeklügelte Formen der Pflanzennutzung waren offenbar schon früher weiter verbreitet als bisher angenommen. Darauf deuten Werkzeuge und Pflanzenreste hin, die Forscher in Usbekistan entdeckt haben.
Ausgeklügelte Formen der Pflanzennutzung waren offenbar schon früher weiter verbreitet als bisher angenommen. Darauf deuten Werkzeuge und Pflanzenreste hin, die Forscher in Usbekistan entdeckt haben.
 Der französische Streamer Raphaël Graven wurde mit Gewaltvideos im Netz bekannt. Am Montag starb er während eines Livestreams. Die Staatsanwaltschaft untersucht den Fall.
Der französische Streamer Raphaël Graven wurde mit Gewaltvideos im Netz bekannt. Am Montag starb er während eines Livestreams. Die Staatsanwaltschaft untersucht den Fall.
 Der Planet Uranus hat sehr viele Monde - bisher kannte man 28. Nun wird noch einer bei dem Eisriesen erspäht. Der blieb aus einem bestimmten Grund bisher verborgen. Und er ist zwar ein Mini-Mond, aber bedeutend, seine Entdeckung "erweitert unsere Sicht auf Uranus und sein rätselhaftes Mondsystem".
Der Planet Uranus hat sehr viele Monde - bisher kannte man 28. Nun wird noch einer bei dem Eisriesen erspäht. Der blieb aus einem bestimmten Grund bisher verborgen. Und er ist zwar ein Mini-Mond, aber bedeutend, seine Entdeckung "erweitert unsere Sicht auf Uranus und sein rätselhaftes Mondsystem".
 Wann fing der Mensch an, systematisch Pflanzen zu nutzen? Mehr als 9000 Jahre alte Funde aus einer Höhle in Asien liefern neue Hinweise. Laut Forschern bestätigt sich immer mehr, dass die Landwirtschaft schrittweise entstand - und ohne konkrete Absicht.
Wann fing der Mensch an, systematisch Pflanzen zu nutzen? Mehr als 9000 Jahre alte Funde aus einer Höhle in Asien liefern neue Hinweise. Laut Forschern bestätigt sich immer mehr, dass die Landwirtschaft schrittweise entstand - und ohne konkrete Absicht.
 Seit Juni 2024 empfiehlt die Ständige Impfkommission den Einsatz eines RSV-Antikörpers bei Babys. Die passive Immunisierung zeigt bereits im Jahr darauf Wirkung, wie die Zahlen des RKI beweisen.
Seit Juni 2024 empfiehlt die Ständige Impfkommission den Einsatz eines RSV-Antikörpers bei Babys. Die passive Immunisierung zeigt bereits im Jahr darauf Wirkung, wie die Zahlen des RKI beweisen.
 Damit sie nicht korrodieren, müssen Windanlagen im Meer speziell behandelt werden: Einige der dafür nötigen Stoffe gelten als bedenklich für die Umwelt. Manche dieser Emissionen könnten vermieden werden.
Damit sie nicht korrodieren, müssen Windanlagen im Meer speziell behandelt werden: Einige der dafür nötigen Stoffe gelten als bedenklich für die Umwelt. Manche dieser Emissionen könnten vermieden werden.
 Es gibt Seepferdchen, die den Korallen, mit denen sie leben, zum Verwechseln ähnlich sehen. Die Symbiose zeigt sich sogar auf der genetischen Ebene der Tiere. Doch der Lebensraum der Tiere ist massiv bedroht.
Es gibt Seepferdchen, die den Korallen, mit denen sie leben, zum Verwechseln ähnlich sehen. Die Symbiose zeigt sich sogar auf der genetischen Ebene der Tiere. Doch der Lebensraum der Tiere ist massiv bedroht.
 Sie sind zwei Zentimeter groß und schwer zu entdecken: Zwerg-Seepferdchen haben sich im Laufe der Evolution perfekt an ihre Umgebung angepasst. Forschende können nun erklären, wie die Tiere das geschafft haben.
Sie sind zwei Zentimeter groß und schwer zu entdecken: Zwerg-Seepferdchen haben sich im Laufe der Evolution perfekt an ihre Umgebung angepasst. Forschende können nun erklären, wie die Tiere das geschafft haben.
 Laut einer aktuellen Umfrage spült fast die Hälfte der Menschen in Deutschland Essensreste die Toilette herunter. Ein Fehler, warnen Fachleute. Was in die Kanalisation gehört – und was nicht.
Laut einer aktuellen Umfrage spült fast die Hälfte der Menschen in Deutschland Essensreste die Toilette herunter. Ein Fehler, warnen Fachleute. Was in die Kanalisation gehört – und was nicht.
 Die Lebenserwartung von Menschen hat sich über die Jahrhunderte stark verändert. Besonders zu Beginn des 20. Jahrhunderts stieg sie schwindelerregend schnell. In einer neuen Studie machen Forscher nun aber eine Verlangsamung aus.
Die Lebenserwartung von Menschen hat sich über die Jahrhunderte stark verändert. Besonders zu Beginn des 20. Jahrhunderts stieg sie schwindelerregend schnell. In einer neuen Studie machen Forscher nun aber eine Verlangsamung aus.
 Fordert jemand am Telefon wie aus dem Nichts Geld, sollten die Alarmglocken schrillen. Das zeigt ein Fall aus Stuttgart: Eine Frau wurde dort zwei Jahre lang mit erfundenen Schulden ihres verstorbenen Mannes konfrontiert.
Fordert jemand am Telefon wie aus dem Nichts Geld, sollten die Alarmglocken schrillen. Das zeigt ein Fall aus Stuttgart: Eine Frau wurde dort zwei Jahre lang mit erfundenen Schulden ihres verstorbenen Mannes konfrontiert.
 US-Präsident Trump lässt die Nationalgarde in Washington, D.C. aufmarschieren und kündigt Einsätze in weiteren Städten an. Kritiker werfen ihm politische Motive vor. Die Kriminalitätsdaten zeichnen ein komplexeres Bild.
US-Präsident Trump lässt die Nationalgarde in Washington, D.C. aufmarschieren und kündigt Einsätze in weiteren Städten an. Kritiker werfen ihm politische Motive vor. Die Kriminalitätsdaten zeichnen ein komplexeres Bild.
 Durchatmen bei SpaceX von Elon Musk: Nach zwei geplatzten Testflügen kann die Rakete Starship nun abheben. Nach vorherigen Explosionen bei Testflügen, braucht das Unternehmen ein Erfolgserlebnis. Denn dort gehen die Ziele über Reisen zum Mond hinaus.
Durchatmen bei SpaceX von Elon Musk: Nach zwei geplatzten Testflügen kann die Rakete Starship nun abheben. Nach vorherigen Explosionen bei Testflügen, braucht das Unternehmen ein Erfolgserlebnis. Denn dort gehen die Ziele über Reisen zum Mond hinaus.
 Künstliche Beleuchtung beeinflusst die Tierwelt, sie macht auch für viele Vögel die Nacht zum Tag. Das haben amerikanische Forscher über verschiedene Arten, Orte und Jahreszeiten hinweg untersucht.
Künstliche Beleuchtung beeinflusst die Tierwelt, sie macht auch für viele Vögel die Nacht zum Tag. Das haben amerikanische Forscher über verschiedene Arten, Orte und Jahreszeiten hinweg untersucht.
 Wissenschaftlich belegt: Bairisch ist schwer verständlich – zumindest für künstliche Intelligenz. Eine neue Studie zeigt, dass die Spracherkennung Schwierigkeiten hat, Gesprochenes ins Hochdeutsche zu verschriftlichen.
Wissenschaftlich belegt: Bairisch ist schwer verständlich – zumindest für künstliche Intelligenz. Eine neue Studie zeigt, dass die Spracherkennung Schwierigkeiten hat, Gesprochenes ins Hochdeutsche zu verschriftlichen.
 Die Trump-Regierung feiert Abschiebungen mit Memes über Billigflieger. Die Administration weiß offenbar genau, wie man die aufmerksamkeitsheischenden Mechanismen der Plattformen bedient – und bespielt damit nun auch TikTok.
Die Trump-Regierung feiert Abschiebungen mit Memes über Billigflieger. Die Administration weiß offenbar genau, wie man die aufmerksamkeitsheischenden Mechanismen der Plattformen bedient – und bespielt damit nun auch TikTok.
 Auf der Gamescom platzt die Bombe: King Art Games aus Bremen entwickeln den neuen Teil der Warhammer-Echtzeitstrategiereihe "Dawn of War". ntv.de hat den Titel in Köln angespielt - und die ersten Eindrücke haben es in sich.
Auf der Gamescom platzt die Bombe: King Art Games aus Bremen entwickeln den neuen Teil der Warhammer-Echtzeitstrategiereihe "Dawn of War". ntv.de hat den Titel in Köln angespielt - und die ersten Eindrücke haben es in sich.
 Sollen Handys aus Klassenzimmern verbannt werden? In die hitzige Debatte mischen sich nun vier Organisationen ein und fordern »Medienkompetenz statt pauschaler Smartphone-Verbote«. Sie haben gute Gründe.
Sollen Handys aus Klassenzimmern verbannt werden? In die hitzige Debatte mischen sich nun vier Organisationen ein und fordern »Medienkompetenz statt pauschaler Smartphone-Verbote«. Sie haben gute Gründe.
 Die SpaceX Rakete "Starship", die größte und leistungsstärkste Rakete überhaupt, soll eines Tages wiederverwendbar werden. Bei Start- und Landeversuchen treten jedoch immer Probleme auf. Beim zehnten Test feiern die Wissenschaftler einen Erfolg. NASA-Chef Duffy reagiert begeistert.
Die SpaceX Rakete "Starship", die größte und leistungsstärkste Rakete überhaupt, soll eines Tages wiederverwendbar werden. Bei Start- und Landeversuchen treten jedoch immer Probleme auf. Beim zehnten Test feiern die Wissenschaftler einen Erfolg. NASA-Chef Duffy reagiert begeistert.
 Ein Teenager tötet sich selbst, die Eltern sehen die Verantwortung dafür bei ChatGPT – und ziehen vor Gericht. OpenAI, das Unternehmen hinter dem Chatbot, kündigt nun Änderungen an, um besser mit »sensiblen Situationen« umzugehen.
Ein Teenager tötet sich selbst, die Eltern sehen die Verantwortung dafür bei ChatGPT – und ziehen vor Gericht. OpenAI, das Unternehmen hinter dem Chatbot, kündigt nun Änderungen an, um besser mit »sensiblen Situationen« umzugehen.
 Darf man Grundwasser mit privaten Brunnen anzapfen? Ist immer genug für alle da? Und wo herrscht in Deutschland gerade sogenannter Grundwasserstress? Der SPIEGEL erklärt es in Grafiken.
Darf man Grundwasser mit privaten Brunnen anzapfen? Ist immer genug für alle da? Und wo herrscht in Deutschland gerade sogenannter Grundwasserstress? Der SPIEGEL erklärt es in Grafiken.
 Aller guten Dinge sind zehn: Der jüngste Testflug von Starship, der Riesenrakete von Elon Musk, ist geglückt. Im All unterwegs, hatte die Rakete noch eine weitere Mission.
Aller guten Dinge sind zehn: Der jüngste Testflug von Starship, der Riesenrakete von Elon Musk, ist geglückt. Im All unterwegs, hatte die Rakete noch eine weitere Mission.
 Die Toniebox, eine Erfindung aus Deutschland, steht in Millionen Haushalten. Jetzt wird sie neu aufgelegt – mit frischen Features und bildschirmfreien Spielerlebnissen, die teurer sind als neue Figürchen.
Die Toniebox, eine Erfindung aus Deutschland, steht in Millionen Haushalten. Jetzt wird sie neu aufgelegt – mit frischen Features und bildschirmfreien Spielerlebnissen, die teurer sind als neue Figürchen.
 »Die Weite des Ozeans überrascht uns jeden Tag«: Sportangler staunen über einen einzigartigen Hai vor Costa Rica. Wissenschaftler haben eine Erklärung für seine ungewöhnliche Farbe.
»Die Weite des Ozeans überrascht uns jeden Tag«: Sportangler staunen über einen einzigartigen Hai vor Costa Rica. Wissenschaftler haben eine Erklärung für seine ungewöhnliche Farbe.
 Eine Studie enthüllt eine tödliche Allianz: Ein Schimmelpilz, der schwere Lungenentzündungen auslöst, wird durch einen Virus noch gefährlicher. Forschende zeigen erstmals, wie der virale Helfer Infektionen beim Menschen verstärkt. Neue Therapien könnten helfen.
Eine Studie enthüllt eine tödliche Allianz: Ein Schimmelpilz, der schwere Lungenentzündungen auslöst, wird durch einen Virus noch gefährlicher. Forschende zeigen erstmals, wie der virale Helfer Infektionen beim Menschen verstärkt. Neue Therapien könnten helfen.
 Im Internet soll er Angebote für angebliche Mietwohnungen veröffentlicht haben und dann die Konten der arglosen Wohnungssuchenden leergeräumt haben. Die Staatsanwaltschaft Berlin klagt einen 46-Jährigen wegen schweren Betrugs an.
Im Internet soll er Angebote für angebliche Mietwohnungen veröffentlicht haben und dann die Konten der arglosen Wohnungssuchenden leergeräumt haben. Die Staatsanwaltschaft Berlin klagt einen 46-Jährigen wegen schweren Betrugs an.
 Ned hat ein linksgewundenes Gehäuse und ist damit ein Exot. Nun soll der Aufruf einer Zeitschrift dafür sorgen, dass die Schnecke kein Leben in unfreiwilliger Abstinenz führen muss.
Ned hat ein linksgewundenes Gehäuse und ist damit ein Exot. Nun soll der Aufruf einer Zeitschrift dafür sorgen, dass die Schnecke kein Leben in unfreiwilliger Abstinenz führen muss.
 Im vergangenen Jahr wurde ein groß angelegter Angriff chinesischer Hacker auf US-Politiker bekannt. Nun machen neben dem FBI und der NSA auch der Verfassungsschutz und weitere deutsche Behörden auf die Bedrohung aufmerksam.
Im vergangenen Jahr wurde ein groß angelegter Angriff chinesischer Hacker auf US-Politiker bekannt. Nun machen neben dem FBI und der NSA auch der Verfassungsschutz und weitere deutsche Behörden auf die Bedrohung aufmerksam.
 Ankylosaurier sind vor allem für ihre starken Panzer bekannt. Bei einer Art entdecken Forschende jedoch eine extravagante Rüstung aus Platten und Stacheln, die Ihresgleichen sucht. Doch wozu der Aufwand? Das Forscherteam hat bereits eine Vermutung.
Ankylosaurier sind vor allem für ihre starken Panzer bekannt. Bei einer Art entdecken Forschende jedoch eine extravagante Rüstung aus Platten und Stacheln, die Ihresgleichen sucht. Doch wozu der Aufwand? Das Forscherteam hat bereits eine Vermutung.
 Ankylosaurier sind für ihre Panzer bekannt. Doch ausgerechnet der früheste Vertreter der Gruppe wartete mit einer beispiellosen Rüstung auf. Forschende haben eine Vermutung, wozu sie gut war.
Ankylosaurier sind für ihre Panzer bekannt. Doch ausgerechnet der früheste Vertreter der Gruppe wartete mit einer beispiellosen Rüstung auf. Forschende haben eine Vermutung, wozu sie gut war.
 Spektakuläre Bilder aus freier Wildbahn: Beim britischen »Wildlife Photographer Award« werden die besten Tierfotos des Jahres ausgezeichnet. Wer mit seinen Fotos dabei ist, hatte bei der Arbeit entweder viel Geduld oder riesiges Glück.
Spektakuläre Bilder aus freier Wildbahn: Beim britischen »Wildlife Photographer Award« werden die besten Tierfotos des Jahres ausgezeichnet. Wer mit seinen Fotos dabei ist, hatte bei der Arbeit entweder viel Geduld oder riesiges Glück.
 Forschende aus den Niederlanden und der Schweiz haben untersucht, wie sich Schaum auf einem Bier bildet und wie stabil er dann ist. Die bisher gängige Theorie zu ergänzen, dauerte ziemlich lange.
Forschende aus den Niederlanden und der Schweiz haben untersucht, wie sich Schaum auf einem Bier bildet und wie stabil er dann ist. Die bisher gängige Theorie zu ergänzen, dauerte ziemlich lange.
 Erst machte die Technik Probleme, dann das Wetter: Trotz Widrigkeiten war der zehnte Testflug der Starship-Rakete von SpaceX erfolgreich. Zum ersten Mal konnte das Raumschiff das Aussetzen von Satelliten simulieren.
Erst machte die Technik Probleme, dann das Wetter: Trotz Widrigkeiten war der zehnte Testflug der Starship-Rakete von SpaceX erfolgreich. Zum ersten Mal konnte das Raumschiff das Aussetzen von Satelliten simulieren.
 Die neuen Pixel-Phones können mit der Stimme des Testers fremde Sprachen sprechen und Dinge fotografieren, die mit bloßem Auge kaum zu sehen sind. Reicht Googles KI aus, um die wenigen Hardware-Neuerungen auszugleichen?
Die neuen Pixel-Phones können mit der Stimme des Testers fremde Sprachen sprechen und Dinge fotografieren, die mit bloßem Auge kaum zu sehen sind. Reicht Googles KI aus, um die wenigen Hardware-Neuerungen auszugleichen?
 Der Klimawandel wirkt sich offenbar direkt auf die Bisskraft von Haien aus. Das haben Biologen von der Heinrich-Heine-Universität festgestellt. Die Proben für die Studie nahmen sie bei Haifischen aus Oberhausen.
Der Klimawandel wirkt sich offenbar direkt auf die Bisskraft von Haien aus. Das haben Biologen von der Heinrich-Heine-Universität festgestellt. Die Proben für die Studie nahmen sie bei Haifischen aus Oberhausen.
 Als Teenager stand unser Autor auf der Gamescom stundenlang für die neuesten Games an. Mit 31 feierte er nun sein Comeback in den Schlangen, auf der Suche nach den vielleicht letzten echten Gamern.
Als Teenager stand unser Autor auf der Gamescom stundenlang für die neuesten Games an. Mit 31 feierte er nun sein Comeback in den Schlangen, auf der Suche nach den vielleicht letzten echten Gamern.
 Während ältere Menschen zunehmend zufriedener werden, sind junge Erwachsene heute unglücklicher als zuvor. Die Trendwende, die sich weltweit erkennen lässt, hat langfristige Folgen für die Gesellschaft. Fachleute zeigen sich besorgt.
Während ältere Menschen zunehmend zufriedener werden, sind junge Erwachsene heute unglücklicher als zuvor. Die Trendwende, die sich weltweit erkennen lässt, hat langfristige Folgen für die Gesellschaft. Fachleute zeigen sich besorgt.
 Walhaie sind mit die größten Fische und stark gefährdet. Eine Studie zeigt: Fast 77 Prozent der Tiere in einem indonesischen Tourismusgebiet tragen Verletzungen oder Narben. Forscher fordern Schutzmaßnahmen, um die Art zu retten.
Walhaie sind mit die größten Fische und stark gefährdet. Eine Studie zeigt: Fast 77 Prozent der Tiere in einem indonesischen Tourismusgebiet tragen Verletzungen oder Narben. Forscher fordern Schutzmaßnahmen, um die Art zu retten.
 Flauschige Fakekaninchen sollen helfen, die massenhafte Ausbreitung von invasiven Pythons in den Everglades zu bekämpfen. Die Robotertierchen riechen sogar wie die echten.
Flauschige Fakekaninchen sollen helfen, die massenhafte Ausbreitung von invasiven Pythons in den Everglades zu bekämpfen. Die Robotertierchen riechen sogar wie die echten.
 Vor Costa Rica haben Fischer einen orangefarbenen Hai gefangen. Wissenschaftler sind fasziniert, wenn Tiere farblich aus der Reihe fallen. Die Fotos.
Vor Costa Rica haben Fischer einen orangefarbenen Hai gefangen. Wissenschaftler sind fasziniert, wenn Tiere farblich aus der Reihe fallen. Die Fotos.
 In Mexiko breitet sich der fleischfressende Schraubenwurm aus. Den Parasiten fand man bisher auf Rindern, Hunden und Pferden. Auch Menschen sollen bereits in Behandlung sein, einen Fall gab es jüngst auch in den USA.
In Mexiko breitet sich der fleischfressende Schraubenwurm aus. Den Parasiten fand man bisher auf Rindern, Hunden und Pferden. Auch Menschen sollen bereits in Behandlung sein, einen Fall gab es jüngst auch in den USA.
 Schon die Vorstellung ruft bei den meisten Menschen pure Abscheu hervor: Hunderte Fliegenlarven fressen sich allmählich durch das Gewebe im Körper bis ins Gehirn. Ein erster Fall bei einem Menschen in den USA wird nun offiziell bestätigt. Einige Behörden im Land planen verschiedene Maßnahmen gegen die Art.
Schon die Vorstellung ruft bei den meisten Menschen pure Abscheu hervor: Hunderte Fliegenlarven fressen sich allmählich durch das Gewebe im Körper bis ins Gehirn. Ein erster Fall bei einem Menschen in den USA wird nun offiziell bestätigt. Einige Behörden im Land planen verschiedene Maßnahmen gegen die Art.
 Ein Teenager tötet sich selbst, seine Eltern verklagen deswegen nun die ChatGPT-Entwickler. Der Fall aus den USA ist komplex. Doch klar scheint, dass OpenAI sein Tool unzureichend auf heikle Anfragen vorbereitet hat.
Ein Teenager tötet sich selbst, seine Eltern verklagen deswegen nun die ChatGPT-Entwickler. Der Fall aus den USA ist komplex. Doch klar scheint, dass OpenAI sein Tool unzureichend auf heikle Anfragen vorbereitet hat.
 Geghostet – und geprellt? Mit Vorwürfen gegen Papaplatte hat der Cutter Pamabu eine Debatte über den Umgang von Internetstars mit ihren Helfern im Hintergrund ausgelöst. Probleme hat die Branche über seinen Fall hinaus.
Geghostet – und geprellt? Mit Vorwürfen gegen Papaplatte hat der Cutter Pamabu eine Debatte über den Umgang von Internetstars mit ihren Helfern im Hintergrund ausgelöst. Probleme hat die Branche über seinen Fall hinaus.
 An Deutschlands höchstem Berg steigen die Temperaturen. Die Klimakrise lässt an der Zugspitze Gletscher und den letzten Permafrost verschwinden. Das könnte Folgen für den Berg selbst und seine Besucher haben.
An Deutschlands höchstem Berg steigen die Temperaturen. Die Klimakrise lässt an der Zugspitze Gletscher und den letzten Permafrost verschwinden. Das könnte Folgen für den Berg selbst und seine Besucher haben.
 Die Route durch die arktischen Gewässer nördlich Sibiriens ist schiffbar geworden. Nun soll ein Frachter auf diesem Weg in Rekordzeit von China nach England fahren. An Bord: knapp 5000 Container mit Waren für das Weihnachtsgeschäft.
Die Route durch die arktischen Gewässer nördlich Sibiriens ist schiffbar geworden. Nun soll ein Frachter auf diesem Weg in Rekordzeit von China nach England fahren. An Bord: knapp 5000 Container mit Waren für das Weihnachtsgeschäft.
 Ehec heißt der Erreger, der im Darm schwere Entzündungen auslösen und sogar zum Tod führen kann. In Deutschland und in Belgien werden zuletzt fast 40 Fälle bekannt. Das erinnert an den Ausbruch von 2011, bei dem rund 3800 Menschen infiziert waren.
Ehec heißt der Erreger, der im Darm schwere Entzündungen auslösen und sogar zum Tod führen kann. In Deutschland und in Belgien werden zuletzt fast 40 Fälle bekannt. Das erinnert an den Ausbruch von 2011, bei dem rund 3800 Menschen infiziert waren.
 Freundinnen und Freunde sind für uns besonders wichtig. Wir sollten um sie kämpfen, raten Psychologen. Weil sie uns glücklicher machen und gesünder. Außerdem lässt sich von gelungener Freundschaft viel für die Liebe lernen.
Freundinnen und Freunde sind für uns besonders wichtig. Wir sollten um sie kämpfen, raten Psychologen. Weil sie uns glücklicher machen und gesünder. Außerdem lässt sich von gelungener Freundschaft viel für die Liebe lernen.
 Der Antikörper Lecanemab hilft, Alzheimer im Frühstadium zu verzögern. Das Medikament mit dem Namen Leqembi ist ab September in Deutschland erhältlich. Doch nur ein Bruchteil der Betroffenen profitiert davon.
Der Antikörper Lecanemab hilft, Alzheimer im Frühstadium zu verzögern. Das Medikament mit dem Namen Leqembi ist ab September in Deutschland erhältlich. Doch nur ein Bruchteil der Betroffenen profitiert davon.
 Eine neue Studie zeigt, dass der Widerstand gegen Regeländerungen wie ein Tempolimit oft nur kurzfristig anhält. Nach der Einführung akzeptieren viele Menschen die Maßnahmen überraschend schnell. Die Ergebnisse der Untersuchungen könnten auch politische Entscheidungen beeinflussen.
Eine neue Studie zeigt, dass der Widerstand gegen Regeländerungen wie ein Tempolimit oft nur kurzfristig anhält. Nach der Einführung akzeptieren viele Menschen die Maßnahmen überraschend schnell. Die Ergebnisse der Untersuchungen könnten auch politische Entscheidungen beeinflussen.
 Mütter, die den Alltag mit ihren Kindern im Netz präsentieren, sind gefragt – bei Nutzern und Werbekunden. Doch das Geschäftsmodell steht in der Kritik: Gefährdet die Vermarktung des Familienlebens das Wohl des Nachwuchses?
Mütter, die den Alltag mit ihren Kindern im Netz präsentieren, sind gefragt – bei Nutzern und Werbekunden. Doch das Geschäftsmodell steht in der Kritik: Gefährdet die Vermarktung des Familienlebens das Wohl des Nachwuchses?
 Dass sein Chatbot Grok nicht die Download-Charts in Apples App Store anführt, ärgert Elon Musk. In einer Klage macht er den iPhone-Konzern und die ChatGPT-Macher dafür verantwortlich und wirft ihnen ein Monopol vor.
Dass sein Chatbot Grok nicht die Download-Charts in Apples App Store anführt, ärgert Elon Musk. In einer Klage macht er den iPhone-Konzern und die ChatGPT-Macher dafür verantwortlich und wirft ihnen ein Monopol vor.
 Der Klimawandel greift das Mittelmeer besonders stark an. Es ist seicht und erwärmt sich deshalb schneller. Unterwasserflora und Fauna leiden so sehr, dass die Forscher vor der Entstehung von Unterwasser-Wüsten warnen.
Der Klimawandel greift das Mittelmeer besonders stark an. Es ist seicht und erwärmt sich deshalb schneller. Unterwasserflora und Fauna leiden so sehr, dass die Forscher vor der Entstehung von Unterwasser-Wüsten warnen.
 Das Futter wird knapp: In Rheinland-Pfalz brechen die Störche früher als sonst in ihr Winterquartier auf. Auch in anderen Bundesländern melden Probleme aufgrund von Trockenheit.
Das Futter wird knapp: In Rheinland-Pfalz brechen die Störche früher als sonst in ihr Winterquartier auf. Auch in anderen Bundesländern melden Probleme aufgrund von Trockenheit.
 Die Erderwärmung hat vielerlei Folgen. Mit einer umfangreichen Übersichtsarbeit kann ein Forschungsteam klären, was bestimmte Szenarien für die Besiedlung von Böden bedeuten.
Die Erderwärmung hat vielerlei Folgen. Mit einer umfangreichen Übersichtsarbeit kann ein Forschungsteam klären, was bestimmte Szenarien für die Besiedlung von Böden bedeuten.
 Pferde spielen in der Geschichte der Menschheit eine wesentliche Rolle. Sie sind für die rasante Entwicklung in Landwirtschaft, Transport und Handel verantwortlich. Dass sie zum Begleiter des Menschen wurden, ist kein Zufall.
Pferde spielen in der Geschichte der Menschheit eine wesentliche Rolle. Sie sind für die rasante Entwicklung in Landwirtschaft, Transport und Handel verantwortlich. Dass sie zum Begleiter des Menschen wurden, ist kein Zufall.
 Spektakulärer Fund in Bayern: Experten entdecken Überreste zweier fleischfressender Riesenlurche aus der Triaszeit. Die Tiere weisen Ähnlichkeit zu Krokodilen auf. Wie sie vor rund 230 Millionen Jahren starben, können die Forschenden nur mutmaßen.
Spektakulärer Fund in Bayern: Experten entdecken Überreste zweier fleischfressender Riesenlurche aus der Triaszeit. Die Tiere weisen Ähnlichkeit zu Krokodilen auf. Wie sie vor rund 230 Millionen Jahren starben, können die Forschenden nur mutmaßen.
 Die Lebenserwartung von Menschen hat sich über die Jahrhunderte stark verändert. Besonders zu Beginn des 20. Jahrhunderts stieg sie schwindelerregend schnell. In einer neuen Studie machen Forscher nun aber eine Verlangsamung aus.
Die Lebenserwartung von Menschen hat sich über die Jahrhunderte stark verändert. Besonders zu Beginn des 20. Jahrhunderts stieg sie schwindelerregend schnell. In einer neuen Studie machen Forscher nun aber eine Verlangsamung aus.
 Wann fing der Mensch an, systematisch Pflanzen zu nutzen? Mehr als 9000 Jahre alte Funde aus einer Höhle in Asien liefern neue Hinweise. Laut Forschern bestätigt sich immer mehr, dass die Landwirtschaft schrittweise entstand - und ohne konkrete Absicht.
Wann fing der Mensch an, systematisch Pflanzen zu nutzen? Mehr als 9000 Jahre alte Funde aus einer Höhle in Asien liefern neue Hinweise. Laut Forschern bestätigt sich immer mehr, dass die Landwirtschaft schrittweise entstand - und ohne konkrete Absicht.
 Nach monatelangen Attacken von Donald Trump startet Harvard ins neue Semester – mit strikten Sparmaßnahmen und verunsicherten Studierenden. Manche fürchten, die Universität könnte sich doch auf einen Deal einlassen.
Nach monatelangen Attacken von Donald Trump startet Harvard ins neue Semester – mit strikten Sparmaßnahmen und verunsicherten Studierenden. Manche fürchten, die Universität könnte sich doch auf einen Deal einlassen.
 Unwahrheiten beim Dating sind nicht nur menschlich. Eine Studie legt nahe, dass Gottesanbeterinnen mit Pheromonen ihren schlechten Fitnesszustand verschleiern. Die Paarung endet für die Männchen oft tödlich.
Unwahrheiten beim Dating sind nicht nur menschlich. Eine Studie legt nahe, dass Gottesanbeterinnen mit Pheromonen ihren schlechten Fitnesszustand verschleiern. Die Paarung endet für die Männchen oft tödlich.
 Mindestens 800 Menschen sind bei dem schweren Erdbeben in Afghanistan gestorben. Experten wissen um die seismische Aktivität in der Region. Doch die Häuser dort sind darauf nicht ausgelegt.
Mindestens 800 Menschen sind bei dem schweren Erdbeben in Afghanistan gestorben. Experten wissen um die seismische Aktivität in der Region. Doch die Häuser dort sind darauf nicht ausgelegt.
 Nicht mehr nur der Arzt oder die Ärztin hört auf den Herzschlag, sondern auch eine künstliche Intelligenz: Ein Forscherteam hat das Potenzial eines neuartigen Stethoskops untersucht. Es könnte mehr Leben retten.
Nicht mehr nur der Arzt oder die Ärztin hört auf den Herzschlag, sondern auch eine künstliche Intelligenz: Ein Forscherteam hat das Potenzial eines neuartigen Stethoskops untersucht. Es könnte mehr Leben retten.
 Seit 200 Jahren galten Druck und Reibung als Grund, warum Menschen auf Eis rutschen. Doch ein deutsches Forscherteam zeigt, dass die unterschiedliche Ladung von Molekülen entscheidend ist. Selbst bei extremen Minusgraden soll Skifahren noch möglich sein.
Seit 200 Jahren galten Druck und Reibung als Grund, warum Menschen auf Eis rutschen. Doch ein deutsches Forscherteam zeigt, dass die unterschiedliche Ladung von Molekülen entscheidend ist. Selbst bei extremen Minusgraden soll Skifahren noch möglich sein.
 Spektakuläre Bilder aus freier Wildbahn: Beim britischen »Wildlife Photographer Award« werden die besten Tierfotos des Jahres ausgezeichnet. Wer mit seinen Fotos dabei ist, hatte bei der Arbeit entweder viel Geduld oder riesiges Glück.
Spektakuläre Bilder aus freier Wildbahn: Beim britischen »Wildlife Photographer Award« werden die besten Tierfotos des Jahres ausgezeichnet. Wer mit seinen Fotos dabei ist, hatte bei der Arbeit entweder viel Geduld oder riesiges Glück.
 Ein Teenager tötet sich selbst, die Eltern sehen die Verantwortung dafür bei ChatGPT – und ziehen vor Gericht. OpenAI, das Unternehmen hinter dem Chatbot, kündigt nun Änderungen an, um besser mit »sensiblen Situationen« umzugehen.
Ein Teenager tötet sich selbst, die Eltern sehen die Verantwortung dafür bei ChatGPT – und ziehen vor Gericht. OpenAI, das Unternehmen hinter dem Chatbot, kündigt nun Änderungen an, um besser mit »sensiblen Situationen« umzugehen.
 Eine Studie enthüllt eine tödliche Allianz: Ein Schimmelpilz, der schwere Lungenentzündungen auslöst, wird durch einen Virus noch gefährlicher. Forschende zeigen erstmals, wie der virale Helfer Infektionen beim Menschen verstärkt. Neue Therapien könnten helfen.
Eine Studie enthüllt eine tödliche Allianz: Ein Schimmelpilz, der schwere Lungenentzündungen auslöst, wird durch einen Virus noch gefährlicher. Forschende zeigen erstmals, wie der virale Helfer Infektionen beim Menschen verstärkt. Neue Therapien könnten helfen.
 Gerade beseitigt – und schon wieder flattert eine Motte ins Gesicht. Warum Lebensmittelmotten die Ninjas der Kücheninsekten sind. Und wie man sie schnell und einfach loswird.
Gerade beseitigt – und schon wieder flattert eine Motte ins Gesicht. Warum Lebensmittelmotten die Ninjas der Kücheninsekten sind. Und wie man sie schnell und einfach loswird.
 Die Larven der Schraubenwurmfliege fressen sich bei Nutz- und Wildtieren innerhalb kurzer Zeit durchs Fleisch und töten diese schließlich. Die Art wurde deshalb in ganz Amerika bekämpft. Doch nun ist sie in mehreren lateinamerikanischen Ländern zurück. Die USA reagieren bereits.
Die Larven der Schraubenwurmfliege fressen sich bei Nutz- und Wildtieren innerhalb kurzer Zeit durchs Fleisch und töten diese schließlich. Die Art wurde deshalb in ganz Amerika bekämpft. Doch nun ist sie in mehreren lateinamerikanischen Ländern zurück. Die USA reagieren bereits.
 Ein uraltes Naturphänomen stockt: Die Auftriebsströmung im Golf von Panama bleibt Anfang des Jahres fast völlig aus - ein bisher einzigartiges Ereignis. Forschende sind besorgt, der "historisch beispiellose Ausfall" könnte weitreichende Folgen für die Stabilität ganzer Meeresökosysteme haben.
Ein uraltes Naturphänomen stockt: Die Auftriebsströmung im Golf von Panama bleibt Anfang des Jahres fast völlig aus - ein bisher einzigartiges Ereignis. Forschende sind besorgt, der "historisch beispiellose Ausfall" könnte weitreichende Folgen für die Stabilität ganzer Meeresökosysteme haben.
 Zum ersten Mal seit Beginn der Messungen hat das kalte, nährstoffreiche Tiefenwasser des Golfs von Panama nicht die Meeresoberfläche erreicht. Forschende rätseln über die Gründe für den plötzlichen Stillstand des Auftriebs.
Zum ersten Mal seit Beginn der Messungen hat das kalte, nährstoffreiche Tiefenwasser des Golfs von Panama nicht die Meeresoberfläche erreicht. Forschende rätseln über die Gründe für den plötzlichen Stillstand des Auftriebs.
 Die Nordsee erreicht im Sommer 2025 durchschnittlich 15,7 Grad - und damit Rekordtemperatur seit Beginn der Messungen. Auch die Ostsee zeigt eine besorgniserregende Erwärmung. Experten sehen darin klare Anzeichen des Klimawandels und warnen vor zunehmenden marinen Hitzewellen.
Die Nordsee erreicht im Sommer 2025 durchschnittlich 15,7 Grad - und damit Rekordtemperatur seit Beginn der Messungen. Auch die Ostsee zeigt eine besorgniserregende Erwärmung. Experten sehen darin klare Anzeichen des Klimawandels und warnen vor zunehmenden marinen Hitzewellen.
 Die Software auf den eigenen Geräten aktuell zu halten, lohnt sich. Erst recht dann, wenn sowohl Apple als auch WhatsApp Updates ausliefern, die Nutzer vor einem »ausgeklügelten Angriff« schützen.
Die Software auf den eigenen Geräten aktuell zu halten, lohnt sich. Erst recht dann, wenn sowohl Apple als auch WhatsApp Updates ausliefern, die Nutzer vor einem »ausgeklügelten Angriff« schützen.
 Cyberkriminelle versuchen auf den verschiedensten Wegen, auf Smartphones und Computern einzudringen. Bei Messengerdienst Whatsapp gibt es jüngst eine Lücke im System, die offenbar bereits ausgenutzt wurde. Das Unternehmen rät den Usern jetzt selbst aktiv zu werden.
Cyberkriminelle versuchen auf den verschiedensten Wegen, auf Smartphones und Computern einzudringen. Bei Messengerdienst Whatsapp gibt es jüngst eine Lücke im System, die offenbar bereits ausgenutzt wurde. Das Unternehmen rät den Usern jetzt selbst aktiv zu werden.
 Gerade beseitigt – und schon wieder flattert eine Motte ins Gesicht. Warum Lebensmittelmotten die Ninjas der Kücheninsekten sind. Und wie man sie loswird.
Gerade beseitigt – und schon wieder flattert eine Motte ins Gesicht. Warum Lebensmittelmotten die Ninjas der Kücheninsekten sind. Und wie man sie loswird.
 Per Update will Apple die Strahlungswerte des iPhone 12 verringern. Was hat es damit auf sich? Wie hoch sind die Grenzwerte? Und sollte man Vorsichtsmaßnahmen ergreifen? Der Überblick.
Per Update will Apple die Strahlungswerte des iPhone 12 verringern. Was hat es damit auf sich? Wie hoch sind die Grenzwerte? Und sollte man Vorsichtsmaßnahmen ergreifen? Der Überblick.
 ChatGPT gibt in Kalifornien einem 16-Jährigen Hinweise, wie er sich das Leben nehmen kann. Nachdem dieser seinen Plan in die Tat umsetzt, gehen die Eltern gegen OpenAI vor und fordern Schmerzensgeld und eine Regulierung des KI-Bots. Der Konzern kündigt Reformen an.
ChatGPT gibt in Kalifornien einem 16-Jährigen Hinweise, wie er sich das Leben nehmen kann. Nachdem dieser seinen Plan in die Tat umsetzt, gehen die Eltern gegen OpenAI vor und fordern Schmerzensgeld und eine Regulierung des KI-Bots. Der Konzern kündigt Reformen an.
 Nach der Landung in Bulgarien hieß es, die Maschine der EU-Kommissionspräsidentin habe GPS-Probleme gehabt. Schnell stand der Vorwurf im Raum, Russland sei dafür verantwortlich. Doch der Fall ist kompliziert.
Nach der Landung in Bulgarien hieß es, die Maschine der EU-Kommissionspräsidentin habe GPS-Probleme gehabt. Schnell stand der Vorwurf im Raum, Russland sei dafür verantwortlich. Doch der Fall ist kompliziert.
 Vor knapp 40 Jahren bricht A23a von der Antarktis ab - und steckt die nächsten knapp dreieinhalb Jahrzehnte fest. Seitdem ist der einst größte Eisberg der Welt vergleichsweise mobil. Inzwischen steuert er wohl unaufhaltsam auf sein Ende zu.
Vor knapp 40 Jahren bricht A23a von der Antarktis ab - und steckt die nächsten knapp dreieinhalb Jahrzehnte fest. Seitdem ist der einst größte Eisberg der Welt vergleichsweise mobil. Inzwischen steuert er wohl unaufhaltsam auf sein Ende zu.
 Schon die Vorstellung ruft bei den meisten Menschen pure Abscheu hervor: Hunderte Fliegenlarven fressen sich allmählich durch das Gewebe im Körper bis ins Gehirn. Ein erster Fall bei einem Menschen in den USA wird nun offiziell bestätigt. Einige Behörden im Land planen verschiedene Maßnahmen gegen die Art.
Schon die Vorstellung ruft bei den meisten Menschen pure Abscheu hervor: Hunderte Fliegenlarven fressen sich allmählich durch das Gewebe im Körper bis ins Gehirn. Ein erster Fall bei einem Menschen in den USA wird nun offiziell bestätigt. Einige Behörden im Land planen verschiedene Maßnahmen gegen die Art.
 Der erste Teil von "The Outer Worlds" war ein beeindruckender Überraschungserfolg mit einigen Defiziten. Der Nachfolger macht auf den ersten Blick vieles noch besser und gleichzeitig jede Menge Laune. Wird das eine Sci-Fi-Sensation?
Der erste Teil von "The Outer Worlds" war ein beeindruckender Überraschungserfolg mit einigen Defiziten. Der Nachfolger macht auf den ersten Blick vieles noch besser und gleichzeitig jede Menge Laune. Wird das eine Sci-Fi-Sensation?
 Fachleute bezeichnen die Aktion als archäologischen Super-GAU: Das Schifffahrtsamt Elbe-Nordsee hat das 1919 in der Nordsee gesunkene U-Boot U16 eigenmächtig geborgen – mit einer erheblichen Panne.
Fachleute bezeichnen die Aktion als archäologischen Super-GAU: Das Schifffahrtsamt Elbe-Nordsee hat das 1919 in der Nordsee gesunkene U-Boot U16 eigenmächtig geborgen – mit einer erheblichen Panne.
 Der größte Regenwald der Erde steht massiv unter Druck: Die Abholzung im Amazonas führt zu weniger Regen in der Trockenzeit und steigenden Temperaturen, wie eine neue Studie zeigt. Forschende warnen vor dramatischen Folgen für das Ökosystem.
Der größte Regenwald der Erde steht massiv unter Druck: Die Abholzung im Amazonas führt zu weniger Regen in der Trockenzeit und steigenden Temperaturen, wie eine neue Studie zeigt. Forschende warnen vor dramatischen Folgen für das Ökosystem.
 Im Kampf gegen die Erderwärmung galt unterirdische CO2-Speicherung lange als geeignetes Mittel. Doch einer neuen Studie zufolge ist die weltweite Kapazität viel geringer als gedacht - wenn man auf sichere Lösungen setzt.
Im Kampf gegen die Erderwärmung galt unterirdische CO2-Speicherung lange als geeignetes Mittel. Doch einer neuen Studie zufolge ist die weltweite Kapazität viel geringer als gedacht - wenn man auf sichere Lösungen setzt.
 Der Biochemiker Johannes Krause hat Hunderte Knochen aus dem frühen Mittelalter untersucht. Sein Befund: Die Deutschen waren schon immer »ein wilder Mix«.
Der Biochemiker Johannes Krause hat Hunderte Knochen aus dem frühen Mittelalter untersucht. Sein Befund: Die Deutschen waren schon immer »ein wilder Mix«.
 Nach einem Urteil auf eine Sammelklage in Kalifornien soll Google 365 Millionen Euro an seine Nutzer zahlen. Auch in Frankreich erlitt der Internetkonzern eine potenziell teure juristische Niederlage.
Nach einem Urteil auf eine Sammelklage in Kalifornien soll Google 365 Millionen Euro an seine Nutzer zahlen. Auch in Frankreich erlitt der Internetkonzern eine potenziell teure juristische Niederlage.
 Im Rahmen einer Aktion werden dem Naturschutzbund 7000 Hornissensichtungen gemeldet. Eines fällt dabei auf: Die asiatische Art ist nur in westlichen Bundesländern vertreten. Dafür hat der Nabu eine einfache Erklärung.
Im Rahmen einer Aktion werden dem Naturschutzbund 7000 Hornissensichtungen gemeldet. Eines fällt dabei auf: Die asiatische Art ist nur in westlichen Bundesländern vertreten. Dafür hat der Nabu eine einfache Erklärung.
 Achtung! Wer zu lange mit dem Mobiltelefon auf der Toilette sitzt, riskiert Hämorrhoidalleiden. Das hat auch mit der Schwerkraft zu tun.
Achtung! Wer zu lange mit dem Mobiltelefon auf der Toilette sitzt, riskiert Hämorrhoidalleiden. Das hat auch mit der Schwerkraft zu tun.
 Der Erdkern rotiert seit etwa 2008 langsamer - und von der Erdkruste aus betrachtet in eine andere Richtung, so eine Studie. Ans Licht bringt dies die Analyse von Erdbeben und früheren Atomtests. Über die Folgen können die Forschenden nur spekulieren.
Der Erdkern rotiert seit etwa 2008 langsamer - und von der Erdkruste aus betrachtet in eine andere Richtung, so eine Studie. Ans Licht bringt dies die Analyse von Erdbeben und früheren Atomtests. Über die Folgen können die Forschenden nur spekulieren.
 Deutsche Imker sind wegen der Asiatischen Hornisse besorgt: Eine Meldeaktion des Nabu bringt nun erste Erkenntnisse über ihre aktuelle Verbreitung. In zwei Bundesländern fühlt sich die invasive Art demnach am wohlsten.
Deutsche Imker sind wegen der Asiatischen Hornisse besorgt: Eine Meldeaktion des Nabu bringt nun erste Erkenntnisse über ihre aktuelle Verbreitung. In zwei Bundesländern fühlt sich die invasive Art demnach am wohlsten.
 Bereits vor Jahrzehnten hat sich A23a vom antarktischen Festland gelöst, nun zerfällt der riesige Eisberg rapide in einzelne Brocken. Forschende sagen voraus, dass er schon bald ganz verschwunden sein könnte.
Bereits vor Jahrzehnten hat sich A23a vom antarktischen Festland gelöst, nun zerfällt der riesige Eisberg rapide in einzelne Brocken. Forschende sagen voraus, dass er schon bald ganz verschwunden sein könnte.
 Das Forschungsschiff »Polarstern« war zwei Monate lang im Eis der Arktis unterwegs. Was die Wissenschaftler gefunden haben, könnte auf eine ökologische Katastrophe hinweisen.
Das Forschungsschiff »Polarstern« war zwei Monate lang im Eis der Arktis unterwegs. Was die Wissenschaftler gefunden haben, könnte auf eine ökologische Katastrophe hinweisen.
 Sie lösen Probleme schneller als jeder Rechner und erfahren einen Hype. Allerdings werden ein paar wichtige Faktoren vergessen, die für den Erfolg der Quantencomputer entscheidend sind.
Sie lösen Probleme schneller als jeder Rechner und erfahren einen Hype. Allerdings werden ein paar wichtige Faktoren vergessen, die für den Erfolg der Quantencomputer entscheidend sind.
 Die Trump-Regierung darf nicht länger Steuergeld für Harvard blockieren. An der Eliteuni wird über den Etappensieg gejubelt. Doch ob tatsächlich Mittel fließen, ist fraglich. Es wird ein harter Gegenschlag befürchtet.
Die Trump-Regierung darf nicht länger Steuergeld für Harvard blockieren. An der Eliteuni wird über den Etappensieg gejubelt. Doch ob tatsächlich Mittel fließen, ist fraglich. Es wird ein harter Gegenschlag befürchtet.
 Ein neuer Ebola-Ausbruch in der Demokratischen Republik Kongo hat laut Behörden mehr als ein Dutzend Todesopfer gefordert. Gegen die Zaire-Variante gibt es einen Impfstoff. Nun kommt es auf die Logistik an, mahnt ein Minister.
Ein neuer Ebola-Ausbruch in der Demokratischen Republik Kongo hat laut Behörden mehr als ein Dutzend Todesopfer gefordert. Gegen die Zaire-Variante gibt es einen Impfstoff. Nun kommt es auf die Logistik an, mahnt ein Minister.
 Mit "Jupiter" will Europa vor allem im Bereich von KI-Modellen international wettbewerbsfähig sein. Der Supercomputer, der mindestens eine Trillion Rechenoperationen pro Sekunde ausführen kann, wird in Jülich offiziell in Betrieb genommen.
Mit "Jupiter" will Europa vor allem im Bereich von KI-Modellen international wettbewerbsfähig sein. Der Supercomputer, der mindestens eine Trillion Rechenoperationen pro Sekunde ausführen kann, wird in Jülich offiziell in Betrieb genommen.
 Vernetzte Kochtöpfe, Beauty-Tech und Gadgets mit direktem Draht zum Arzt: Die Technikschau Ifa geht los. Um auch die Gen Z anzulocken, setzt Messechef Leif Lindner auf TikTok-Influencer – und auf Jan Böhmermann.
Vernetzte Kochtöpfe, Beauty-Tech und Gadgets mit direktem Draht zum Arzt: Die Technikschau Ifa geht los. Um auch die Gen Z anzulocken, setzt Messechef Leif Lindner auf TikTok-Influencer – und auf Jan Böhmermann.
 Zehn Jahre nach der Einigung auf ein Weltklimaabkommen ist im Amazonas niemand in Feierstimmung. COP30-Gastgeber Brasilien versucht, gute Stimmung zu machen, sorgt aber selbst für Unmut.
Zehn Jahre nach der Einigung auf ein Weltklimaabkommen ist im Amazonas niemand in Feierstimmung. COP30-Gastgeber Brasilien versucht, gute Stimmung zu machen, sorgt aber selbst für Unmut.
 Für Patientinnen mit Brustkrebs in fortgeschrittenem Stadium sind die Behandlungsmöglichkeiten oft begrenzt. Biontech möchte ein zielgerichtetes, aber schonendes Medikament entwickeln. In einer Studie zeigt die Behandlung mit dem Präparat nun Wirkung.
Für Patientinnen mit Brustkrebs in fortgeschrittenem Stadium sind die Behandlungsmöglichkeiten oft begrenzt. Biontech möchte ein zielgerichtetes, aber schonendes Medikament entwickeln. In einer Studie zeigt die Behandlung mit dem Präparat nun Wirkung.
 Am Sonntagabend zeigt sich eine totale Mondfinsternis über Deutschland. Dank Hoch "Nina" sind die Wetterbedingungen vielerorts ideal, nur der späte Mondaufgang erschwert die Sicht. Im Osten Deutschlands sind die Bedingungen am besten.
Am Sonntagabend zeigt sich eine totale Mondfinsternis über Deutschland. Dank Hoch "Nina" sind die Wetterbedingungen vielerorts ideal, nur der späte Mondaufgang erschwert die Sicht. Im Osten Deutschlands sind die Bedingungen am besten.
 »Jupiter« liefert eine Trillion Rechenoperationen pro Sekunde: In Jülich geht einer der rasantesten Supercomputer der Welt an den Start. Kanzler Merz verspricht sich davon »ganz neue Möglichkeiten«.
»Jupiter« liefert eine Trillion Rechenoperationen pro Sekunde: In Jülich geht einer der rasantesten Supercomputer der Welt an den Start. Kanzler Merz verspricht sich davon »ganz neue Möglichkeiten«.
 Der Löwe ist das Wappentier von Venedig. Die berühmte Statue vom Markusplatz war aber ursprünglich ein chinesischer Grabwächter – und könnte mit Marco Polos Vater weit gereist sein.
Der Löwe ist das Wappentier von Venedig. Die berühmte Statue vom Markusplatz war aber ursprünglich ein chinesischer Grabwächter – und könnte mit Marco Polos Vater weit gereist sein.
 "Wer die Wahl hat, hat die Qual", lautet ein Sprichwort, das auch auf Froschweibchen bei der Partnerwahl zutrifft. Ein Forschungsteam beobachtet Froschdamen und spielt ihnen Quaken vor.
"Wer die Wahl hat, hat die Qual", lautet ein Sprichwort, das auch auf Froschweibchen bei der Partnerwahl zutrifft. Ein Forschungsteam beobachtet Froschdamen und spielt ihnen Quaken vor.
 Auge in Auge mit Deutschlands Supercomputer gerät Kanzler Merz im nordrhein-westfälischen Jülich ins Schwärmen. Doch Zweifel an den Superlativen sind angebracht: Ist "Jupiter" vielleicht nur deshalb so potent, weil die USA und China ihre Rechner gar nicht erst fürs Ranking melden?
Auge in Auge mit Deutschlands Supercomputer gerät Kanzler Merz im nordrhein-westfälischen Jülich ins Schwärmen. Doch Zweifel an den Superlativen sind angebracht: Ist "Jupiter" vielleicht nur deshalb so potent, weil die USA und China ihre Rechner gar nicht erst fürs Ranking melden?
 Der Plan der australischen Regierung, ein Social-Media-Verbot für Kinder unter 16 Jahren zu verhängen, hat auch in Deutschland eine Debatte entfacht. Grünenchefin Franziska Brantner will auch hierzulande ein striktes Vorgehen.
Der Plan der australischen Regierung, ein Social-Media-Verbot für Kinder unter 16 Jahren zu verhängen, hat auch in Deutschland eine Debatte entfacht. Grünenchefin Franziska Brantner will auch hierzulande ein striktes Vorgehen.
 Die frühe Außenministerin ist in New York angekommen. Die neue Präsidentin der Uno-Vollversammlung inszeniert sich auf Instagram im Stil von »Sex and the City«. Eine Chance, die Markus Söder sicher genutzt hätte, ließ sie aber aus.
Die frühe Außenministerin ist in New York angekommen. Die neue Präsidentin der Uno-Vollversammlung inszeniert sich auf Instagram im Stil von »Sex and the City«. Eine Chance, die Markus Söder sicher genutzt hätte, ließ sie aber aus.
 Altern ist der unaufhaltsame biologische Prozess des Verfalls, dessen Geschwindigkeit von vielen Faktoren abhängt. Die Zustände im All könnten diesen Prozess verlangsamen, doch es gibt dabei einen Haken.
Altern ist der unaufhaltsame biologische Prozess des Verfalls, dessen Geschwindigkeit von vielen Faktoren abhängt. Die Zustände im All könnten diesen Prozess verlangsamen, doch es gibt dabei einen Haken.
 Die frühere Außenministerin ist in New York angekommen. Die neue Präsidentin der Uno-Vollversammlung inszeniert sich auf Instagram im Stil von »Sex and the City«. Eine Chance, die Markus Söder sicher genutzt hätte, ließ sie aber aus.
Die frühere Außenministerin ist in New York angekommen. Die neue Präsidentin der Uno-Vollversammlung inszeniert sich auf Instagram im Stil von »Sex and the City«. Eine Chance, die Markus Söder sicher genutzt hätte, ließ sie aber aus.
 Deutschland gibt Milliarden für umweltschädliche Subventionen aus – und fast genauso viel fürs Beseitigen der Folgen, sagt Klement Tockner. Der Direktor der Senckenberg-Gesellschaft fordert mehr Prävention.
Deutschland gibt Milliarden für umweltschädliche Subventionen aus – und fast genauso viel fürs Beseitigen der Folgen, sagt Klement Tockner. Der Direktor der Senckenberg-Gesellschaft fordert mehr Prävention.
 Es ist ein beeindruckendes Naturschauspiel: Eine totale Mondfinsternis lockt weltweit Sternengucker an. Auch in Deutschland kann die Eklipse bestaunt werden, besonders gut im Osten. Der Mond erscheint währenddessen rötlich gefärbt.
Es ist ein beeindruckendes Naturschauspiel: Eine totale Mondfinsternis lockt weltweit Sternengucker an. Auch in Deutschland kann die Eklipse bestaunt werden, besonders gut im Osten. Der Mond erscheint währenddessen rötlich gefärbt.
 Krallen oder Nägel? Das scheint eine entscheidende Frage in der Entwicklungsgeschichte von Nagetieren zu sein. Dabei war das Vorhandensein eines ganz speziellen Nagels von besonderer Bedeutung, wie Forschende jetzt herausfinden.
Krallen oder Nägel? Das scheint eine entscheidende Frage in der Entwicklungsgeschichte von Nagetieren zu sein. Dabei war das Vorhandensein eines ganz speziellen Nagels von besonderer Bedeutung, wie Forschende jetzt herausfinden.
 Am Sonntagabend werden die sozialen Netzwerke plötzlich mit Bildern des Mondes geflutet: eine totale Mondfinsternis, wie es sie nur selten gibt. Einen Haken gibt es aber für die Betrachter hierzulande.
Am Sonntagabend werden die sozialen Netzwerke plötzlich mit Bildern des Mondes geflutet: eine totale Mondfinsternis, wie es sie nur selten gibt. Einen Haken gibt es aber für die Betrachter hierzulande.
 Die Software auf den eigenen Geräten aktuell zu halten, lohnt sich. Erst recht dann, wenn sowohl Apple als auch WhatsApp Updates ausliefern, die Nutzer vor einem »ausgeklügelten Angriff« schützen.
Die Software auf den eigenen Geräten aktuell zu halten, lohnt sich. Erst recht dann, wenn sowohl Apple als auch WhatsApp Updates ausliefern, die Nutzer vor einem »ausgeklügelten Angriff« schützen.
 Hobby-Astronomen aus aller Welt blickten in der vergangenen Nacht hinauf zum Mond. Der schob sich für etwa eine Stunde in den Schatten der Erde. Die schönsten Bilder des Himmelspektakels.
Hobby-Astronomen aus aller Welt blickten in der vergangenen Nacht hinauf zum Mond. Der schob sich für etwa eine Stunde in den Schatten der Erde. Die schönsten Bilder des Himmelspektakels.
 Ein verbreitetes Hautbakterium zeigt eine Haftkraft, die stärker ist als jede bekannte natürliche Proteinbindung. Der Erreger ist meist harmlos, kann aber auch schwere Infekte verursachen. Das Wissen über seine Klebeformel könnte neue Therapien ermöglichen.
Ein verbreitetes Hautbakterium zeigt eine Haftkraft, die stärker ist als jede bekannte natürliche Proteinbindung. Der Erreger ist meist harmlos, kann aber auch schwere Infekte verursachen. Das Wissen über seine Klebeformel könnte neue Therapien ermöglichen.
 Hobbyastronomen aus aller Welt blickten in der vergangenen Nacht hinauf zum Mond. Der schob sich für etwa eine Stunde in den Schatten der Erde. Die schönsten Bilder des Himmelspektakels.
Hobbyastronomen aus aller Welt blickten in der vergangenen Nacht hinauf zum Mond. Der schob sich für etwa eine Stunde in den Schatten der Erde. Die schönsten Bilder des Himmelspektakels.
 Obwohl Prochlorococcus zu den kleinsten Organismen überhaupt gehört, hat es riesigen Einfluss auf das Leben auf der Erde. Doch das Cyanobakterium könnte bald zu großen Teilen verschwinden. Das könnte eine Kettenreaktion auslösen.
Obwohl Prochlorococcus zu den kleinsten Organismen überhaupt gehört, hat es riesigen Einfluss auf das Leben auf der Erde. Doch das Cyanobakterium könnte bald zu großen Teilen verschwinden. Das könnte eine Kettenreaktion auslösen.
 Das Meeresbakterium Prochlorococcus produziert bedeutende Mengen des Sauerstoffs auf der Erde. Eine Studie legt nahe, dass dem Organismus die Erwärmung der Ozeane arg zusetzt. Die Folgen könnten schwerwiegend sein.
Das Meeresbakterium Prochlorococcus produziert bedeutende Mengen des Sauerstoffs auf der Erde. Eine Studie legt nahe, dass dem Organismus die Erwärmung der Ozeane arg zusetzt. Die Folgen könnten schwerwiegend sein.
 Die Soundcore Sleep A30 sind besonders kleine und flache Ohrhörer, mit denen man auch auf der Seite liegend schlafen können soll. Eine aktive Geräuschunterdrückung, diverse Klänge und eine Schnarchmaskierung sollen zusätzlich helfen, schnell und durchgehend zu ruhen. ntv.de hat ausprobiert, ob das funktioniert.
Die Soundcore Sleep A30 sind besonders kleine und flache Ohrhörer, mit denen man auch auf der Seite liegend schlafen können soll. Eine aktive Geräuschunterdrückung, diverse Klänge und eine Schnarchmaskierung sollen zusätzlich helfen, schnell und durchgehend zu ruhen. ntv.de hat ausprobiert, ob das funktioniert.
 In historischer Tracht eines germanischen Stammeskriegers macht sich Finnian Garvey auf, um den römischen Limes entlangzulaufen. Seine Reise startet der 27-Jährige in Rheinland-Pfalz. Für den Weltrekord plant er 38 Tage ein.
In historischer Tracht eines germanischen Stammeskriegers macht sich Finnian Garvey auf, um den römischen Limes entlangzulaufen. Seine Reise startet der 27-Jährige in Rheinland-Pfalz. Für den Weltrekord plant er 38 Tage ein.
 Der Impfgegner Robert F. Kennedy Jr. hat eine Kehrtwende der US-Gesundheitspolitik eingeleitet. Einige Bundesstaaten begehren auf. Doch der radikale Umbau geht womöglich gerade erst richtig los.
Der Impfgegner Robert F. Kennedy Jr. hat eine Kehrtwende der US-Gesundheitspolitik eingeleitet. Einige Bundesstaaten begehren auf. Doch der radikale Umbau geht womöglich gerade erst richtig los.
 Im Kampf gegen die Erderwärmung galt unterirdische CO2-Speicherung lange als geeignetes Mittel. Doch einer neuen Studie zufolge ist die weltweite Kapazität viel geringer als gedacht - wenn man auf sichere Lösungen setzt.
Im Kampf gegen die Erderwärmung galt unterirdische CO2-Speicherung lange als geeignetes Mittel. Doch einer neuen Studie zufolge ist die weltweite Kapazität viel geringer als gedacht - wenn man auf sichere Lösungen setzt.
 Viele Millionen Menschen leben weltweit mit Diabetes, ohne dass die Krankheit bei ihnen diagnostiziert wurde. Auch in Deutschland ist die Dunkelziffer hoch. Fachleute befürchten eine »stille Epidemie«.
Viele Millionen Menschen leben weltweit mit Diabetes, ohne dass die Krankheit bei ihnen diagnostiziert wurde. Auch in Deutschland ist die Dunkelziffer hoch. Fachleute befürchten eine »stille Epidemie«.
 Die Erderwärmung führt auch dazu, dass Permafrost nach und nach schwindet. Das wiederum setzt viele Stoffe frei, die wiederum direkt in die Flüsse gelangen. Wie stark der Einfluss in den USA ist, beschreibt ein Forschungsteam.
Die Erderwärmung führt auch dazu, dass Permafrost nach und nach schwindet. Das wiederum setzt viele Stoffe frei, die wiederum direkt in die Flüsse gelangen. Wie stark der Einfluss in den USA ist, beschreibt ein Forschungsteam.
 Der Klimatrend bleibt ungebrochen, aber der August fällt weltweit ein wenig milder aus als in den Rekordjahren zuvor. Deutschland bekommt das zu spüren. In Süd- und Südosteuropa hingegen machen Trockenheit und Hitze extrem zu schaffen.
Der Klimatrend bleibt ungebrochen, aber der August fällt weltweit ein wenig milder aus als in den Rekordjahren zuvor. Deutschland bekommt das zu spüren. In Süd- und Südosteuropa hingegen machen Trockenheit und Hitze extrem zu schaffen.
 Die gefährliche Chagas-Krankheit tritt vor allem in Lateinamerika auf. Doch Forschende möchten die Krankheit jetzt auch in den USA als »endemisch« einstufen lassen.
Die gefährliche Chagas-Krankheit tritt vor allem in Lateinamerika auf. Doch Forschende möchten die Krankheit jetzt auch in den USA als »endemisch« einstufen lassen.
 Jedes Jahr im Herbst zieht es wieder zahllose Pilzsammler in die Wälder. Für manche von ihnen endet die Mahlzeit im Krankenhaus. Fachmann Stefan Fischer erklärt, was dann passiert – und was bei möglichen Vergiftungen zu tun ist.
Jedes Jahr im Herbst zieht es wieder zahllose Pilzsammler in die Wälder. Für manche von ihnen endet die Mahlzeit im Krankenhaus. Fachmann Stefan Fischer erklärt, was dann passiert – und was bei möglichen Vergiftungen zu tun ist.